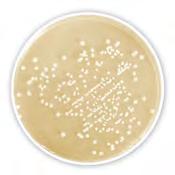
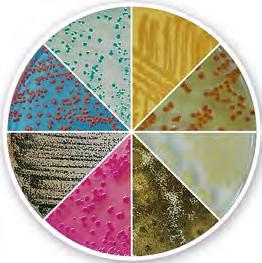
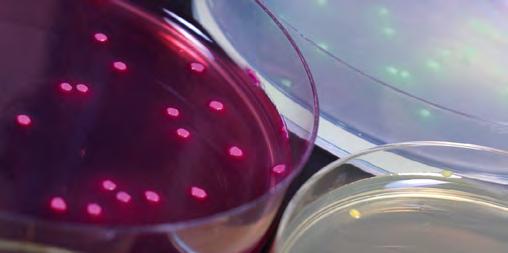

Offizielles Organ des Schweizerischen Chemie- und Pharmaberufe Verbandes April / Mai 2024 4–5/2024

DIE FACHZEITSCHRIFT FÜR DIE CHEMIE- UND LABORBRANCHE

SCHNELL, EINFACH, AUTOMATISCH: NIR-SPEKTROSKOPIE VON METROHM


Die richtige Formel für mehr Energieeffizienz
Kein Stillstand, keine Sorgen. Klüber Lubrication bietet individuelle Lösungen für die chemische Industrie. Mehr Effizienz und Zuverlässigkeit bei optimierten Wartungskosten. klüber.ch
#the_right_Formula
Laborista? Ja, gern!

Offenbar werden Cappuccinos heute auch koffeinfrei bestellt. Als dies kürzlich jemand neben mir mit grosser Selbstverständlichkeit tat, rief eine Stimme in mir: «Verhältnisblödsinn»! Doch der Reihe nach.
Bei einem koffeinfreien Cappuccino ist Kaffee also nicht nur eine Nebenzutat, sondern hat auch noch eine unerwünschte Wirkung. Ist es für eine Sekundäringredienz nicht absurd, dass deren Pflanze erst auf einem anderen Kontinent angebaut und aufbereitet, dann transportiert, geröstet und gemahlen wird, bevor wir sie konsumieren? Für diejenigen, die den Wachmach-Effekt nicht mögen, kommt ein weiterer Verarbeitungsschritt hinzu: Das Entkoffeinieren. Und dann, in einem Guss, wird der Kaffeegeschmack und -geruch durch das Beimischen von Milch auf eine Note reduziert.
Dass bei den «milch-dominierten» Kaffeegetränken die Kuhmilch gerne mit Hafer-, Sojaoder Reismilch ersetzt wird, ist mittlerweile normal. Wieso also nicht auch den Kaffee mit einer anderen Zutat ersetzen? Der ganze Produktionsaufwand bliebe erspart und der durch den Klimawandel bedrohte Kaffeeanbau würde entlastet werden.
So hatte ich insgeheim gehofft, dass der bekannteste Schweizer Hersteller von KaffeeMilch-Mischgetränken auf diesem Gebiet bereits forscht, was umsatztechnisch nachvollziehbar wäre. Doch dies wurde nach meiner Anfrage nicht bestätigt, man setze auf «frisch gebrühten Kaffee in Barista-Qualität mit hochwertiger Schweizer Milch –schonend verarbeitet und ganz ohne künstliche Zusatzstoffe.»
Im Netz wurde ich anderswo fündig: Forschende in Finnland berichteten von erstmals im Labor gezüchtetem Kaffee – mit Koffein! Mehr noch: Es wurden Zellkulturen verschiedener Kaffeesorten angelegt und beim Kultivierungsprozess sogar die Aromen verändert. Geschmack und Geruch des Labor-Kaffeepulvers seien fast normal, die Herausforderungen lägen noch in der Zubereitung und Zulassung. Nächstes Jahr sollten wir mehr darüber erfahren.
Das Geniale am «Laborista»: Der Kaffee könnte also auf die Vorlieben der LatteMacchiato-Fans auf Mass geschneidert werden. Ist der Herstellungsprozess umweltfreundlich, ergibt das Sinn und es müsste weniger hingeblättert werden – zumindest, wenn mit subventionierter Kuhmilch gestreckt wird. Ausserdem müsste nicht in die teure Züchtung klimaresistenterer Pflanzen investiert werden.
Für Espressoliebhaber wäre das natürlich keine Option, doch Herr und Frau Schweizer trinken den Kaffee ausser Haus sowieso mehrheitlich als Mischgetränk.
Im Fokus dieser Ausgabe geht es auch um die Zellkultivierung im Labor, die Themen liegen aber in der medizinischen Forschung. Ich wünsche Ihnen eine spannende Lektüre!
 Luca Meister redaktion@sigwerb.com
Luca Meister redaktion@sigwerb.com
Nachhaltig denken und handeln gehört zu den grössten Herausforderungen der Zukunft. In uns finden Sie den Partner mit den gleichen Werten. Nachricht verstanden.
#FUTURESILIENCE

Laborbedarf, Life Science und Chemikalien www.carlroth.com


4–5 /2024 EDITORIAL 1
CH_ChemiaXtra_FUTURERESILIENCE_1_3_58x266.indd 6 08.02.2024 13:09:48
FOKUS
Druck das Herz mal aus –dann schauen wir
Additive Fertigung in der Medizin: Bei Weichgeweben kommt die Herausforderung der Formstabilität hinzu. Doch selbst ganze Organe werden mit Unterstützung durch den 3-D-Druck zugänglich. 04 04
08


14

LABOR
KI klopft an die Labortüren
Starlab hat ein Stimmungsbarometer der Laborbranche erstellt. Die Umfrage ist auch für die Schweiz relevant, wo mehr oder weniger die gleichen Themen dominieren: KI, Nachhaltigkeit und Fachkräfte.
CHEMIE
Substrate objektiv auswählen
Unbewusster Voreingenommenheit vorbeugen: Mit einem computergestützten Verfahren sollen subjektive Verzerrungen in Studien zur Herstellung neuer chemischer Verbindungen vermieden werden.
12

BIOWISSENSCHAFTEN
Über den Verlust gesunder Darmmikroben
Eine neue Studie kommt zum Schluss, dass Menschen in industrialisierten Gesellschaften jene Mikroben verlieren, die Ballaststoffe in der Nahrung für einen gesunden Verdauungstrakt verwandeln.
IMPRESSUM
Die Fachzeitschrift für die Chemie- und Laborbranche www.chemiextra.com
Erscheinungsweise
7 × jährlich
Jahrgang
14. Jahrgang (2024)
Druckauflage 7650 Exemplare
WEMF / SW-Beglaubigung 2023
6495 Exemplare Total verbreitete Auflage 1823 Exemplare davon verkauft
ISSN-Nummer 1664-6770
Geschäftsleiter
Andreas A. Keller

Herausgeber/Verlag
SIGWERB GmbH
Unter Altstadt 10, Postfach
CH-6302 Zug +41 41 711 61 11 info@sigwerb.com www.sigwerb.com
Anzeigenverkaufsleitung
Thomas Füglistaler
Anzeigenverkauf
SIGI media AG
Jörg Signer
Alte Bahnhofstrasse 9a
CH-5610 Wohlen
+41 56 619 52 52 info@sigimedia.ch
Redaktion
Luca Meister
Unter Altstadt 10, Postfach
CH-6302 Zug
+41 41 711 61 11 redaktion@sigwerb.com
Dr. Christian Ehrensberger redaktion@sigwerb.com
Redaktionelle Mitarbeit
Dr. Kurt Hermann
16

MEDIZIN
Zyklische Peptide für orale Arzneimittel
Höhere Bioverfügbarkeit: Mit oral verfügbaren zyklischen Peptiden könnte eine neue Generation von Medikamenten für bisher unbehandelbare Krankheiten hervorgebracht werden.
18

ERNÄHRUNG
Alternative Proteine treiben Food-Bereich an
Aktuelle gesellschaftliche Entwicklungen im Food-Bereich wirken sich unmittelbar auf lebensmittelchemische Prozesse aus. Ein Beispiel stellt der Trend zu alternativen Proteinen dar.
Vorstufe
Triner Media + Print Schmiedgasse 7 CH-6431 Schwyz +41 41 819 08 10 beratung@triner.ch www.triner.ch
Abonnemente +41 41 711 61 11 info@sigwerb.com www.chemiextra.com
Druck
Fontana Print SA Via Giovanni Maraini 23 CH-6963 Pregassona +41 91 941 38 21 www.fontana.ch
Jahresabonnement Schweiz: CHF 38.00 (inkl. Porto/MwSt.) Jahresabonnement Ausland: CHF 58.00 (inkl. Porto)
Copyright Zur Veröffentlichung angenommene Originalartikel gehen in das ausschliessliche Verlagsrecht der SIGWERB GmbH über. Nachdruck, fotomechanische Vervielfältigung, Einspeicherung in Datenverarbeitungsanlagen und Wiedergabe durch elektronische Medien, auch auszugsweise, nur mit Genehmigung des Verlags. Für unverlangt eingesandte Manuskripte wird keine Haftung übernommen.
Copyright 2024 by SIGWERB GmbH, CH-6302 Zug
INHALTSVERZEICHNIS 2 4–5/2024

VERANSTALTUNGEN
Analytica 2024
Unsere Messenachschau mit den wichtigsten Zahlen und einer Bildergalerie: Die ChemieXtra-Redaktion hat die Highlights der Fachmesse für Labortechnik, Analytik und Biotechnologie zusammengetragen. 20

FIRMEN BERICHTEN
Zimmerli Messtechnik feiert 50-Jähriges
1974 haben Peter W. und Ursula Zimmerli eine prozesstechnische Erfolgsgeschichte in Gang gesetzt, die seit einem halben Jahrhundert andauert und dieses Jahr ihr 50-jähriges Jubiläum feiert. 30
39

SICHERHEIT
Umweltfreundlichere Flammschutzmittel
Eine Alternative zu den problematischen bromierten Flammschutzmitteln sind phosphororganische Flammschutzmittel. Eine vergleichende Studie untersuchte die Umweltauswirkungen beider Mittel.

ZUM TITELBILD
«Good Vibes» in Ihrem Labor mit schneller, einfacher und automatischer Nahinfrarotspektroskopie
OMNIS NIRS bringt «GOOD VIBES made in Switzerland» in Ihr Labor. Das NahinfrarotSpektrometer von Metrohm wurde komplett in der Schweiz entwickelt und wird in Herisau produziert. Dabei werden robuste Komponenten verwendet, die einen langjährigen, zuverlässigen Gerätebetrieb im Labor oder in der Produktion garantieren. Das NIR-Spektrometer kann zahlreiche Qualitätsparameter in flüssigen und festen Proben in nur wenigen Sekunden bestimmen. Die Temperatur der Proben kann zwischen 25°C und 80°C liegen und wird dank ausge -

VERFAHRENSTECHNIK
Wasserabweisende Textil fasern ohne PFAS
Mit einem neuen Verfahren mit lassen sich umweltfreundliche wasserabweisende Textilfasern erzeugen. Erste Analysen zeigen: Die «guten» Fasern sind besser.

UMWELT
PFAS im Blut – ein kardiovaskuläres Risiko?
VERBANDSSEITEN



klügelter Algorithmen direkt an der Probe bestimmt und geregelt.
Die Entwicklung des NIRS-Vorhersagemodells kann dem integrierten OMNIS Model Developer (OMD) überlassen werden. Sie wählen Ihre Proben aus, und mit nur einem Klick wird Ihr Modell automatisch parametrisiert und berechnet.
Das neue OMNIS NIRS ist einfach zu bedienen und erledigt Routineanalysen schnell und effizient. Das macht Freude und bringt «good vibes» in ihr Labor.
Metrohm Schweiz AG 4800 Zofingen
Tel. +41 62 745 28 28 info@metrohm.ch www.metrohm.ch

INHALTSVERZEICHNIS 3 4–5/2024
DIE FACHZEITSCHRIFT FÜR DIE CHEMIE- UND LABORBRANCHE Offizielles Organ des Schweizerischen Chemie- und Pharmaberufe Verbandes April Mai 2024 4–5/2024 SCHNELL, EINFACH, AUTOMATISCH: NIR-SPEKTROSKOPIE
METROHM
VON
SCV-Informationen 52 PRODUKTE 57 LIEFERANTENVERZEICHNIS 61 AUS DER FORSCHUNG 44 AUS DER BRANCHE 48
40
42
Nahziel: Gewebe zum Labortest von Wirkstoffen – Fernziel: ein ganzes Organ
Druck das Herz mal aus – dann schauen wir
Die additive Fertigung macht in der Technik komplexe Formen zugänglich. In der Medizin verwendet man den Druck dreidimensionaler Strukturen zum schichtweisen Aufbau von Knochenimplantaten und Zahnkronen. Bei Weichgeweben kommt als spezielle Herausforderung die Formstabilität hinzu, doch selbst ganze Organe werden mit Unterstützung durch die additive Fertigung zugänglich.
Dr. Christian Ehrensberger
Beim Versuch, ein Stück Haut, einen Herzmuskel, Lungenbläschen oder ein anderes Organ im Labor wachsen zu lassen, besteht die Gefahr, am Ende einen Zellklumpen zu erhalten. Die Zellen haben sich wie gewünscht differenziert, aber ihnen fehlt die Struktur. Bei der Überwindung dieser Schwierigkeit helfen Verfahren der additiven Fertigung («3-D-Druck»).
Gedruckte Stützstruktur für Zellen
Im lebenden Organismus gibt den Zellen ein Netzwerk von Proteinen einen festen Halt. Eine solche extrazelluläre Matrix lässt sich aber auch künstlich herstellen – mit einem 3-D-Drucker . Amelie Erben hat es kürzlich am Beispiel von Lungengewebe gezeigt, wobei sich die Kultivierung von Lungenbläschen sogar als eine besondere Herausforderung erwies. Denn weil diese von einer extrem dünnen extrazellulären Matrix gebildet werden, durch die der Sauerstoff an den Blutkreislauf abgegeben wird, muss die umgebende Proteinstruktur besonders präzise aufgebaut sein. Die Forscherin des Centrums für Angewandtes Tissue Engineering und Regenerative Medizin der Hochschule München und des Heinz Nixdorf Lehrstuhls für Biomedizinische Elektronik der Technischen Universität München nutzte für den Druck der nur wenige Mikrometer dünnen 3-DStruktur die sogenannte Zwei-PhotonenStereolithographie. Bei diesem Verfahren werden Proteine an bestimmten Punkten miteinander zu Ketten verschweisst, Schicht für Schicht. Erste Experimente haben offenbar gezeigt: Die Zellen lassen sich in dieser gedruckten Umgebung tatsächlich gut vermehren und weisen Eigen -

Verschiedene Forschungsgruppen sind auf dem Weg dorthin: ein ganzes Organ, zum Beispiel ein Herz, einfach ausdrucken. (Bild: Adpic)
schaften auf, die denen von natürlichem Lungengewebe ähnlich sind.
Im nächsten Schritt sollen nun Gefässe zur Versorgung des gezüchteten Gewebes ergänzt werden. Durch eine gedruckte dreidimensionale Proteinstruktur mit einem 80 Mikrometer dünnen Kanal soll dann die
Versorgung der Zellen mit Sauerstoff und Nährstoffen simuliert werden.
Muskelgewebedruck aus Hydrogel und Fasern
Aussichtsreiche Materialien für die Gerüste sind Hydrogele, wasserhaltige und gleich -

Zellkultivierung im Labor der Hochschule München. (Bild: Alexander Ratzing)
4 4–5/2024 Fokus

Hunde bekommen häufig Hautprobleme – da hat das Vollhaut-Äquivalent für Labortests seine volle Berechtigung. (Bild: Envato)
zeitig wasserunlösliche Polymere. Sie geben Zellen nicht nur mechanischen Halt, sondern spenden ihnen auch lebensnotwendiges Wasser. Ein Hydrogel, das neben Wasser auch Zellen enthält, wird als BioTinte bezeichnet und finden seit Jahrzehnten breite Anwendung in der Gewebezucht («Tissue Engineering»), der künstlichen Herstellung biologischer Gewebe. Bio-Tinte lässt sich vorteilhafterweise zu dreidimensionalen Strukturen drucken. In Kombination mit dem sogenannten TouchSpinning-Verfahren, mit dem sich Fasern aus einer Polymerlösung gewinnen lassen, entsteht ein Hydrogel-Faser-Verbundwerkstoff. Beide Verfahren – der Bio-TintenDruck und das Touch-Spinning – lassen sich jetzt in einem einzigen Gerät verei -
Literatur
nen. Dieses produziert Zellen in der Art von Binde- oder Muskelgewebe. Die Fasern weisen dabei eine Vorzugsrichtung; entlang dieser wachsen die Zellen.
Knorpelgewebe wächst in Drei-Millimeter-Fussbällen
Wie weit das Tissue Engineering bereits fortgeschritten ist, erkennt man am Stand der Technik im Bereich der Gewinnung von Knorpelzellen aus Stammzellen. Dies gilt als Königsdisziplin, weil sich hier besonders gern unförmige Zellklumpen bilden und anschliessend auch noch schrumpfen. Für eine definierte Geometrie, für gleichmässig verteilte Zellen und für eine hohe Zelldichte sorgen jetzt Stützstrukturen aus «Käfigen» oder «Fussbällen»
1. Amelie Erben, Marcel Hörning, Bastian Hartmann, Tanja Becke, Stephan A. Eisler, Alexander Southan, Séverine Cranz, Oliver Hayden, Nikolaus Kneidinger, Melanie Königshoff, Michael Lindner, Günter E. M. Tovar, Gerald Burgstaller, Hauke Clausen-Schaumann, Stefanie Sudhop, and Michael Heymann (2020), Precision 3DPrinted Cell Scaffolds Mimicking Native Tissue Composition and Mechanics, Adv. Healthcare Mater., DOI: 10.1002/adhm.202000918
2. W. Kitana, V. Levario-Diaz, E. A. Cavalcanti-Adam, L. Ionov, Biofabrication of Composite Bioink-Nanofiber Constructs: Effect of Rheological Properties of Bioinks on 3D (Bio)Printing and Cells Interaction with Aligned Touch Spun Nanofibers. Adv. Healthcare Mater. 2023, 2303343. DOI: 10.1002/adhm.202303343
3. O. Kopinski-Grünwald et al., Scaffolded spheroids as building blocks for bottomup cartilage tissue engineering show enhanced bioassembly dynamics, Acta Biomaterialia, 174, 163 (2024)
4. Pressemeldung Fraunhofer-Institut für Grenzflächen- und Bioverfahrenstechnik IGB vom 1.2.2024
mit einem Durchmesser von einem Drittelmillimeter. Sie lassen sich zu beliebigen Formen aneinanderfügen wie Bausteine. In diese fussballförmigen Käfige werden zunächst Stammzellen eingebracht, die sich schon in Richtung Knorpelzellen differenziert haben. Sie füllen das winzige Volumen rasch vollständig aus. Die Zellen in unterschiedlichen Mini-Fussbällen verwachsen nach einiger Zeit, wandern mitunter auch von einem Fussball in einen anderen und ergeben schliesslich eine geschlossene Gesamtstruktur ohne Hohlräume.
Die gedruckten Stützelemente aus Kunststoff bauen sich selbstständig ab und verschwinden über einen Zeitraum von Monaten nach und nach; es bleibt das fertig geformte Gewebe in der gewünschten Form. Das Nahziel besteht nun darin, kleine massgeschneiderte Knorpelgewebsteile zu produzieren und nach einer Verletzung in bestehendes Knorpelmaterial einzusetzen. Ein Fernziel sehen die Forscher in der Herstellung auch von anderen Geweben – inklusive Blutgefässen .
Hunde-Vollhaut-Äquivalent im Labor statt Tierversuch
Auch die Haut ist ein Organ, ein sehr grosse sogar. So beeindruckt die erstmalige Herstellung einer reproduzierbaren In-vitro-Hundehaut im Labor unter der Projektbezeichnung «WowWowSkin». Das Vollhaut-Äquivalent haben Forscher auf der Basis von echter Hundehaut entwickelt. Sie mussten dazu zunächst die unterschiedlichen Hautschichten voneinander trennen, die Zellen separat vermehren und am Ende wieder zusammenfügen.
An solchen Vollhaut-Äquivalenten lässt sich nun die Wirkung medizinischer Therapeutika für die empfindliche Hundehaut präzise testen. Auch Pflegemittel wie Shampoo oder Fellseife lassen sich damit auf Verträglichkeit untersuchen – ganz ohne Tierversuche.
Auch das künstliche Lungengewebe aus München ist für Test-Zwecke gedacht: Im nächsten Schritt wird die Forschergruppe die Reaktionen der Zellen auf verschiedene Reize erforschen und die Gerüststruktur weiter an das natürliche Vorbild annähern. In einer ähnlichen Phase befindet sich das gedruckte Bindegewebe bzw. die Muskelfasern.

5 4–5/2024 Fokus
Beschädigtes Gewebe im Körper wieder aufbauen und regenerieren
Venen aus dem Labor
Das CSEM und Clexbio, ein in Norwegen ansässiges Startup, haben gemeinsam einen neuartigen Bioreaktor entwickelt für die Züchtung menschlicher Venen im Labor. Die vom Research Council of Norway finanzierte Lösung soll das Leben von Millionen von Menschen, die an schwerer chronischer Veneninsuffizienz (CVI) leiden, durch die Möglichkeit erleichtern, ihnen biotechnisch hergestellte Venen zu implantieren.
Gemeinsam haben die Partner einen Bioreaktor-Prototypen für die Herstellung funktioneller Venenimplantate aus menschlichem Stammzellgewebe entwickelt und getestet, der sich in den Körper des Patienten integriert und zu lebendem Gewebe wird. Clexbio nutzte hierfür seine Kompetenzen im Bereich der regenerativen Medizin, seine IP-Plattform und sein Fachwissen über Hydrogele, während die CSEM-Ingenieurinnen und -Ingenieure ihr Know-how in den Bereichen Automatisierung, mikrophysiologische Systeme und intelligente Labortechnik einbrachten.
Eine biologisch abbaubare Matrix
Die Plattformtechnologie «Vivoset» von Clexbio ist eine Zell-Biomaterial-Formulierung, die Gewebe mit komplexem Aufbau, wie zum Beispiel Venen, formen und bau -

Chemistry Glasswareand Reactors
• CompleteProcessReactorSystems (300 ml to150 l) ‐ready‐to‐useorcustomized
• FilterReactor Systems and Gas Scrubbers
• Schlenk‐Lines and Airfree® chemistry
• Peptide Synthesis, PressureVesselsand
• Sublimation Apparatusand Condensers
• Adapters forEvaporators and forFiltration

Entwicklung von Venentransplantaten aus menschlichem Gewebematerial, die sich in den Körper des Patienten integrieren und zu echtem, lebendem Gewebe werden können. (Bild: CSEM)
gezüchtete Venentransplantat kann Patienten direkt implantiert werden.


• CustomizedGlassware, Stands and PTFE products









en kann. Diese Venen werden durch die Kombination normaler Zellen mit dem patentierten Biomaterial des Unternehmens in einem mikrofluidischen Verfahren hergestellt. Sobald sich das gewünschte Gewebe gebildet hat, werden sowohl die Zellen als auch das Gerüst entfernt. Zurück bleibt ein Implantat, das aus menschlicher extrazellulärer Matrix besteht, dem Hauptbestandteil natürlicher Gewebe. Das so
Was ist chronische venöse Insuffizienz?
Das Technologie-Innovationszentrum CSEM ist auf die Entwicklung von standardisierten Gewebezucht-Plattformen spezialisiert. Die Expertinnen und Experten arbeiteten mit den Skandinaviern zusammen, um einen Bioreaktor zu entwerfen und zu validieren, der diese Gewebeimplantate skaliert herstellen kann. Der Bioreaktor ermöglicht den
Zu einer schweren chronischen venösen Insuffizienz (CVI) kann es kommen, wenn die Klappen in den Beinvenen nicht richtig funktionieren, wodurch das Blut zurückfliesst und sich in den Venen staut. Die Krankheit, unter der Millionen von Menschen auf der ganzen Welt leiden, kann Symptome wie Krampfadern, Schmerzen, Schwellungen, Ödeme, Krämpfe und wiederkehrende Geschwüre verursachen. Synthetische Implantate oder Stents haben bisher versagt, da sie zu thrombotischen Ereignissen im venösen System führen. Die derzeitigen Behandlungsmöglichkeiten beschränken sich auf Kompressionsstrümpfe bis hin zur symptomatischen Wundbehandlung. Doch bis heute gibt es keine wirksame Methode, um schwere CVI-Fälle zu medizinieren.
6 4–5/2024 Fokus
Labortechnik GmbH Thelenberg 6 D‐53567 Asbach Tel. +49 (0) 26 83 / 4 30 94 info@dunnlab.de www.dunnlab.de Visit us in June at the Chemspec Europe 2024 in Düsseldorf!
Dunn
Nachbau der röhrenförmigen Struktur der Venen, die das Blut aus den Organen zurück zum Herzen transportieren. Durch die Kombination aus einem Gerüst, biokompatiblen Membranen und 3-D-Druck mit biokompatiblen Harzen konnte das CSEMTeam die Form für die Herstellung von Röhren wie Venen entwickeln und eine Reihe von künstlichen Geweben mit einer Länge von rund zehn Zentimeter und einem Durchmesser von zirka einem Zentimeter herstellen.
Erste vorklinische Ergebnisse von Clexbio zeigen, dass die Implantate bei den Patienten nach der Einpflanzung keine Immunreaktion auslösen. Stattdessen werden sie von den eigenen Zellen des Patienten besiedelt und verwandeln sich in funktionelles Gewebe, das sich in den Körper integriert und mit ihm wächst –eine regenerative Lösung und ein möglicher Durchbruch in der modernen Medizin.
Hightech Bioproduktionssystem
Ziel des «Supervene»-Projekts war es, standardisierte und automatisierte Herstellungsverfahren für die regenerative Medizin zu entwickeln, die vom Labor in den klinischen Bereich übergehen. «Vivoset ist eine neue Technologie, die das unglaubliche Potenzial neuartiger Zelltherapien freisetzen kann», sagt Stéphanie Boder-Pasche, Senior Project Manager in Cell Microtechnologies am CSEM. Ihr Kollege Gilles Weder, Leiter der Abteilung Forschung & BD in Life Science Technologies am CSEM, ergänzt: «Für die Herstellung solch revolutionärer Implantate benötigen wir ein geschlossenes hightech Bioproduktionssystem, das automatisiert funktioniert.» Die Venen reifen über einige Wochen in einer sterilen Umgebung, automatisiert umströmt von Medien für die Sauerstoff- und Nährstoffversorgung.

Für Armend Håti, CEO und Mitbegründer von Clexbio, ist dies ein wichtiger Meilenstein: «Die Verwendung eines geschlossenen Systems zur Herstellung der Venentransplantate verringert das Risiko einer Kontamination, gewährleistet Produktqualität und -sicherheit.» Darüber hinaus werde die Einhaltung gesetzlicher Vorschriften erleichtert. «Dies ist eine wichtige Voraussetzung dafür, dass wir in Zukunft Studien am Menschen durchführen und das Produkt unter GMP-Bedingungen im grossen Massstab vermarkten können.»
NEXT
Weitere vorklinische Tests
Nach der Basisentwicklung des Systems wird Clexbio jetzt weitere vorklinische Tests an grösseren Tiermodellen durchführen, um Daten über die Funktionsfähigkeit der biotechnologisch hergestellten Venenimplantate im Herz-Kreislauf-System zu sammeln, einschliesslich ihrer Fähigkeit, sich mit den eigenen Zellen des Wirts zu besiedeln.
www.csem.ch
www.clexbio.com

Die neuen Unistate® überzeugen mit noch mehr Präzision und Effizienz und bringen Ihre Temperierprojekte auf das nächste Level.

Besuchen Sie uns! Halle 4.0, G26

Jetzt auch erhältlich als Green Line-Modelle mit CO2 als natürliches Kältemittel!

Die nächste Unistat-Generation schlägt ein neues Kapitel in der hochpräzisen Temperierung auf. Die neuen Modelle überzeugen durch ein reduziertes Füllvolumen für noch mehr Leistung, sowie dichtungsfreie, magnetgekuppelte Umwälzpumpen und erweiterte Sicherheitsstandards.
www.huber-online.com

7 4–5/2024 Fokus
Eine Reihe von Bioreaktoren zur Züchtung von Venentransplantaten, entwickelt von CSEM und Clexbio. (Bild: CSEM)
GENERATION T hermodynamics Das ORIGINAL neu gedacht!
Inspired by temperature
Neue Strategie zur Beurteilung der Anwendbarkeit von Reaktionen
Substrate objektiv auswählen
Unbewusster Voreingenommenheit vorbeugen: An der Universität Münster wurde ein computergestütztes Verfahren entwickelt, mit dem subjektive Verzerrungen in Studien zur Herstellung neuer chemischer Verbindungen vermieden werden sollen.
Chemikerinnen und Chemiker entwickeln und optimieren neue chemische Reaktionen häufig an sogenannten Modellsystemen, das heisst an einfachen, leicht zugänglichen Substraten. Anschliessend zeigen sie beispielhaft an bis zu etwa 100 anderen Substraten, dass die Reaktion funktioniert. Diese Demonstration vielseitiger Anwendbarkeit heisst im Fachjargon «Scope». Durch eine subjektive Auswahl der Substrate entsteht jedoch häufig ein verzerrtes Bild der Anwendungsbreite der neu entwickelten Reaktion. Oft ist unklar, ob sie zur Synthese eines gewünschten Produktes genutzt werden kann. Eine Forschungsgruppe um den Chemiker Prof. Dr. Frank Glorius von der Universität Münster schlägt daher eine Möglichkeit vor, die Modellsubstrate zur Evaluation einer neuen chemischen Reaktion computergestützt –und somit unvoreingenommen – auszuwählen.

Das Team um Prof. Dr. Frank Glorius überführte alle zugelassenen pharmazeutischen Wirkstoffe in einen digitalen Code. (Grafik: Uni MS – Debanjan Rana/Glorius Group).
Die Auswahl der Substrate orientiert sich an der Komplexität und den strukturellen Eigenschaften echter pharmazeutischer Verbindungen. «Unsere Methode zielt darauf ab, die Qualität und den Informationsgehalt chemischer Reaktionsdaten künftig zu verbessern und Wissenslücken zu schliessen», betont Glorius. Ein vertieftes Verständnis neuer Reaktionen senke die Barrieren für deren Anwendung sowohl im akademischen als auch im industriellen Kontext. Die Verfügbarkeit hochwertiger, unvoreingenommen generierter Daten erleichtere darüber hinaus den Einsatz von maschinellem Lernen signifikant und ebne den Weg für eine umfassendere Nutzung der Daten. Die Arbeit wurde in der Fachzeitschrift veröffentlicht.
Unsere Kompetenz:
VTT AG
Hardstrasse 47
CH - 4132 Muttenz
Tel. +41 (0)61 717 98 98
info@vtt-group.com www.vtt-group.com


Einweg-Schutzbekleidung
- Vlieskittel
- Kopfschutzhauben - Überschuhe - Mundschutz


Flexible Verpackungen
- Food / Non Food
- Pharma / Chemie
- Agro
8 4–5/2024 Chemie
«Wir möchten ein Umdenken anstossen» Versuche, die Entwicklung und Evaluierung von chemischen Reaktionen zu standardisieren und zu objektivieren, seien noch ziemlich neu und nicht weit verbreitet. «Wir möchten mit unserer Publikation einen Umdenkprozess anstossen. Statt möglichst vielen Experimenten, die oft voreingenommen geplant sind oder einen vorab ersichtlichen Ausgang haben, sollte der bestmögliche Informationsgewinn über neue chemische Reaktionen im Vordergrund stehen», sagt Erstautor Debanjan Rana.
Chemikerinnen und Chemiker wählen Substrate, die strukturell einfach, dem Modellsubstrat ähnlich oder schlichtweg gerade im Labor verfügbar sind. Erfolglose Reaktionen erwähnen sie in ihrer Publikation häufig überhaupt nicht, um ein besseres Bild abzugeben.»
Niklas Hölter
Universität Münster
Auch andere Wissenschaftler haben bereits versucht, chemische Reaktionen anhand von «besser» ausgewählten Substraten zu bewerten. Diese Arbeiten beschränkten sich jedoch auf Spezialfälle – entweder auf fest ausgewählte Strukturen mit pharmazeutischer Relevanz oder auf speziell für eine einzige Reaktion zugeschnittene Strukturen, die jedoch in einem aufwändigen Verfahren berechnet und ausgewählt werden müssen. Im Gegensatz zu den vorhergegangenen Arbeiten berücksichtigt die an der Universität Münster vorgestellte Methode die gesamte Struktur eines Moleküls. Sie ist somit universell für jede chemische Reaktion anwendbar.
Mitautor Niklas Hölter unterstreicht, dass der Scope von zentraler Bedeutung in allen Publikationen der chemischen Synthese sei. «Chemikerinnen und Chemiker
treffen die Auswahl der zu testenden SubstratVerbindungen aber häufig voreingenommen», ergänzt er. «Beispielsweise wählen sie Substrate, die strukturell einfach, dem Modellsubstrat ähnlich oder schlichtweg gerade im Labor verfügbar sind. Erfolglose Reaktionen erwähnen sie in ihrer Publikation häufig überhaupt nicht, um ein besseres Bild abzugeben.»
In chemisch sinnvolle Regionen eingeteilt
Bei der Synthese von neuen chemischen Verbindungen, beispielsweise Wirkstoffe oder Materialien, müssen Chemikerinnen und Chemiker aus einer grossen Anzahl bekannter chemischer Reaktionen und Methoden diejenige auswählen, die zur Herstellung der Zielverbindung am besten geeignet ist. Hierfür berücksichtigen sie mehrere Faktoren wie die Ausbeute des gewünschten Produktes sowie umweltund sicherheitstechnische Aspekte. Die Entwicklung neuer, vielseitig einsetzbarer chemischer Reaktionen ist daher nach wie vor ein Schwerpunkt aktueller chemischer Forschung.
Über die Methode
Die Forschungsgruppe der Universität Münster überführte mittels sogenannter molekularer Fingerprints alle zugelassenen pharmazeutischen Wirkstoffe in einen digitalen Code. Mit nicht überwachtem maschinellen Lernen und ClusteringMethoden entwickelten sie ein Modell, das diesen «Raum» pharmazeutischer Wirkstoffe in chemisch sinnvolle Regionen einteilt, basierend auf den Molekülstrukturen.
Zur Evaluation einer neuen chemischen Reaktion lassen sich tausende potenzieller TestSubstrate mithilfe des Machine Learning Modells in denselben Raum hineinprojizieren. Aus dem Zentrum jeder der zuvor identifizierten Regionen wird automatisiert ein TestSubstrat ausgewählt, um den gesamten Raum ohne «Bias» abzudecken.

Mein
ERP. Damit habe ich alles im Griff.
Effizienz, Transparenz, Flexibilität – darauf kommt es jetzt an. Die IT ist der Schlüssel dafür. Ob ERP, MES, Rückverfolgung oder intelligente Planungssoftware: das CSBSystem ist die Komplettlösung für die Prozessindustrie. Damit können Sie heute Ihre Produktion optimieren und morgen Ihren ganzen Betrieb digitalisieren.
www.uni-muenster.de
Mehr über unsere Lösungen für die Prozessindustrie: www.csb.com

9 4–5/2024
Schritt identifiziert, der photochemische Reaktionen begrenzt
Die Effizienz von Photochemie beeinflussen
Forschende der Universität Basel zeigen, wie sich die Energieeffizienz von photochemischen Reaktionen um das Zehnfache steigern liesse. Nachhaltigere und kostengünstigere Anwendungen rücken damit in greifbare Nähe.
Die herkömmliche Produktion von Medikamenten, Kunststoffen oder Düngemittel braucht Hitze für die chemischen Reaktionen. Diese erfolgen im industriellen Rahmen meist in mehreren Etappen über verschiedene Zwischenprodukte. Bei der Photochemie liefert hingegen Licht die Energie – und der Weg zum gewünschten Produkt erfordert oft weniger Zwischenschritte. Zudem erlaubt es die Photochemie, mit weniger gefährlichen Substanzen als in der herkömmlichen Chemie zu arbeiten: Mit Licht lassen sich Substanzen zur Reaktion bringen, die unter Hitze nicht gut reagieren können. Dennoch gibt es bis jetzt nicht viele industrielle Anwendungen von Photochemie, unter anderem weil die Energiezufuhr mit Licht oft ineffizient ist oder unerwünschte Nebenprodukte entstehen.
Die Forschungsgruppe von Prof. Dr. Oliver Wenger beschreibt in der Fachzeitschrift Nature Chemistry ein grundlegendes Prinzip, das die Energieeffizienz von Photochemie unerwartet stark beeinflusst und die Geschwindigkeit von photochemischen Reaktionen erhöhen kann.
Bei einer solchen Reaktion befinden sich die Ausgangs-Moleküle in einer flüssigen Lösung. Erhalten sie Energie in Form von Licht, können sie miteinander Elektronen austauschen und sogenannte Radikale bilden. Diese extrem reaktionsfreudigen Moleküle entstehen immer paarweise und bleiben dabei umgeben vom Lösungsmittel, welches die Radikalpaare umschliesst wie eine Art Käfig. Damit die Radikale zu den gewünschten Zielprodukten weiterreagieren können, müssen sie aus diesem Käfig «ausbrechen» und ausserhalb davon einen Reaktionspartner finden. Die Forschenden um Wenger und seine Postdoktorandin Dr. Cui Wang haben dieses Ausbrechen als entscheidenden Schritt identifiziert, der die Energieeffizienz und


Durch Licht erzeugte Radikale können ihre Reaktivität erst entfalten, sobald sie aus einer Art «Käfig» ausbrechen, den das Lösungsmittel um sie herum bildet. (Illustration: Universität Basel, Jo Richers)
die Geschwindigkeit von photochemischen Reaktionen begrenzt.
Radikale büxen aus
Solange die Radikale paarweise im Lösungsmittelkäfig verbleiben, können sie miteinander spontan zu den Ausgangsstoffen zurückreagieren. Diese Rückreaktion verschwendet Energie, weil sie das bereits aufgenommene Licht nur dazu braucht, um wieder zum Startpunkt zu gelangen. Die Basler Forschungsgruppe konnte diese Rückreaktion verlangsamen und damit den Radikalen mehr Zeit geben, den Käfig zu verlassen. Je langsamer die ungewollte Rückreaktion wurde, desto mehr Radikale konnten ausbrechen, und desto energieeffizienter und schneller entstanden die gewünschten Zielprodukte.
Für ihre Studie verwendete Cui Wang, die mittlerweile eine Juniorprofessur an der Universität Osnabrück (D) innehat, zwei bestimmte Farbstoffe: Beide nehmen Licht auf und speichern dessen Energie für eine kurze Zeit, bevor sie es zur Bildung von Radikalpaaren verwenden. Einer der beiden untersuchten Farbstoffe konnte je -
doch deutlich mehr Energie speichern und auf die Radikale übertragen als der andere. Aufgrund der zusätzlichen Energie konnten die Radikale den Lösungsmittelkäfig bis zu zehnmal effizienter verlassen. In der Folge entstanden auch die Zielprodukte mit bis zu zehnmal höherer Energieeffizienz. «Dieser direkte Zusammenhang zwischen dem Ausbrechen der Radikale aus dem Lösungsmittelkäfig und der effizienteren Bildung der Zielprodukte ist erstaunlich klar», sagte Cui Wang.
Farbstoffe sind entscheidend
Die entscheidende Erkenntnis: Einzelne Farbstoffe können pro aufgenommener Lichtmenge mehr Radikale freisetzen als andere. «Über die Wahl des Farbstoffs lässt sich also die Energieeffizienz von photochemischen Reaktionen steigern», betont Oliver Wenger. Die Energieeffizienz sei wiederum ein mitentscheidendes Kriterium für die industrielle Verwendung von Photochemie.
www.unibas.ch
10 4–5/2024 Chemie
Parasiten erkennen Zucker auf roten Blutkörperchen
Mechanismus der Malaria-Invasion enthüllt
Eine Entdeckung gibt Aufschluss darüber, wie der Malariaparasit Plasmodium falciparum in menschliche rote Blutkörperchen eindringt. Eine Studie des Schweizerischen Tropen- und Public Health-Instituts und der Griffith University (Australien) enthüllt die Rolle eines Zuckers namens Sialinsäure bei diesem Invasionsprozess. Die Ergebnisse haben Auswirkungen auf die Entwicklung von Impfstoffen und Medikamenten gegen Malaria.
Mit 249 Mio. Malariafällen und 608 000 Todesfällen im Jahr 2022 bleibt Malaria eine ungelöste globale Gesundheitsbedrohung. Der Malariaparasit Plasmodium falciparum ist die Hauptursache der schweren Malaria und für die meisten Malariatodesfälle verantwortlich. Alle klinischen Symptome der Malaria werden durch die Vermehrung der Malariaerreger in den roten Blutkörperchen verursacht. Es ist zwar bekannt, dass P. falciparum in die roten Blutkörperchen des Menschen eindringt, aber die genauen Ziele, an die sich der Parasit bindet, waren bisher nicht bekannt. Man wusste zwar, dass das Malariaprotein, das cysteinreiche protektive Antigen (CyRPA), für die Invasion der roten Blutkörperchen essentiell ist, aber welche Rolle es dabei genau spielt, war nicht geklärt.
Eine multidisziplinäre Forschungsgruppe aus sechs Institutionen unter der Leitung des Schweizerischen Tropen- und Public HealthInstituts (Swiss TPH) und des Institute for Glycomics in Australien hat die Bindungseigenschaften von CyPRA untersucht. Die Forschenden entdeckten, dass ein Zucker namens Sialinsäure eine Schlüsselkomponente auf der Oberfläche roter Blutkörperchen ist, die vom Malariaparasiten erkannt wird und für den Invasionsprozess unerlässlich ist. Die Ergebnisse wurden in der Fachzeitschrift Cell Reports veröffentlicht. «Wir zeigen, dass sich P. falciparum CyRPA an eine spezifische Kohlenhydratstruktur (Glykan) auf der Oberfläche der roten Blutkörperchen bindet. Das CyRPA-Protein ist hochgradig angepasst, um an ein Glykan zu binden, das mit einer Sialinsäure endet.

(Grafik: Cell Reports, https://doi.org/10.1016/j.celrep.2024.114012)
Die Entdeckung der Schlüsselfunktion von CyRPA bei der Invasion von Wirtszellen liefert eine Erklärung für die parasitenhemmende Wirkung von CyRPA-spezifischen Antikörpern», erklärt Gerd Pluschke vom Swiss TPH und Mitautor der Publikation. «Der Mensch unterscheidet sich von anderen Primaten dadurch, dass er nur einen Typ von Sialinsäure, Neu5Ac genannt, produzieren kann. Dieser genetische Unterschied zwischen dem Menschen und seinen engsten Verwandten wird seit langem für die artspezifische Anpassung von Malariaparasiten verantwortlich gemacht. In dieser Studie zeigen wir, dass die menschliche Form der Sialinsäure, Neu5Ac, vom human-spezifischen Malariaparasiten P. falciparum stark bevorzugt wird, was die Anpassung dieses Parasiten an den Menschen erklären könnte», sagte Michael Jennings vom Institute for Glycomics und Mitautor der Studie.
Impfstoffe, die auf die prä-erythrozytären Stadien von P. falciparum abzielen, sind zugelassen. Sie zeigen jedoch nur eine mässige Wirksamkeit. Es gibt keinen zugelassenen Impfstoff gegen das Blutstadium der Malaria, aber es wird intensiv an Impfstoffen gegen das Blutstadium geforscht.
«Die Entdeckung der Schlüsselfunktion von CyRPA bei der Invasion von Wirtszellen unterstützt das Konzept, CyRPA als Ziel für einen Impfstoff gegen das Blutstadium klinisch zu testen», so Pluschke.
«Die essentielle Bindungsaktivität von CyRPA an ein spezifisches Glykan bestätigt CyRPA auch als Wirkstoffziel. Und wie wir in unserer Studie zeigen, können kleinmolekulare Inhibitoren, die in diese Funktion eingreifen, die Malariareplikation hemmen», so Jennings.
www.swisstph.ch

11 4–5/2024 Biowissenschaften
Von Ballaststoffen, Primaten und Nutztieren
Über den Verlust gesunder Darmmikroben
Ballaststoffe sind gesund. Eine neue Studie diverser internationaler Akteure kommt zum Schluss, dass Menschen in industrialisierten Gesellschaften aber jene Mikroben verlieren, die Ballaststoffe in der Nahrung für einen gesunden Verdauungstrakt verwandeln.
Ballaststoffe sind Zellulose, der faserige Stoff, aus dem Pflanzen bestehen: Blätter, Stängel, Wurzeln, Halme und Baumstämme. Sie stammen aus Gemüse oder Vollkornprodukten und tragen dazu bei, dass unser Darmmikrobiom gesund und ausgeglichen bleibt. Ballaststoffe dienen als Ausgangspunkte für eine natürliche Nahrungskette. Am Anfang stehen Bakterien, die Zellulose verdauen und dem Rest unseres Mikrobioms eine ausgewogene Ernährung bieten.
Dass die Ernährungsgewohnheiten in Industriegesellschaften weit von denen der Menschen in der Antike entfernt sind, wirkt sich offenbar auf unsere Darmflora aus. Denn neu entdeckte, zelluloseabbauende Bakterien aus dem menschlichen Darmmikrobiom verschwinden, insbesondere in den Industriegesellschaften. Zu diesem Schluss kommt eine in der Fachzeitschrift Science publizierte Studie der
Ein Guter Tipp
Laborchemikalien
Bioanalytik
Chromatographie
Filtration
Industriestrasse 7
CH-5522 Tägerig
Tel.05648170 60
Fax 056 48170 68 www.egtchemie.ch


Dass die Ernährungsgewohnheiten in Industriegesellschaften weit von denen der Menschen in der Antike entfernt sind, wirkt sich offenbar auf unsere Darmflora aus. (Bild: Shutterstock)
Forschungsgruppe um Prof. Itzhak Mizrahi an der Ben-Gurion-Universität (BGU) des Negev (Israel), mit Unterstützung des Weizmann Institute of Science (Israel) und internationalen Mitarbeitenden in den USA und Prof. Dr. William Martin, Evolutionsbiologe an der Heinrich-Heine-Universität Düsseldorf und Mitautor.
Wie Baumstämme im Schwimmbad
«Im Laufe der menschlichen Evolution waren Ballaststoffe immer ein Hauptbestandteil der menschlichen Ernährung», erklärt die leitende Forscherin Sarah Moraïs von der BGU, «sie sind auch ein Hauptbestandteil der Ernährung unserer Primatenvorfahren.» Moraïs und ihr Team identifizierten wichtige neue Mitglieder des menschlichen Darmmikrobioms: zelluloseabbauende Bakterien namens Ruminococcus. Diese Bakterien bauen Zellulose ab, indem sie grosse und hochspezialisierte extrazelluläre Proteinkomplexe, so genannte Zellulosomen, produzieren. «Es ist keine leichte Aufgabe, Zellulose abzubauen, und nur wenige Bakterien sind
dazu in der Lage», erklärt Ed Bayer vom Weizmann-Institut, einer der weltweit führenden Forscher auf dem Gebiet der Cellulosomen und Mitautor. «Zellulose ist schwer zu verdauen, weil sie unlöslich ist. Ballaststoffe im Darm sind wie ein Baumstamm in einem Schwimmbad: Sie werden nass, aber sie lösen sich nicht auf.» Cellulosomen werden von Bakterien so konstruiert, dass sie sich an Cellulosefasern anlagern und diese auseinanderziehen, wie die einzelnen Fäden eines Seils. Die cellulosomalen Enzyme zerlegen dann die einzelnen Faserfäden in kürzere Ketten, die dann löslich werden. Sie können nicht nur von Ruminococcus, sondern auch von vielen anderen Mitgliedern des Darmmikrobioms verdaut werden. «Unterm Strich verwandeln Cellulosomen Ballaststoffe in Zucker, die eine ganze Gemeinschaft ernähren – eine beachtliche technische Leistung», sagt Bayer. Die Produktion von Cellulosomen stellt Ruminococcus an die Spitze der Faserabbaukaskade, die ein gesundes Darmmikrobiom ernährt. Aber die Evolutionsgeschichte von Ruminococcus ist kompliziert, und die
12 4–5/2024 Biowissenschaften

westliche Kultur fordert ihren Tribut von unserem Mikrobiom, wie diese neue Studie zeigt.
Mikrobiom-Bestandteile von Nutztieren übernommen?
«Diese Cellulosom-produzierenden Bakterien gibt es schon lange, ihre Vorfahren sind wichtige Mitglieder des Pansenmikrobioms von Kühen und Schafen», erklärt Prof. Mizrahi von der BGU, Experte für Pansenbiologie und Hauptautor. Der Pansen ist das spezielle Magenorgan von Kühen, Schafen und Hirschen, in dem das von ihnen gefressene Gras durch zelluloseabbauende Mikroben, darunter Ruminococcus, in nützliche Nahrung umgewandelt wird. «Wir waren überrascht zu sehen, dass die zuellulose-produzierenden Bakterien des Menschen im Laufe der Evolution offenbar den Wirt gewechselt haben, denn die Stämme des Menschen sind enger mit den Stämmen von Nutztieren verwandt als mit den Stämmen unserer eigenen Primatenvorfahren», erklärt Prof. Mizrahi. «Es sieht so aus, als hätten die Menschen wichtige Bestandteile eines gesunden Darmmikrobioms von Nutztieren übernommen, die sie schon früh in der menschlichen Evolution domestiziert haben. Möglich wäre das.»
Doch damit ist die Geschichte noch nicht zu Ende. Die Beprobung menschlicher Kohorten ergab, dass Ruminococcus-Stämme tatsächlich robuste Bestandteile des menschlichen Darmmikrobioms in menschlichen Jäger- und Sammlergesellschaften und in ländlichen Gesellschaften sind, dass sie aber in Probanden aus industrialisierten Gesellschaften spärlich vorkommen oder fehlen. «Unsere Vorfahren in Afrika vor 200 000 Jahren haben ihr Mittagessen nicht im Drive-In geholt oder sich eine Pizza nach Hause liefern lassen», sagt Evolutionsbiologe William Martin von der Heinrich-Heine-Universität Düsseldorf. In den westlichen Gesellschaften ist dies jedoch weit verbreitet. In den industrialisierten Gesellschaften, die sich immer weiter von den landwirtschaftlichen Betrieben entfernt haben, in denen die Lebensmittel erzeugt werden, ändert sich die Ernährung. Diese Abkehr von einer ballaststoffreichen Ernährung ist eine mögliche Erklärung für den Verlust wichtiger zelluloseabbauender Mikroben in unserem Mikrobiom, schlussfolgern die Autoren. Wie kann man diesem evolutionären Rückgang entgegenwirken? Es könnte helfen, das zu tun, was Ärzte und Ernährungswissenschaftler schon seit Jahrzehnten empfehlen: Mehr Ballaststoffe essen.
www.hhu.de

Prozesse verbessern ist wie Rennradfahren. Mit einem ausdauernden Partner läuft alles effizienter.
Energieoptimierung ist der Schlüssel zu einer nachhaltigen Produktion. Als Ihr starker Partner für strategisches Energiemanagement helfen wir Ihnen, mit steigenden Energiekosten und strengeren Umweltzielen umzugehen. Wir sind an Ihrer Seite – und zeigen Ihnen Wege auf, wie Sie Energie einsparen und ressourcenschonend arbeiten können, ohne auf Sicherheit, Qualität, Zuverlässigkeit und Betriebszeit verzichten zu müssen.
Erfahren Sie mehr unter www.ch.endress.com

13 4–5/2024 Biowissenschaften
Clostridium clariflavum, ein faserabbauendes Bakterium, das Zellulosefasern mit Hilfe von Zellulosomen abbaut. (Bild: Itzhak Mizrahi)
Branchentrend «grüner und intelligenter»
KI klopft an die Labortüren
Starlab hat 350 Forschende aus den wichtigsten Märkten in Europa befragt und daraus ein Stimmungsbarometer der Laborbranche erstellt. Die Umfrage ist auch für die Schweiz relevant, wo mehr oder weniger die gleichen Themen dominieren: Künstliche Intelligenz, Nachhaltigkeit und Fachkräfte.
Viele Labore in Europa erwarten dieses Jahr nicht nur Wachstum und steigenden Materialbedarf, sondern weiterhin Personalengpässe und steigende Preise für Verbrauchsmaterialien. Trotz dieser Herausforderungen blicken sie optimistisch in die Zukunft. Insbesondere die Life-ScienceBranche ist materiell gut gewappnet: Lieferverzögerungen von Liquid-HandlingProdukten sind nicht mehr vorhanden, der Bedarf an Material steigt. Entsprechend bewerten Labore die Herausforderungen für 2024 anders als in den Vorjahren: Die Angst vor Personalengpässen und die Sorge vor steigenden Preisen beim Verbrauchsmaterial sind zentral.
Branche grün sensibilisiert
Trotz oder gerade wegen der Herausforderungen aus Preisdynamik und Personalmangel öffnen sich die Labore für die beiden Thementrends Nachhaltigkeit und künstliche Intelligenz. 9 von 10 Laboren sind laut der Erhebung von Starlab der Meinung, dass Nachhaltigkeit für Labore immer wichtiger wird. 95 Prozent reduzieren deswegen schon heute Abfall wo möglich, 92 Prozent sparen bewusst Energie und 75 Prozent bestellen grössere Gebindegrössen, um Transportemissionen und Verpackungsmüll zu reduzieren. Mehr als jedes dritte Labor bildet sich zudem regelmässig zu Umweltthemen fort (72 Prozent) oder bestellt nachhaltig produzierte oder wiederverwendbare Produkte. Klaus Ambos, CEO bei Starlab International, sagt: «In der Laborbranche hat innerhalb einer Dekade ein Paradigmenwechsel stattgefunden. Über Jahre haben Einwegprodukte dominiert und mit Blick auf Messgenauigkeit schien es vielen unmöglich, dass jemals Recyclingmaterial Einzug hält. Das ist heute anders. Die Laborpraxis wird immer nachhaltiger.» Sie ist sogar

zum Wettbewerbsfaktor avanciert. «Je mehr Einrichtungen und Unternehmen Klimaneutralität anstreben, desto mehr müssen sich zuliefernde Labore darauf einstellen, ihren ökologischen Fussabdruck zu verbessern», fährt Ambos fort.
«Insgesamt wird es durch KI mehr Fachkräfte brauchen, um das volle Potenzial auszuschöpfen.»
Dr. Moritz Werder, Sales Manager bei Starlab Schweiz
Auf Anfrage von ChemieXtra ergänzt Dr. Moritz Werder, Sales Manager bei Starlab Schweiz: «Nachhaltigkeit ist als Gesamttrend in der Laborpraxis angekommen und entspricht dem Kundenbedürfnis. Schon die ehemalige Life Systems Design AG – und heutige Starlab Schweiz – ist mit ihrem Polypropylen-Re -
cycling-Service bereits vor über 20 Jahren auf viel Zuspruch gestossen.» Da aber Nachhaltigkeit heute gelebte Praxis sei, beschäftige die Labore im Moment vordergründig der Fachkräftemangel.
KI in der Schweiz bedeutender Mit dem Fachkräftemangel verstrickt ist die Anwendung von KI. Aus den von Starlab erhobenen Zahlen lässt sich die Weitsicht der Forschenden lesen, durch digitale Hilfe dem Problem des Fachkräftemangels zu begegnen. 63 Prozent der 306 Befragten glauben, dass KI in Laboren an Relevanz gewinnt. 67 Prozent betrachten KI als Chance und nur 33 Prozent als Risiko. Für Labore sind digital lernende Mitarbeiter nicht mehr wegzudenken. Für 12 Prozent der Umfrageteilnehmer hat maschinelle Intelligenz den Laboralltag bereits massgeblich verändert, 21 Prozent meinen, dass KI jetzt bereits Einzug hält. Eine Mehrheit von 45 Prozent erwartet, dass KI in den nächsten fünf Jahren die Arbeit im Labor massgeblich verändern wird.

14 4–5/2024 Labor
Fachkräftebedarf ist in der Schweiz höher als im europäischen Durchschnitt. (Bild: Envato)
Der

In diesen Bereichen sehen die Befragten Vorteile der künstlichen Intelligenz im Labor. (Grafik: Starlab)
Werder von Starlab Schweiz fährt fort: «In der Schweiz erwarten wir eine Beschleunigung der Forschung durch künstliche Intelligenz. Schon heute zählt das Land zu den führenden Anbietern bei KI-Anwendungen in der Life Science-Branche.» Die Schweizer Laborbranche sei ein hervorragender Nährboden für KI-getriebene Innovationen. «Insgesamt wird es aber durch KI mehr Fachkräfte brauchen, um das volle Potenzial auszuschöpfen. Gerade weil es in der Schweiz so viele florierende Life Science-Unternehmen gibt, ist der Fachkräftebedarf in der Schweiz schon heute höher als im europäischen Durchschnitt. KI wird das weiter verschärfen.»
«Künstliche Intelligenz stellt den Menschen in den Mittelpunkt. Sie ist ein Nährboden für Sinn, Haltung und Leidenschaft in Laboren.»
schungstempo und den Möglichkeiten, Krankheiten zu erkennen und Menschen zu heilen. Selbstlernende Anwendungen unterstützen gleichermassen einfache als auch komplexe Prozesse», erklärt Ambos. «Künstliche Intelligenz stellt den Menschen in den Mittelpunkt. Sie ist ein Nährboden für Sinn, Haltung und Leidenschaft in Laboren.»
Sorgen bei Datenschutz und Ethik
Das Laborpersonal und die Forschenden wissen gleichzeitig um die Grenzen. Am meisten sorgen sich die Befragten um fehlende juristische Regelungen (69 Prozent), gefolgt von Datenschutzbedenken und mangelnder Transparenz (je 68 Prozent). Auch ethische Bedenken, ein befürchteter Kreativitätsverlust oder mangelnde Nachvollziehbarkeit ängstigen die Mehrheit der Befragten. Dass KI-Anwendungen demnächst den Laborjob übernehmen, befürchtet nur eine Minderheit.





















































FAULHABER Applikationen
Klaus Ambos, CEO von Starlab International Made
Gemäss der Umfrage versprechen sich zwar 81 Prozent mehr Effizienz und 63 Prozent Kosteneinsparungen durch KI. Der eigentliche Schub ergibt sich jedoch, weil KI die Arbeit an sich verändert. «Es geht nicht nur um digitale Annehmlichkeiten, Komfort oder Erleichterungen. KI eröffnet eine neue Dimension beim For -
Klaus Ambos fasst zusammen: «KI klopft zweifelsfrei laut und deutlich an die Labortüren. Die Möglichkeitsoptionen werden nicht nur erkannt, sondern genutzt. Nun ist die Politik gefragt», sagt der Geschäftsführer und fordert wettbewerbsfähige Rahmenbedingungen.
ChemieXtra
Quelle: Medienmitteilung Starlab Group


Mit FAULHABER Antriebssystemen erwachsen fantastische Möglichkeiten für Robotik- und Automatisierungsanwendungen in der Agrartechnik.

www.faulhaber.com/agricultural-robotics/de



15 4–5/2024 Labor
to grow your imagination
WE CREATE MOTION
Genf, 11.–14.06.2024 Stand G83
Ersatz für injizierte oder intravenöse Therapien
Zyklische Peptide für orale Arzneimittel
Forschende an der EPFL haben stabile, oral verfügbare zyklische Peptide entwickelt, die eine viel höhere Bioverfügbarkeit aufweisen als herkömmliche Peptide. Mit diesen könnte eine neue Generation von Medikamenten für bisher unbehandelbare Krankheiten hervorgebracht werden.
Nik Papageorgiou ¹
Seit Jahrzehnten ist eine grosse Anzahl von Proteinen, die für die Behandlung verschiedener Krankheiten von entscheidender Bedeutung sind, für eine orale Arzneimitteltherapie nicht zugänglich. Herkömmliche kleine Moleküle haben oft Schwierigkeiten, an Proteine mit flachen Oberflächen zu binden, oder sie müssen spezifisch für bestimmte Proteinhomologe sein. Grössere Biologika, die auf diese Proteine abzielen, müssen in der Regel injiziert werden, was die Patientenfreundlichkeit und Zugänglichkeit einschränkt.
In einer neuen Studie, die in der Fachzeitschrift Nature Chemical Biology veröffentlicht wurde, haben Forschende im Labor von Prof. Christian Heinis an der EPFL einen Meilenstein in der Arzneimittelentwicklung erreicht. Ihre Forschung öffnet die Tür zu einer neuen Klasse von oral verfügbaren Medikamenten und löst damit ein langjähriges Problem der Pharmaindustrie. «Es gibt viele Krankheiten, für die zwar die Targets identifiziert wurden, für die aber keine Medikamente entwickelt werden konnten, die diese Targets binden und erreichen», sagt Heinis. «Die meisten von ihnen sind Krebsarten, und viele Ziele in diesen Krebsarten sind Protein-ProteinInteraktionen, die für das Tumorwachstum wichtig sind, aber nicht gehemmt werden können.»
Die Studie konzentrierte sich auf zyklische Peptide, die vielseitige Moleküle sind. Diese sind bekannt für ihre hohe Affinität und Spezifität bei der Bindung an anspruchsvolle Krankheitsziele. Gleichzeitig hat sich die Entwicklung zyklischer Peptide als orale

Chemische Struktur eines zyklischen Peptides, das mit einer neuen Methode entwickelt wurde und in Tiermodellen eine gute orale Verfügbarkeit aufgewiesen hat. (Bild: C. Heinis, EPFL)
Arzneimittel als schwierig erwiesen, da sie schnell verdaut oder vom Magen-DarmTrakt schlecht aufgenommen werden. «Zyklische Peptide sind für die Arzneimittelentwicklung von grossem Interesse, da diese Moleküle an schwierige Zielstrukturen binden können, für die es schwierig war, mit etablierten Methoden Medika -
mente zu entwickeln», erklärt Heinis. «Doch die zyklischen Peptide können in der Regel nicht oral, als Pille, verabreicht werden, was ihre Anwendung enorm einschränkt.»
Zyklischer Durchbruch
Die Forschungsgruppe nahm das Enzym Thrombin ins Visier, das aufgrund seiner zentralen Rolle bei der Blutgerinnung ein kritisches Krankheitsziel darstellt: Die Regulierung von Thrombin ist der Schlüssel zur Vorbeugung und Behandlung thrombotischer Erkrankungen wie Schlaganfälle und Herzinfarkte.
Um zyklische Peptide zu erzeugen, die gegen Thrombin gerichtet und ausreichend stabil sind, entwickelten die Forschenden eine zweistufige kombinatorische Synthesestrategie, um eine umfangreiche Bibliothek zyklischer Peptide mit Thioetherbindungen zu synthetisieren, die ihre metabolische Stabilität bei oraler Einnahme erhöhen.
«Es ist uns nun gelungen, zyklische Peptide zu erzeugen, die an ein Krankheitsziel unserer Wahl binden und auch oral verab -
Ein EPFL-Spin-off erhält 26 Millionen Euro
Die von Prof. Christian Heinis und Sevan Habeshian an der EPFL entwickelte Technologie für die Herstellung von oral verfügbaren zyklischen Peptiden wird vom EPFL-Spinoff Orbis Medicines, das orale makrozyklische Arzneimittel erforscht, kommerziell genutzt. Das Lausanner Unternehmen hat Ende Februar den Start einer 26-MillionenEuro-Finanzierung bekanntgegeben für die Erweiterung und Weiterentwicklung makrozyklischer Arzneimittel, sogenannten «nCycles». Makrozyklen sind eine grosse und vielfältige Familie von Verbindungen mit äusserst wünschenswerten therapeutischen Eigenschaften, die durch das Vorhandensein einer zyklischen Struktur definiert sind. Die nCycles werden systematisch so entwickelt, dass sie oral bioverfügbar und membrandurchlässig sind.
ChemieXtra
www.orbismedicines.com

16 4–5/2024 Medizin
EPFL
ins Deutsche: ChemieXtra
1
Übersetzung

«Es ist uns nun gelungen, zyklische Peptide herzustellen, die an ein Krankheitsziel unserer Wahl binden und auch oral verabreicht werden können.» Prof. Christian Heinis, EPFL Lausanne (Bild: EPFL)
reicht werden können», sagt Heinis. «Dazu haben wir eine neue Methode entwickelt, bei der Tausende von kleinen zyklischen Peptiden mit zufälligen Sequenzen im Nanomassstab chemisch synthetisiert und in einem Hochdurchsatzverfahren untersucht werden.»
Zwei Schritte, ein Topf
Das neue Verfahren besteht aus zwei Schritten und findet im selben reaktiven Behälter statt, von Chemikern auch als «One Pot» bezeichnet. In einem ersten Schritt werden lineare Peptide synthetisiert, die dann in einem chemischen Prozess eine ringförmige Struktur bilden, also «zyklisiert» werden. Dazu werden «biselektrophile Linker» – chemische Verbindungen, die zwei Molekülgruppen miteinander verbinden – verwendet, um stabile Thioether-Bindungen zu bilden. In der zweiten Phase werden die zyklisierten Peptide einer Acylierung unterzogen, einem Prozess, bei dem Carbonsäuren an sie angehängt werden, wodurch sich ihre Molekularstruktur weiter verändert. Die Technik macht Zwischenreinigungsschritte überflüssig und ermöglicht ein Hochdurchsatz-Screening direkt in den Syntheseplatten, wobei die Synthese und das Screening Tausender von Peptiden kombiniert werden, um Kandidaten mit hoher Affinität für bestimmte Krankheitsziele – in diesem Fall Thrombin – zu identifizieren. Mit dieser Methode hat der Manuel Merz, Doktorand an der EPFL und Projektleiter, eine umfassende Bibliothek von 8448 zyklischen Peptiden mit einer durchschnittlichen Molekülmasse von etwa 650 Dalton erstellt, die nur wenig über der für oral verfügbare kleine Moleküle empfohlenen Höchstgrenze von 500 Dalton liegt. Die

Chemische Reaktionen zur Synthese von zyklischen Peptidbibliotheken im Nanomassstab. (Bild: EPFL)
zyklischen Peptide zeigten auch eine hohe Affinität für Thrombin.
Bei Tests an Ratten wiesen die Peptide eine orale Bioverfügbarkeit von bis zu 18 Prozent auf, das heisst, wenn das zyklische Peptidmedikament oral eingenommen wird, gelangen 18 Prozent davon erfolgreich in den Blutkreislauf, sodass eine therapeutische Wirkung erzielt werden kann.
Ziele setzen
Durch die «orale Verfügbarkeit» von zyklischen Peptiden werden Möglichkeiten zur Behandlung von diversen Krankheiten eröffnet, die mit herkömmlichen oralen Medikamenten nur schwer zu behandeln sind. Die vielseitige Methode kann an eine breite Palette von Proteinen angepasst werden, was zu einem Durchbruch in Bereichen führen könnte, in denen der medizinische Bedarf derzeit nicht gedeckt ist. «Um die Methode auf anspruchsvollere Krankheitsziele wie Protein-Protein-Interaktionen anzuwenden, müssen wahrscheinlich grössere Bibliotheken synthetisiert und untersucht werden», ergänzt Merz. «Durch die Automatisierung weiterer Schritte der Methode scheinen Bibliotheken mit mehr als einer Million Molekülen in Reichweite zu sein.»
In einem nächsten Projektschritt nehmen die Forschenden mehrere intrazelluläre Protein-Protein-Interaktionsziele ins Visier, für die es bisher schwierig war, Hemmstoffe auf der Basis klassischer kleiner Moleküle zu entwickeln. Sie sind zuversichtlich, dass zumindest für einige von ihnen oral anwendbare zyklische Peptide entwickelt werden können.
Für flammenlose Druckentlastung und kompakte
Explosionsentkopplung.

Entkopplung von Explosionen, Funken und Flammenfronten: das EXKOP® System von REMBE® ist eine sichere, kostengünstige und unkomplizierte Entkopplung für staubführende Anlagen.

Explosionsdruckentlastung ohne Flammen- und Staubausbreitung: mit dem REMBE® Q-Rohr® können Apparate und Behälter innerhalb von geschlossenen Räumen druckentlastet werden.
8703 Erlenbach Telefon 044 910 50 05 www.paliwoda.ch
Offizieller Partner der
www.epfl.ch

17 4–5/2024 Medizin
R-KB

Nassisolierung, Fraktionierung und NIR gefragt
Alternative Proteine treiben Food-Bereich an
Aktuelle gesellschaftliche Entwicklungen im Food-Bereich wirken sich unmittelbar auf lebensmittelchemische Prozesse aus. Ein Beispiel stellt der Trend zu alternativen Proteinen dar.
Welch hoher Stellenwert Produkten aus diesem Bereich zukommen könnte, hat unlängst die Bühler AG mit ihrem neuen Proteinanwendungszentrum in Uzwil gezeigt. Der Lebensmittel-Prozess-Spezialist will hier die Entwicklung von Verfahren zur Herstellung von Nahrungsmitteln auf pflanzlicher Basis fördern, darunter Fleischund Fischersatzprodukte.
Die passen in klimaschonende und umweltfreundliche politische Strategien, in das derzeitige Nachfrageverhalten vieler Konsumenten und können zur Sättigung der acht Milliarden plus X Menschen auf der Erde beitragen. Den Ausgangspunkt bilden pflanzliche Quellen (Leguminosen, Getrei -

de, Soja, Hülsenfrüchte oder Ölsaaten), tierische Quellen (Insekten oder Zellkulturen) und weitere Proteinquellen (Mikro- und Makroalgen, Pilze, Bakterien und Hefen).
Als wesentliche Elemente der Verarbeitungsprozesse kommen hier unter anderem Nassisolierungs- und Fraktionierungstechniken zur Trennung von Proteinen zum Tragen. Konkret benötigt werden Extruder und Hochleistungskühldüsen. Im Zusammenspiel bringen sie es auf 1000 Kilogramm nass extrudierte «AlternativProteine» pro Stunde.
Eine Voraussetzung für einen reibungslosen Ablauf der Maschinenprozesse bilden Automatisierungslösungen mit einer zen -
pH-MESSUNG
ZUVERLÄSSIG UND SICHER
tralen Überwachung und Steuerung sowie mit einer Übersicht über die Produktion in Echtzeit – kurz: eine adäquate Prozessanalytik (PAT). In diesem Bereich erweist sich gerade die Nahinfrarot-Spektroskopie als Verfahren der Wahl.
Man braucht dazu nur geeignete Fenster, durch die das NIR-System in den laufenden Prozess «hineinsehen» kann, oder eine faseroptische Ankopplung. Idealerweise verwendet der Prozessanalytiker dabei modulare Systeme und eröffnet sich zusätzlich die Möglichkeit, von NIR auf MIR (mid infrared) oder auf sichtbares Licht (visible) umzuschalten oder auch auf UV-Fluoreszenz (z. B. Aflatoxin-/Mykotoxin-Nachweis).
Von Indikatorstäbchen über Pufferlösungen mit und ohne Farbcodierung bis hin zu Kalibrierungs-Sets – CHEMSOLUTE® hat alles für die pH-Messung.
4–5/2024
Alternative Proteine: «Rindfleisch» wird im 3-D-Druck produziert. (Bild: Shutterstock)
www.thgeyer.com

Datengetriebene Ernährungskonzepte auf wissenschaftlicher Basis könnten die Umstellung unserer Essgewohnheiten flankieren. (Bild: Shutterstock)
Es versteht sich von selbst, dass NIR-Messungen ebenso zu den typischen Qualitätssicherungsmassnahmen im Labor gehören, so etwa bei der Rohstoffeingangs- und der Warenausgangskontrolle. In Zukunft werden solche Messungen womöglich häufiger mit portablen Analysegeräten durchgeführt werden können. Sie decken heute ohne weiteres grosse Wellenlängenbereiche ab (z. B. 1100 bis 2500 Nanometer) und bringen es auf hohe Signal-RauschVerhältnisse – nicht zuletzt dank weiterentwickelter Fourier-Transform-Algorithmen (FTIR).
Diese Entwicklung setzt sich bis zu den handgehaltenen Analysegeräten der Konsumenten fort. Diese sollen mittelfristig befähigt werden, wichtige Parameter von Lebensmitteln am Point of Sales (PoS) bei der Migros mit seinem Smartphone bestimmen zu können. Dieses würde nur ein paar Franken mehr kosten (schätzungsweise nicht einmal 10 CHF).
Das Branchenevent Ilmac in Lausanne gibt seinen Besucherinnen und Besuchern in diesen und anderen Bereichen der Lebensmittelchemie und -technologie eine klare Orientierung. An zwei Tagen präsentieren die Aussteller und Startups Prozesse, PAT und Laboranalytik und geben einen Ausblick auf Schnellverfahren bis hin zur PoS-Analytik für Konsumenten. Dies kann auf der wissenschaftlich getriebenen Ilmac Conference mit vielen Fachvorträgen noch vertieft werden. Die Agenda wird ab April verfügbar sein.
Ilmac Lausanne 2024
Daten: Mittwoch, 18. und Donnerstag, 19. September 2024
Öffnungszeiten: 9 bis 17 Uhr
Ort: Expo Beaulieu Lausanne, Halle 36
Veranstalterin: MCH Messe Schweiz (Basel) AG
Information: www.ilmac.ch
Community-Netzwerk «Ilmac 365»: https://365.ilmac.ch/event/ilmac
Kostenloses Ticket: www.ilmac.ch/free-ticket (Code: cx-24)


Small but mighty
With its compact dimensions, our Brevis GC-2050 saves valuable lab space. It offers you easy operation and maintenance with less consumption, and is supported by LabSolutions and other leading software packages.
S pace-saving
4 GC-2050 can be placed on a typical lab table
Free choice
Suitable for hydrogen, argon, helium or nitrogen as carrier gas
Cost-saving
30 % less power* and up to 90 % reduced gas consumption
* Compared with the conventional Shimadzu GC.
www.shimadzu.ch / small-but-mighty
4–5/2024
Learn more!
Leitmesse der Laborbranche
Analytica 2024 mit guter Bilanz
Eine angenehme, positive Stimmung war an der Analytica vorzufinden, wo über 1000 Aussteller den rund 34 000 Besuchern ihre Neuheiten für das ganze Spektrum der Labortechnik, Analytik und Biotechnologie zeigten. An den Messeständen und den Begleitveranstaltungen dominierten die Themen Digitalisierung und Nachhaltigkeit im Labor.
Gemäss der Messe München könne die Analytica 2024 sowohl bei den Ausstellerals auch den Besucherzahlen nahezu nahtlos an die Veranstaltungen vor der Pandemie anknüpfen. Armin Wittmann und Susanne Grödl, bei der Messe München für die Analytica zuständig, ergänzen: «Ob bei der Analyse von Schadstoffen, der Früherkennung von Krankheiten oder der Entwicklung von Impfstoffen – die Innovationskraft dieser Branche macht den Fortschritt in vielen Bereichen des täglichen Lebens erst möglich.» Das die Leitmesse der Laborbranche stets eine hervorragende Plattform ist, um neue Technologien einzuführen und neue Kunden in sämtlichen Segmenten zu gewinnen, war auch dieses Jahr wieder zu spüren.
«Auf diese Analytica haben alle gewartet: Mit zahlreichen Besuchern und vielen guten Gesprächen lieferte sie in wirtschaftlich herausfordernden Zeiten entscheidende Impulse für uns und die gesamte Branche», sagt Dr. Gunther Wobser, Geschäftsführender Gesellschafter von Lauda Dr. R. Wobser.
Mathis Kuchejda, Geschäftsführer von Schmidt + Haensch und Vorsitzender der Analysen, Bio- und Labortechnik beim Branchenverband Spectaris, stimmt zu:

Eine aus Kanada angereiste Ausstellerin –
Ganaoui, GRW Development – mit symbolischer Geste eingangs Messegelände. (Bild: ChemieXtra)


Könnte auch ein Wandgemälde sein: Messebesucherinnen vor der Seitenwand des Standes von Analytik Jena. (Bild: ChemieXtra)
«Viele innovative Produkte, Kunden aus aller Welt und Informationen zu den neuesten Trends: Die Analytica ist auch in diesem Jahr ihrem Ruf als Weltleitmesse und Branchentreff der Analysen-, Bio- und Labortechnik gerecht geworden. Insgesamt ist die Stimmung sowohl bei Ausstellern wie auch Besuchern ausserordentlich gut.»
Foren und Konferenz gut besucht
Ein abwechslungsreiches Begleitprogramm bildete die Schwerpunktthemen der Messe ab und bot dem Publikum die Gelegenheit, das Labor der Zukunft live zu erleben. Susanne Grödl, Deputy Exhibition Director der Analytica, sagt: «Mit unseren Angeboten zu Digitalisierung, künstlicher Intelligenz und Nachhaltigkeit haben wir einen Nerv getroffen. Die jeweiligen Foren- und Konferenzprogramme waren sehr gut besucht.» Das
Konzept, der Branche Orientierungswissen zu vermitteln, scheint aufgegangen zu sein. Viel Publikum und volle Ränge auf der Sondertribüne gab es beim «Live Lab», bei dem dreimal täglich gängige Laborprozesse präsentiert wurden. Auf der Sonderschau «Digital Transformation» konnten Interessierte ebenfalls mehrmals täglich das smarte Labor der Zukunft erleben und ausprobieren. Die beiden Sonderschauen zogen zusammen rund 3500 Zuschauerinnen und Zuschauer an.
Ein weiterer Publikumsmagnet war das Forum «Arbeitsschutz und Arbeitssicherheit», das anhand von explosiven LiveDemonstrationen anschaulich die Gefahren der täglichen Laborarbeit zeigte und einen besonderen Fokus auf den Umgang mit Lithium-Ionen-Akkus legte. Grosser Andrang herrschte beim «Jobday» am letzten Messetag. Dort bekamen Studienabgänger und Young Professionals in zahl -
20 4–5/2024 Veranstaltungen
Roumy

Beim «Live Lab» wurden dreimal pro Tag Laborprozesse präsentiert. (Bild: ChemieXtra)
reichen Vorträgen Informationen zu beruflichen Perspektiven in der Branche sowie die Gelegenheit, potenzielle Arbeitgeber kennenzulernen.
Die 2024er-Ausgabe in Zahlen
Die Analytica Conference verzeichnete dieses Jahr mit 2225 Teilnehmenden einen neuen Rekord. Besonders voll waren die Zuhörerreihen bei den Sessions zu Nachhaltigkeitsthemen, KI in der Diagnostik und Forensik. «Wie schon in der Ver gangenheit zeichnete sich die Analytica Conference wieder durch über 180 hochkarätige Vorträge und vielfältige analytische Themengebiete aus und bildete so eine optimale Ergänzung zum Ausstellungsbereich», resümiert Prof. Dr. Oliver J. Schmitz von der Universität Duisburg-Essen. Neben den Top-Themen der Branche befasste sich das Vortragsprogramm auch mit dem interdisziplinären Potenzial der Analytik, beispielsweise bei der Analyse alter Ölgemälde, in der Archäometrie oder bei der Aufklärung von Kriminalfällen.
1066 Aussteller reisten aus 42 Ländern und Regionen an, davon 53 Prozent von ausserhalb Deutschlands. Die Top-Ten-Ausstellerländer waren nach Deutschland (in dieser Reihenfolge): China, USA, Italien, Grossbritannien und Nordirland, Schweiz, Niederlande, Frankreich, Südkorea, Indien und Österreich. Es kamen rund 34 000 Besucher aus 117 Ländern und Regionen, wobei der Auslandsanteil bei knapp 40 Prozent lag. Die Top-Ten-Besucherländer waren nach Deutschland (in dieser Reihenfolge): Österreich, Schweiz, Italien, Grossbritannien und Nordirland, Frankreich, Niederlande, China, Spanien, USA und Polen. Die nächste Messeausgabe findet vom 24. bis 27. März 2026 statt.
https://analytica.de


Kontinuierliche Messung auch bei Gas- und Luft-Einschlüssen im Medium
OPTIMASS Serie –Coriolis Masse-Durchflussmessgeräte mit Entrained Gas Management (EGMTM)
• Messgeräte gewährleisten den Betrieb selbst bei unterschiedlichen Gasanteilen und komplexen Durchflussbedingungen
• Erhebliche Verbesserungen bei:
– An- und Abfahren von Anlagen
– Herstellung von lufthaltigen Produkten
– Fehlersuche im Prozess
• Messung von Masse, Volumendurchfluss, Dichte, Temperatur und Strömungsgeschwindigkeit sowie Konzentration mit einem Gerät


KROHNE AG



Uferstrasse 90, 4019 Basel, Tel. 061 638 30 30, info@krohne.ch, www.ch.krohne.com

21 4–5/2024
products solutions services
Analytica 2024
Die Highlights
Auf dieser Bilderstrecke hat die ChemieXtra-Redaktion Experten und Exponate, die an der Analytica in München aufgefallen sind, zusammengetragen.
(Bilder: ChemieXtra)

Anton Paar – Daniela Kratz, Event Marketing, am Messestand, den sie konzipiert hat.

Büchi – Ein am Stand präsentiertes Glasreaktorsystem.
Camag – Mit dem «HPTLC Pro» wurde ein vollautomatisches Probenanalyse- und Auswertesystem zur Qualitätskontrolle präsentiert.

Einer der Publikumsmagnete – Ob auch ohne das bunte Auto so viele Tragtaschen verteilt worden wären?

Carl Roth – Viel Publikum und eine gelassene Stimmung beim Anbieter von Produkten für Laborbedarf, Life Science und Chemikalien.

Vici – Unter anderem vor Ort: Der «GC Zero Air Generator», der für kohlenwasserstofffreie Luft für hochempfindliche GC-FID-Analysen sorgt.



Julabo – Der Peltierkühler «TE400» und das Wasserbad Pura 22.
Veranstaltungen

Lauda – Premiere der mobilen, akkubetriebenen Ultratiefkühltruhe «Mobifreeze M 270»: Enrico Bossart, Leiter Produktmanagement, bei der Präsentation.

MWS – Werner Lautenschläger, Geschäftsführer, vor dem neuen Direkt-Quecksilber-Analysator für Feststoff-, Flüssigkeitsund Gasproben «DMA-1 evo».


Shimadzu – das Unternehmen bleibt dran: Desinfektion ergibt auch nach der Pandemie Sinn, insbesondere auf einer Messe.



Hamilton – Das Unternehmen präsentierte eine automatisierte Lösung für das Pipettieren, Verarbeiten und Transportieren von Bioproben.
Spetec – In der Vitrine des Herstellers von Labortechnik, Reinraumtechnik und Laserschutz: Eine Spritzenpumpe zur Dosierung von Flüssigkeiten im Mikroliter- bzw. Nanoliterbereich.

 Semadeni – Grosses Interesse am Stand des Anbieters von Kunststoffprodukten für das Labor.
Scat – Im unverkennbaren Pink: Mara Höcker, Verkauf bei Scat, in Ihrer Messerolle.
Socorex – Yves Lachavanne, Geschäftsführer, und Giulia Faé, Verkauf Italien und Tessin.
Semadeni – Grosses Interesse am Stand des Anbieters von Kunststoffprodukten für das Labor.
Scat – Im unverkennbaren Pink: Mara Höcker, Verkauf bei Scat, in Ihrer Messerolle.
Socorex – Yves Lachavanne, Geschäftsführer, und Giulia Faé, Verkauf Italien und Tessin.

Die Schweiz lag sowohl unter den Top-10-Besucherländern als auch den Top-10-Ausstellerländern.

Mettler Toledo – Grosser Andrang am Stand des Messtechnikspezialisten.

YMC – Jetzt für den Einsatz bis zu einer Temperatur von 70 Grad: Maja Stahl, Produktspezialistin, mit der neuen Glassäule «YMC HT».


Aussicht vom Julabo-Stand aus in Richtung KNF, Edmund Bühler und Huber.

Netzsch – Aussteller in Halle A1 präsentierten Produkte und Lösungen für die Analytik und Qualitätskontrolle.

Emaform – Sechsteiliges Gehäuse für ein Messgerät zur Bestimmung von gelöstem Sauerstoff aus Polypropylen.


Gasgeneratoren von

H2, N2, Null-Luft etc. www.vicischweiz.ch
VICI Schweiz AG Sarbachstrasse 5 · CH-6345 Neuheim Telefon +41 41 757 51 51 info-schweiz@vici.ch · www.vicischweiz.ch
21. Schweizer Sonderabfalltag
Wo sich die Sonderabfallprofis treffen
Fachpersonen und Verantwortliche aus Industrie, Gewerbe und Institutionen versammeln sich am 4. Juni wieder am Sonderabfalltag im Hotel Arte, Olten. Ein Blick auf die Referate der Tagung, die zum 21. Mal stattfindet.
In Schweizerhalle, Klybeck, Rosenthal und Monthey wurde bis 1971 das blasenkrebsauslösende Benzidin in grossen Mengen hergestellt. Dr. Martin Forter von Ärztinnen und Ärzte für den Umweltschutz, Basel, geht der Frage nach, ob die betroffenen Kantone bei der Altlastenuntersuchung dieser Areale Rechnung getragen haben. Wurde dem heimtückischen Benzidin nachgegangen? Mit diesen Fragen soll geklärt werden, ob sich die Altlastenverordnung bewährt hat.
«Messmethoden im Umweltbereich: Herausforderungen und Unsicherheiten», so lautet das Thema von Dr. Marina Kuster von der Wessling AG, Lyss. Sie geht umwelt-analytischen Fragestellungen nach, insbesondere im Abfallbereich. Was sind die Herausforderungen und Unsicherheiten in der Praxis betreffend Handhabung und Grenzwerte, gerade wenn es sich um PFAS (per- und polyfluorierte Alkylverbindungen) handelt?
Für ein Praxisreferat wurde Michael Waldner der Vito Recycling AG, Péry-La Heutte, gewonnen. Sein Unternehmen betreibt in Péry die modernste Bodenwaschanlage der Schweiz. Vor dem Hintergrund der Ressourcenknappheit ist diese Anlage ein wichtiger Baustein in der Kreislaufwirtschaft. Im Referat wird darauf eingegangen, wie die Bodenwaschanlage funktioniert und welchen Herausforderungen sich die Betreiber stellen.
Rebekka Gulde und Fabienne Eugster vom Verband Schweizer Abwasser- und Gewässerschutzfachleute (VSA) werden dem Publikum mit einer Situationsanalyse die Stoffeinträge aus Industrie und Gewerbe im Abwasser aufzeigen. Welche Aktivitäten dienen zur Aufklärung und Reduktion in priorisierten Branchen? Weiter werden Erkenntnisse präsentiert, die aus Machbarkeitsstudien und Untersuchungen von Abwässern stammen.

Wer mit Sonderabfällen zu tun hat, kommt nicht darum herum, diese zu klassieren.
Dieter Offenthaler von der ThommenFuler AG in Rüti bei Büren wird aufzeigen, auf was bei der Klassierung von Abfällen zu achten ist.
Martin Luther, Vertreter des Bundesamt für Umwelt, spricht über die Revision der Verordnung über den Verkehr mit Abfällen (VeVA). Der Begriff «Siedlungsabfall» soll durch die konkrete Nennung von Abfallarten ersetzt werden. Was hat das für Auswirkungen? Weiter wird darauf eingegangen, wie die geplanten restriktiven Bedingungen aussehen, unter welchen die biogenen Abfälle aus Haushalten und die pflanzlichen Abfälle aus dem Gartenunterhalt künftig exportiert werden dürfen.
Auch dieses Jahr gibt es ein Referat zum Thema Batterien. 2024 geht es um Lithium-Ionen-Antriebsbatterien. Was sind die Herausforderungen mit dem neuen Abfallstrom? Wie entwickelt sich der Markt? Welche Recyclingtechnologie wird verwendet? Diese Fragen wird Jodok Reinhardt von der Librec AG, Biberist, beantworten. Ein spannender Vortrag werden Guido Hesse (Hesse Digital AG, Rugell) und Urban Frei (Rytec AG, Münsigen) halten.
Zum Thema «Versicherungen für die Entsorgungs- und Recyclingbranche: Wege aus den Deckungsnotständen» gehen sie auf die sogenannten Peer-to-Peer (P2P)Versicherungen ein und erklären, wie diese funktionieren und für welche Anwendungsfelder diese in Frage kommen. Zudem wird darauf eingegangen, welche Deckungsnotstände mit diesen Versicherungen beseitigt werden können. Interessant werden diesbezüglich vor allem der Kostenvergleich zu traditionellen Modellen und die Frage, welche Anbieter es auf dem Markt geben wird.
www.ecoserve.ch
Preise, hohe Qualität, prompte Services.

25 4–5/2024 Veranstaltungen
Aufräumarbeiten nach dem Brand in Schweizerhalle, 1986. (Bild: Comet Photo, CC BY-SA 4.0, Wikimedia Commons)
Van der Heijden
www.mlt.ch MLT_Text-Ins. Kühlgeräte_58x45_4.17.indd 1 05.04.17 18:08
Umlaufkühler der Marke
Top
Achema 2024
Prozessindustrie im Wandel
Vom 10. bis am 14. Juni öffnet die Achema in Frankfurt ihre Tore. Im Mittelpunkt der fünftägigen Messe steht eine wichtige Frage: Wie kann sich die Prozessindustrie in einer Welt im Wandel erfolgreich positionieren? Antworten liefern die Ausstellung, eine Sonderschau und das Begleitprogramm.
Die Prozessindustrie steht vor grossen Herausforderungen. An die Stelle der jahrzehntelangen Entwicklung hin zu mehr Globalisierung treten zunehmende Instabilität und teils protektionistische Tendenzen in der Handelspolitik. Andererseits machen der Wandel zu mehr Nachhaltigkeit, die Entwicklung der Wasserstoffwirtschaft oder das Streben nach Rohstoffsicherung neue globale Netzwerke erforderlich. Wie positionieren sich Unternehmen der Prozessindustrie in diesem anspruchsvollen Umfeld? Welche Technologien werden benötigt, um auf die neuen Herausforderungen zu reagieren? Und welche politischen Rahmenbedingungen müssen geschaffen werden, um eine wirtschaftliche Transformation zu ermöglichen, die dem Klimawandel gerecht wird? Diese Fragen stehen im Mittelpunkt der diesjährigen Achema Eröffnungsveranstaltung am Abend des ersten Messetages, dem 10. Juni, von 17.00 bis 18.30 Uhr im Saal Europa, Halle 4.0. Konkrete Lösungen für diese und viele andere Herausforderungen stehen gleichermassen auch bei den 2700 Ausstellern aus mehr als 50 Ländern im Vordergrund, die – auf zwölf Ausstellungsgruppen und eine Sonderschau verteilt – ein vielseitiges Spektrum an Innovationen und Produkten präsentieren. Mit mehr als 1000 Rednern setzt das begleitende Kongress und Bühnenprogramm darüber hinaus Impulse für eine erfolgreiche Transformation.
Prozesstechnik und Pharmaindustrie
Die Prozesstechnik steht an einem Scheideweg: Während neue Investitionen in grüne Technologien zunehmen, wird es immer komplexer, den Betrieb aufrechtzuerhalten und installierte Anlagen wettbewerbsfähig zu steuern. Hier setzt die «Pro


der letzten Achema-Ausgabe 2022. (Bild: Dechema)
cess Innovation Stage» mit Themen wie Elektrifizierung, Flexibilisierung und Effizienzsteigerung von chemischen Prozessen ebenso an wie mit Beiträgen zu intelligenter Technik, Ausrüstung, Analytik und Betrieb.
Die Pharmatechnik ist der am schnellsten wachsende Bereich der Achema. 2024 steht die biopharmazeutische Produktion im Fokus, mit folgender zentralen Herausforderung: Bestehende Verfahren müssen immer höheren Anforderungen und Massstäben genügen.
Labor und Digitalisierung
Das Labor ist sowohl Entstehungsort von Innovationen als auch Hüter der Produktqualität. Mehr denn je bestimmt sich der Erfolg durch die im Labor und an den Schnittstellen zu Technik und Produktion eingesetzten Technologien und Standards. Neben Gestaltung, Planung, Bau und Management von Laboren werden auch fortschrittliche Bioanalytik und pharmazeutische Anwendungen beleuchtet. Nebst der «Lab Innovation Stage» wird die Messe eine Aktionsfläche rund um das digitali
sierte, miniaturisierte und automatisierte Labor der Zukunft präsentieren. Die Digitalisierung und dadurch entstehende Innovationen wie fortschrittliche Analytik oder Industrie 4.0 Technologien sind weiterhin ein Dauerbrenner in Frankfurt. Hierzu wird die «Digital Innovation Stage» sich mit zahlreichen Themen rund um den derzeit wichtigsten Wegbereiter für Innovationen befassen.
Die Skalierung der Wasserstoffproduktion und infrastruktur ist schliesslich auch Thema. Gezeigt werden Lösungen zu Erzeugung, Handhabung, Transport und Speicherung von Wasserstoff. Die «Hydrogen Innovation Stage» deckt dabei die Aspekte ab, die für die Prozessindustrie relevant sind: Eine rasche Skalierung von Produktion und Infrastruktur, Power to X, industrielle Anwendungen, Sektorenkopplung und vieles mehr. Die Sonderschau Wasserstoff präsentiert die bisherigen Meilensteine der Wasserstoffwirtschaft und künftige Herausforderungen.
www.achema.de
26 4–5/2024 Veranstaltungen
Impression
ACHEMA-EXPONAT
Laborreaktorsysteme effizient automatisieren

HiTec Zang präsentiert auf der ACHEMA Innovationen im Bereich der Laborautomatisierung. Das LabVision® -System ist eine Kombination aus der LabVision®-Software für Messwerterfassung, Automatisierung, Dokumentation und den Schnittstellengeräten LabBox® und LabManager®, die den Anschluss an bestehende Laborgeräte ermöglichen. Diese Entwicklung repräsentiert einen signifikanten Fortschritt in der chemischen Synthese und Prozessoptimierung und ist speziell darauf ausgelegt, die Effizienz im Labor zu maximieren und die Reproduzierbarkeit von Experimenten zu verbessern.
– Mehr Effizienz und Produktivität durch die Automatisierung von Routineaufgaben.
– Präzise Kontrolle und Überwachung über Parameter wie Temperatur, Druck und Reaktionszeit für konsistentere Ergebnisse.
– Integrierte Sicherheitsfunktionen für den sicheren Betrieb bei komplexen Reaktionen.
– Benutzerfreundlichkeit durch intuitive Benutzeroberfläche und automatisierte Datenprotokollierung.
«Wir sind stolz darauf, dass wir mit dem LabVision® -System nicht nur die Art und Weise der Durchführung von Experimenten verändern, sondern auch neue Innovationsmöglichkeiten in der Forschung schaffen,» sagt Christoph Zang, CEO der HiTec Zang GmbH.
Halle 12.0

HiTec Zang GmbH
Ebertstr. 28–32
D-52134 Herzogenrath
Telefon +49 241 910 100 info@hitec-zang.de www.hitec-zang.de
Trennung thermisch empfindlicher Stoffe

Die Molekulardestillation, auch HochvakuumWischschicht-, Dünnschicht- oder Kurzwegdestillation genannt, ist ein bekanntes Verfahren zur Trennung thermisch empfindlicher Stoffe. Kombiniert in einer neuen Konstruktion mit präzisen Temperaturregeleinheiten, ermöglicht dies eine Hochleistungsdestillation für viele verschiedene Anwendungen und Produkte.
Der SP 1000 CC von Pilodist, ein schlüsselfertiges System für den Laborbetrieb und die Produktion kleinerer Mengen, nutzt individuelle Temperaturkontrollen für alle Heizungsund Kühlkreisläufe. Der mit einem JULABO Umwälzthermostat temperierte Vorlagebehälter heizt das Produkt für eine optimale Fliessfähigkeit vor. Für eine optimale Wärmeübertragung mit hoher Umwälzgeschwindigkeit wird der Verdunster ausserdem mit einem JULABO Umwälzthermostaten betrieben, während der Verflüssiger das Destillat mit einem JULABO Umwälzthermostat auffängt und kühlt. Zusätzlich wird der Feuchtigkeitsabsorber zum Auffangen der sehr leichten flüchtigen Stoffe mit einem JULABO Tauchkühler auf –90 °C abgekühlt.
MAAG Group auf der Achema

Nach der Uebernahme von Witte durch die MAAG Group Anfang 2023 wird auf der Achema in Frankfurt, Deutschland eine erste gemeinsame Produktentwicklung vorgestellt:
Die neue CHEM-X Zahnradpumpe ist ein Symbol für diese synergetische Partnerschaft, die für die anspruchsvollsten Anwendungen in verschiedenen Branchen entwickelt wurde. Der Schwerpunkt liegt dabei auf Leistung, Langlebigkeit und Effizienz.
Die Pumpe verfügt über ein fortschrittliches Zahnraddesign, das für minimale hydraulische Pulsation und maximalen volumetrischen Wirkungsgrad optimiert ist. Die Verwendung innovativer Materialien stellt sicher, dass die Pumpe aggressiven Chemikalien und hohen Temperaturen standhält, ohne ihre Lebensdauer oder Leistung zu beeinträchtigen.
Das neue Produkt kann mit einem intelligenten Steuerungssystem ausgestattet werden. Diese Systeme ermöglichen die Überwachung und Anpassung in Echtzeit und stellen sicher, dass die Pumpe unter verschiedenen Prozessbedingungen mit höchster Effizienz arbeitet.
JULABO GmbH
Gerhard-Juchheim-Strasse 1
D-77960 Seelbach
Telefon +49 7823 51-0
Fax +49 7823 2491
info.de@julabo.com www.julabo.com
Maag Pump Systems AG
Aspstrasse 12
8154 Oberglatt
Telefon +41 44 278 82 00 welcome@maag.com www.maag.com


4–5/2024 27
Stand
Stand D115 Halle 9.0
E64
Halle 4.0 Stand A24
Halle 8.0 Stand K78
Chemspec Europe 2024
Früh buchen ist angesagt
Neue Anbieter kennenlernen, Geschäftsbeziehungen vertiefen und sich austauschen: Am 19. und 20. Juni findet die Chemspec Europe in Halle 3 der Messe Düsseldorf statt. Die 37. Ausgabe der internationalen Messe für Fein- und Spezialchemie findet während der Fussball-EM statt – eine frühzeitige Planung des Besuchs lohnt sich demnach.
2024 stellen mehr als 305 Aussteller aus allen Bereichen der Fein- und Spezialchemie ihre neuesten Produkte und Innovationen in Düsseldorf vor. Vom Start-up über das KMU bis hin zum globalen Marktführer: An der breitgefächerten Ausstellerliste lässt sich auch die internationale Ausrichtung der Messe erkennen. Besonders beteiligt sind neben Deutschland die Schweiz – zum Beispiel mit Arxada oder CABB, Österreich, Frankreich, Belgien, die USA und Indien. Christiane Beck, Veranstaltungsmanagerin der Chemspec Europe, sagt: «Die chemische Industrie ist einer der grössten Produktionssektoren Europas und leistet in der Material- und Werkstoffforschung bahnbrechende Arbeit, gerade auf den Gebieten der Biochemie und Nanotechnologie, mit einem starken Fokus auf Nachhaltigkeit und grüne Chemie. Branchenführende Aussteller und ein breitgefächertes Konferenzprogramm bieten geballtes Fachwissen und machen die Chemspec Europe 2024 zur perfekten Anlaufstation, um sich Experteninformationen aus erster Hand zu beschaffen – unabdingbar für alle, die im raschen Wandel der Branche wettbewerbsfähig blei-



ben wollen, die zunehmend von neuen Technologien, Digitalisierung und ökologischen Erwägungen vorangetrieben wird.»
Konferenz und Matchmaking
In Zusammenarbeit mit Partnerorganisationen bietet die Messe ein erstklassiges Kon -




28 4–5/2024 Veranstaltung en
Die Chemspec Europe ist an beiden Veranstaltungstagen von 9 bis 17 Uhr geöffnet. (Bild: RX Global)
www.ramseyer.ch
Wissenswertes zum Besuch
Bis am 5. Juni gibt es Tickets zum Frühbucherpreis von 50 Euro. Danach gilt der reguläre Online-Ticketpreis von 85 Euro. Beim Kauf vor Ort erhöht sich der Eintritt auf 100 Euro. Das «Besucher-Plus»-Ticket kostet 250 Euro (nach Verfügbarkeit).
Allen Besuchenden wird empfohlen, möglichst bald ihre Hotelunterkunft zu buchen, da im Sommer die Fussball-EM in Deutschland ausgetragen wird und die Zimmernachfrage in Düsseldorf entsprechend hoch ist.
ferenzprogramm. Dort dreht sich alles um intensiven Erfahrungsaustausch, spannende Einblicke in laufende Projekte der Forschung und Entwicklung sowie hochwertiges Networking. Besuchende können sich auf ein umfangreiches Programmangebot auf fünf verschiedenen Themenbühnen freuen: Das Agrochemical Lecture Theatre, das Pharma Lecture Theatre, das Royal Society of Chemistry Symposium, das Regulatory Services Lecture Theatre und die Innovative Startups Presentations. Die Teilnahme ist für alle Teilnehmerinnen und Teilnehmer der Chemspec Europe kostenlos.
CE: BxH/mm 184 x 131 mm + BZ 3 mm
Ein Matchmaking-Programm soll das Networking vor Ort verbessern. Die Vernetzungsplattform verlinkt Teilnehmende mit passenden Kaufinteressen und Produktangeboten und ermöglicht das Arrangieren persönlicher Meetings schon vor Messebeginn. Diesbezüglich sorgen erweiterte Ticketoptionen für eine zusätzliche Vernetzung mit anderen Besuchenden und gewähren Zutritt zur Matchmaking-Lounge. Dort können «Besucher-Plus»-Ticketinhaber an vorab vereinbarten Treffen teilnehmen. Wer das Ticket über die Messewebsite bestellt, erhält im Vorfeld der

Impression der letzten Messeausgabe 2023 in Basel. (Bild: RX Global)
Veranstaltung automatisch eine Einladung zur Nutzung des Matchmaking-Service.
www.chemspeceurope.com

Heute anfragennächste Woche testen. Miet- und Gebrauchtgeräte von Weiss Technik.
Als weltweit operierende Unternehmensgruppe verfügt Weiss Technik über einen umfangreichen Gerätepool an Lagerund Mietgeräten. Hierzu zählen Temperatur- und Klimaprüfschränke sowie Stabilitätsprüfschränke, Korrosionstestkammern und Temperaturschock-Prüfschränke. Fragen Sie nach unseren kurzfristig verfügbaren Geräten.

29 4–5/2024 Veranstaltung en
Weiss Technik AG · info.ch@weiss-technik.com www.weiss-technik.ch
Prozesstechnik
Zimmerli Messtechnik feiert 50-Jähriges
1974 haben Peter W. und Ursula Zimmerli in Riehen (BS) eine prozesstechnische Erfolgsgeschichte in Gang gesetzt, die seit einem halben Jahrhundert andauert und 2024 ihr 50-jähriges Jubiläum feiert. Das 2022 von den Geschwistern Christine Vincenzi und Peter Zimmerli übernommene Familienunternehmen ist stets mit dem technologischen Fortschritt mitgegangen und wurde schnell zum gefragten Spezialisten für massgeschneiderte Durchfluss-, Druck- und Temperaturmesstechnik, sowie Füllstands- und Wägetechnik.
Luca Meister
Von A wie Analyse-Messtechnik bis Z wie Zimmerli-Regler – stets der optimalen Prozesstechnik auf der Spur, begleiten die Experten der Zimmerli Messtechnik AG ihre Kunden von der Planung bis hin zu Wartung und Service. In den letzten 50 Jahren hat sich das Unternehmen mit Sitz in Riehen (BS) ein umfassendes technologisches Know-how mit einem breiten Erfahrungsschatz angeeignet. Ihr Erfolgsrezept? «Um für unsere Kunden Spitzenlösungen zu entwickeln, erweitern wir unsere Kompetenzen laufend mit den neuesten Technologien», erklärt Peter Zimmerli. Neben Standardlösungen spielen kundenspezifische Prozesse die Hauptrolle für das auf allen Kontinenten tätige Riehener Familienunternehmen.
Egal für welche Prozessanwendung, ein umfassendes Portfolio ermöglicht es den Kunden, ihre messtechnischen Herausforderungen mit sicheren und verlässlichen Instrumenten kosteneffizient und wirtschaftlich zu betreiben.
Vertretung von Top-Herstellern und eigene Produktion
Zuverlässig und auf dem höchsten Stand der Technik war der Produktekatalog schon immer. Die Zimmerli Messtechnik AG zählt namhafte Hersteller zu ihren lang jährigen Partnern. Dabei wird die Vielzahl an Lieferanten vervollständigt mit der eigenen Produktion der Zimmerli Druckregler in der Schweiz.
Die anspruchsvollen Kunden der Zimmerli Messtechnik AG stammen aus nahezu allen Industriebereichen wie z. B. Pharma, Chemie, Energie und Kraftwerke, Life Sciences, Öl und Gas sowie Wasser/Abwas-


ser. Sowohl kleinere Anlagen z. B. im Bereich Forschung und Entwicklung als auch industrielle Grossanlagen werden mit Mess- und Regeltechnik der weltweit tätigen Basler ausgestattet.
Mittlerweile in zweiter
Generation
Angefangen hat alles mit der Durchflussmesstechnik. Mit dem Vertrieb der «Rotameter» begann für Peter W. und Ursula Zimmerli 1974 eine anhaltende Erfolgsgeschichte. Über die Jahre wurde das Sor-

timent ausgebaut und die Kompetenzen auf den ganzen Anlagenlebenszyklus erweitert. Peter Zimmerli ergänzt: «Wir unterstützen unsere Kunden, egal ob Einzelunternehmung oder Grosskonzern bei ihren Bestellungen sowohl technologisch als auch wirtschaftlich und prüfen die Dinge jeweils vollständig durch. Damit sind wir weitaus mehr als ein Handelsbetrieb, und das wird geschätzt.» So beschäftigt das Unternehmen heute 16 Mitarbeitende und verfügt im ganzen Team über eine stark gefragte Expertise. Das Merkmal des KMU:

30 4–5/2024 Firmen berichten
Peter W. Zimmerli und Ursula Zimmerli.
Das Team der Zimmerli Messtechnik, aufgenommen im April 2024. (Bilder: Zimmerli Messtechnik)

Alle Komponenten der «Zimmerli-Regler» stammen aus der Schweiz.
Langjährige Mitarbeitende, die Profis auf ihrem Gebiet sind.
Die Zimmerli Messtechnik AG ging schon immer mit der Zeit: «Die Produkte wurden weiterentwickelt, denn die Anwendungen sind vielfältiger und herausfordernder geworden», fährt der Geschäftsführer fort. «Zum Beispiel im Bereich der regenerativen Energien wird robuste Messtechnik für die komplexen Anforderungen immer wichtiger.
Auch der Bereich Wasserstoffanwendungen spielt eine immer grössere Rolle bei den Anliegen unserer Kunden.» Dank der eigenen Produktion einschliesslich Werkstatt, Prüfstand und Lager werden Spezialanforderungen, Modifikationen oder Ergänzungen schnell und kosteneffizient umgesetzt. Nebst dem, dass Ventile und Instrumente auf Herz und Nieren geprüft werden, profitieren Kunden von kurzen Lieferzeiten und auch der Serviceiensatz in der Schweiz beim Kunden vor Ort wird zur schnellen Problemlösung sehr geschätzt und gerne genutzt.
«Zimmerli-Regler»: Präzision auf höchstem Niveau
Flaggschiff des Portfolios sind die «Zimmerli-Regler». Ob für Gase, Flüssigkeiten oder Wasserdampf: Die hochpräzisen und prozesssicheren Druckregler werden im eigenen Haus produziert. «Als flexibles KMU mit kurzen Kommunikationswegen haben wir dadurch nahezu keine Lieferkettenprobleme und können unsere Kunden zeitnah beliefern», sagt Peter Zimmerli. Die für alle Druckbereiche und ohne externe Energiespeisung funktionierenden
Zimmerli-Regler kommen neben den oben erwähnten Industrien auch in der Lebensmittelproduktion und Landwirtschaft zum Einsatz. Zimmerli-Regler verhindern unter anderem auch, dass Prozessgase in unerwünschten Mengen in die Atmo sphäre gelangen und leisten somit einen wichtigen Beitrag zum Umweltschutz.
Alle Zimmerli-Druckregler sind ursächlich Differenzdruckregler, die den Überlagerungsdruck (Differenzdruck) in einem Prozess auf Basis des atmosphärischen Drucks konstant halten. Es stehen Regler Kombinationen für Überdruck-, Domdruck-, Negativdruck- und dynamische Drucküberlagerung zur Verfügung. Durch das abgestimmte Regelverhalten zwischen Reduzierer und Überströmer lässt sich damit der Schutzgasverbrauch um bis zu 90 Prozent senken. Moderne Tanks, Zentrifugen, Prozess oder
Kompetenzprofil
Armaturen und Ventile
Automatisierungslösungen
Dampf-Armaturen
Druck- und Temperaturmesstechnik
Druckregler
Durchflussmesstechnik
Füllstandsmesstechnik
Wägetechnik
Sicherheitsventile
Pumpenschutz
Service/Wartung

Retro-Werbung.
Lagerbehälter werden üblicherweise mit zwei Zimmerli-Reglern bestückt. Da sämtliche Komponenten aus der Schweiz stammen, sind individuelle Kundenwünsche in puncto Komponenten, Materialien oder Oberflächen effizient umsetzbar. Darüber hinaus bietet die Zimmerli Messtechnik AG auch immer wieder Lösungen für veraltete Techniken, die sonst im Markt nicht mehr zu finden sind.
Die Erwartung übertreffen
Werden Systeme langlebig konzipiert, muss auch an Wartung und Service gedacht werden. In Riehen bezieht man von Anfang an den Servicegedanken mit ein und ist stets bestrebt, die Kundenerwartungen zu übertreffen. «Wir leben eine ausgesprochene KMU-Kultur, zu der ein guter Umgang gehört, intern und extern», sagt Peter Zimmerli, der auf langjährige Geschäftsbeziehungen setzt.
Ob für neue Lösungen oder Optimierungen bestehender Anlagen, mit der Zimmerli Messtechnik AG profitieren Kunden von einem verlässlichen Partner, der stets Zeit und Kosten im Visier behält. Peter Zimmerli schliesst: «Dank der Treue unserer Kunden und der Leistung unseres Teams haben wir diesen Meilenstein erreicht. 50 Jahre Zimmerli Messtechnik AG und wir freuen uns auf die Zukunft.»
Zimmerli Messtechnik AG
CH-4125 Riehen
info@zimmerliag.com www.zimmerliag.com

31 4–5/2024 Firmen berichten
Neue
Sicherheitswerkbank für das Labor
Claire neo – Flexibilität neu erleben
Höchste Sicherheit und Flexibilität für das Labor der Zukunft – die neue Generation von Sicherheitswerkbänken, «Claire neo», setzt neue Massstäbe für Sicherheit, Design und Funktion.
Neue Rastermasse für bessere Flächennutzung und Planung
Das Konzept der Claire neo erlaubt in pharmazeutischen, medizinischen und biologischen Fachbereichen höchste Flexibilität und erfüllt künftige Anforderungen der Laborarbeit. Das Augenmerk der neuen Flexibilität ist die Fertigung im metrischen Rastermass von 30-cm-Schritten. Die Vorgängermodellreihe Claire pro/Claire pure sowie Wettbewerbermodelle basierten historisch bedingt auf angloamerikanischen Hepa-Filtermassen im Fussraster, wodurch gebrochene Masse entstanden. Die Claire neo hingegen integriert sich durch ihre Aussenmasse von 1200 mm, 1500 mm, 1800 mm oder 2100 mm optimal in die moderne Laborumgebung und ermöglicht eine maximal effiziente Flächennutzung und Planung von Laborräumlichkeiten.
Zukunftssicher dank hoher Flexibilität
Um sich neuen Anforderungen und Verwendungszwecken anzupassen, erlaubt die Konstruktionsweise der Sicherheitswerkbank auch nachträgliche Anpassungen. So werden z. B. verschiedenartige Arbeitsplatten, Schnittstellen für Datenübertragung und Stromversorgung sowie Medienzugänge für Gase und Flüssigkeiten problemlos von Servicetechnikerinnen oder Anwendern selbst nachgerüstet. Zusätzlich besteht durch die innovative Architektur der Luftführung die Möglichkeit vor Ort, die Sicherheitswerkbank von einem 2-Filter-System zu einem 3-FilterSystem umzurüsten, um die Sicherheit bei der Arbeit mit Zytostatika oder gefährlichen Biostoffen zu erhöhen.
Zudem erhöht das neue Arbeitsplattenkonzept die Flexibilität der Claire neo. Das universelle Design ermöglicht es, alle Arbeitsplatten zwischen allen Claire neo-


Modellen auszutauschen und zu kombinieren. Dadurch wird eine individuelle Anpassung an den jeweiligen Prozess ermöglicht. Es steht ein umfangreiches Portfolio an Standard-Arbeitsplatten aus Edelstahl sowie einer Vielzahl an Sondermodellen zur Auswahl. Hierzu gehören Arbeitsplatten aus weissem Sicherheitsglas für eine besonders helle Arbeitsumgebung sowie funktionale Arbeitsplatten mit z. B. integrierter Temperierfunktion oder Tastatur. Die Stromversorgung und der Datentransfer erfolgen mittels Plug-and-Play-

Funktion unterhalb der Arbeitsfläche. Dank der flächenbündigen und flüssigkeitsdichten Integration lassen sich die Funktionen ohne Einschränkung der verfügbaren Fläche sicher nutzen und im Arbeitsbereich individuell anordnen.
Digitalisierung und Labor 4.0 spielen mittlerweile auch in der Forschung und medizinisch-pharmazeutischen Branche eine zentrale Rolle. Durch die flexibel erweiterbare Steuerungssoftware und die anwenderfreundliche OPC-UA-Schnittstelle erfüllt die Claire neo diese Anforderungen. So ist es möglich, dass die Sicherheitswerkbank mit anderen Laborgeräten und Überwachungseinrichtungen kommuniziert und unterschiedlichste Betriebsdaten sowie sämtliche Anmeldungen und Alarmmeldungen nachverfolgt und speichert. Zudem sind das User-Interface und die Menüführung äusserst intuitiv und individuell konfigurierbar. So können über das neue Display u. a. das Nutzerprofil konfiguriert und 15 Funktionstasten individuell belegt werden.
32 4–5/2024 Publire P ortage
Die neue Sicherheitswerkbank «Claire neo». (Bild: Skan)
Das neue High-End-Touch-Display der Claire neo.
(Bild: Skan)

Langlebig und Ressourcenschonend
Auch die Nachhaltigkeit wurde bei der Entwicklung berücksichtigt. Durch den Einsatz hochwertiger, energiesparender Komponenten, intelligenter Luftsteuerung und der Kombination von Eco-Modus mit ESMFunktion (Energy Save Mode) wurde der Stromverbrauch gegenüber dem Vorgängermodell um 9 bis 17 Prozent gesenkt. Diese Effekte werden durch Umrüstungsoptionen, die Auslegung aller Komponenten auf Langlebigkeit mit typischer Nutzungsdauer von mehr als 15 Jahren (ausgenommen Verschleissteile) sowie der Ermöglichung einer höchsteffizienten Laborplanung verstärkt. Dadurch werden ressourcen- und investmentintensive Neuanschaffungen weitestgehend vermieden.
https://skan.com/puresolutions

WE MAKE INDUSTRIES WORK

33 4–5/2024 Publire P ortage
Funktionale Arbeitsplatte mit Temperierfunktion aus weissem Sicherheitsglas (Bild: Skan)
Anzeige 04 ChemieXtra.indd 1 10.04.2024 13:08:53
Ultraschall-Durchflussmessung
Verlässlich, flexibel, wartungsfrei
In der chemischen Industrie ermöglicht das Ultraschall-Clamp-On-Portfolio von Endress+Hauser präzise Durchflussmessungen, selbst bei korrosiven, abrasiven oder toxischen Medien, und neu auch bei sehr hohen Temperaturen.
Möchten Sie den Durchfluss in Ihrer Applikation messen, können aber den Prozess nicht unterbrechen? Oder ist Ihr Medium zu aggressiv für einen direkten Kontakt mit dem Messaufnehmer? Die Lösung könnte ein Ultraschall-Durchflussmessgerät von Endress+Hauser sein. Diese Geräte sind nicht-invasiv und bieten maximale Flexibilität. Sie können einfach von aussen auf verschiedene Rohrtypen installiert werden und messen den Volumendurchfluss zuverlässig ohne Druckverlust. Dank wartungsfreier Koppelpads ist eine optimale Schallübertragung gewährleistet, was zu einer konstant hohen Signalstärke und stabilen Messung über den gesamten Lebenszyklus des Geräts führt, ohne Wartungsaufwand.
Entworfen für anspruchsvolle
Messanforderungen
Prosonic Flow P 500 ermöglicht eine einfache Montage durch das Clamp-on-Installationssystem, ohne dass Prozesse unterbrochen werden müssen. Er ist für den wartungsfreien Langzeitbetrieb in verschiedenen Industrien unter rauen Bedingungen ausgelegt.

Wenn der Platz begrenzt ist: Ultraschall Clamp-on-Durchflussmessgerät mit FlowDCFunktion für konstant hohe Performance auch bei nur 2 × DN Einlaufstrecken. (Bild: Endress)

Zuverlässige Messperformance: Die bewährten Sensoren liefern langzeit-stabile Signale, selbst bei Hochtemperaturanwendungen bis zu 550 °C.
• Hohe Sicherheitsstandards: Der Prosonic Flow P 500 wurde gemäss den Anforderungen an die funktionale Sicherheit gemäss IEC 61508 entwickelt und verfügt über internationale Zulassungen für explosionsgefährdete Bereiche.
Turbulenzen sind keine Störfaktoren mehr
Ultraschall-Durchflussmessgeräte sind nicht von Druck, Dichte und Leitfähigkeit des Mediums beeinflusst und können daher in vielen Flüssigkeiten eingesetzt werden. Insbesondere für Rohöl und raffinierte Ölprodukte, allgemeiner gesprochen für Kohlenwasserstoffe, ergibt sich der tatsächliche Volumenstrom erst aus einer Druck- und Temperaturkompensation. Endress+Hauser stellt dazu ein spezielles Petroleum-Anwendungspaket zur Verfügung, das die nötigen Korrekturwerte auf der Basis des API MPMS und der ASTMBerechnungstabellen berechnet.
Die Geräte verfügen über eine softwaregestützte Funktion namens FlowDC (Fow Disturbance Compensation), die Verwirbelungen im Medium kompensiert, die durch Verengungen und Bögen verursacht werden. Diese Funktion ermöglicht es, die Messstelle näher an die Störstelle zu bringen und erfordert weniger gerade Rohrstrecken als andere Geräte, was sie ideal für den Einsatz in beengten Anlagen macht.
Heartbeat Technology integriert Prüffunktionen
Wie in der gesamten Proline-Produktpalette sind die Prosonic Flow Geräte mit Heartbeat Technology ausgestattet. Geräte

Endress+Hauser Clamp-on-Sensoren für eingriffsfreie Durchflussmessungen ohne Rohrarbeiten oder Prozessunterbrechungen. (Bild: Endress)
mit Heartbeat Technology verfügen über Eigendiagnose-, Eigenüberwachungs- und Verifizierungs funktionen und können ihren Zustand regelmässig in die Cloud melden und zum Beispiel anstehende Wartungsarbeiten über eine Trendauswertung sinnvoll planbar machen. Diagnosefunktionen können über die Cloud auch jederzeit manuell angestossen werden. Die Diagnosemeldungen erfolgen standardisiert nach NAMUR NE 107.
Endress+Hauser (Schweiz) AG
Kägenstrasse 2
CH-4153 Reinach BL1 Tel. +41 61 715 75 75 info.ch@endress.com www.ch.endress.com
34 4–5/2024 Publire P ortage
Neue technische Entwicklung für «Good Vibrations»
NIR-Spektroskopie mit Spassfaktor
OMNIS NIRS räumt mit althergebrachten Ansichten über die Nahinfrarot-Spektroskopie auf, denn es ist einfach zu bedienen, braucht kaum Kenntnisse in Chemometrie und macht die Modellerstellung zum Kinderspiel.
Mehrere Parameter gleichzeitig bestimmen
Die NIR-Spektroskopie gehört zu den Methoden der Schwingungsspektroskopie und untersucht die Schwingungsmuster von Molekülen. Diese hinterlassen einen einzigartigen «Fingerabdruck», der im Gerät automatisch in ein lesbares Ergebnis umgewandelt wird. Je nach Aufgabe kann man die Identität einer Substanz bestätigen oder Mengenanteile von Inhaltsstoffen bestimmen – bei der Quantifizierung oft auch mehrere Parameter gleichzeitig. Häufig lassen sich sogar physikalische Eigenschaften molekularen Ursprungs messen.
Vereinfachte Routineanalysen
Die Anwendung ist unkompliziert und erfordert nur geringe Vorkenntnisse. Es werden keine Chemikalien oder Lösemittel verwendet, was Abfall vermeidet. Die Messung dauert dank neuer Technologie meist weniger als eine Minute. Die Probenvorbereitung ist minimal, die Geräte sind kompakt. Alle Aspekte, die in der Routineanalytik üblicherweise Schwierigkeiten bereiten und teuer sind, entfallen. Das ist ein gros-
ser Vorteil, insbesondere wenn Kosten gesenkt werden müssen.
NIR-Spektroskopie –aufwändige Modellerstellung
Und wo ist dann also der Haken? NIRSpektroskopie ist eine Sekundärmethode. Man muss dem System vorgängig beibringen, welchem Spektrum ein bestimmtes Ergebnis entspricht. Zum Erarbeiten eines Modells braucht man einen Satz Trainingsspektren mit bekannten Referenzwerten. Auf dieser Basis kann man ein Modell errechnen, was bislang gute Kenntnisse in Chemometrie erforderte.
Neue Technik – weniger Hürden
Vorkenntnisse in Chemometrie sind mit dem neuen OMNIS NIRS nicht mehr zwingend erforderlich. Geeignete Primärmethoden wie beispielsweise die Titration können mit der NIR-Spektroskopie verbunden werden und das integrierte Methoden-Erstellungstool OMD (OMNIS Model Developer), berechnet die Modelle vollautomatisch. Erfahrene NIR-Spezialisten

NIR-Spektrometer.

haben versucht, die Ergebnisse von OMD manuell zu verbessern und sind daran gescheitert. Dieser Punkt geht an den Algorithmus!
Selbstverständlich können auch andere Methoden genutzt werden, um geeignete Referenzproben zu erzeugen, beispielsweise das gesamte Spektrum der Chromatographie.
Wer nicht die Zeit und Kapazität für die Erstellung eines eigenen Kalibrationsmodells hat, kann mit bestehenden, käuflichen Vorkalibrierungen arbeiten. Die Anzahl verfügbarer Vorkalibrierungen wächst kontinuierlich. Diese können als Einstieg genutzt oder mit eigenen Spektren ergänzt werden, um die Genauigkeit zu erhöhen. Je nach Anspruch ist dies der Königsweg.
Das Arbeiten mit dem neuen OMNIS NIRS Spektrometer ist einfach, schnell und bringt «good vibrations» auch in Ihr Labor.

Metrohm Schweiz AG CH-4800 Zofingen info@metrohm.ch www.metrohm.ch

35 4–5/2024 Publire P ortage
«Good vibrations» in Ihrem Labor mit dem neuen OMNIS
Schnell, kompakt und mit anderen Methoden kombinierbar: Das sind einige der Vorzüge von OMNIS NIRS. (Bilder: Metrohm)
Sulzer unterstützt Andritz bei der Biomethanol Produktion
Biomethanol aus Zellstoff und Papier
Die Integration moderner Extraktionstechnologien, Destillationsverfahren und Prozesspumpen in BiomethanolAufbereitungskonzepte bringt die Zellstoffindustrie in eine Schlüsselrolle bei der Herstellung und Verfeinerung der Basischemikalie aus existierenden Stoffströmen.
Kai Joedicke ¹
Weltweit wächst das Interesse an Methanol aus erneuerbaren Quellen, sowohl aus ökologischen als auch aus ökonomischen Gründen. Ein besonderer Fokus liegt dabei auf der Nutzung von Methanol aus regenerativen Quellen statt der herkömmlichen energieintensiven Produktion aus Synthesegas.
Klimafreundliche Alternative Methanol gehört zu einer grösseren Gruppe von Basischemikalien/Basiskraftstoffen, die aus erneuerbaren Quellen gewonnen werden. Im Gegensatz zu fossilen Brennstoffen, deren Entstehung Millionen von Jahren dauert und die bei ihrer Verbrennung CO2 freisetzen, bieten diese Biokraftstoffe den Vorteil eines geschlossenen Kohlenstoffkreislaufs. Methanol kann zum Beispiel über Synthese aus CO2 unter Nutzung von Wasserstoff gewonnen werden, aber auch als Beiprodukt bei der Zellstoffherstellung aus der natürlichen Ressource Holz.
In den letzten Jahren hat die Nutzung von Biomethanol als Alternative zu herkömmlichen Kraftstoffen wie Benzin oder Diesel an Fahrt aufgenommen. Methanol ist ein gut transportabler Energieträger und vor allem die Schiff und Flugzeugindustrie wird in Zukunft auch auf solche Energieträger angewiesen sein.
Pulp- und Papierindustrie als Nachhaltigkeitskatalysator
Die Zellstoffindustrie kann eine Schlüsselrolle in der Herstellung und Verfeinerung von Biomethanol aus existierenden Stoff
1 Kai Joedicke, Director Key Accounts and Regional Sales Manager at Process Plants

strömen spielen. Innovative Technologien und effiziente Verfahren sind erforderlich, um Biomethanol in der erforderlichen Reinheit und Qualität für verschiedene industrielle Anwendungen herzustellen. Hierbei kommen Unternehmen wie Sulzer und Andritz ins Spiel. Sulzer, ein führender Anbieter von Trennund Aufbereitungstechnologien und Prozesslösungen, ist mit dem Technologieunternehmen Andritz eine Kooperation eingegangen, die die Produktion von jährlich 12 000 Tonnen Biomethanol ermöglicht. Dabei werden verschiedene SulzerTechnologien in das BiomethanolAufbereitungskonzept Kraftanol von Andritz integriert. Die neue Biomethanol Aufbereitungsanlage ist die weltweit grösste ihrer Art und wird von Veolia im finnischen Äänekoski betrieben.
Die genutzte Extraktionstechnologie von Sulzer ist dabei besonders innovativ, da sie
die Entfernung auch kleinster Mengen von Verunreinigungen aus dem Rohmaterial ermöglicht. Es werden weitere SulzerTechnologien und Produkte eingesetzt, um das Verfahren zu optimieren. Dabei kommen Einbauten zur Optimierung der weiteren Destillation sowie verschiedene Prozesspumpen von Sulzer zum Einsatz, um eine hohe Methanol Qualität zu erzeugen und einen reibungslosen und zuverlässigen Be
triebsablauf zu gewährleisten. Dadurch kann aus Methanol aus Zellstoffwerken hochwertiges Biomethanol produziert werden, das in einer Vielzahl von Industrien, einschliesslich des Transport und Chemiesektors, eingesetzt werden kann.
Kreislaufwirtschaft als Lösung
Die Biomethanolanlage wird an ein lokales Zellstoffwerk integriert, das seinerseits mit Rohstoffen aus der Natur arbeitet. Diese Vernetzung von natürlichen Edukten, in

Ausgangspunkt Papierindustrie: Die Verbindung von natürlichen Rohstoffen, industriellen Verfahren und Biomethanol als einem ihrer Produkte stellt ein Paradebeispiel für das Prinzip der Kreislaufwirtschaft dar. (Bild: Shutterstock)
36 4–5/2024 Publire P ortage

Reinheit,
Qualität:
Extraktionstechnologien werden selbst kleinste Mengen von Verunreinigungen aus Biomethanol entfernt. (Bild: Sulzer Chemtech)
dustriellen Prozessen und einer stofflich oder als Treibstoff nutzbaren Biochemikalie als eines der Produkte illustriert das Prinzip der Kreislaufwirtschaft. Durch die Zusammenarbeit von Unternehmen wie Sulzer und Andritz und die Implementierung innovativer Technologien wird ein wichtiger Beitrag zur Herstellung von regenerativen Kraftstoffen geleistet. Dies ist ein bedeutender Schritt in Richtung einer nachhaltigeren und umweltbewussteren Zukunft – und zeigt das Potenzial der Branche, einen positiven Einfluss auf die Umwelt auszuüben und gleichzeitig wirtschaftlich nachhaltige Lösungen zu fördern.
Sulzer Chemtech CH-4123 Allschwil chemtech@sulzer.com www.sulzer.com
High-Pressure Homogenizers

Please visit AVESTIN at ACHEMA in Frankfurt, Germany, 10 - 14 June 2024, Hall 5.0, Booth C51
A few millilitres to thousands of litresup to 2,000 bar / 30,000 psiused for Cell Rupture, Emulsions, Nanoparticles, and Liposomes
See at our booth at ACHEMA: a lab homogenizer and a 55 L/h homogenizer.
AVESTIN, Inc., Ottawa, Canada
Tel: +1-613-736-0019
E-mail: avestin@avestin.com
AVESTIN Europe GmbH, Germany
Tel: +49-621-724-5980
E-mail: avestin@avestin.net www.avestin.com www.avestin.com

37 4–5/2024 Publire P ortage
Hohe
hohe
Dank innovativer
Chemie Extra Achema 2024.indd 1 2024-03-04 11:17:32 AM
Kältetechnik
Energieeffizienz für mehr Klimaschutz
Mit der Einführung mehrerer neuer Kältegeräte erweitert Julabo sein Portfolio um umweltfreundliche und energieeffiziente Kälteumwälzthermostate im gesamten Leistungsspektrum von 200 Watt bis 2,5 Kilowatt. Alle Geräte arbeiten mit natürlichen Kältemitteln und tragen dadurch erheblich zum Klimaschutz bei.
Die grösseren Kältegeräte ab 800 Watt Kälteleistung bieten beeindruckende Energieeinsparpotenziale von bis zu 70 Prozent: Elektronische Expansionsventile, drehzahlgeregelte Verdichter und Lüfter erlauben einen nutzungsabhängigen Stromverbrauch. Dies führt bei vielen Anwendungsszenarien zu deutlichen Betriebskosteneinsparungen und somit zu einer schnelleren Amortisation der Anschaffungskosten. Die Kosteneinsparung ergibt sich aus der Energieeinsparung und dem Strompreis. Werden bei der Anwendung verschiedene Temperaturrampen und Lastanforderungen abgefahren und der Teillastbereich bei ca. 50 Prozent eingependelt, liegt die Energieeinsparung bei 400 Watt pro Stunde. Selbst bei niedrigen Stromkosten bewegt sich die Amortisationszeit der Geräte in vielen Anwendungsfällen bereits in einem Zeitraum von weniger als zwei Jahren. Gleichzeitig bedeutet der geringere Energieverbrauch einen positiven Beitrag zum


Klimaschutz. Trotz starker Leistungswerte ist die neueste Generation an Kälteumwälzthermostate äusserst kompakt und benötigt eine geringe Stellfläche im Labor.
Energieeinsparpotenzial bei Temperiersystemen
Um das mögliche Einsparpotential bei der Investition in neues Temperier-Equipment abzuschätzen und zu berücksichtigen, muss der konkret geplante Einsatzzweck betrachtet werden. Bei vielen typischen Anwendungen im Labor oder Industriebereich wird zu Beginn des Temperiervorgangs ein fest definierter Sollwert vorgegeben, den das Temperiergerät in einem möglichst kurzen Zeitintervall erreichen soll. Dazu arbeiten alle beteiligten Komponenten unter hoher Last. Nach dem Erreichen des Sollwerts wird die gewünschte Temperatur oft «nur» stabil gehalten. Eine Phase, in der es ausreicht, wenn beteiligte Komponenten wie Lüfter oder Verdichter im Teillastbetrieb arbeiten.


Die neuen umweltfreundlichen und energieeffizienten Kälteumwälzthermostate von Julabo. (Bild: Julabo)
Die neuen MAGIO Kältethermostate
Kältethermostate der MAGIO Reihe zeichnen sich durch ihre Premiumqualität und Leistungsstärke in Verbindung mit einer intuitiven Bedienbarkeit aus. Die Geräte bieten extra starke Druck- und Saugpumpen und besitzen eine sehr hohe Heizleistung, um externe Applikationen noch dynamischer temperieren zu können. Mit einem Arbeitstemperaturbereich von –50 bis +200 ° C und einer starken Kälteleistung von 1,87 bzw. 2,57 Kilowatt bei 20 ° C sind die MAGIO MX-1800F und MAGIO MX-2500F die neuen Flaggschiffe der Kälteumwälzthermostate. Mit dem MAGIO MS-1200FW bietet JULABO nun auch eine wassergekühlte Version der leistungsstarken Kältemaschine an. Wassergekühlte Systeme sind in der Regel effizienter als luftgekühlte Systeme, da Wasser eine höhere spezifische Wärmekapazität hat als Luft.
Julabo GmbH
Gerhard-Juchheim-Strasse 1 D-77960 Seelbach
Tel. +49 7823 51 0
https://world.julabo.com
38 4–5/2024 Publire P ortage
Der leistungsstarke Kältethermostat MAGIO MX-1800F. (Bild Julabo)
MAGIO MX-2500F: Hohe Heizleistung für externes Temperieren. (Bild: Julabo)
E-Mobilität und Elektronik
Umweltfreundlichere Flammschutzmittel
Weltweit steigt die Nachfrage nach elektronischen Geräten. Um Brände zu verhindern, stecken in jedem von ihnen Flammschutzmittel. Eine mögliche Alternative zu den verbreiteten, aber problematischen bromierten Flammschutzmitteln sind phosphororganische Flammschutzmittel. Welche Umweltauswirkungen die beiden Mittel im Vergleich haben, untersuchte ein Fraunhofer-Institut im Auftrag von Clariant. Dabei standen Kunststoffbauteile wie Ladestecker für Elektroautos oder USB-C-Anschlüsse im Fokus.
Bromierte Flammschutzmittel sind derzeit am weitesten verbreitet, da sie schlicht sehr wirksam sind. Sie sind effizient herzustellen, bei hohen Temperaturen stabil und können kosteneffizient produziert werden. Zu finden sind sie in Automobilen, Elektronik, Textilien und Möbeln. Der weltweite Verbrauch von Flammschutzmitteln wird auf 2,4 Millionen Tonnen geschätzt. Mehr als die Hälfte davon stecken in elektrischen und elektronischen Anwendungen wie auch der E-Mobilität. Doch bromierte – also halogenierte –Flammschutzmittel haben schädliche Auswirkungen auf die Umwelt und die Gesundheit: Sie können in Boden, Wasser, Klärschlamm oder auch bei Wildtieren nachgewiesen werden. Zudem entstehen bei deren Verbrennung toxische Emissionen. Daher sind dringend weniger schädliche Flammschutzmittel notwendig.
Erste umfassende Studie
Bisherige Untersuchungen konnten zeigen, dass viele Phosphorverbindungen in flammhemmenden Anwendungen im Vergleich zu bromierten Flammschutzmitteln sicherer und weniger toxisch sind. Jedoch fehlten bisher ganzheitliche und quantifizierende Lebenszyklusuntersuchungen dieser Flammschutzmittel von der Wiege bis zur Bahre.
Das Fraunhofer-Institut für Umwelt, Sicherheits- und Energietechnik (Umsicht) ver-

glich nun im Auftrag von Clariant in einer Lebenszyklusanalyse erstmalig die Umweltauswirkungen von flammgeschützten Kunststoffen für Ladestecker und elektronische Geräte. Gleichzeitig ist diese Analyse Teil einer Fallstudie für die Europäische Kommission entsprechend der Leitlinie «Safe and Sustainable-by-Design», die Lebenszyklusbewertungen – und nicht nur die Toxizität – als Bewertungskriterium in der Chemikalienentwicklung vorsieht. Clariant vermarktet die untersuchte Flammschutzformulierung unter dem Handelsnamen «Exolit OP 1400». Dieses enthält das Flammschutzmittel Diethylphosphinsäure (DEPAL) für dessen Herstellung u. a. gelber Phosphor, Natronlauge und Calciumhydroxid benötigt werden.
Ohne Antimontrioxid
Die Forschenden kamen zu dem Ergebnis, dass die Umweltbelastungen des Exolit OP 1400 insgesamt geringer ist und daher eine praktikable Alternative zu herkömmlichen bromierten Flammschutzmitteln in technischen Kunststoffen darstellt. «Der Einsatz von phosphororganischen Flammschutzmitteln wie Aluminiumdiethylphosphinat (DEPAL) verringert deutlich die negativen Auswirkungen auf die menschliche Gesundheit und Umwelt», erklärt Dr. Daniel Maga, Autor der Ökobilanzierung vom Fraunhofer Umsicht. Die Umweltvorteile bestehen vor allem in der Ressour-

In Kunststoffbauteilen der Ladestecker für EAutos stecken Flammschutzmittel wie auch in vielen anderen elektronischen Produkten, Textilien oder auch Möbeln. (Bild: Fraunhofer Umsicht)
censchonung, da kein Antimontrioxid wie bei den bromierten Formulierungen benötigt wird. Antimon zählt seit 2010 zu den 14 von der EU als kritisch eingestuften Rohstoffen.
Der CO2-Fussabdruck der Phosphor-Alternative ist zwar nur geringfügig kleiner als der von bromierten Flammschutzmitteln, was vor allem auf die energieintensive Gewinnung von Phosphor aus Phosphatgestein zurückzuführen ist. Durch einen höheren Anteil erneuerbarer Energien in der Phosphorproduktion könnte dieser aber reduziert werden. Weiterhin ist die Entsorgung von Exolit OP 1400 weniger umweltbelastend und ermöglicht in der Zukunft eine bessere Kreislaufführung.
www.umsicht.fraunhofer.de

Fragen Sie uns danach und wir legen Ihren Jahresbedarf bei uns auf Lager

39 4–5/2024 Sicherheit
VICI Schweiz AG Sarbachstrasse 5 · CH-6345 Neuheim Telefon +41 41 757 51 51 info-schweiz@vici.ch · www.vicischweiz.ch
Spritzenfilter
Vials und Caps
Fluor-freie Faser ist besser als PFAS-Imprägnierung
Wasserabweisende Textilfasern ohne PFAS
Regenjacken, Badehosen oder Polsterstoffe: Textilien mit wasserabweisenden Eigenschaften benötigen eine chemische Imprägnierung. Fluor-haltige PFAS sind zwar wirkungsvoll, schaden aber der Gesundheit und reichern sich in der Umwelt an. Empa-Forschende entwickeln nun ein Verfahren mit alternativen Substanzen, mit dem sich umweltfreundliche wasserabweisende Textilfasern erzeugen lassen. Erste Analysen zeigen: Die «guten» Fasern weisen Wasser stärker ab und trocknen schneller als die der herkömmlichen Produkte.
Soll eine Badehose nach dem Schwimmen ihre Form behalten und schnell trocknen, muss sie zwei Eigenschaften kombinieren: Sie muss elastisch sein und darf sich nicht mit Wasser vollsaugen. Eine derartige wasserabweisende Wirkung lässt sich in der Textilindustrie durch das Behandeln der Textilien mit Chemikalien erreichen, die das elastische Kleidungsstück mit sogenannten hydrophoben Eigenschaften ausstatten. In den 1970er-Jahren begann man, hierfür neuartige synthetische Fluorverbindungen einzusetzen –Verbindungen, die bedenkenlos unzählige Anwendungsmöglichkeiten zu bieten schienen, sich später aber als höchst problematisch herausstellten. Denn diese Fluor-Kohlenstoff-Verbindungen, kurz PFAS, reichern sich in der Umwelt an und schaden der Gesundheit.
Empa-Forschende entwickeln daher gemeinsam mit Schweizer Textilunterneh -


Dirk Hegemann, Empa St. Gallen, entwickelt Plasma-Beschichtungsverfahren für umweltfreundliche Textilien. (Bild: Empa)
men alternative umweltfreundliche Verfahren, mit denen sämtliche Fasern wasserabweisend ausgerüstet werden können. Dirk Hegemann vom «Advanced Fibers»-Labor der Empa in St. Gallen über das Projekt: «Wir setzen hochvernetzte Siloxane ein, die silikon-ähnliche Schichten
The Original Filter Papers since 1883
The Original
Go and explore our range of high-quality products!
The Original Filter Papers since 1883
• Filter papers
• Thimbles
erzeugen und – anders als fluor-haltige PFAS – unbedenklich sind.»
In Plasmawolken gehüllt
Die Plasma-Beschichtungsanlagen der Empa reichen von handlichen Tischmodellen bis hin zu raumfüllenden Geräten. Für
The Original Filter Papers since 1883
Go and explore our range of high-quality products!
Go and explore our range of high-quality products!
• Membranes

• Filter papers
• papers
• Thimbles
• Thimbles
• Syringe Filters New! PES Membranes Syringe Filters

• Membranes
• Membranes
• New! Membranes Syringe Filters
• New! Membranes










4–5/2024 Verfahrenstechnik
Andrea Six
lifescience.hahnemuehle.com
Diagnostic Environment Food & Beverage Microbiology Molecular Biology
lifescience.hahnemuehle.com
NEW CATALOGUE Life Science Diagnostic Environment Food & Beverage Microbiology Molecular Biology
lifescience.hahnemuehle.com
NEW CATALOGUE Life Science Food & Beverage Microbiology
G ewerbestrasse 10 C H - 4 4 5 0 Sissach Tel + 41 61 971 8 3 4 4 Fa x + 41 61 971 8 3 4 5 info @ sebio ch ww w seb o ch 1 5 vreS n g Sc encein Sw erland
1 Andrea Six, Empa

Mikroskopie, 20-fache Vergrösserung – Wo Wasser nicht benetzen kann: Selbst gedehnte Fasern lassen den Wassertropfen (bläulich) abperlen. (Bild: Cilander/Empa)
die Faserbeschichtung werden die Siloxane in einem reaktiven Gas zerstäubt und aktiviert. Auf diese Weise behalten sie ihre funktionalen Eigenschaften und umschliessen die Textilfasern mit einer nur 30-Nanometer-feinen wasserabweisenden Hülle. Derart beschichtete Fäden lassen sich da nach zu wasserabweisenden Textilien jeg licher Art verarbeiten, etwa zu Kleidungs stücken oder technischen Textilien wie Polsterstoffe.
Der Vorteil gegenüber herkömmlichen nasschemischen Verfahren: Selbst bei komplex strukturierten Textilien ist die lü ckenlose Verteilung der hydrophoben Sub stanzen bis in alle Windungen der ver schlungenen Fasern gewährleistet. Dies ist zentral, denn schon eine winzige benetz bare Stelle würde genügen, damit Wasser in die Tiefe einer Badehose eindringt und so das schnelle Trocknen des Kleidungs stücks verhindert. «Es ist uns sogar gelun gen, selbst anspruchsvollere, elastische Fasern mit dem neuen Verfahren dauerhaft zu imprägnieren, was bisher nicht möglich war», so Hegemann.
Grosses Interesse seitens Industrie
bereits deutlich leidet, bleibt die fluor-freie Faser auf hohem Niveau. Damit ist sie trotz Beanspruchung doppelt so wasserabweisend und trocknet deutlich effizienter. Hegemann und sein Team sind nun daran, das fluor-freie Laborverfahren zu leistungsfähigen und wirtschaftlich tragfähigen industriellen Prozessen zu skalieren. «Die Industrie ist an nachhaltigen PFAS-Alternativen sehr interessiert», sagt der Forscher. Die Schweizer Textilunternehmen Lothos KLG, Beag Bäumlin & Ernst AG und AG Cilander sind mit an Bord, wenn es darum






geht, umweltfreundliche fluor-freie Textilien zu entwickeln. «Eine gelungene Zusammenarbeit, die Materialien, Fasertechnologie und Plasmabeschichtung kombiniert und zu einer innovativen, nachhaltigen und effektiven Lösung führt», sagt Dominik Pregger von Lothos. Bernd Schäfer, CEO von Beag, fügt an: «Die Technologie ist umweltfreundlich und verfügt gleichzeitig über ein interessantes wirtschaftliches Potenzial.»
www.empa.ch


In ersten Laboranalysen schneiden Textilien aus den neuen Fasern mit umweltfreundlicher Beschichtung bereits leicht besser ab als herkömmliche PFAS-beschichtete Stoffe: Sie saugen weniger Wasser auf und trocknen schneller. So richtig ins Gewicht fallen die wundersamen Eigenschaften der fluor-freien Beschichtung aber erst nach mehrmaligem Waschen der Textilien: Während die herkömmliche PFAS-Imprägnierung bei dehnbaren Textilien

Ihre Experten für Reproduzierbarkeit






Große Applikations-Vielfalt Ideale Trennungen für kleine und Bio-Moleküle
Nano- bis (semi)präparativer Maßstab



Robuste und hocheffi ziente (U)HPLC
Schneller, kompetenter und individueller Support Ihr Erfolg ist unsere Priorität! Profi tieren Sie vom YMC-Expertenwissen.












Bleiben Sie up-to-date mit dem YMC Expertise Portal www.ymc-schweiz.ch | info@ymc-schweiz.ch | + 41 61 561 80 50




41 4–5/2024 Verfahrenstechnik
Korrelation zwischen PFAS-Spiegel und schädlichen Blutfetten
PFAS im Blut – ein kardiovaskuläres Risiko?
Forschende des Deutsche Zentrum für Neurodegenerative Erkrankungen (DZNE) haben nachgewiesen, dass Spuren der allgegenwärtigen PFAS im menschlichen Blut mit ungünstigen Fettprofilen und daher mit einem erhöhten Risiko für Herz-Kreislauf-Erkrankungen einhergehen.
Seit ihrer Erfindung in den 1950er-Jahren sind Schätzungen zufolge mehr als 10 000 verschiedene Substanzen aus der Kategorie der per- und polyfluorierten Alkylverbindungen, kurz: PFAS, entwickelt worden. Wegen ihrer wasser-, fett- und schmutzabweisenden Eigenschaften kommen sie in tausenden Produkten wie Kosmetik, in Zahnseide, aber auch in Pfannen-Beschichtungen und in Löschschaum zum Einsatz. Neben ihrer chemischen Grundkonstruktion haben PFAS eine weitere Gemeinsamkeit: Sie sind so gut wie nicht abbaubar – deshalb ihre Bezeichnung als «Ewigkeitschemikalien». Insbesondere über das Grundwasser gelangen sie in die menschliche Nahrungskette.
Jüngere besonders betroffen
Die Befunde der Forschenden sind der jüngste Beitrag zur aktuellen Diskussion über die Wirkung von PFAS auf die Gesundheit des Menschen. «Wir sehen deutliche Anzeichen für eine gesundheitsbedenkliche Wirkung von PFAS. Und wir haben festgestellt, dass bei gleicher PFASKonzentration im Blut die negativen Effekte bei jüngeren Probanden stärker ausgeprägt sind als bei älteren», sagt Prof. Dr. Dr.
Über die Rheinland Studie

Monique Breteler, Direktorin für Populationsbezogene Gesundheitsforschung am Deutschen Zentrum für Neurodegenerative Erkrankungen (DZNE). Die Ergebnisse der Untersuchung legten ausserdem nahe, dass schon relativ niedrige PFAS-Konzentrationen im Blut mit ungünstigen BlutfettProfilen verbunden sind.
«Unsere Daten zeigen einen statistisch signifikanten Zusammenhang zwischen PFAS im Blut und schädlichen Blutfetten, die mit
Seit 2016 erforscht das DZNE im Rahmen einer auf Jahrzehnte angelegten, bevölkerungsbasierten Studie im Bonner Stadtgebiet Faktoren, welche die menschliche Gesundheit bis ins hohe Alter beeinflussen. Dabei steht das Gehirn im Fokus. Studienteilnehmende werden alle paar Jahre zu einer Bestandsaufnahme ihrer körperlichen und geistigen Fitness eingeladen und die Entwicklung ihrer Gesundheit wird erfasst. Das Untersuchungsprogramm dauert jeweils sieben Stunden. Es beinhaltet die Sammlung von Biomaterialien wie Blut und Urin, Befragungen zum Lebensstil, Untersuchungen des Herz-Kreislauf-Systems, Tests der kognitiven Fähigkeiten und körperlichen Fitness sowie eine Vielzahl weiterer Untersuchungen, die sich modernster Medizintechnik bedienen – inklusive Hirnscan im Magnetresonanztomografen.

einem kardiovaskulären Risiko assoziiert sind. Je höher der PFAS-Spiegel, desto höher ist die Konzentration dieser Fettstoffe. Strenggenommen ist das noch kein Beweis dafür, dass die Ewigkeitschemikalien Verursacher der ungünstigen Blutfett-Profile sind. Doch die enge Korrelation stützt diesen Verdacht. Sie ist ein starkes Argument für eine strengere Regulierung von PFAS, um die Gesundheit zu schützen», so die Forscherin. Auffällig sei, dass bei nahezu allen Probanden PFAS im Blut nachgewiesen werden konnte. Man könne diesen Chemikalien also nicht entgehen. «Auch wenn wir für die von uns untersuchten Probanden keine unmittelbare Gesundheitsgefährdung sehen, so ist die Situation dennoch bedenklich. Denn auf lange Sicht kann sich das erhöhte Risiko sehr wohl auf Herz und Kreislauf negativ auswirken», so Breteler. Grundlage für die aktuelle Untersuchung waren die «Rheinland Studie» des DZNE (siehe Kasten) und die sogenannte NEOStudie aus den Niederlanden («Netherlands Epidemiology of Obesity study»). Forschende des DZNE arbeiteten dafür mit Fachleu-
42 4–5/2024 Umwelt
Blutproben im Labor. (Symbolbild: DZNE/Haagman)
ten des niederländischen Leiden University Medical Center zusammen. Die Blutproben von insgesamt mehr als 2500 Frauen und Männern im Alter zwischen 30 und 89 Jahren flossen in die Analysen ein. Dabei kam modernste Technik zum Einsatz. «Erst seit wenigen Jahren gibt es die Technologie, um Blutproben mit der Genauigkeit zu untersuchen, die für unsere Fragestellung notwendig ist», sagt DZNE-Forscherin Elvire Landstra. Sie ist, gemeinsam mit einem Kollegen aus Leiden, Erstautorin der Fachpublikation, die in der Fachzeitschrift Exposure and Health erschien.
Bislang detaillierteste Studie
Die Blutproben wurden mittels «Massenspektrometrie» detailliert untersucht. Die
Forschenden fokussierten sich in ihrer Analyse auf drei der am weitesten verbreiteten Chemikalien-Arten – PFOA, PFOS und PFHxS – und ermittelten zusätzlich die Konzentration von 224 Blutfetten, Metaboliten und Aminosäuren. «Mit diesem sogenannten Untargeted Approach – also einem bewusst breit angelegten Ansatz ohne vorgefasster Zielrichtung – konnten wir den Zusammenhang zwischen der PFAS-Konzentration und einem nachteiligen Profil an Fettstoffen, sogenannten Lipiden, nachweisen. Dazu gehören das allgemein bekannte Cholesterin und diverse andere Blutfette, die als Risikofaktoren für Herz-Kreislauf-Erkrankungen bekannt sind», erklärt Elvire Landstra. Wesentliche Unterschiede zwischen den Proben aus
Bonn (D) und Leiderdorp (NL) gab es nicht. «Unsere Untersuchung ist die bislang detaillierteste zu diesem Thema und diejenige mit der grössten Datenbasis. Bisherige Studien hatten eine Korrelation zwischen PFAS und gesundheitsbedenklichen Blutfetten bereits nahegelegt, aber so deutlich wie in unserer Studie hatte sich dieser Zusammenhang nicht gezeigt.» Künftige Studien könnten nach Ansicht der Bonner Forschenden auf spezifische Bereiche des Körpers eingehen. «Wir haben uns das Blutbild angeschaut. In einem nächsten Schritt wäre es sinnvoll, das Vorkommen von PFAS in einzelnen Organen zu untersuchen», sagt Monique Breteler.
www.dzne.de
Nur ein Fünftel der Bäche in gutem Zustand
Eine Untersuchung von 99 Schweizer Bächen zeigt: Die Mehrheit weist wesentliche Defizite beim ökologischen Zustand auf und kann ihre Funktion als Lebensraum für Tiere nur eingeschränkt erfüllen. In über 70 Prozent der untersuchten Gewässer fehlen Insektenlarven und andere Kleinlebewesen, die empfindlich auf Pestizide reagieren.
Kleine Bäche und Flüsse bilden den grössten Teil des 65 000 Kilometer langen Gewässernetzes der Schweiz, und sie beherbergen eine vielfältige Fauna. Viele dieser Gewässer sind aber stark von menschgemachten Beeinträchtigungen betroffen. Fast ein Viertel ist eingedolt oder es wurden andere Veränderungen an der Struktur der Bachbetten vorgenommen. Zudem sind die Bäche in stark landwirtschaftlich genutzten Einzugsgebieten oft durch Pestizide belastet.
Um ein differenziertes Bild über den ökologischen Zustand der Schweizer Bäche zu

Rund 100 Bäche in der ganzen Schweiz wurden in der Studie untersucht. (Grafik: Ilg & Alther, 2024, überarbeitet von Eawag)
erhalten, wurden 99 Bäche des Mittellandes, Teilen des Juras und der Talebenen grösserer Täler beprobt. Die Studie wurde durchgeführt von der VSA-Plattform Wasserqualität, der Eawag und der Universität Zürich.
Die Auswahl soll ein möglichst unterschiedliches Ausmass menschlicher Einflüsse abdecken. Als Indikatoren für die Beurteilung wurden Fische und Makrozoobenthos gewählt. Unter Makrozoobenthos werden mit blossem Auge sichtbare, wirbellose Organismen am Gewässergrund zusammengefasst. Einzelne Arten dieser Gemeinschaft reagieren sehr empfindlich gegenüber Veränderungen in ihrer Umwelt, zum Beispiel auf Schadstoffe oder Verbauungen im und am Gewässer oder auf die Landnutzung im Einzugsgebiet. Die Diversität der kleinen Tiere ermöglicht daher wichtige Rückschlüsse auf die Wasser- und Gewässerqualität.
Empfindliche Insekten fehlen aufgrund von Pestiziden
Die Untersuchungen des Makrozoobenthos und der Fische zeigen, dass die in
früheren Studien dokumentierten grossen Belastungen kleiner Fliessgewässer mit Pestiziden aus der Landwirtschaft zum Fehlen von empfindlichen Insekten in den Gewässern führen. Die Mehrheit der untersuchten Bäche kann ihre Funktion als Lebensraum für Tiere nur eingeschränkt erfüllen. An knapp 80 Prozent der Stellen ist eine Beeinträchtigung dieser Wasserlebewesen durch menschliche Einflüsse sichtbar. Nur an etwa 20 Prozent der Stellen ist die Lebensgemeinschaft naturnah und standortgerecht.
Die Studie bestätigt, dass die Insektengemeinschaften in einem grossen Teil der Schweizer Bäche mit einer zu hohen Pestizidbelastung und einem schlechten ökomorphologischen Zustand stark gestört sind. Sie unterstreicht damit die Dringlichkeit von Massnahmen zum Schutz und zur Aufwertung dieser Gewässer. Eine Reduzierung der menschlichen Einflüsse ist entscheidend, um die Lebensräume für Tiere zu erhalten und die Biodiversität zu schützen.
www.eawag.ch

43 4–5/2024 Umwelt
Naturtrübe Apfelsäfte fördern Darmgesundheit
Eine Studie der Deutschen Sporthochschule Köln, der Leibniz Universität Hannover und der Universität Wien zeigt, dass sich das Trinken von naturtrüben Apfelsaftschorlen positiv auf die Funktion der Darmbarriere auswirkt. Der Darm ist ein zentrales immunogenes Organ und beeinflusst das gesamte Immunsystem. Er muss einerseits Nährstoffe aufnehmen, anderseits als Barriere wirken und pathogene Bakterien abwehren. Eine intakte Darmbarriere ist somit nicht nur für die Gesundheit des Darms, sondern auch für den gesamten Organismus von zentraler Bedeutung.

Neben der rehydrierenden Wirkung begünstigen naturtrübe Apfelsaftschorlen die Regeneration des Darms. (Bild: Envato)
Verschiedene Untersuchungen zeigen, dass die sportliche Aktivität und die Zufuhr von Nahrungsstoffen einen Einfluss auf die Darmbarriere haben. So
belegen Studien eine verminderte Barrierefunktion bei extremen körperlichen Belastungen wie etwa einem Marathon. Ähnliches wurde bei fettreicher Diät oder fruktose-reicher Ernährung festgestellt.
Der Konsum von zuckerhaltigen Getränken nach intensiver körperlicher Belastung wurde in vielen Studien bereits als regenerationsfördernd beschrieben. Daher wird der Konsum kohlenhydrathaltiger Sportgetränke nach körperlicher Belastung empfohlen. Viele Sportler greifen hier auch zu der natürlichen Alternative in Form von Fruchtsäften oder Fruchtsaftschorlen.


DENIOS PRODUKTWELTSICHERES ARBEITEN IM LABOR
Die neue Erkenntnis: Das Trinken von naturtrüben Apfelsaftschorlen wirkt sich positiv auf die Funktion der Darmbarriere aus, sowohl im Alltag als auch nach körperlicher Belastung. Hinzu kommt, dass die Aufnahme von Zuckern nach körperlicher Belastung die Regeneration des Darms verlangsamen kann. Werden die Zucker jedoch eingebettet in einer Fruchtsaftmatrix aufgenommen, wie bei naturtrüben Apfelsäften, können diese negativen Effekte deutlich abgemildert werden.
www.uni-hannover.de
LÖSUNGEN FÜR GESETZESKONFORME
GEFAHRSTOFFLAGERUNG UND SICHEREN UMGANG IM LABOR
W Gefahrstoffschränke, Auffangwannen und Kleingebinderegale für brennbare und agressive Stoffe
W Laborflaschen und Laborbehälter, Pumpen, Trichter und Probenehmer sowie Chemikalienbindemittel für den täglichen Umgang
W Persönliche Schutzausrüstung (PSA), Gefahrstoffarbeitsplätze wie auch Notduschen für Körper und Augen zwecks vollumfänglichem Mitarbeiterschutz
W Unverzichtbare Ausstattung und Geräte wie Labormikroskope, Laborwaagen, Labormöbel, Sicherheits- und Entsorgungsbehälter
WWW.DENIOS. CH/LABORBEDARF
44 AUS DER FORSCHUNG 4–5/2024










Weshalb rollt sich bedrucktes Papier auf?

Für ihre Versuche haben Ulrich Hirn (r.) und Alexander Maass Papier mit Modelltinte besprüht und anschliessend eine Woche lang beobachtet, um die Krümmung zu messen. (Bild: TU Graz, Lunghammer)
Einseitig bedrucktes Papier rollt sich nach einigen Tagen auf. Forschende der Technischen Universität Graz haben entdeckt, dass dies an Lösungsmitteln in der Tinte liegt, die mit der Zeit in Richtung der unbedruckten Seite des Papiers wandern. Bislang war unbekannt, warum einseitig bedrucktes Papier nach einigen Stunden bis Tagen beginnt, sich aufzurollen, nachdem es im Inkjet-Verfahren bedruckt wurde und nach dem Drucken und Trocknen eigentlich glatt war. An der TU Graz wurde jetzt herausgefunden, dass dies aufgrund der Lösungsmittel in der Tinte geschieht. Diese wandern in Richtung der unbedruckten Seite durch das Papier und lassen die Zellulosefasern auf der unbedruckten Seite aufquellen.
Die Forschenden haben A4-Druckerpapier mit Modelltinte bestehend aus Wasser und Glycerin besprüht und eine Woche lang mit einem Laserscanner beobachtet. Während mit Wasser besprühtes Papier sich nach 24 Stunden nicht weiter einrollte, hielt der Prozess bei dem mit Tinte besprühtem Papier eine Woche lang an. Der Grund: Das Glycerin, das im Gegensatz zu Wasser erst bei sehr hohen Temperaturen verdunstet, wanderte langsam aber stetig von der besprühten Seite des Papiers auf die andere Seite.
Temperature control in pe ection –
Diesen Prozess konnten die Forschenden nachweisen, indem sie zu verschiedenen Zeitpunkten einige der Papierproben in hauchdünne Lagen auftrennten und den jeweiligen Glycerin-Gehalt bestimmten – in den oberen, besprühten Schichten ging dieser kontinuierlich zurück, in den unteren nahm es zu. Da Glycerin, ähnlich wie Wasser, Zellulosefasern aufquellen lässt, veränderte sich im Versuchszeitraum das Volumen der verschiedenen Papierschichten: Die Lagen nahe der besprühten Seite schrumpften, die tieferen Lagen quollen auf. So rollte sich das Papier kontinuierlich eine Woche lang.
Glycerin ersetzen?
«Zur Lösung des Problems könnte man Glycerin durch andere Lösungsmittel ersetzen. Das ist aber nicht so einfach, weil Glycerin der Inkjet-Druckfarbe wichtige Eigenschaften verleiht, die sie erst geeignet für den Tintenstrahldruck macht», erklärt Ulrich Hirn. Alternativ könnte man auch die Rückseite des Papiers bedrucken oder mit einem entsprechenden Anteil von Glycerin behandeln. Die Ergebnisse wurden in der Fachzeitschrift Materials & Design veröffentlicht.
www.tugraz.at

Entdecken Sie die neue MATIC Produktelinie
Einfache Bedienung
Modular erweiterbar
Konnektivität für Ihre Bedü nisse
Energiee izient und ökologisch
Entwickelt und in der Schweiz gebaut















4–5/2024
Global presence Branches Distributors Headquarters and production Switzerland Swiss made
www.tool-temp.ch
Aus Abfall wird Gold
Schon im Mittelalter und der frühen Neuzeit wollten die Alchemisten Unedles in Gold zu verwandeln. An der ETH ist jetzt Ähnliches gelungen: Es wurde zwar kein anderes chemisches Element in Gold verwandelt, doch mithilfe eines Nebenprodukts aus der Käseherstellung wurde aus Elektroschrott Gold gewonnen. Elektroschrott enthält verschiedene wertvolle Metalle, darunter Kupfer, Kobalt und auch relevante Mengen an Gold. Dieses aus ausgedienten Smartphones und Computern zurückzugewinnen ist wegen der steigenden Nachfrage nach dem Edelmetall von Interesse. Bisherige Rückgewinnungsverfahren sind allerdings energieintensiv und benötigen hochgiftige Chemikalien. Die Gruppe von Prof. Raffaele Mezzenga präsentiert nun eine effiziente, kostengünstige und viel nachhaltigere Methode: Mit einem Schwamm aus einem Proteingeflecht ist es ihr gelungen, Gold aus Elektroschrott herauszufischen.
Für die Herstellung des Schwammes nutzten die Forschenden Molkenproteine. Diese denaturierten sie bei grosser Hitze und mit Säure, sodass sie in einem Gel zu Protein-Nanofasern aggregierten. Dieses Gel trockneten sie, wodurch ein Schwamm aus diesen Proteinfasern entstand. Um im Laborversuch Gold zurückzugewinnen, wurden die Metallteile der Elektronikleiterplatten von 20 alten Computern entfernt und in einem Säurebad aufgelöst, sodass die Metalle darin als Ionen vorlagen.
Legten die Forschenden den Proteinfaserschwamm in die Metallionen- Lösung, lagerten sich die Gold-Ionen an die Proteinfasern an. Auch andere Metall- Ionen können sich an die Fasern anlagern, Gold-Ionen lagern sich jedoch viel effizienter an als diese. In einem nächsten Schritt wurde der Schwamm erhitzt. Dadurch kristallisierten die Gold- Ionen zu Flocken, welche schliesslich zu einem Goldnugget eingeschmolzen wurden. Aus den

Das grösste ist rund fünf Millimeter breit: Das aus Computer- Leiterplatten gewonnene Goldnugget in drei
Leiterplatten erhielt man ein rund 450 Milligramm schweres Nugget mit einem Anteil von 91 Prozent Gold an der Gesamtmasse (der Rest ist Kupfer). Dies entspricht knapp 22 Karat.
Die Technologie ist wirtschaftlich: Die Kosten für die Beschaffung der Ausgangsmaterialen und die Energiekosten des ganzen Prozesses sind zusammen 50 mal geringer als der Wert des Goldes, das zurückgewonnen werden kann.
Neben Elektroschrott haben die Forschenden auch Industrieabfälle aus der MikrochipHerstellung oder von Vergoldungen im Visier. Ausserdem wollen sie untersuchen, ob sie die Proteinfaserschwämme auch aus anderen proteinhaltigen Neben- oder Abfallprodukten der Lebensmittelindustrie herstellen können.
https://ethz.ch
ENERGIEKOSTEN EINSPAREN
Erfahren Sie mehr über Ihr Einsparpotential. Wir zeigen Ihnen gerne persönlich unsere neuen individuellen Lösungen.
Lassen Sie sich von unseren Experten beraten.
info@buschag.ch I www.buschvacuum.com

46 AUS DER FORSCHUNG 4–5/2024
BIS ZU
Teilen. (Bild: ETH/Alan Kovacevic)
Mechanismus entdeckt
Die Zelldegeneration kann Entzündungen und Funktionsstörungen im gesamten Körper verursachen. An der Universität Freiburg wurde jetzt herausgefunden, dass eine spezifische medikamentöse Behandlung diesen Zustand lindern kann, indem sie einen bestimmten Mechanismus stimuliert. Jede unserer 15 Billionen Zellen produziert Abfallprodukte, die «recycelt» werden müssen. Das Problem: Die Effizienz unseres intrazellulären Reinigungssystems, die Autophagie, nimmt mit zunehmendem Alter ab. Die Auswirkungen sind besonders in den Neuronen spürbar, wo sich Abfallstoffe ansammeln, die zu chronischen Entzündungen und zum Absterben der Neuronen führen können. Eine in der Fachzeitschrift Nature Communications publizierte Studie der Universität Freiburg und dem CSIC in Spanien hat untersucht, ob unsere Zellen trotz des Alterungsprozesses eine andere, spezifischere Art der Autophagie bewahren, die Mitophagie. Diese ist auf die Erhaltung und das Recycling der Mitochondrien, den Energiekraftwerken unserer Zellen, spezialisiert.
An Mäusepopulationen konnten mithilfe eines Fluoreszenzmarkierungssystems gezeigt werden, dass die Mitophagie im Laufe ihres Alterungsprozesses stabil blieb oder sogar zunahm – in allen Organen. «Wir vermuteten, dass dies eine Strategie der Zellen ist, um die Ausbreitung mitochondrialer DNA im Zytoplasma zu verhindern. Nun ist es aber genau diese Ausbreitung, die eine Abwehrreaktion und damit eine Entzündung auslöst», erklärt Patricia Boya. Um diese

Verbesserte kognitive Funktionen durch Stimulierung der Mitophagie. (Bild: Adpic)
Hypothese zu testen, verabreichten die Forschenden am Autophagie-Labors der Universität Freiburg älteren Mäusen Urolithin A, eine Substanz, die bekannt dafür ist, die Mitophagie zu stimulieren. «Wir wollten sehen, ob wir damit diesen Mechanismus stimulieren und die Zellen künstlich dazu anregen, aufzuräumen.»
Neuroin flammation könnte reduziert werden
Die Nagetiere wiesen dann tatsächlich niedrigere Entzündungswerte auf, was sich in einer Verbesserung ihrer kognitiven, visuellen und motorischen Funktionen niederschlug. Da das Experiment in Zellkulturen von älteren menschlichen Spendern reproduziert wurde, weist darauf hin, dass das Phänomen zwischen den Arten auf systemischer Ebene erhalten bleibt. Die altersbedingte Neuroinflammation könnte also durch die Stimulierung der Mitophagie reduziert werden. Der Vorteil: Diese Strategie beeinträchtigt die Physiologie des Immunsystems nicht und hat keine immunsuppressive Wirkung.
www.unifr.ch


Neue Plattformgeneration
Lean. Effective. Agile. Platformized.– das Versprechen für innovative, plattformbasierte Ventile:

• Systemübergreifende Schnittstellen für mehr Flexibilität
• Optimale Anpassung an Betriebs- und Anlagenverhältnisse
• Elektrifizierter, intelligenter und vernetzter als je zuvor Entdecken Sie die Zukunft der Ventiltechnik.
ACHEMA 2024 Halle 8/Stand F4

leap.gemu-group.com

47 AUS DER FORSCHUNG 4–5/2024
GEMÜ P40, D40 und S40 mit Stellungsrückmelder GEMÜ 12A0
Neuer Produktkatalog
Die Firma Dr. Möller & Schmelz GmbH, Hersteller von Nährkartonscheiben und gebrauchsfer-

tigen Agar- und Flüssignährmedien für die Getränkeindustrie, hat einen neuen Gesamtkatalog zur Ergänzung der anwendungsspezifischen Broschüren für Brauereien und Mineralwasser- und Softdrink-Abfüller aufgelegt. Neben der übersichtlichen Präsentation der Produktpalette, bietet der neue Katalog die Möglichkeit, über das Erfassen von QR-Codes aktuelle weiterführende Informationen zu den einzelnen Produkten abzurufen. Das spart Zeit für zusätzliche Recherche, die sinnvoller im Labor eingesetzt werden kann.
www.sebio.ch
Tochterfirma gegründet
Der Hersteller von Isolatorsystemen für aseptische Produktionsprozesse baut aus und eröffnet in Brasilien ein Tochterunternehmen.
Die Skan Gruppe sieht im brasilianischen Markt erhebliches Potenzial für ihre Isolatorsysteme und hat im Februar eine lokale Vertriebsgesellschaft gegründet. Durch die Gründung der «Skan do Brasil» sichert sich das Unternehmen einen Zugang zu diesem Zukunftsmarkt. Thomas Huber, CEO der Skan Gruppe, sagt: «Unser Anliegen ist die Ausbildung von Servicepersonal nach den Schweizer Standards, die unsere Kunden vor Ort den bestmöglichen Service und Sup -

port bieten können.» Der erste Auftritt des Unternehmens wird die Messe FCE Pharma Brasilien, die Anfang Juni in São Paulo stattfindet, sein.
www.skan.ch






Besuchen Sie uns ACHEMA Halle 4.0, Stand A24


48 AUS DER BRANCHE 4–5/2024
(Bild: Getty Images)
(Bild: Sebio)
Patentanmeldungen in der Schweiz
Nach wie vor führend
Das Europäische Patentamt (EPA) verzeichnete 2023 mit 199 275 Patentanmeldungen einen neuen Höchststand. Die Schweiz steht erneut an der Spitze des Länderrankings mit den meisten Patentanmeldungen pro Einwohner.
Mit 9410 Patentanmeldungen haben Erfinderinnen und Erfinder sowie Unternehmen aus der Schweiz 2023 das Rekordergebnis von 2022 übertroffen. Mit Blick auf die Gesamtzahl der eingereichten europäischen Patentanmeldungen belegt die Schweiz den siebten Platz weltweit und den dritten Rang in Europa. Der neue Patentindex weist erstmals auch auf den Innovationsbeitrag von Frauen. 2023 kamen von allen Schweizer Patentanmeldungen 29 Prozent mit der Nennung von mindestens einer Erfinderin. Dies liegt zwar über dem europäischen Durchschnitt, jedoch deutlich unter Spanien (46%), Frankreich (33%) und Belgien (32%), den drei hier führenden Ländern.
Auch 2023 war die Eidgenossenschaft im Patentindex mit 1085 Anmeldungen pro Million Einwohner das Land mit der höchsten Zahl an Patentanmeldungen pro Kopf. Damit liegt sie erneut an der Spitze und verzeichnete etwa mehr als doppelt so viele Patentanmeldungen pro Kopf wie

Patentanmeldungen stehen als wichtiger Frühindikator für die Investitionen der Unternehmen in die Forschung und unterstützen die Vermarktung von Erfindungen. (Bild: Adpic)
das zweitplatzierte Schweden (495 Einreichungen pro Million Einwohner). Dieser Wert gilt als wesentlicher Indikator für die Innovationsstärke eines Landes.
Über 17 Prozent mehr Patente aus der Chemie
Das führende Technologiefeld für Patentanmeldungen aus der Schweiz war erneut die Medizintechnik mit 1010 Anmeldungen. Europaweit belegt die Schweiz damit den zweiten Platz in diesem Sektor – hinter Deutschland – und liegt weltweit auf Platz drei.
Auf dem zweiten Rang im nationalen Ranking liegen die Konsumgüter, gefolgt von der Messtechnik. Eine starke Zunahme der Patentanmeldungen aus der Schweiz verzeichnete neben dem Transportwesen die Chemie mit einem Plus von 17,2 Prozent im Vergleich zum Vorjahr.
Fünf Kantone dominieren
Das EPA verzeichnete für die Kantone Zürich (neu auf Platz 1), Waadt (Platz 2), und Basel-Stadt (Platz 3) die meisten Patentanmeldungen. Zusammen mit den Kantonen Zug (Platz 4) und Genf (Platz 5) machen die Top 5 der Kantone fast 60 Prozent aller Patentanmeldungen aus der Schweiz aus. Unter den Top 100 der anmeldestärksten Regionen innerhalb der 39 EPA-Mitgliedstaaten finden sich 16 Kantone.
In der Rangliste der anmeldeaktivsten Schweizer Firmen war Hoffmann-La Roche mit 754 Patentanmeldungen 2023 erneut Spitzenreiterin. Auf Platz zwei aus der Schweiz folgt Japan Tobacco International (706), dahinter liegen Philip Morris (527), ABB (488) und Nestlé (443).
www.epo.org





49 AUS DER BRANCHE 4–5/2024 L&R Kältetechnik GmbH & Co. KG Hachener Straße 90 a-c 59846 Sundern-Hachen Tel. 02935 9652 0 info@lr-kaelte.de www.lr-kaelte.de INDUSTRIEKÄLTEANLAGEN STEUERUNGSTECHNIK H2O-TECHNOLOGY TIEFTEMPERATURTECHNIK KÄLTETECHNIK EINSATZFÄLLE FÜR EXTREME
SGAS fordert zu ihrem Vierzigsten mehr Unterstützung
Die Schweizerische Gesellschaft für Arbeitssicherheit (SGAS) feiert am 25. April in Bern ihr 40-jähriges Jubiläum. Obwohl das Engagement der 1800 Spezialistinnen und Spezialisten dazu beigetragen hat, die Zahl der Berufsunfälle seit 1980 um die Hälfte zu senken, hat eine kürzlich durchgeführte Umfrage ein Optimierungspotenzial aufgezeigt.
Anfang 1984 wurde durch das gleichzeitige Inkrafttreten des Unfallversicherungsgesetzes (UVG) und der Verordnung über die Unfallverhütung (VUV) etwas Wichtiges gesetzlich verankert: Die Arbeitssicherheit und die Pflicht der Arbeitgeber, Sicherheitsfachleute beizuziehen, um die Ge -
sundheit und den Schutz der Arbeitnehmenden zu gewährleisten. So wurde im Juni 1984 die SGAS gegründet, mit dem Ziel, qualitativ hochwertige Weiterbildungen zu fördern, die Arbeit ihrer Mitglieder hervorzuheben und deren Interessen zu vertreten. Die SGAS bietet u. a. Fachtagungen, führt ein Register der Spezialisten für Arbeitssicherheit und einen Katalog an Ausbildungen mit Gütesiegeln.
Eine kürzlich durchgeführte Umfrage unter ihren Mitgliedern ergab, dass 62 Prozent die gesetzlichen Anforderungen in puncto Weiterbildung einhalten. Die 37,5 Prozent, die sich nicht auf dem neuesten Stand befinden, haben als


Hauptgründe mangelnde Unterstützung durch den Arbeitgeber, Zeitmangel oder Angst vor Bestrafung angegeben. Für die SGAS sind die Kontrollorgane dafür verantwortlich, dass die gesetzlichen Verpflichtungen betreffend der Übernahme der Weiterbildungskosten eingehalten werden. So dürfen Zeit und Kosten im Zusammenhang mit einer Ausbildung nicht zu Lasten der Mitarbeitenden gehen.
Zum Wohlstand beigetragen Für Cédric Cagnazzo, Unternehmer und Vorstandsmitglied der SGAS, geben diese Ergebnisse zu denken: «Die Sicherheit am Arbeitsplatz wird von Führungskräften, die mit anderen Prioritäten kämpfen, oft als Belastung betrachtet. Verschiedene Studien belegen jedoch, dass Prävention den Unternehmen zugutekommt, da Absenzen den Arbeitgebern viel Geld kosten. Die Ausbildung sollte daher als Investition betrachtet werden und die Meinung über Sicherheitsfachleute geändert werden.»
Die Spezialistinnen für Arbeitssicherheit tragen dank ihrem Engagement in Miliztätigkeiten zur Verbreitung einer Kultur der Gesundheitsprävention bei, nicht nur in Unternehmen, sondern auch in der Bevölkerung. Dieses Modell der Sozialpartnerschaft ist unbestreitbar ein Teil der DNA der Schweiz und hat zu ihrem Wohlstand beigetragen.
Postulat zur Unterstützung des Milizsystems Angesichts der Schwächung des Milizsystems haben die SGAS und Suissepro letztes Jahr eine Erklärung zur Unterstützung des Milizsystems in

Die SGAS konstatiert einen Mangel an Unterstützung der Unternehmen und zu wenig Kontrollen bei der Arbeitssicherheit. (Bild: Envato)
der Schweiz lanciert, um die Unternehmen für die Problematik zu sensibilisieren und sie zu ermutigen, konkrete Massnahmen zur Unterstützung von Mitarbeitenden, die sich engagieren möchten, zu ergreifen. «Mit 31 mitunterzeichnenden Unternehmen und Verbänden (Arbeitgeber und Gewerkschaften), die sich verpflichten, günstige Arbeitsbedingungen für Miliztätigkeiten zu schaffen, liegt das Ergebnis dieser Kampagne weit über unseren Erwartungen», erklärt Christian Wyssmüller, Präsident der SGAS. Es zeigt, wie sehr die Schweiz am Milizsystem hängt. Zahlreiche Persönlichkeiten haben uns ebenfalls ihre Unterstützung zugesagt, und wir freuen uns, dass Jean Tschopp, Nationalrat, ein Postulat eingereicht hat, in dem er den Bundesrat auffordert, etwaige Anreize und Unterstützungsmassnahmen zu prüfen, die es Arbeitnehmenden ermöglichen, sich für die Allgemeinheit zu engagieren, um unser Milizsystem weiterzuentwickeln.»
www.sgas.ch
50 AUS DER BRANCHE 4–5/2024
Drei
Marken unter neuem Dach
Busch Vacuum Solutions, Pfeiffer Vacuum und Centrotherm Clean Solutions vereinen sich unter dem Dach der Busch Group. Zusammen bieten sie ein umfangreiches Produktportfolio und ein verbessertes Kundenerlebnis.
Die neue Busch Group mit Hauptsitz im Schwarzwald (D) ist jetzt einer der weltweit grössten Hersteller von Vakuumlösungen, zu den Vakuumpumpen, Vakuumsysteme, Gebläse, Kompressoren und Abgasreinigungssysteme gehören. Über 8000 Mitarbeitende in 45 Ländern erwirtschaften einen konsolidierten Jahresumsatz von fast zwei Milliarden Euro. Durch die Bündelung der Expertise von Busch Vacuum Solutions in Grob- und Feinvakuum-Anwendungen, der branchenführenden Hochvakuum- und Lecksuch-Technologie von Pfeiffer Vacuum sowie der nachhaltigen Abgasreinigungs -

(Bild: Busch Group)
systeme von Centrotherm Clean Solutions bietet die Busch Group ab sofort umfassende Lösungen und Dienstleistungen für alle Industriebereiche an.
Weltweites Servicenetz
Zertifizierter Schutz gegen folgende Risiken:

Abriss der Firmengeschichten
Busch Vacuum Solutions – und jetzt auch die Busch Group – ist ein Familienunternehmen, dessen Leitung seit Anbeginn in den Händen der Familie Busch liegt. 1963 gründeten Ayhan und Dr.-Ing. Karl Busch gemeinsam das Unternehmen und entwickelten die erste Vakuumpumpe speziell für das Verpacken von Lebensmitteln. Als sich das Unternehmen zu einem weltweiten Pionier in der Vakuumindustrie entwickelte, traten ihre drei Kinder Ayla, Sami und Kaya Busch in die Geschäftsführung ein und brachten neue Perspektiven und Ansätze in das Unternehmen ein.
Pfeiffer Vacuum, Erfinder der Turbomolekular-Vakuumpumpe und heute Anbieter umfassender Vakuumlösungen, wurde 1890 gegründet und hat seinen Sitz im hessischen Asslar. Centrotherm Clean Solutions hat seinen Hauptsitz in Blaubeuren und blickt auf über dreissig Jahre Erfahrung in der Konstruktion technologisch führender Abgasreinigungssysteme für die Halbleiterindustrie zurück.
Als Komplettanbieterin mit umfangreichem Produktportfolio für alle Kundenbedürfnisse eröffnet die Busch Group ihrem Kundenstamm ein verbessertes Kundenerlebnis.
Die Technologien der drei Gruppenmitglieder sind rund um den Globus in sämtlichen Industrien zu finden. Von der Lebensmittelverpackung bis zur Logistik, von Mikrochips für elektronische Geräte über Medizintechnik bis zur Weltraumforschung: Die Busch Group bietet Lösungen für die unterschiedlichsten Anwendungen. Dazu gehören auch die Konzeption und der Bau massgeschneiderter Vakuumsysteme sowie ein weltweites Servicenetz – das sich jetzt über noch mehr Märkte erstreckt. Insgesamt produziert die Gruppe in 19 eigenen Werken in China, Deutschland, Frankreich, Grossbritannien, Indien, Rumänien, der Schweiz, Südkorea, Tschechien, den USA und Vietnam. In jedem Land bieten lokale, kompetente Teams massgeschneiderte Unterstützung an, wobei diese auch von einem globalen Expertennetzwerk unterstützt werden.
www.buschvacuum.com





4–5/2024 Persönliche Schutzausrüstung (PSA) ist Vertrauenssache Ihr Partner für Personenund Umweltschutz Pedi AG Köllikerstrasse 17 CH-5036 Oberentfelden Tel. 062 737 72 80 www.pedi.ch Pedi AG Köllikerstrasse 17 CH-5036 Oberentfelden Tel. 062 737 72 80 www.pedi.ch
Rutschsicher
für flexible
www.pedi.ch
unterwegs
Arbeitsplätze kein Durchkommen für Gefahrstoffe
Drei Unternehmen vereinen ihre Kräfte.
■ Infostelle SCV
Schweizerischer Chemieund Pharmaberufe Verband Postfach 509 CH-4005 Basel info@cp-technologe.ch www.cp-technologe.ch
■ Präsident Kurt Bächtold Bodenackerstrasse 15F CH-4334 Sisseln praesident@cp-technologe.ch
SEKTION FRICKTAL
Protokoll der Generalversammlung
22. März 2024
Ort: Wine&Dine, Spier 35, Elfingen
Beginn: 18.05 Uhr/Ende: 19.05 Uhr/Rahmenprogramm im Anschluss
Teilnehmer: Dieter Brunner, Daniel Giebson, Peter Siebenhaar, Filipp Chlebus, Stefan Petryna, Hans Gloor, Pierre Petryna, Thomas Weilandt, Fabio Laneri, Alois Leisibach, Kurt Bächtold, Andy Näf, Patrick Merkofer; Entschuldigt:
Traktanden
1. Begrüssung: Unser Präsident, Dieter Brunner, begrüsst um 18.05 Uhr die Teilnehmer der 36. GV der SCV-Sektion Fricktal. Wir freuen uns besonders über den Besuch des Zentralvorstands, in der Per-
son von Kurt Bächtold. Vor der GV fand bereits ein Apéro statt.
2. Wahl des Stimmenzählers: Hans Gloor wird zur Wahl des Stimmenzählers vorgeschlagen. Seine Wahl erfolgt einstimmig. Es sind 12 Personen anwesend, 12 sind stimmberechtigt. Das absolute Mehr beträgt 7.
3. Protokoll der 35. ordentlichen Generalversammlung: Das Protokoll der 35. ordentlichen Generalversammlung ist auf der Website des Verbands, www.cp-technologe. ch und in der Verbandszeitschrift ChemieXtra veröffentlicht.
3.1. Genehmigung des Protokolls: Das Protokoll wird einstimmig genehmigt.



■ Höhere Fachprüfung Chemietechnologe Daniel Müller weiterbildung@cp-technologe.ch
■ Termine Alle Termine online anschauen: www.cp-technologe.ch

4. Anträge: Es sind keine Anträge von Seite Mitglieder eingegangen. ZV-Anträge siehe unter Abschnitt 11.
5. Jahresbericht des Präsidenten: Dieter Brunner gibt in seinem Jahresbericht die Situation 2023 wieder. Der Jahresbericht wird separat auf der Website des Verbands, www. cp-technologe.ch/sektionen/ fricktal und in der Verbandszeitschrift ChemieXtra veröffentlicht.
6. Jahresbericht Veranstaltungen: Daniel Giebson blickt zusammen mit den Teilnehmern zurück auf ein aktives Verbandsjahr:
• Mai: Generalversammlung im Restaurant Zollhüsli
• September: Ebianum/Baggermuseum mit anschliessendem Abendessen
• November: Schoggiworkshop bei Beschle mit anschliessendem Apéro riche Zu den Veranstaltungen wurde jeweils ein Bericht in der ChemieXtra und auf der Website des Verbands veröffentlicht.
7. Jahresrechnung und Revisionsbericht: Filipp Chlebus stellt
die Jahresrechnung 2023 vor. Sie schliesst mit einer Vermögensabnahme von CHF 4354.57 ab. Grund sind nicht bezahlte Mitgliederbeiträge und ein budgetiertes Minus. Ein Teil der Mitgliederbeiträge sind im 2024 eingegangen und werden in diesem Jahr verbucht. Es wird entschieden, dass die Rechnung weiterhin per E-Mail versendet wird. Zahlungserinnerungen werden künftig per Post versendet. Die Kassenprüfer Andreas Ruess und Stefan Petryna bestätigen die tadellose Kassenführung und schlagen den Stimmberechtigten vor, die Decharge zu erteilen.
7.1. Genehmigung der Jahresrechnung: Die Decharge wird einstimmig erteilt.
8. Mutationen: Filipp Chlebus gibt einen Überblick über die Mitgliederzahlen sowie die Einund Austritte.
8.1. Aufnahme von Neumitgliedern: 1 neues Interessenmitglied. Die Aufnahme erfolgt einstimmig.
8.2 Statuswechsel: 3 Statuswechsel (neu in Pension)
8.3. Austritt/Ausschluss von Mitgliedern: 4 Austritte durch Kündigung. Neu gehören der Sektion Fricktal 64 Mitglieder an.
52 4–5/2024 VERBANDSSEITE
Ein Teil der Mitglieder, während die Rechnung durchgekaut wird. Das später auf dem Teller servierte Fleisch ist wesentlich zarter … (Bilder: Patrick Merkofer)


9. Budget: Basierend auf den Erfahrungen aus den letzten Jahren und den geplanten Aktivitäten hat Filipp den Budgetvorschlag 2024 erstellt. Die Details dazu werden den Teilnehmern erklärt. Das Budget sieht eine Vermögensabnahme von CHF 1770.– vor. Die Ausgaben für die Anlässe sind grosszügig bemessen. Es wird diskutiert, dass das Budget für das kommende Jahr keine weitere Vermögensabnahme mehr ausweisen soll.
9.1. Genehmigung des Budgets: Das Budget wird einstimmig genehmigt.
10. Jahresprogramm 2024: Daniel Giebson stellt das Jahresprogramm 2024 vor. Neben den Aktivitäten der Sektion Fricktal stehen unseren Mitgliedern auch die Aktivitäten der anderen Sektionen des SCV offen. Die Angebote der Sektion Fricktal im Überblick:
• 22. März 2024: GV im Wine & Dine Elfingen
• Ca. September (Termin wird bekanntgegeben): Novartis Campus Basel, mit anschliessendem Besuch der VoltaBrauerei
• 14. März 2025: Generalversammlung 2025. Ort und Zeit werden zu einem späteren Zeitpunkt bekannt gegeben
Alle Termine werden auf der Website des Verbands www.cp-technologe.ch und in der Verbandszeitschrift ChemieXtra veröffentlicht. Das Jahresprogramm wird einstimmig angenommen.
11. Bericht vom Zentralvorstand: Wir freuen uns besonders über die Teilnahme von Kurt Bächtold, dem Präsidenten des Zentralvorstands. Er nimmt die Gelegenheit wahr und gibt uns einen Überblick über die Verbandsaktivitäten im Zentralvorstand. Insbesondere sind personelle Veränderungen im Zentralvorstand per DV zu berichten. Weiterhin wird die Bildungsverordnung des Chemieund Pharmatechnologen EFZ turnusgemäss überprüft.
11.1 Anträge des Zentralvorstands zur DV 2024: Statutenänderungen:
• 3.1.2 Aktivmitglieder (einstimmig an unserer GV angenommen)
Die folgende Anpassung lässt die Bezeichnungen offen. Durch die abgeschlossene Berufsfeldanalyse und die jetzige Umsetzung werden sich Anpassungen ergeben, die damit bereits abgedeckt sind – Aktivmitglieder sind im Besitz des eidgenössischen oder eines gleichwertigen ausländischen Berufsausweises in einem chemischen Beruf oder einer höheren Fachausbildung oder eines akademischen Abschlusses. Sie besitzen das aktive und passive Stimm- und Wahlrecht. Sie bezahlen einen Jahresbeitrag (siehe Finanzreglement) an die Zentralkasse. Der Jahresbeitrag wird von der Delegiertenversammlung jeweils neu festgelegt.
• 4.2.2 Aufgaben und Befugnisse der DV (einstimmig an unserer GV angenommen)
• Ersatzlos gestrichen werden die folgenden Aussagen: Entgegennahme des Zweijahresberichts. Festsetzung der Subventionen für Beiträge
auf der Homepage und im Verbandsorgan. Separate Wahl des Vizepräsidenten ist zu streichen. Dafür ist der Kassier separat zu wählen.
• 4.3.1 Allgemeines (einstimmig an unserer GV angenommen)
• Als Folge Anpassung 4.2.2: Der ZV besteht mindestens aus fünf Mitgliedern der ihm angeschlossenen Sektionen. Er konstituiert sich selbst mit Ausnahme des Präsidenten und des Kassiers, welche von der DV gewählt werden.
Finanzieller Beitrag an den Zentralvorstand (einstimmig an unserer GV angenommen):
• Aussetzen der Sektionsbeiträge an den ZV für 2 Jahre. Der Jahresbeitrag der Sektionen an den ZV wird bis zur nächsten DV 2026 auf CHF 0.- pro Aktiv- und Passivmitglied festgelegt. Die Delegierten der Sektion Fricktal sind beauftragt, an der DV entsprechend zu stimmen.


53 4–5/2024 VERBANDSSEITE
Unsere GV-Teilnehmer lauschen den Worten des Gastgebers.
Thomas (links im Bild) referiert über den Rebbau.
Aufruf an unsere Mitglieder: Ein Verband lebt durch seine Mitglieder. Mitgliederwerbung lohnt sich beim SCV. Es winkt eine tolle Prämie für jedes neue Mitglied. Detailinformationen unter www.cp-technologe.ch und beim Vorstand.
Wine&Dine Elfingen: Leidenschaft ist die vielleicht beste Voraussetzung für Spitzener-
gebnisse. Im Wein&Dine zaubert Esther Villiger die Speisen zu, die zu den vorzüglichen Weinen des Guts passen. Für die Aufrechterhaltung der Tradition des Weinbaus ist Thomas Villiger verantwortlich, der zu Gunsten des Elfinger Pinot Noir vor über 20 Jahren auf eine Weinbau-Karriere im Piemont verzichtete. Neben Pinot Noir steht in Elfingen auch

Thomas, Andy und Dieter riskieren einen kurzen Blick in die Kamera, um dann weiter die Vorspeise zu geniessen.
SEKTION AARGAU
Protokoll der Generalversammlung
Teilnehmer: Daniel Müller, Josef Wäckerlig, Hansrudolf Plüss, Gerhard Furrer, Kurt Friderich, Marcel Dürr, Remo Kleeb, Janine Rytz, Patrick Schumacher, Patrick Spichiger, Madeleine Leuenberger, Patrik Moser
Entschuldigt: Marco Grünenfelder, Hansjörg Schmid, Patricia, Dryja, Daniel Hähner, Boris Krause, Patrick Merkofer, Christine Merz, Gerard Roxas, Bertram Zubler, Flavio Zumsteg
Gast: Kurt Berchtold
Vorsitz: Daniel Müller
Vorsitz: Restaurant Roggenhausen, Aarau
Gast: Josef Wäckerlig


Riesling auf dem Programm. Während die Trauben allesamt aus Elfingen stammen, erfolgt die Kelterung im Schaffhauser Neuenkirch.
Kochen ist Handwerk: Esthers Koch-Stil ist, wie sie selbst hervorhebt, mit der Einfachheit gepaart. Wo möglich kommen regionale Produkte aus Bioproduktion unters Messer. Auf dem Teller landen ehrliche Menüs ohne allzu viel Schnickschnack. Dass das Auge auch bei einfachen Menüs mitessen darf, versteht sich von selbst. Alle Informationen zum Wine&Dine Elfingen findest du hier: www.wdspier.ch
Unsere GV ist gesellig und kulinarisch hochstehend: Der Vorstand der SCV-Sektion Fricktal setzt sich aus Geniessern zusammen. Davon profitieren auch unsere Mitglieder.
Wir lassen uns während (und besonders nach dem offiziellen Teil) der GV verwöhnen. Alte Bekannte treffen, über gute und schwierigere Zeiten diskutieren und einfach eine gesellige Zeit miteinander erleben. In diesem Sinne steht das diesjährige Rahmenprogramm der GV SCV-Sektion Fricktal. Hast du unsere diesjährige GV verpasst? Schade! Umso mehr freuen wir uns auf deine Teilnahme im nächsten Jahr. Als Mitglied der SCV-Sektion Fricktal bist du am Puls des Geschehens, wenn es um Chemie, Pharma, Biotechnologie geht: Nahe am Beruf und Influencer, wenn es um die Entwicklung von Berufsbildern der Branche und ums Networking geht.
Merkofer, März 2024
Traktanden
1. Begrüssung: Daniel Müller eröffnet um 19:30 Uhr die GV, begrüsst die zahlreich erschienenen Mitglieder. Einige Mitglieder haben sich entschuldigt, dem Präsidenten liegt eine Absenz Liste vor. Auch der Präsident des ZV, Kurt Berchtold wird begrüsst.
2. Erstellen der Präsenzliste: Eine Präsenzliste ist in Zirkulation, mit der Bitte, dass sich alle einschreiben. Es sind 12 stimmberechtigte Mitglieder anwesend.
3. Wahl des Stimmenzählers: Zum Stimmenzähler wird einstimmig Remo Kleeb gewählt.
4. Protokoll vom 10.03.23: Das Protokoll wird so genehmigt.
Daniel Müller verdankt die Arbeit des Protokollführers.
5. Jahresrückblick des Präsidenten: Rückblick 2023: Am 10.03.23 fand die GV mit 12 Personen statt.
Am 09.06.23 durften wir unter der Führung von Ivan Oberli die Altola besichtigen. Es war sehr interessant zu se -
hen was mit den Abfällen gemacht wird und viele Lösungsmittel abgemischt werden und so in die Zementfabrik als Heizmittel weiterverwendet. Am 20.10.23 trafen sich 8 Personen zu einem gemütlichen Abend bei Daniel Müller. Hansruedi Plüss verschickte wie üblich die Neujahrswünsche mit der Schokolade, herzlichen Dank. Der Jahresbericht des Präsidenten wird einstimmig genehmigt.
6. Mutationen/Wahlen: Mitgliederbestand per 01.03.2024:
54 4–5/2024 VERBANDSSEITE
Patrick
38 Aktivmitglieder, 2 Studenten, 1 Lehrling, 3 Pensionierte. Heinz Jäggi ist 2023 leider verstorben.
Daniel Müller, unser Präsident, hat seinen Rücktritt bekanntgegeben. Er hat im vergangenen Jahr nach einem Nachfolger gesucht, der nicht nur die Präsidentschaft der Sektion Aargau übernimmt, sondern auch seine Ämter im Zentralvorstand und dessen Gremien. Es ist ihm gelungen, Remo Kleeb zu überzeugen. Remo Kleeb wird einstimmig zum neuen Präsidenten gewählt.
Remo nimmt die Wahl an und bedankt sich für die Chance, die wir ihm geben. Daniel Müller wird ihn bei Bedarf weiterhin unterstützen. Es sind keine weiteren Demissionen bekannt.
Vorstand
Kassier: Hansrudolf Plüss
Aktuar: Josef Wäckerlig
Beisitzer: Hansjörg Schmid
Das Revisorenteam bleibt mit Daniel Häner und Gerhard Furrer bestehen. Als Ersatzrevisorin beibt Madeleine Müller bestehen.
Der Vorstand und das Revisorenteam werden einstimmig gewählt.
Daniel Müller bedankt sich beim Vorstand und den Revisoren für die gute Zusammenarbeit.
7. Kassa- Revisorenberichte: Kassaberichte: Hansrudolf Plüss zeigt die Rechnung mit Abschluss per 29.02.2024. Revisorenberichte: Die Rechnungsrevisoren Gerhard Furrer und Daniel Häner haben für die Zeitspanne vom 1. März 2023 bis am 29. Februar 2024 die Jahresrechnung geprüft.
Folgendes wird festgestellt:
• Die Belege für das Vereinsjahr 2023 sind vollständig vorhanden und stimmen mit der Buchhaltung überein
• Die Bilanz und die Erfolgsrechnung stimmen mit der Buchhaltung überein und die Buchhaltung wurde sauber und ordnungsgemäss geführt
• Ein Verlust ist zu verzeichnen: Dieser geht daher hervor, da keine Jahresbeiträge der Mitglieder für das Jahr 2023 erhoben wurden
• Die gesetzlichen Bestimmungen werden eingehalten
• Aufgrund der Ergebnisse der Prüfung stellen wir den Antrag an die Generalversammlung, die vorliegende Jahresrechnung zu genehmigen und dem Kassier Hansruedi Plüss Entlastung zu erteilen
• Dem Vorstand sei ebenfalls Entlastung zu erteilen
Der Antrag wird einstimmig angenommen.
Budget: Der Schwerpunkt wird auch im kommenden Jahr wieder auf gesellschaftlichen Aktivitäten liegen.
Budgetierte Ausgaben 2023: Fr. 1600.–
Budgetierte Einnahmen 2023: Fr. 1055.–
Budgetierter Verlust: Fr. 545.–
Das Budget wird einstimmig genehmigt.
Die gute Arbeit des Kassiers wird verdankt.
8. Festsetzen des Mitgliederbeitrages: Der ZV verzichtet vorerst für die nächsten zwei Jahre auf den Beitrag von Fr. 45.– pro Mitglied. Im Gegenzug werden keine Subventionen mehr zum Beispiel für Beiträge in der ChemieXtra oder der Website aus-
bezahlt. Die Abogebühren der ChemieXtra werden vom ZV übernommen. Man hofft mit diesen Massnahmen neue Mitglieder zu gewinnen.
Vorschlag mit dem Vorbehalt, dass der Verzicht auf den Jahresbeitrag an der nächsten DV beschlossen wird: Den Jahresbeitrag von Fr. 65.– auf Fr. 25.–zu senken.
Der Vorschlag wird einstimmig angenommen. Studenten werden wie Lernende (in Ausbildung) behandelt und sind vom Mitgliederbeitrag befreit.
9. Jahresprogramm 2023: Daniel Müller hat zusammen mit Remo Kleeb ein paar Vorschläge ausgearbeitet.
• Generalversammlung am 14.03.25 um 19:30 Uhr im Wildpark Roggenhausen.
• Firmenbesichtigung der Methrom in Zofingen am 07.06.24 um ca. 16 Uhr
• Gemütliches Zusammensein bei Daniel Müller am 20.09.24 um ca. 19 Uhr
Die Jahresprogramme anderer Sektionen sind auch für uns zugänglich. Es sind verschiedene Besichtigungen und Ausbildungen geplant.
Das genaue Programm kann auf der Website www.cp-technologe.ch eingesehen werden oder wird in unserem Verbandsorgan ChemieXtra www.chemiextra.com publiziert.
Die genauen Daten des Programms werden durch Hansrudolf Plüss zusammen mit der Rechnung für den Jahresbeitrag an die Mitglieder verschickt. Das Programm wird so genehmigt.
Für die nächsten Jahre werden ein paar Vorschläge gemacht:
• Besichtigung des Belchentunnels. Kurt Friedrich könnte bei Bedarf einen Kontakt vermitteln.
• Besichtigung des Stahlwerks Tyssen Krupp in Deutschland. Dies wäre ein mehrtägiger Ausflug.
10. Diverses und Umfrage:
• Kurt Fridrich: Der Werkstattkurs wurde von 24 Teilnehmern besucht. Es wurde versucht, das Niveau zu steigern. Es scheint momentan schwierig zu sein, gute Lernende zu finden. Ein Bericht für die ChemieXtra wird verfasst. Wer darf Mitglied beim SCV werden?
Die Statuten des ZV besagen unter Punkt 3.1.2: «Aktivmitglieder sind Chemikanten oder CP-Technologen, die im Besitze des eidgenössischen oder eines gleichwertigen ausländischen Berufsausweises sind, Chemietechnologen mit eidg. Diplom, sowie an den Berufen Interessierte mit einer Berufsausbildung im chemisch-technischen Bereich» An der DV soll der Antrag gestellt werden, alle Chemieberufe zuzulassen.
Die Sektion Aargau lässt bereits jetzt alle Chemieberufe zu.
• Kurt Berchtold: Die DV findet am 15.06.24 in Bern statt.
• Allgemeine Frage: Ist es möglich, die Teilnehmerliste mit den Handy-Nummern zu versenden?
Dies ist aus Datenschutzgründen problematisch. Die Liste wird heute Abend aufgelegt und kann freiwillig mit den Handy-Nummern ergänzt werden. Interessierte können die Liste am Schluss der GV abfotografieren.
Um 20:30 Uhr endet die GV. Daniel Müller lädt alle im Namen der Sektion Aargau zum Nachtessen ein.
Josef Wäckerlig, März 2024


55 4–5/2024 VERBANDSSEITE
SEKTION NORDWESTSCHWEIZ
Jahresprogramm 2024
Für dieses Jahr hat der Vorstand der SCV-Sektion Nordwestschweiz das folgende Jahresprogramm zusammengestellt:
Samstag, 18. Mai
Besuch Genusswelt im Läckerli Huus Frenkendorf
Kosten für Mitglieder: 5 CHF (Nichtmitglieder: 8 CHF)

Samstag, 6. Juli
Grill auf der Sichtern Kosten für Mitglieder: keine (Nichtmitglieder: 5 CHF)
Bitte eigene Grilladen mitnehmen. Verschiebedatum: 20. Juli
Samstag, 12. Oktober
Italienische Salsiccia selber produzieren
Kosten für Mitglieder: 30 CHF (Nichtmitglieder: 40 CHF)
Freitag, 8. November
Bowling & Jahresabschluss Kosten für Mitglieder: keine (Nichtmitglieder: 10 CHF)
Details zu den einzelnen Veranstaltungen werden jeweils nach der Anmeldung zugestellt. Das Inkasso wird an der Veranstaltung gemacht.
Anmeldung
Anmeldungen zu den Veranstaltungen werden bis spätestens zwei Wochen vor dem Termin erbeten. Bitte senden Sie dazu Ihren Namen sowie die Anzahl der teilnehmenden Personen an folgende E-MailAdresse: SCV-Sektion-NWS@ bluewin.ch
Vielen Dank!
Vorankündigung 2025
Die 27. Generalversammlung findet am Freitag, 7. Februar 2025, statt. Die Einladungen zur GV werden im Dezember 2024 verschickt.


Der Vorstand i. V. Martin Nagel SCV-Sektion-NWS@bluewin.ch





Wir bieten Automatisierungssysteme für: Laborreaktorsysteme
Batch- & Flow-Prozesse
reproduzierbare & sichere Ergebnisse

VERBANDSSEITE
Bowling zum Jahresabschluss. (Bild: Adpic)
Jetzt Gratis-Ticket anfordern! Beschleunigen Sie
Laborprozesse!
Ihre
Mini - Hochdruck-Reaktoren
Robuste Zahnradpumpe
Anfang 2023 übernahm die Maag Gruppe den Pumpenhersteller Witte. Eine erste gemeinsame Produktentwicklung wird jetzt auf der Achema präsentiert.

Die beiden Unternehmen haben sich zusammengeschlossen, um eine neue Generation von Zahnradpumpen zu schaffen, die neue Massstäbe für Effizienz, Zuverlässigkeit und Leistung setzen soll. Die neue «Chem-X»-Zahnradpumpe –ein erstes Resultat der synergetischen Partnerschaft – wurde für die anspruchsvollsten Anwendungen in verschiedenen Branchen entwickelt. Die Pumpe verfügt über ein fortschrittliches Zahnraddesign, das für minimale hydraulische Pulsation und maximalen volumetrischen Wirkungsgrad optimiert ist. Die Verwendung innovativer Materialien stellt sicher, dass die Pumpe
aggressiven Chemikalien und hohen Temperaturen standhält, ohne ihre Lebensdauer oder Leistung zu beeinträchtigen. Die Chem-X kann mit einem intelligenten Steuerungssystem ausgestattet werden. Diese Systeme ermöglichen die Überwachung und Anpassung in Echtzeit und stellen sicher, dass die Pumpe unter verschiedenen Prozessbedingungen mit höchster Effizienz arbeitet.
Maag Pump Systems AG CH-8154 Oberglatt welcome@maag.com www.maag.com
Ventiltechnologie – Sprung in die Zukunft
Mit der Einführung einer neu entwickelten Produktgeneration setzt Gemü zu einem grossen Sprung –dem LEAP – nach vorne an. LEAP, eine Abkürzung für «Lean. Effective. Agile. Platformized.» verkörpert sowohl fortschrittliche Produkte in modularer Bauweise als auch eine innovative Produktionsmethode.
Auf der Achema stellt das Unternehmen die Vorreiter seiner neuen Produktgeneration exklusiv vor. Zu den ersten Produkten zählen:
• GEMÜ D40 – ein pneumatisch betätigtes Membranventil
GEMÜ S40 – ein pneumatisch betätigtes Sitzventil

GEMÜ P40 – ein pneumatisch betätigtes Bodenablassventil
GEMÜ 12A0 – ein elektrischer Stellungsrückmelder
Die neuen Ventile verfügen über einheitliche Antriebsmodule auf
Plattformarchitektur, um eine flexible Anpassung an unterschiedliche Anforderungen zu ermöglichen. Der elektrische Stellungsrückmelder GEMÜ 12A0 verfügt über moderne Kommunikationsschnittstellen und integrierte Sensorik. Kompatibel mit den Ventiltypen der neuen Plattformgeneration bietet er eine platzsparende, einfache Möglichkeit zur Automatisierung.
Gemü Vertriebs AG Ventil-, Mess- und Regelsysteme CH-6343 Rotkreuz vertriebsag@gemue.ch www.gemue.ch
Non-invasive Signalisierung für raue Prozesse
Durch die Überwachung der sicherheits- und betriebskritischen Druckentlastungseinrichtungen schaffen Berstscheiben und Signalisierungssysteme einen erheblichen betrieb -

lichen Mehrwert, wobei selbst für raue chemische Prozesse wiederverwendbare Überwachungssysteme verfügbar sind.
In der gesamten Chemiebranche sind Prozesse mit hohen Temperaturen und hochkorrosiven Medien weit verbreitet. Dabei muss das Risiko von ungewollten Betriebszuständen auf Grund unzulässiger Überdrücke durch ein schnelles und sicheres Abschalten reduziert werden.
Sind konventionelle Signalisierungen mit extremen Bedingungen nicht immer kompatibel, werden in die Prozessleittechnik als zusätzliches Überwachungssystem oftmals weitere Signalisierungen integriert. Sie sind heute in bestimmten Varianten
für hohe Dichtigkeitsanforderungen ausgelegt und arbeiten non-invasiv. Durch schnelle Signalisierung über das Ansprechen der Berstscheibe tragen sie zur Prozesssteuerung und zur Verminderung von Stillstandzeiten bei.
Der Einsatz moderner Signalisierungseinrichtungen erweist sich als Pluspunkt für Produktivität und Sicherheit und ist weiterführend mit Blick auf Umweltbelange notwendig und sinnvoll.
Paliwoda AG CH-8703 Erlenbach info@paliwoda.ch www.paliwoda.ch
Mini - Hochdruck-Reaktoren
Mini - Hochdruck-Reaktoren

- Edelstahl, Edelstahl/Hastelloy, Hastelloy - mit und ohne PTFE-Auskleidung - 10 ml bis 100 ml / bis 300°C / 200 bar
Kleine Hochdruck-Reaktoren
– Edelstahl, Edelstahl/Hastelloy, Hastelloy – mit und ohne PTFE-Auskleidung
– 10 ml bis 100 ml – bis 300°C / 200 bar
- Edelstahl, Edelstahl/Hastelloy, Hastelloy - mit und ohne PTFE-Auskleidung - 10 ml bis 100 ml / bis 300°C / 200 bar
Kleine HochdruckReaktoren
Kleine Hochdruck-Reaktoren
- Edelstahl, Edelstahl/Hastelloy, Hastelloy - mit und ohne PTFE-Auskleidung - 10 ml bis 100 ml / bis 300°C / 200 bar
Kleine Hochdruck-Reaktoren
- Edelstahl, Edelstahl/Hastelloy, Hastelloy - mit und ohne PTFE - 15
All

- Edelstahl, Edelstahl/Hastelloy, Hastelloy - mit und ohne PTFE-Auskleidung - 150 ml bis 300 ml / bis 300°C / 200 bar
– Edelstahl, Edelstahl/Hastelloy, Hastelloy
– mit und ohne PTFE-Auskleidung
All-In-One-System
– 150 ml bis 300 ml
– bis 300°C / 200 bar
- Edelstahl, Edelstahl/Hastelloy, Hastelloy - mit und ohne PTFE-Auskleidung - 150 ml bis 300 ml / bis 300°C / 200 bar
- Intelligentes Rührsystem, Heizen, Kühlen - Auswertung von Temperatur, Druck und Rührung - Datenlogging via PC-Software Hil-Trade GmbH
Dorfstrasse 26 / 8902 Urdorf
Tel. 044 777 17 29
Email: Web: www.
- Intelligentes Heizen, Kühlen
- Auswertung von Temperatur, Druck und Rührung
- Datenlogging via PC Hil-Trade GmbH

Intelligentes Rührsystem – Heizen und Kühlen
All-In-One-System - Intelligentes Rührsystem, Heizen, Kühlen - Auswertung von Temperatur, Druck und Rührung
Dorfstrasse 26 / 8902 Urdorf Tel. 044 777 17 29 Email: info@hiltrade.ch Web: www.hiltrade.ch
- Datenlogging via PC-Software
Hil-Trade GmbH Dorfstrasse 26 / 8902 Urdorf Tel. 044 777 17 29 Email: info@hiltrade.ch Web: www.hiltrade.ch

www.berghof.com


57 PRODUKTE 4–5/2024
Mini-HochdruckReaktoren
All-In-One-System
–
–
Mini-Reaktor bis 25 ml oder bis 40 ml BR-Reaktoren 75 ml bis 5700 ml Reaktor-Systeme -Edelstahl -Hastelloy Hil-Trade Gmb H Dorfstrasse 26 CH-8902 Urdor f Telefon 044 77 7 17 2 9 info@hiltrade.ch
Berghof Hoch& Nieder-DruckReaktoren mit & ohne PTFE-Lining
–
Auswertung von Temperatur, Druck und Rührung
Datenlogging via PC-Software www.berghof.com
www.hiltrade.ch
Mini-Reaktor bis 25 ml oder bis 40 ml BR-Reaktoren 75 ml bis 5700 ml Reaktor-Systeme
-Hastelloy Hil-Trade Gmb H Dorfstrasse 26 CH-8902 Urdor f Telefon 044 77 7 17 2 9 info@hiltrade.ch
-Edelstahl
www.hiltrade.ch
Der kleinste der Welt
Er ist in die bürstenlosen Motoren der «22xx...BX4»-Familie integriert und verfügt sowohl über umfangreiche Funktionen als auch Leistung: Der neue integrierte MotionController «22xx…BX4 IMC». Der Längenzuwachs im Vergleich zum einzelnen Motor beträgt nur 18 mm und beinhaltet einen vollwertigen Servocontroller sowie einen 12-Bit-Encoder. Dabei kann die volle Leistung der Motoren in den unterschiedlichsten Ausführungen genutzt werden.
Die Ausführung mit RS232-Schnittstelle ermöglicht die Einbindung vom PC und über embedded Master, die CANopen-Ausführung eignet sich für industrielle Automatisierungsnetzwerke. Die direkte Unterstützung durch gängige SPS ist durch die Konformität mit dem «CiA 402 Servo Drive»-Standard sichergestellt. Aber auch mit der RS232-Version können mehrere

Antriebe über einen einzigen Master-Port gesteuert werden. Der integrierte Motion-Controller kann typische Aufgaben wie das Homing eines Antriebs direkt über seine

Arbeiten in neuen Mustern.
Bis zu 17‘800 m2 massgeschneiderte Gewerbeflächen für Einzelunternehmer bis zum Global Player direkt beim Bahnhof Basel SBB.
lokalen digitalen und analogen I/Os übernehmen. Alternativ können beide Ausführungen auch ohne Master als «Standalone» betrieben werden. In die -
sem Fall werden seine digitalen und analogen I/Os sehr flexibel für lokale Steuerungsaufgaben oder für diskrete Soll- und Istwerte genutzt. Weitere Features sind eingebaute Stromregelung (für Überlast-Schutz), Diagnosefunktion und niedrige EMV-Emissionen.
Die bürstenlosen Motoren mit dem neuen integrierten Motion-Controller sind beispielsweise geeignet für Anwendungen in Medizin und Labor, Automatisierung, Robotik oder industrielle Sondermaschinen. Gemäss Hersteller das kompakteste Motion-Control-System auf dem Markt.
Mikrowellen-Aufschlüsse zur spektrometrischen Elementanalyse werden noch schneller und komfortabler – und sie lassen sich sogar mit einer eingebauten Kamera beobachten und so besser optimieren. Die Aufschlussgeschwindigkeit liegt bei herkömmlichen Geräten bei gut einer Stunde zuzüglich der Abkühlung auf Raumtemperatur zur Weiterverarbeitung der Proben. Mit einer schnellen Mikrowelle reichen aber fünf Minuten inklusive Abkühlung für einen Aufschluss. Dann kann die Probe vermessen werden. Verschraubungen oder Werkzeugmontagen für die Druckbehälter gehören der Vergangenheit an. Und viele unterschiedliche Proben lassen sich individuell mit den geeigneten Säuren und Programmen abarbeiten.
Ein integrierter Autosampler kann das unbeaufsichtigte Abarbeiten aller Proben auch über Nacht erlauben. Mit externen Roboterzugriffen können die Aufschlussgefässe zudem in das Mikrowellen-Aufschlussgerät bewegt werden sowie

Faulhaber SA CH-6980 Croglio info@faulhaber.ch www.faulhaber.com

die Dosierung der Reagenzien erfolgen.
Die integrierte Kamera sorgt für Durchblick bei der Aufschlussreaktion, macht Aufschluss-Verläufe sichtbar und vereinfachen so die Methodenoptimierung.
CEM GmbH D-47475 Kamp-Lintfort info@cem.de www.cem.de
58 PRODUKTE 4–5/2024
via-basel.com
Mikrowellen-Aufschluss
Transportwagen mit Dämpfer und Kamlokflansch
In vielen industriellen Bereichen werden neben stationären Druckluft-Membranpumpen und Pulsa -

tionsdämpfern auch mobile Systeme benötigt. Beispielsweise als Notpumpen, als kurzfristiger Ersatz für eine defekte Pumpe oder für Umfüll- oder Reinigungsaufgaben. Für diese Zwecke bietet Almatechnik TDF selbst hergestellte Transportwagen oder Traggestelle an. Die neue Produktesparte Almatechnik Systeme bietet die Möglichkeit, das Pumpsystem nach den Betriebsbedingungen der Anwen -
dung zu konfigurieren. So können die Transportwagen mit Durchfluss- und Druckmessgeräten, Sicherheitsventilen oder Strömungswächter ausgestattet werden. Der Einbau von konfigurierbaren Schaltschränken ermöglicht es, die Geräte vollständig autonom und automatisiert zu betreiben um einen optimalen Betrieb zu garantieren. Dies bringt zahlreiche Vorteile mit sich, beginnend mit nur einem ein -
Cloud-Lösung unterstützt Dekarbonisierung
Unternehmen der Prozessindustrie können jetzt mit Cloud-Services ihren CO2-Fussabdruck auf der Basis europäischer Standards visualisieren und managen.
Zu den wichtigen EU-Standards zählen zum Beispiel das CBAM-System zur Bestimmung fairer Preise für CO2-intensiv gefertigte Waren oder der Digital Product Passport (DPP). Um solchen Bestimmungen gerecht zu werden, arbeitet ein Cloud-Service für das CO2-Emissionsmanagement mit Daten von Messsystemen und Überwachungsgeräten und berechnet daraus den CO2-Fussabdruck.
Ein solcher Service lässt sich in übergeordnete Systeme einbinden – bis hin zu ERP-Lösungen («Enterprise Resource Planning»). Sie ermöglichen ein weitreichendes









Management von Prozessen und sogar von ganzen Unternehmen. Dabei finden die Visualisierung und Steuerung des CO2-Fussabdrucks nach klimaneutralen Standards besondere Berücksichtigung.
Auf der betriebspraktischen Ebene erleichtert eine solche Komplettlö -

sung das Erstellen von Dashboards und Berichten, die den europäischen Emissionsgesetzen und -vorschriften entsprechen (z. B. WBCSD PACT, Catena-X). Als Cloud-Service ist die Lösung einfach zu aktualisieren, falls sich Gesetze und Vorschriften ändern.
zigen Lieferanten, über den Wegfall der Montagearbeiten bis hin zu der Gewissheit, ein getestetes und montiertes Plug-and-Play-System zu besitzen.
Almatechnik TDF AG CH-4314 Zeiningen info@almatechnik-tdf.ch www.almatechnik-tdf.ch
Auf der Management-Ebene ermöglicht die Komplettlösung, die CO2-Emissionen durch die Optimierung des Energieverbrauchs zu reduzieren und die Rohstoffbeschaffung zu verbessern. Ein Mittel dazu stellen Digitale Zwillinge (Digital Twin) dar. Zusätzlich können Beratungsdienstleistungen des Cloud-Anbieters zur Emissionsreduzierung und Hilfen bei der Umsetzung in Anspruch genommen werden.
Yokogawa Europe Branches B.V. Amersfoort Swiss Branch Allschwil 4123 Allschwil stefan.lugert@ch.yokogawa.com www.yokogawa.com/ch


NEXT LEVEL SOLUTIONS







































Die MAAG Group ist Partner der kunststoffverarbeitenden Industrie weltweit. Unsere integrierten Lösungen für Pumpen- und Filtrationssysteme sowie Pelletizing-, Pulvermühlen- und Recyclingsysteme zeichnen sich durch hervorragende Leistungen für anspruchsvolle Kundenanforderungen aus.

















PRODUKTE 4–5/2024
Integrated Systems for Polymer Processing maag.com NEW member of the MAAG Group: Besuchen Sie uns in Frankfurt a.Main 10.-14.6.2024 HALLE 8.0 STAND K78
Die Dichtung, die mitdreht
Die hygienischen CinchSeal Radialwellendichtungen der Serie 9700 für industrielle Mischer und Trockner sind aus Edelstahl gefertigt. Alle Innenteile entsprechen den FDA-Normen für indirekten Produktekontakt. Die geteilten Gleitringdichtungen werden für verschiedene Industrien wie die Lebensmittelherstellung sowie für die pharmazeutische und chemische Industrie empfohlen, die Edelstahlteile benötigen, um mit aggressiven Reinigungsmitteln umgehen zu können und um die hygienischen Anforderungen zu erfüllen. Alle Dichtungselemente sind geteilt, dies macht Installation und Umrüstung von Mischanlagen zu einem Kinderspiel. Viele Mischer und Trockner können einfach und problemlos von mechanischen Packungen auf die CinchSeal 9700 umgebaut werden. Aufgrund ihrer anpassungsfähigen Konstruktion können wir diese Dichtung zu ei -

nem sehr günstigen Preis anbieten, so dass sich die Investition schnell amortisiert. Eine CinchSeal Dichtung kann für eine chargenweise oder wöchentliche Reinigung sehr leicht demontiert werden, es sind kostengünstige Reparatursets erhältlich und die solide Ausführung sorgt für zuverlässigen und kontinuierlichen Betrieb während vielen Jahren.
Swissfilter AG CH-5037 Muhen info@swissfilter.ch www.swissfilter.ch

Praktisch alle unsterilen Spritzenfilter

Für die Filtration kleinerer wässriger oder organischer Flüssigkeitsmengen sind unsterile Spritzenfilter in jedem Labor unentbehrlich – gut, wenn sie mit allen gängigen Membranen und in allen Porengrössen und Durchmessern griffbereit sind. Beispielsweise reichen die Porengrössen in vier Stufen von 0,22 µm bis 5,0 µm. Das Membranmaterial besteht aus CME, Nylon, PES, PTFE oder PVDF. Die hydrophile Membran aus Cellulosemischester dient zur Filtration wässriger Lösungen. Die hydrophile Nylon-Membran ist
zur Filtration wässriger und vieler organischer Lösungen geeignet. Mit einer hydrophilen Membran aus Polyethersulfon können Abscheidungen feinster Partikel aus wässrigen Lösungen vorgenommen werden. Mit einer hydrophoben Membran aus Polytetrafluorethylen sind Filtrationen von organischen Lösungen und die Luftfiltration möglich. Eine hydrophile Membran aus Polyvinylidenfluorid ist zur Filtration wässriger und schwach organischer Lösungen geeignet. Das Gehäuse besteht je nach Ausführung aus PE, PP oder PVC. Als Anschlüsse sind ein Luer-Lock-Eingang sowie ein Luer-Ausgang vorhanden.
Roth AG CH-4144 Arlesheim info@carlroth.ch www.carlroth.ch
Effizienz steigern, Fehler reduzieren
Kompakt – Leistungsstark – Preiswert
TOC/TNb-Kompaktanalysator bei geringem Probenaufkommen
Schnelle Analysen bei einfachster Handhabung Sie benötigen lediglich eine 230V-Steckdose
DIN-konform nach EN 1484 und EN 12260 www.dimatec.de
Analysentechnik GmbH
DIMATEC
Analysentechnik GmbH
DE-79112 Freiburg (TB-Südwest)
Tel. +49 (0) 76 64 / 50 58 605 essen@dimatec.de www.dimatec.de

Labor | Wasser | Gas
Sie erhalten die DIMATEC-Systeme auch bei unserem Schweizer Vertriebspartner ensola AG 8902 Urdorf
Tel. +41 (0)44 870 88 00 info@ensola.com www.ensola.com
Die mit neuen Funktionen ausgestattete «Allianc iS Bio HPLC»-Plattform von Waters soll der QC-Analyse in der Biopharmazie helfen, die Effizienz zu steigern und übliche Fehler zu eliminieren. Das HPLC-System soll dabei helfen, strengere und sich entwickelnde Compliance-Anforderungen zu erfüllen und gleichzeitig kürzere Zeiträume für die Produktfreigabe zu erreichen.
Fortschrittliche Bio-Separationstechnologie kombiniert dieses Gerät mit integrierten intelligenten Gerätefunktionen. Das bio-inerte Gerätedesign zeichnet sich durch die «MaxPeak HPS»-Technologie von Waters aus, die auf wichtige interne Komponenten einschliesslich des Systemflusspfads angewendet wird, um unerwünschte Wechselwirkungen mit metalladsorbierenden Analyten zu reduzieren. Das System lässt sich mit den «QuanRecovery»Fläschchen und -Platten sowie HPLC-Säulen mit «eConnect»-Säulen-Tag-Technologie von Waters kombinieren und ermöglicht so zuverlässige Plattformmethoden, die eine langwierige Säulenkonditionierung und Methodenentwicklung überflüssig machen.

Um Labore bei der Erfassung, Verwaltung und Auswertung von Chromatografie-Testergebnissen zu unterstützen, kann das System auch mit der «Empower Chromatography»-Software des Herstellers kombiniert werden. Ausserdem Wissenswert: Das System lässt sich nahtlos in Flüssigchromatografiegeräte von Waters und anderen Herstellern integrieren.
Waters AG Täfernstrasse 14a CH-5405 Baden-Dättwil www.waters.com
60 PRODUKTE 4–5/2024 ensola
Wasseranalytik ohne Labor DIMA-easyTOC mit DIMA-easyTNb
ANTRIEBSTECHNIK
ANTRIEBSTECHNIK

AUTOMATION AUTOMATION


Ihr Spezialist für Anlagen und Prüfmittel in der ZfP www.helling.de

Helling GmbH Spökerdamm 2 D-25436 Heidgraben Tel.: +49 4122 922-0 info@helling.de

ABSPERRKLAPPEN FÜR DIE CHEMISCHE INDUSTRIE

FAULHABER SA Croglio · Switzerland Tel. + 41 91 611 31 00 www.faulhaber.com
Experts for Automated Processes!
HiTec Zang GmbH info@hitec-zang.de www.hitec-zang.de




ABSPERRKLAPPEN FÜR DIE CHEMISCHE INDUSTRIE



APPARATE-, ANLAGENUND MASCHINENBAU

APPARATE-, ANLAGENUND MASCHINENBAU

Rötzmattweg 105 CH-4600 Olten Tel. +41 (0)62 207 10 10
IEP Technologies GmbH info.iep.ch@hoerbiger.com - www.ieptechnologies.com

ABWASSERBEHANDLUNG ABWASSERBEHANDLUNG

Ihr Partner für individuelle Abwasserbehandlung FLONEX AG sales@flonex.ch CH-4127 Birsfelden www.flonex.ch Sternenfeldstrasse 14 Tel. +41 61 975 80 00 PUMPEN


Theodorstr. 10 | D-70469 Stuttgart Tel +49 711 897-0 | Fax +49 711 897-3999 info@coperion.com | www.coperion.com


APPARATEBAU ANLAGEN- UND APPARATEBAU




ARMATUREN

LABORMESSUND ANALYSEGERÄTETITRATION

Schweiz AG
Metrohm Schweiz AG Industriestrasse 13
CH-4800 Zofingen
Telefon +41 62 745 28 28


ANALYTIK UND ÖKOTOXIKOLOGIE
ARMATUREN
Telefax +41 62 745 28 00 E-Mail info@metrohm.ch www.metrohm.ch

ANALYTIK UND ÖKOTOXIKOLOGIE
Ihr Auftragsforschungslabor in Witterswil.
BEDIEN- UND VISUALISIERUNGSSYSTEME IM EX-BEREICH PROZESSAUTOMATION

Längfeldweg 116 · CH-2504 Biel/Bienne Telefon +41 32 374 76 76 · Telefax +41 32 374 76 78 info@ch.pepperl-fuchs.com · www.pepperl-fuchs.ch
BEHÄLTER AUS CHROMNICKEL ANLAGEN- UND APPARATEBAU


Industrie Neuhof 30 3422 Kirchberg Tel. +41 34 447 70 00 Fax +41 34 447 70 07 info@anlagenbau.ch www.anlagenbau.ch

Anlagenbau AG Ihr Partner für ProzesstechnikANLAGEN- UND APPARATEBAU





IES Ltd Benkenstrasse 260 4108 Witterswil Tel. + 41 (0)61 705 10 31 info@ies-ltd.ch www.ies-ltd.ch
ANLAGEN- UND APPARATEBAU ANLAGEN- UND APPARATEBAU

Industrie Neuhof 30 3422 Kirchberg

Anlagenbau AG

Verschraubungen, Ventile, Druckregler, Rohre u.v.m finden Sie in unserem Online-Shop:
www.hps-solutions.ch
ASEPTISCHE VENTILE


BERSTSCHEIBEN ASEPTISCHE VENTILE

BRANDSCHUTZ, EXPLOSIONSSCHUTZ




Tel. +41 34 447 70 00 Fax +41 34 447 70 07 info@anlagenbau.ch www.anlagenbau.ch
Ihr Partner für ProzesstechnikANLAGEN- UND APPARATEBAU




ANTRIEBSTECHNIK ANTRIEBSTECHNIK



Elektromotorenwerk
Brienz AG Mattenweg 1 CH-3855 Brienz Tel. +41 (0)33 952 24 24 www.emwb.ch



GEMÜ Vertriebs AG Schweiz Telefon: 041 799 05 55 E-Mail: vertriebsag@gemue.ch · www.gemue.ch


ASEPTISCHE VENTILE
ANDRÉ RAMSEYER AG

Industriestrasse 32 CH-3175 Flamatt Tel. 031 744 00 00 info@ramseyer.ch www.ramseyer.ch
AUFTRAGSANALYSEN
AUFTRAGSANALYSEN
In Grosswiesen 14 8044 Gockhausen/Zürich Tel 044 881 20 10 www emott ch / info@emott ch G GMMP P z zeerrttiiffiizziieerrt t Labor für Festkörperanalytik & Elektronenmikroskopie & XRD

6 LIEFERANTENVERZEICHNIS 61 4–5/2024 LIEFERANTENVERZEICHNIS 3-D LASERSCANNINGSPRAY 3-D LASERSCANNINGSPRAY P T
T LT R T
T
T
M
V
U
ROTOTEC AG 031 838 40 00 Luzernstrasse 224c info@rototec.ch 3078 Richigen www.rototec.ch Pumpen Verschleisstechnik Revisionen ROTOTEC AG 031 838 40 00 Luzernstrasse 224c info@rototec.ch 3078 Richigen www.rototec.ch Pumpen Verschleisstechnik Revisionen Pumpen Ersatzteile Instandhaltungen ALLGEMEINE
HPS-Solutions GmbH | Fraunhoferstr. 5 D-82152 Martinsried +49 (0) 89 744 926-0 | info@hps-solutions.de
ANDRÉ RAMSEYER AG Industriestrasse 32 CH-3175 Flamatt Tel. 031 744 00 00 info@ramseyer.ch www.ramseyer.ch
CSF Wunderle GmbH Ebnatstrasse 129 · CH-8200 Schaffhausen Tel. +41 52 6354040 · Fax +41 52 6354041 info@csfwunderle.com · www.csfwunderle.com BRANDSCHUTZ, EXPLOSIONSSCHUTZ CSF_LV_2.indd 1 25.01.24 08:52 ABSPERRKLAPPEN FÜR DIE CHEMISCHE INDUSTRIE IEP Technologies GmbH info.iep.ch@hoerbiger.com
Rötzmattweg 105 CH-4600 Olten Tel. +41 (0)62 207 10 10
HETTICH AG | 8806 Bäch SZ | +41 44 786 80 20 sales@hettich.ch | www.hettich.ch Succursale Suisse Romande (Canton de Vaud) Tél. +41 44 786 80 26
vertreiben
der folgenden Marken:
committed to science HUBERLAB. AG Industriestrasse 123 CH-4147 Aesch T +41 61 717 99 77 info@huberlab.ch www.huberlab.ch
- www.ieptechnologies.com
BRUTSCHRÄNKE / CO ² -BRUTSCHRÄNKE BRUTSCHRÄNKE/ CO2-BRUTSCHRÄNKE
Wir
und bieten Service für Brutschränke
CHEMIEDISTRIBUTION
Ihr Vollversorger für Chemikalien & Reagenzien CHEMIEDISTRIBUTION
CHROMATOGRAPHIESÄULEN CHROMATOGRAPHIESÄULEN
DOSIERPUMPEN DOSIERPUMPEN

Tel. +41 31 972 31 52
Fax +41 31 971 46 43 info@msp.ch www.msp.chCHROMATOGRAPHIESÄULEN


KNF Neuberger GmbH Business Unit Lab
Alter Weg 3 DE-79112 Freiburg Tel. +49 (0) 7664 5909 0 backoffice.lab@knf.com www.knf.com


Gewerbestrasse 10
CH-4450 Sissach
Tel. +41 61 971 83 44 Fax +41 61 971 83 45 info@sebio.ch www.sebio.ch

Liquidhandling
Spektrophotometrie
Zentrifugation
Sicherheitswerkbänke
CH-4460 Gelterkinden i nfo@hemotec.ch
Tel. +41 (0)61 981 66 33 w ww.hemotec.ch
DAMPFARMATUREN ASEPTISCHE VENTILE
Industriestrasse 32
CH-3175 Flamatt
ANDRÉ RAMSEYER AG
DRUCKBEHÄLTER ANLAGEN- UND APPARATEBAU




DRUCKREDUZIERVENTILE ASEPTISCHE VENTILE ANDRÉ RAMSEYER AG
Industriestrasse 32 CH-3175 Flamatt Tel. 031 744 00 00 info@ramseyer.ch www.ramseyer.ch
Tel. 031 744 00 00 info@ramseyer.ch www.ramseyer.ch
DICHTUNGEN
DICHTUNGEN
liquitec AG
Industrie Neuhof 54 CH-3422 Kirchberg


T +41 55 450 83 00
F +41 55 450 83 01


info@liquitec.ch www.liquitec.ch
DIENSTLEISTUNGEN
DIENSTLEISTUNGEN

DACHSER Spedition AG Regional Offi ce Switzerland Althardstrasse 355 CH-8105 Regensdorf Phone +41 (0)44 8721 100 dachser.regensdorf@dachser.com dachser.ch


DIENSTLEISTUNGEN

Technical Laboratory Services Europe GmbH & Co. KG
Weidkamp 180 DE-45356 Essen Tel. +49 201 8619 130 Fax +49 201 8619 231 info@teclabs.de www.teclabs.de
Herstellerübergreifender Service für HPLC und GC
DILUTOREN / DISPENSER
DILUTOREN / DISPENSER

Liquidhandling
Spektrophotometrie
Zentrifugation
Sicherheitswerkbänke
CH-4460 Gelterkinden info@hemotec.ch
Tel. +41 (0)61 981 66 33 www.hemotec.ch
DISPENSER / PIPETTEN
Socorex Isba S A • Champ-Colomb 7a • 1024 Ecublens socorex@socorex.com • www.socorex.com DISPENSER / PIPETTEN

FARBMESSUNG (FLÜSSIGKEITEN)
ELEKTROTECHNISCHE UND OPTISCHE SENSOREN

ELEKTROTECHNISCHE UND OPTISCHE SENSOREN

HAMILTON Bonaduz AG Via Crusch 8 · 7402 Bonaduz

Telefon +41 58 610 10 10 Telefax +41 58 610 00 10 contact.pa.ch@hamilton.ch www.hamiltoncompany.com


ERP-SOFTWARE ERP-SOFTWARE


casymir schweiz ag Fabrikmattenweg 11 CH-4144 Arlesheim www.casymir.ch kontakt@casymir.ch Tel. +41 61 716 92 22


ABSPERRKLAPPEN FÜR DIE CHEMISCHE INDUSTRIE
EXPLOSIONSSCHUTZ




Rötzmattweg 105 CH-4600 Olten Tel. +41 (0)62 207 10 10
IEP Technologies GmbH info.iep.ch@hoerbiger.com - www.ieptechnologies.com

EXPLOSIONSSCHUTZ, EX-GERÄTE (ATEX) PROZESSAUTOMATION

Längfeldweg 116 · CH-2504 Biel/Bienne Telefon +41 32 374 76 76 · Telefax +41 32 374 76 78 info@ch.pepperl-fuchs.com · www.pepperl-fuchs.ch
FABRIKPLANUNG


ASSCO Engineering AG Lerzenstrasse 10 · CH-8953 Dietikon www.assco.ch · info@assco.ch
FABRIKPLANUNG Planung von Produktionstechnologien


FARBMESSUNG (FLÜSSIGKEITEN)

FARBMESSUNG (FLÜSSIGKEITEN)


• Photometer • Messgeräte • Reagenzien
Hach Lange GmbH

Rorschacherstr. 30 a 9424 Rheineck Tel. 084 855 66 99 Fax 071 886 91 66 www.ch.hach.com

FIBEROPTIKSCHAUGLASLEUCHTEN

FIBEROPTIKSCHAUGLASLEUCHTEN

PROCESS ILLUMINATION AND OBSERVATION
www.maxmuller.com info.ch@maxmuller.com +41 61 487 92 92
Hagmattstrasse 19 CH–4123 Allschwil SWITZERLAND
FILTER FILTER



Bachmannweg 21 CH-8046 Zürich T. +41 44 377 66 66 info@bopp.ch www.bopp.com


Sefiltec AG · Separation- und Filtertechnik Engineering Haldenstrasse 11 · CH-8181 Höri ·
FILTERPATRONEN



iFIL AG Industriestrasse 16 CH-4703 Kestenholz www.ifil.eu.com info@ifil.eu.com

FLAMMENSPERREN ASEPTISCHE VENTILE
ANDRÉ RAMSEYER AG
Industriestrasse 32 CH-3175 Flamatt Tel. 031 744 00 00 info@ramseyer.ch www.ramseyer.ch
FLÜSSIGKEITSPUMPEN DOSIERPUMPEN

KNF Neuberger GmbH Business Unit Lab
Alter Weg 3 DE-79112 Freiburg Tel. +49 (0) 7664 5909 0 backoffice.lab@knf.com www.knf.com
FÜLLSTAND FLUORESZENZ-SPEKTROSKOPIE

Aquasant Messtechnik AG T +41 61 935 5000|www.aquasant.com
GASE / GASVERSORGUNG GASE/GASVERSORGUNG
H. Lüdi + Co. AG Moosäckerstrasse 86 8105 Regensdorf
INNOVATIV, NACHHALTIG, FLEXIBEL!
P +41 44 843 30 50 E sales@hlag.ch W www.hlag.ch
62 4–5/2024 LIEFERANTENVERZEICHNIS
LIEFERANTENVERZEICHNIS
1 5 vreS n g Sc encein Sw tzerland CO ² INKUBATOREN CO 2
-INKUB A TOREN
SWISS EXCELLENCE
1936
SINCE
FILTER
Tel. +41 43 411 44 77
+41 43 411 44 78
info@sefiltec.com
FILTERPATRONEN
Fax
·
· www.sefiltec.com
GASGEMISCHE, SPEZIALGASE
GASGEMISCHE, SPEZIALGASE
Messer Schweiz AG
Seonerstrasse 75
5600 Lenzburg
LABORBEDARF

Tel. +41 62 886 41 41 · info@messer.ch · www.messer.ch

HPLC UND UHPLC
HPLC UND UHPLC

expression ® Compact Mass Spectrometer Ihr universeller Molmasse-Schnelltester zur Überwachung von Syntheseverläufen, DC-, Flash LC- & (U)HPLC-Trennungen Advion Ltd. www.advion.com | central-europe@advion.com
KÄLTE- UND KLIMAANLAGEN
KÄLTE- UND KLIMAANLAGEN

Kälte- und Klimaanlagen
Ostringstrasse 16 4702 Oensingen
Tel. +41 62 388 06 06 Fax +41 62 388 06 01 kaelte@pava.ch www.pava.ch
KOMPRESSOREN 100% ÖLFREI
KOMPRESSOREN 100% ÖLFREI

committed to science
Ihr Vollversorger für Laborbedarf & Laborgeräte LABORBEDARF LABORBEDARF

MASSENSPEKTROMETRIE
HUBERLAB. AG Industriestrasse 123 CH-4147 Aesch T +41 61 717 99 77 info@huberlab.ch www.huberlab.ch
Lab • instruments • consumables • services +41 41 769 00 00 info@vitaris.com www.vitaris.com

LABORGERÄTE SCHÜTTELAPPARATE

LAUDA DR. R. WOBSER GMBH & CO. KG Laudaplatz 1 97922 Lauda-Königshofen
LABOR- / MEDIKAMENTENUND BLUTKÜHLSCHRÄNKE
LABOR- / MEDIKAMENTENUND BLUTKÜHLSCHRÄNKE

Wir vertreiben

KAESER Kompressoren AG
Grossäckerstrasse 15 8105 Regensdorf Tel. +41 44 871 63 63 Fax +41 44 871 63 90 info.swiss@kaeser.com www.kaeser.com

KONDENSATABLEITER ASEPTISCHE VENTILE
ANDRÉ RAMSEYER AG
LAGER- UND PROZESSBEHÄLTER
LAGER- UND PROZESSBEHÄLTER
NBS SCIENTIFIC
ANBIETER VON
Industriestrasse 32 CH-3175 Flamatt Tel. 031 744 00 00 info@ramseyer.ch www.ramseyer.ch
Werderstraße 4, 69469 Weinheim +49 (0) 6201 398 7000 info@nbsscientific.de www.nbsscientific.de

LOGISTIK
LOGISTIK
KÜHL- UND TIEFKÜHLCONTAINER
KÜHL- UND TIEFKÜHLCONTAINER ALLESKÖNNER
AUCH FÜR ZERTIFIZIERTE PROZESSE MIT INTEGRALER DOKUMENTATION, +41 41 420 45 41 gabler-container.ch
LABORAUTOMATISIERUNG AUTOMATION
Experts for Automated Processes!
HiTec Zang GmbH info@hitec-zang.de www.hitec-zang.de



LABORBAU / LABOREINRICHTUNGEN GASE/GASVERSORGUNG




DACHSER Spedition AG Regional Offi ce Switzerland Althardstrasse 355 CH-8105 Regensdorf Phone +41 (0)44 8721 100 dachser.regensdorf@dachser.com dachser.ch


Industrie Allmend 36 4629 Fulenbach +41 62 387 74 35 printsupplies@fischerpapier.ch LOHNABFÜLLUNG

Inserat_FiP_ChemieExtra_60x22_DE.indd




H. Lüdi + Co. AG Moosäckerstrasse 86 8105 Regensdorf


INNOVATIV, NACHHALTIG, FLEXIBEL!
P +41 44 843 30 50 E sales@hlag.ch W www.hlag.ch


MASSENSPEKTROMETRIE CHROMATOGRAPHIESÄULEN

expression ® Compact Mass Spectrometer Ihr universeller Molmasse-Schnelltester zur Überwachung von Syntheseverläufen, DC-, Flash LC- & (U)HPLC-Trennungen Advion Ltd. www.advion.com | central-europe@advion.com

MEMBRANEN MEMBRANEN

Tel. +41 31 972 31 52 Fax +41 31 971 46 43 info@msp.ch www.msp.ch
Track-etched (PC/PET) membranes, coated (Au, Al) for: -Particle analysis (Pharmaceuticals & Microplastics) -Asbestos analysis (VDI 3492) www.i3membrane.de lab@i3membrane.de
MEMBRANPUMPEN DOSIERPUMPEN

KNF Neuberger GmbH Business Unit Lab
MESSTECHNIK MESSTECHNIK
Alter Weg 3 DE-79112 Freiburg Tel. +49 (0) 7664 5909 0 backoffice.lab@knf.com www.knf.com

VEGA Messtechnik AG Barzloostrasse 2 · 8330 Pfäffikon ZH www.vega.com · info.ch@vega.com
MIKROBIOLOGIE MIKROBIOLOGIE
Sw tzerland
vreS n g Sciencein
1 5


Gewerbestrasse 10 CH-4450 Sissach Tel. +41 61 971 83 44 Fax +41 61 971 83 45 info@sebio.ch www.sebio.ch
PAPIER- UND MEMBRAN FILTRATION CHROMATOGRAPHIESÄULEN

1 5 ivreS n g Sc encein Sw tzerland


Gewerbestrasse 10 CH-4450 Sissach Tel. +41 61 971 83 44 Fax +41 61 971 83 45 info@sebio.ch www.sebio.ch
PIPETTENKALIBRATIONEN PIPETTENKALIBRATIONEN

Liquidhandling Spektrophotometrie Zentrifugation Sicherheitswerkbänke CH-4460 Gelterkinden info@hemotec.ch Tel. +41 (0)61 981 66 33 www.hemotec.ch
PIPETTENKALIBRATIONEN


SCS 0094
Wartung, Reparatur und Kalibration Ihrer Pipetten und anderen Volumenmessgeräten Akkreditiertes Kalibrierlabor Labor Service GmbH Eichwiesstrasse 2 CH-8645 Rapperswil-Jona info@laborservice.ch Tel. +41 (0)55 211 18 68 www.laborservice.ch

6 LIEFERANTENVERZEICHNIS 63 4–5/2024 LIEFERANTENVERZEICHNIS
T +49 (0) 9343 503-0 info@lauda.de · www.lauda.de
HETTICH AG | 8806 Bäch SZ | +41 44 786 80 20 sales@hettich.ch | www.hettich.ch Succursale Suisse Romande (Canton de Vaud) Tél. +41 44 786 80 26
und bieten Service für Laborschränke der folgenden Marke:
INNOVATIVEN LABORLÖSUNGEN
LOHNABFÜLLUNG
1 10.01.20 11:19 LOHNABFÜLLUNG LOHNABFÜLLUNG
MAGNETRÜHRER info@liquitec.ch www.liquitec.ch liquitec AG Industrie Neuhof 54 CH-3422 Kirchberg T +41 55 450 83 00 F +41 55 450 83 01 DICHTUNGEN
Mischwerk Trockenmischungen Flüssigmischungen www.mmb-baldegg.ch
DISPENSER / PIPETTEN


Socorex Isba S A • Champ-Colomb 7a • 1024 Ecublens socorex@socorex.com • www.socorex.com
SINGLE-USE

SDD GmbH


AUTORISIERTER

FLUORESZENZ-SPEKTROSKOPIE
PROZESS-ANALYTIK

Aquasant Messtechnik AG T +41 61 935 5000|www.aquasant.com

Spichermatt 8 CH-6365 Kehrsiten +41 41 612 17 60 info@sdd-pumpen.ch www.sdd-pumpen.ch


DICHTUNGEN

ROTATIONSVERDAMPFER DOSIERPUMPEN

KNF Neuberger GmbH Business Unit Lab
RÜHRTECHNIK PUMPEN

RÜHRTECHNIK
Alter Weg 3 DE-79112 Freiburg
Tel. +49 (0) 7664 5909 0 backoffice.lab@knf.com www.knf.com
PROZESSAUTOMATION PROZESSAUTOMATION
Längfeldweg 116 · CH-2504 Biel/Bienne Telefon +41 32 374 76 76 · Telefax +41 32 374 76 78 info@ch.pepperl-fuchs.com · www.pepperl-fuchs.ch


Anlagenbau AG Ihr Partner für Prozesstechnik

Pumpen Rührwerke 4153 Reinach BL Tel. +41 61 711 66 36 alowag@alowag.ch www.alowag.ch
Industrie Neuhof 30 3422 Kirchberg


Tel. +41 34 447 70 00 Fax +41 34 447 70 07 info@anlagenbau.ch www.anlagenbau.ch

SCHALTSCHRANKSYSTEME

liquitec AG Industrie Neuhof 54 CH-3422 Kirchberg
T +41 55 450 83 00 F +41 55 450 83 01



SCHÜTTELAPPARATE SCHÜTTELAPPARATE
info@liquitec.ch www.liquitec.ch
SICHERHEITSSCHRÄNKE NACH EN 14470-1/-2
SICHERHEITSSCHRÄNKE NACH EN



asecos Schweiz AG Sicherheit und Umweltschutz
asecos Schweiz AG Sicherheit und Umweltschutz


Gewerbe Brunnmatt 5, CH-6264 Pfaffnau Telefon 062 754 04 57, Fax 062 754 04 58
Gewerbe Brunnmatt 5, CH-6264 Pfaffnau Telefon 062 754 04 57, Fax 062 754 04 58 info@asecos.ch, www.asecos.ch

SICHERHEITSVENTILE ASEPTISCHE VENTILE
ANDRÉ RAMSEYER AG
Industriestrasse 32 CH-3175 Flamatt Tel. 031 744 00 00 info@ramseyer.ch www.ramseyer.ch
PUMPEN
AUTOMATION HiTec Zang GmbH info@hitec-zang.de www.hitec-zang.de



CH-4314 Zeiningen • info o@almatechnik-tdf.ch • www.almatechnik-tdf.ch
PUMPEN PUMPEN

SICHERHEITSWERKBÄNKE DILUTOREN / DISPENSER

Liquidhandling Spektrophotometrie Zentrifugation Sicherheitswerkbänke CH-4460 Gelterkinden info@hemotec.ch Tel. +41 (0)61 981 66 33 www.hemotec.ch

Pumpen Rührwerke
4153 Reinach BL Tel. +41 61 711 66 36 alowag@alowag.ch www.alowag.ch PUMPEN


SWISS
www.maxmuller.com info.ch@maxmuller.com +41 61 487 92 92
SINGLE-USE

HänyTec AG
Lättfeld 2 6142 Gettnau
Tel. +41 62 544 33 00 Fax +41 62 544 33 10 contact@haenytec.ch www.haenytec.ch PUMPEN



Hagmattstrasse 19 CH–4123 Allschwil SWITZERLAND SCHAUGLASLEUCHTEN

PROCESS
SWISS EXCELLENCE SINCE 1936

www.maxmuller.com info.ch@maxmuller.com +41 61 487 92 92
Hagmattstrasse 19 CH–4123 Allschwil SWITZERLAND
STERILISATIONSTECHNIK STERILISATIONSTECHNIK

Rte du Pra Rond 4 CH-1785 Cressier / FR Tél. +41 26 674 93 00 Fax +41 26 674 93 02 Internet: www.iwaki.ch E-mail: info@iwaki.ch PUMPEN




FIBEROPTIKSCHAUGLASLEUCHTEN

SCHEIBENWISCHER FÜR SCHAUGLÄSER

PROCESS ILLUMINATION AND OBSERVATION SWISS
Hagmattstrasse
STERILVERBINDUNGSTECHNIK STERILVERBINDUNGSTECHNIK
CONNECTORS VERBINDUNGSTECHNIK AG Hertistrasse 29, CH-8304 Wallisellen Tel. +41 (0)52 354 68 68, www.connectors .ch
64 4–5/2024 LIEFERANTENVERZEICHNIS
LIEFERANTENVERZEICHNIS
ROTOTEC AG 031 838 40 00 Luzernstrasse 224c info@rototec.ch 3078 Richigen www.rototec.ch Pumpen Verschleisstechnik Revisionen ROTOTEC AG 031 838 40 00 Luzernstrasse 224c info@rototec.ch 3078 Richigen www.rototec.ch Pumpen Verschleisstechnik Revisionen Pumpen Ersatzteile Instandhaltungen PUMPEN PUMPEN
VERTRIEBSPARTNER
Experts for Automated Processes! SCHAUGLASARMATUREN FIBEROPTIKSCHAUGLASLEUCHTEN
OBSERVATION
PROCESS ILLUMINATION AND
EXCELLENCE SINCE 1936
FIBEROPTIKSCHAUGLASLEUCHTEN
ILLUMINATION AND OBSERVATION
EXCELLENCE SINCE 1936
www.maxmuller.com info.ch@maxmuller.com +41 61 487 92 92
ARMATUREN
19 CH–4123 Allschwil SWITZERLAND
T +49 (0) 9343 503-0 info@lauda.de · www.lauda.de LAUDA DR. R. WOBSER GMBH & CO. KG Laudaplatz 1 97922 Lauda-Königshofen
14470-1/-2
PIPETTENKALIBRATIONEN
TECHNISCHE GLASBLÄSEREI / LABORFACHHANDEL

TECHNISCHE GLASBLÄSEREI / LABORFACHHANDEL
● Technische Glasbläserei
● Reparaturen
● Spezialanfertigungen
● Laborfachhandel
– LabWare
– Lab Instruments
– Liquid Handling
– Glaswaren
www.glasmechanik.ch
info@glasmechanik.ch
+41 61 711 72 00
Lettenweg 118 4123 Allschwil
TEMPERATURMESSTECHNIK
TEMPERATURMESSTECHNIK
Thermocontrol GmbH
Riedstrasse 14, 8953 Dietikon
TRENNSCHICHTENMESSGERÄTE FLUORESZENZ-SPEKTROSKOPIE

Aquasant Messtechnik AG T +41 61 935 5000|www.aquasant.com
FLUORESZENZ-SPEKTROSKOPIE
TRÜBUNGSMESSUNG
VAKUUMPUMPSTÄNDE DOSIERPUMPEN

KNF Neuberger GmbH Business Unit Lab
VENTILE
Alter Weg 3
DE-79112 Freiburg
Tel. +49 (0) 7664 5909 0 backoffice.lab@knf.com www.knf.com

GEMÜ Vertriebs AG Schweiz
Telefon: 041 799 05 55
E-Mail: vertriebsag@gemue.ch · www.gemue.ch
DICHTUNGEN
Tel. +41 (0)44 740 49 00 Fax +41 (0)44 740 49 55 info@thermocontrol.ch www.thermocontrol.ch


TEMPERIERSYSTEME
TEMPERIERSYSTEME

JULABO GmbH
Gerhard-Juchheim-Strasse 1 77960 Seelbach / Germany





Tel. +49 (0) 7823 51-0 · info.de@julabo.com · www.julabo.com

TEMPERIERTECHNIK SCHÜTTELAPPARATE
LAUDA DR. R. WOBSER GMBH & CO. KG
Laudaplatz 1 97922 Lauda-Königshofen
T +49 (0) 9343 503-0 info@lauda.de · www.lauda.de
TIEFKÜHLTRUHEN UND -SCHRÄNKE

TIEFKÜHLTRUHEN UND -SCHRÄNKE
LAUDA DR. R. WOBSER GMBH & CO. KG
Laudaplatz 1 97922 Lauda-Königshofen
T +49 (0) 9343 503-0 info@lauda.de · www.lauda.de
TOC-ANALYSATOR TOC-ANALYSATOR

Nünningstrasse 22–24
D-45141 Essen
TOC und TNb Wasser- und Feststoffanalytik für Labor- und Online-Anwendungen TOC-ANALYSATOR


Tel. +49 (0) 201 722 390 Fax +49 (0) 201 722 391 essen@dimatec.de www.dimatec.de

Elementar Analysensysteme GmbH
Elementar-Straße 1 D-63505 Langenselbold Tel. +49 6184 9393 – 0 info@elementar.com www.elementar.com
TRÜBUNGSMESSUNG
Aquasant Messtechnik AG T +41 61 935 5000|www.aquasant.com
FARBMESSUNG (FLÜSSIGKEITEN)


Hach Lange GmbH
Rorschacherstr. 30 a 9424 Rheineck

Tel. 084 855 66 99 Fax 071 886 91 66 www.ch.hach.com

FLUORESZENZ-SPEKTROSKOPIE
ÜBERFÜLLSICHERUNG

Aquasant Messtechnik AG T +41 61 935 5000|www.aquasant.com




Ihr Spezialist für Anlagen und Prüfmittel in der ZfP D Leuchten www.helling.de U LED-



Helling GmbH Spökerdamm 2 D-25436 Heidgraben Tel.: +49 4122 922-0 info@helling.de


UV-VIS-SPEKTRALPHOTOMETER UV-VIS-SPEKTRALPHOTOMETER

Liquidhandling Spektrophotometrie Zentrifugation Sicherheitswerkbänke CH-4460 Gelterkinden info@hemotec.ch Tel. +41 (0)61 981 66 33 www.hemotec.ch
VAKUUMPUMPEN VAKUUMPUMPEN
Busch AG
Vacuum Solutions Waldweg 22, 4312 Magden Tel. 061 845 90 90 info@buschag.ch www.busch.chDOSIERPUMPEN

KNF Neuberger GmbH Business Unit Lab
Alter Weg 3 DE-79112 Freiburg
Tel. +49 (0) 7664 5909 0 backoffice.lab@knf.com www.knf.com
liquitec AG Industrie Neuhof 54 CH-3422 Kirchberg

T +41 55 450 83 00 F +41 55 450 83 01



WÄRME- UND TROCKENSCHRÄNKE
info@liquitec.ch www.liquitec.ch

WÄRME- UND TROCKENSCHRÄNKE

Will & Hahnenstein GmbH D-57562 Herdorf
Tel. +49 2744 9317 0 Fax +49 2744 9317 17 info@will-hahnenstein.de www.will-hahnenstein.de
WASSERANALYSEGERÄTE TOC-ANALYSATOR

TOC und TNb
Wasser- und Feststoffanalytik für Labor- und Online-Anwendungen

ZAHNRADPUMPEN ZAHNRADPUMPEN

Nünningstrasse 22–24 D-45141 Essen
Tel. +49 (0) 201 722 390 Fax +49 (0) 201 722 391 essen@dimatec.de www.dimatec.de

Maag Pump Systems AG Aspstrasse 12 CH-8154 Oberglatt Telefon +41 44 278 82 00 welcome@maag.com www.maag.com
DILUTOREN / DISPENSER
ZENTRIFUGEN

Liquidhandling Spektrophotometrie Zentrifugation Sicherheitswerkbänke CH-4460 Gelterkinden info@hemotec.ch Tel. +41 (0)61 981 66 33 www.hemotec.ch ZENTRIFUGEN
Wir vertreiben und bieten Service

6 LIEFERANTENVERZEICHNIS 65 4–5/2024 LIEFERANTENVERZEICHNIS
• Photometer • Messgeräte • Reagenzien
UV-LEUCHTEN UV-LEUCHTEN P T M T LT R T V T U T
HETTICH AG | 8806 Bäch SZ | +41 44 786 80 20 sales@hettich.ch | www.hettich.ch Succursale Suisse Romande (Canton de Vaud) Tél. +41 44 786 80 26 Wir vertreiben
und bieten Service für Wärme- & Trockenschränke der folgenden Marke: WÄRME- UND TROCKENSCHRÄNKE
HETTICH AG | 8806 Bäch SZ | +41 44 786 80 20 sales@hettich.ch | www.hettich.ch Succursale Suisse Romande (Canton de Vaud) Tél. +41 44 786 80 26
der
Marke:
für Zentrifugen
folgenden


19. - 20. Juni 2024 Messe Düsseldorf
Entdecken Sie die Welt der Fein- und Spezialchemie
Bringen Sie Ihr Unternehmen auf die nächste Stufe, knüpfen Sie neue Kontakte und finden Sie maßgeschneiderte Lösungen und innovative Substanzen:
• Pharmazeutika
• Feinchemikalien
• Chemische Zwischenprodukte
• Agrochemikalien
• Auftragssynthese
• Kleb- & Dichtstoffe
• Farben & Beschichtungen

Freuen Sie sich auf ein hochkarätiges Konferenzprogramm mit spannenden Einblicken:
• Farbmittel & Farbstoffe
• Aromen & Duftstoffe
• Grüne Chemikalien
• Haushalts- und Industriechemikalien
• Biobasierte Chemikalien
• Biokatalysatoren
• Kunststoffadditive
• Kosmetik
• Polymere
• Tenside
• Petrochemikalien
• Elektronikchemikalien
• und mehr

• Agrochemical Lecture Theatre
• EFCG Crop Protection & Fine Chemicals Forum
• Pharma Lecture Theatre
• RSC Symposium
• Regulatory Services Lecture Theatre
• Innovative Start-ups
www.chemspeceurope.com Sichern Sie sich jetzt Ihr Ticket:
TOP-Angebote Laborbedarf


Lieferung inkl. Batterien.
Zusätzlich externe Fühler für Temperatur, Feuchte und Druck über den USB-Port anschließbar. Bitte separat bestellen.
ROTH AG · Fabrikmattenweg 12 · 4144 Arlesheim
/
Datenlogger LOG40 Dostmann.
Ideale Messwertüberwachung ohne konstenspielige Installation.
Zur Temperaturüberwachung und -dokumentation von Lager und Transportkonditionen gemäß HACCP, Produktionsstätten, Kühlschränken für Arzneimittel und Tiefkühllager.
• Datenlogger vorprogrammiert (Messintervall: 15 min) und sofort einsetzbar
• Automatische Ausgabe der Daten als PDF- und Excel-Datei, keine Treiberinstallation notwendig
• Windows-kompatible Software zur Programmierung des Loggers (z. B. Messtakt, Alarmgrenzen, Beginn und Ende der Aufzeichnung) bitte kostenlos downloaden
• Status- und Alarm-LEDs mit Signalton
• Stromversorgung mit Lithium-freien Batterien und damit v.a. für die Transportüberwachung geeignet
Technische Daten:
Best.-Nr. 23C3.1
Messbereich Temperatur -40 bis +60 °C
Auflösung Temperatur 0,1 °C
Genauigkeit Temperatur ±0,5 °C (-10 bis +60 °C) , ±1,0 °C (außerhalb)
Datenspeicher 40000 Datensätze
Messtakt 1 s bis 24 h
IP-Schutzklasse 65 Min/Max-Funktion Ja
L x B x H 100 x 40 x 16 mm
Gewicht 65 g
Stromversorgung 2x Batterie Micro/AAA 1,5 V
Gültig von
Bestellungen: 061 / 712 11 60 · Faxbestellungen: 061 / 712 20 21 · E-Mail-Bestellungen: info@carlroth.ch · Roth im Internet: www.carlroth.ch www.carlroth.com/ch/de/Kaufmaennische-Beratung-Aussendienst Netto-Preise in CHF zzgl. MwSt. Bei Aufträgen über 200,– CHF sparen Sie die Versandkostenpauschale von 15,– CHF. Es gelten die allgemeinen Geschäfts- und Lieferbedingungen der Roth AG, Arlesheim
Best.-Nr. VE CHFCHF 23C3.1 1 Stück 64,35 51,45
3. Juni
CH-DE
bis 31. Juli 2024
Thermohygrometer testo 605i Testo.
Kompaktes Profimessgerät aus der Testo Smart Probes Serie zur Nutzung mit Smartphones/Tablets. Messung von Luftfeuchte und -temperatur in Räumen und Kanälen.
Lieferung inkl. Batterien und Kalibrierprotokoll.

• Sondenkopf knickbar für besonders komfortable Messungen
• Einfache Bedienung, Auswertung und Dokumentation mit kostenloser testo Smart App; Anzeige der Messwerte, übersichtliche und grafische Darstellung der Temperaturverläufe, Protokollierung der Messdaten und Verschicken als PDF- oder CSV-Dateien möglich
• Automatische Berechnung von Taupunkt und Feuchtekugeltemperatur via App
• Problemloser Einsatz an weit voneinander entfernten Messpunkten; Bluetooth ® -Reichweite bis 100 m
Technische Daten:
Best.-Nr. 21AT.1
Typ testo 605i
Parameter Temperatur, Feuchte
Messbereich Temperatur -20 bis +60 °C
Auflösung Temperatur 0,1 °C
Genauigkeit Temperatur ±0,8 °C (-20 bis 0 °C), ±0,5 °C (0 bis +60 °C)
Messbereich rel. Feuchte 0 bis 100 %
Auflösung rel. Feuchte 0,1 %
Genauigkeit rel. Feuchte ±3,0 % (10 bis 35 %), ±2,0 % (35 bis 65 %), ±3,0 % (65 bis 90 %), ±5,0 % (<10 % oder >90 %)
Taupunkt Ja L x B x H 218 x 30 x 27 mm
Gewicht 86,4 g
Stromversorgung 3x Batterie Micro/AAA 1,5 V
Powder Pillows VISOCOLOR ® Macherey-Nagel.
Für die photometrische Bestimmung. Jedes Powder Pillow enthält die für eine Bestimmung benötigte Menge an Reagenzien.
Auswertbar mit den Kompaktphotometern PF-12Plus und PF-3, sowie den Spektralphotometern NANOCOLOR ® Advance, NANOCOLOR ® VIS II und NANOCOLOR ® UV/VIS II.
Ammonium Für die Trinkwasser-, Oberflächenwasser- und Abwasseranalytik.
g n Achtung H319-H361d
Messbereich (mg/l) Anzahl Best. Best.-Nr. VE
Chlor frei Für die Schwimmbad- oder Trinkwasseranalytik. Messbereich
Chlor gesamt/Ozon Für die Schwimmbad- oder Trinkwasseranalytik.
Messbereich (mg/l)
2: 0,03–6,00, O 3: 0,03–4,00
Eisen Für die Trinkwasser- und Abwasseranalytik.
h g Gefahr H302-H318-EUH031 EUH208
Messbereich (mg/l) Anzahl Best.
K ieselsäure HR
Zur Kesselwasseranalytik von Kesseln mit niedrigen bis mittleren Drücken.
g Achtung H315-H319-H335-H412
Messbereich (mg/l)
: 2–210
K ieselsäure LR
Zur Kesselwasseranalytik von Kesseln mit hohen Drücken.
g Achtung H315-H319-H335
Messbereich (mg/l)
: 0,02–2,10
Nitrat Für die Trinkwasseranalytik.

g Achtung H317-H412
Messbereich (mg/l) Anzahl
Nitrit Für die Trinkwasser-, Oberflächenwasser- und Abwasseranalytik.
h g Gefahr H314-H317-EUH071
Messbereich (mg/l) Anzahl Best. Best.-Nr. VE CHFCHF
pH Für schwach und stark gepufferte Systeme, wie Schwimmbadoder Trinkwasser.
Messbereich Anzahl
Phosphat Für die Trinkwasser-, Oberflächenwasser- und Abwasseranalytik.
h g Gefahr H314-H332-EUH071
Messbereich (mg/l) Anzahl Best. Best.-Nr. VE CHFCHF
4 3-: 0,03–4,5, PO 4 -P: 0,01–1,5
Sulfat Zur Trinkwasser- und Abwasseranalytik.
g n j Achtung H302-H315-H319-H373-H410
Messbereich (mg/l) Anzahl Best. Best.-Nr. VE CHFCHF
4 2-: 15–200
2
/ /
Best.-Nr. VE CHFCHF 21AT.1 1 Stück 139,10 118,20
CHFCHF NH4 : 0,03–1,00, NH4 -N:
100 24TT.1 1 Stück 196,30 157,00
0,02–0,80
(mg/l) Anzahl Best. Best.-Nr. VE CHFCHF Cl 2: 0,03–6,00 100 24TX.1 1 Stück 32,15 25,65
Anzahl Best Best.-Nr. VE CHFCHF
100 24TY.1 1 Stück 32,15 25,65
Cl
Best.-Nr. VE CHFCHF Fe: 0,03–3,00 100 24X0.1 1 Stück 35,00 27,95
Best. Best.-Nr.
CHFCHF Si:
100 24X1.1 1 Stück 127,05 101,60
Anzahl
VE
1–100, SiO 2
Best. Best.-Nr.
CHFCHF
0,01–1,00, SiO
100 24X2.1 1 Stück 127,05 101,60
Anzahl
VE
Si:
2
Best.-Nr.
NO 3 -: 5–220, NO 3 -N: 1–50 100 24X3.1 1 Stück 68,15 54,45
Best.
VE CHFCHF
NO 2
NO 2
0,01–0,30 100 24X4.1 1 Stück 53,70 42,90
-: 0,03–1,00,
-N:
Best.-Nr.
pH:
100 24X5.1 1 Stück 40,05 31,95
Best.
VE CHFCHF
6,2–8,2
PO
100 24X6.1
Stück 63,45 50,70
1
100 24X7.1 1 Stück 47,85 38,20 Laborbedarf
SO

Tisch-pH-Meter pH 50 VioLab Set Dostmann.
• Großes Display mit gleichzeitiger Anzeige von pH- oder mV-Wert und Temperatur
• Automatische oder manuelle Temperaturkompensation
• Automatische Kalibrierung
• Speicherung der aktuellen Kalibrierung
• Bestätigung bei Erreichen eines stabilen Messwertes
Für allgemein wässrige Proben.
pH-Einstabmesskette 201T mit integriertem Temperaturfühler:
pH-Bereich 0 bis 14, Arbeitstemperatur 0 bis +60 °C, Keramik-Diaphragma, Gel-Elektrolyt, Kunststoff-Schaft, Schaftlänge/-Ø 120/12 mm.
Technische Daten:
Best.-Nr. HAE3.1
Typ pH 50 VioLab Set
Sensor 201T
Parameter pH, Redox, Temperatur
Messbereich pH 0 bis 14
Auflösung pH 0,01 pH
Genauigkeit pH ±0,01
Messbereich Spannung -1999 bis +1999 mV
Auflösung Spannung 1 mV
Genauigkeit Spannung ±1 mV
Messbereich Temperatur 0 bis +100 °C
Auflösung Temperatur 0,1 °C
Genauigkeit Temperatur ±0,5 °C (+5 bis +60 °C), ±1 °C (außerhalb)
Temperatursensor NTC 30 kΩ
Kalibrierpunkte 1/2/3 (pH)
Kalibrierspeicher aktuelle Kalibrierung
Datenspeicher 25 Messungen
Anschluss BNC (pH), Cinch (°C)
L x B x H 160 x 190 x 70 mm
Stromversorgung Netzteil
Netzanschluss 100–240 V, 50/60 Hz
Lieferung inkl. pH-Einstabmesskette 201T, Pufferlösungen (pH 4,01 und 7,00, je 50 ml), Elektrodenhalter und Netzadapter.

pH 4,01
7,00
pH-Pufferlösung ROTILABO ® in Beuteln
ROTH SELECTION.
Reagenzmenge eines Beutels (25 ml) für eine Kalibrierung ausreichend.
• Rückführbar durch Abgleich mit Standard-Referenzen von NIST und PTB
• Mit Analysenzertifikat zur Dokumentation von Qualität, Rückverfolgbarkeit und Genauigkeit
10,01
3
Best.-Nr. VE CHFCHF HAE3.1 1 Stück 533,00 426,40
Genauigkeit pH Best.-Nr. VE CHFCHF ±0,01 KAY0.1 20 Stück 38,90 31,05
Genauigkeit pH Best.-Nr. VE CHFCHF ±0,01 KAY1.1 20 Stück 38,90 31,05
Genauigkeit pH Best.-Nr. VE CHFCHF ±0,02 KAY2.1 20 Stück 38,90 31,05 Laborbedarf
pH
pH
Heiz- und Magnetrührer Digital Komplett-Set AREX-6 Velp.
• Heizplatte aus Aluminium mit Keramikbeschichtung
• Temperatur- und Drehzahleinstellung über Digitalanzeige
• Integriertes Kontaktthermometer mit voller Funktionalität, zur direkten Steuerung der Mediumstemperatur bis 250 °C über Pt 100-Fühler
• Timerfunktion – schaltet die Rühr- und Heizfunktion nach Ablauf des Countdowns ab
• Einstellbarer Reversierbetrieb mit Drehrichtungswechsel (von 5 s bis 99 min, in 1-s-Schritten)
• Einstellbare max. Temperaturgrenze
• Probe Detector Alarm: Erkennt, wenn der Temperaturfühler nicht im Medium eingetaucht ist
Technische Daten:
Best.-Nr. HLN1.1
max. Rührmenge (H 2O) 20 l
Drehzahlbereich 30 bis 1700 min ¹
Arbeitstemperatur Raumtemperatur bis +370 °C
Regelgenauigk. ohne Fühler ±10 K
Regelgenauigk. m. Fühler ±1 K
Timerfunktion 1 bis 99 min in 1-min-Schritten
Stellfläche Ø 135 mm
B x T x H gesamt 160 x 280 x 105 mm
Netzanschluss 230 V, 50/60 Hz

Magnetrührer RSM-Serie
Phönix Instrument.
Technische Daten:
Best.-Nr. XP52.1 XP53.1
Typ RSM-10 B RSM-01 S Rührstellenanzahl 1
max. Rührmenge (H 2O) 3 l 20 l
Drehzahlbereich 100 bis 1500 min ¹ bis 1500 min ¹
Drehzahlanzeige LED -
Stellfläche Ø 135 mm
B x T x H gesamt 155 x 215 x 75 mm160 x 280 x 85 mm
Netzanschluss 200–240 V, 50/60 Hz
(1) Modell RSM-10 B
• Drehzahleinstellung über Digitalanzeige (LED-Display)
• Gehäuse und Plattform aus ABS
Best.-Nr. VE
XP52.1 1 Stück
(2) Modell RSM-01 S
• Mit Plattform aus Edelstahl
• Vollmetallgehäuse
Best.-Nr. VE
XP53.1 1 Stück


Lieferung inkl. Edelstahl-Temperaturmessfühler Pt 100 (Ø 3 mm, L 250 mm), Stativstab und Haltevorrichtung für Temperaturfühler.

Made in Germany /
Mehrstellen-Magnetrührer MIX 15 eco 2mag.
100 % verschleiß- und wartungsfreier Induktionsantrieb für Durchmischung von Lösungen in z. B. 15 Bechergläsern 250 ml, hohe Form, geeignet.
• Edelstahlgehäuse
• Digitalanzeige für exaktes Einstellen der Drehzahl
• Max. 1,5 l Rührvolumen pro Rührstelle
• Synchrondrehend, ruckfreies Rühren auch bei niedrigen Drehzahlen
• SoftStart für zuverlässiges Fangen/Zentrieren und sicheres Beschleunigen des Rührstabes
Technische Daten:
Best.-Nr. 20AE.1
Rührstellenanzahl 15 max. Rührmenge (H 2O) 1,5 l Drehzahlbereich 120 bis 1200 min ¹
B x T x H gesamt245 x 425 x 38 mm
Netzanschluss 100–240 V, 50/60 Hz
Best.-Nr. VE
20AE.1 1 Stück
4
Best.-Nr. VE CHFCHF HLN1.1 1 Stück 929,50 743,60
CHFCHF
219,70 175,75
CHFCHF
409,50 327,60
CHFCHF
1.530,10
Laborbedarf
1.300,55

Heiz- und Magnetrührer ROTILABO ® MH 15 ROTH SELECTION.
• Heizplatte aus Aluminium mit Schutzbeschichtung überzogen
• Mit abgesetzter Bedienfläche zum Schutz vor auslaufender Flüssigkeit
• Front-Panel mit °C- und min -1-Skala
Technische Daten:
Best.-Nr. AAN2.1 Rührstellenanzahl 1 max. Rührmenge (H 2O) 15 l
Drehzahlbereich 100 bis 1500 min ¹ Temperaturbereich 50 bis 310 °C Stellfläche Ø 135 mm
B x T x H gesamt160 x 270 x 85 mm
Netzanschluss 230 V, 50/60 Hz
5
Best.-Nr. VE CHFCHF AAN2.1 1 Stück 405,60 324,45 Laborbedarf
Mini-Zentrifuge mini G IKA.
• Max. Kapazität: 8 x 1,5/2,0 ml Reaktionsgefäße
• Rotor austauschbar ohne Werkzeug
• Digital-Display für Laufzeit (einstellbar von 1 bis 99 min)
Technische Daten:
Best.-Nr. XT15.1
max. Kapazität 8 x 1,5/2,0 ml Reaktionsgefäße
Drehzahl max. (im Mikroliterrotor) 6.000 min ¹
Maximale RZB 2000 x g
B x T x H 155 x 175 x 105 mm
Netzanschluss 230 V, 50/60 Hz

Lieferung inkl. Standard-Rotor für Reaktionsgefäße 8 x 1,5/2,0 ml und einem Rotor für PCR ® -Gefäßstreifen mit 4 x 8 Reaktionsgefäßen à 200 μ l pro Strip und Adaptern für Reaktionsgefäße 0,5/0,4/0,2 ml.
Kein Medizinprodukt/Kein ivD-Produkt.
Best.-Nr. VE
XT15.1 1

Kleinzentrifuge CD-0412-50 für 15-/50-ml-Röhrchen Phönix Instrument.
Mit 6-fach Kombi-Winkelrotor (54°) zum Zentrifugieren von 6 x 15- oder 6 x 50-ml-Röhrchen Typ Falcon ®
• LCD-Display zur Anzeige für Drehzahl oder RZB-Wert und Zeit
• Timer startet nach Erreichen der gewählten Geschwindigkeit
Technische Daten:
Best.-Nr. KEC8.1 Typ CD-0412-50
Maximale Drehzahl 4.000 min ¹
Ergänzende Angaben Drehzahl verstellbar in 100 min -1-Schritten
Maximale RZB 1800 x g
Timerfunktion 0,5 s bis 99 min / Dauerbetrieb / Kurzlauf
B x T x H 300 x 350 x 200 mm
Netzanschluss 100–240 V, 50/60 Hz
Lieferung inkl. 6-fach Winkelrotor (54°).
Kein Medizinprodukt/Kein ivD-Produkt.
Best.-Nr. VE
KEC8.1 1 Stück
6
CHFCHF
457,60 388,95
Stück
CHFCHF
1.293,50 1.034,80 Laborbedarf
/

Mikroliterzentrifuge Frontier FC5513-Serie Ohaus.
Technische Daten:
Best.-Nr.
23NC.1
23NE.1
Typ FC5513 FC5513R
max. Kapazität 24 x 1,5/2,0 ml Reaktionsgefäße
Drehzahl max. (im Mikroliterrotor) 13.500 min ¹ 13.000 min ¹
Maximale RZB 17317 x g 16058 x g
Timerfunktion 10 s bis 99 h, 59 min, 59 s / Dauerbetrieb / Quick Run
B x T x H 277 x 356 x 236 mm287 x 555 x 286 mm
Temperatur-Einstellbereich - -20 - +40 °C
Netzanschluss 230 V, 50/60 Hz
Lieferung inkl. 24 x 1,5/2,0 ml Rotor mit aerosoldichtem Deckel.
(1) Modell FC5513, ungekühlt Standard - luftgekühlt bzw. ohne Kühlfunktion.
Best.-Nr. VE
23NC.1 1 Stück 2.171,00 1.628,25
Allgemeine Angaben für alle Modelle:
• Max. Kapazität: 24 x 1,5/2,0 ml Reaktionsgefäße
• Wahlweise Anzeige von Umdrehungen min -1 oder x g
• Auswahl von 10 Beschleunigungs-/ und 10 Bremsprofilen
• 99 Programmspeicherplätze zum Abrufen von häufig verwendeten Parametern
(2) Modell FC5513R, gekühlt
• Mit Kühlfunktion
• Stufenlos regelbar von -20 bis +40 °C, in 1-°C-Schritten
Best.-Nr. VE CHFCHF
23NE.1 1 Stück 5.331,30 3.998,45
7
CHFCHF
Laborbedarf
S chraubdeckel blau
S chraubdeckel rot

Probendose

Semadeni. Material: PETG, transparent, Schraubverschluss aus HDPE.
Glasklare, zylindrische Dosen mit Eindrückstopfen (LDPE) und Schraubverschluss. Zur Aufbewahrung von Pulver, Pasten, Granulate und sonstige Schüttgüter. Nicht auslaufsicher. Lebensmittelgeeignet.
Kein Medizinprodukt/Kein ivD-Produkt.
Zentrifugenröhrchen
Kartell. Material: PP.
Mit erhabener Graduierung. Steril (γ-sterilisiert) mit rotem Deckel oder unsteril mit blauem Deckel.
In-vitro -Diagnostikum nach IVDD.
Ohne Stehrand
S chraubdeckel weiß

Mit Stehrand
/ / /
Schüssel

Semadeni. Material: PP.
Runde, stabile Schüssel mit zwei seitlich angebrachten Griffen. Vielseitig einsetzbar im Labor und in der Industrie. Temperaturbeständig bis +80 °C.
Kein Medizinprodukt/Kein ivD-Produkt.
Weiss
8
Volumen (ml) Ø (mm) Ø Hals innen (mm) Höhe (mm) Best.-Nr. VE CHFCHF 250 93 77 60 23XL.1 12 Stück 63,55 47,55 500 93 77 100 23XT.1 6 Stück 40,15 30,00 750 93 77 135 23Y0.1 4 Stück 26,80 20,05 1.000 93 77 175 23Y3.1 4 Stück 31,75 23,75
Volumen (ml) Ø (mm) Ø Hals innen (mm) Höhe (mm) Best.-Nr. VE CHFCHF 250 93 77 60 23XK.1 12 Stück 64,85 48,55 500 93 77 100 23XP.1 6 Stück 40,15 30,00 750 93 77 135 23XY.1 4 Stück 27,30 20,45 1.000 93 77 175 23Y2.1 4 Stück 31,75 23,75
Volumen (ml) Ø (mm) Ø Hals innen (mm) Höhe (mm) Best.-Nr. VE CHFCHF 250 93 77 60 23XH.1 12 Stück 64,85 48,55 500 93 77 100 23XN.1 6 Stück 40,15 30,00 750 93 77 135 23XX.1 4 Stück 27,30 20,45 1.000 93 77 175 23Y1.1 4 Stück 31,75 23,75
Volumen (ml) Sterilität Ø außen (mm) Höhe (mm) Zentrifugierbarkeit max. x g Verpackungsart Verp. Best.-Nr. VE CHFCHF 15 Unsteril 17 120 3.000 Beutel 5 x 150 Stück AN76.2 750 Stück 248,30 186,20 15 S teril 17 120 3.000 Beutel 7 x 150 Stück AN77.2 1.050 Stück 399,10 299,30 50 Unsteril 29 115 3.000 Beutel 5 x 100 Stück AN78.2 500 Stück 198,90 149,15 50 S teril 29 115 3.000 Beutel 6 x 100 Stück AN79.2 600 Stück 274,30 205,70
Volumen (ml) Sterilität Ø außen (mm) Höhe (mm) Zentrifugierbarkeit max. x g Verpackungsart Verp. Best.-Nr. VE CHFCHF 50 Unsteril 29 115 3.000 Beutel 5 x 100 Stück AN80.2 500 Stück 230,10 172,55 50 S teril 29 115 3.000 Beutel 6 x 100 Stück AN81.2 600 Stück 296,40 222,30
Volumen (l) Ø außen (mm) Höhe (mm) Best.-Nr. VE CHFCHF 17,0 350 170 20LK.1 1 Stück 15,90 11,90 19,0 400 190 20LL.1 1 Stück 21,30 15,90 34,0 500 250 20LN.1 1 Stück 36,25 27,10
Blau
Volumen (l) Ø außen (mm) Höhe (mm) Best.-Nr. VE CHFCHF 17,0 350 170 20LC.1 1 Stück 15,90 11,90 19,0 400 190 20LE.1 1 Stück 21,30 15,90 34,0 500 250 20LH.1 1 Stück 36,70 27,50 Laborbedarf

Glasfaser-Rundfilter Macherey-Nagel.
Zur schnellen Filtration bei gleichzeitig hohem Rückhaltevermögen. Sehr gute Beständigkeit gegenüber den meisten organischen und anorganischen Lösungsmitteln (nicht beständig gegen Flusssäure).
Typ MN 85/70
Material: Borosilikatglas (Fasern), organische Bindemittel.
Meistverwendete Glasfaserfilter mit hoher mechanischer Stabilität für allgemeine Anwendungen. Temperaturbeständig bis 200 °C.
• Filtrationsgeschwindigkeit Luft: 15 s
• Flächengewicht: 70 g/m2
• Rückhaltebereich: ≥0,6 µm
• Dicke: 0,35 mm
Typ MN 85/70 BF
Material: Borosilikatglas (Fasern), bindemittelfrei.
Verwendung z. B. als Vorfilter bei der Membranfiltration partikelbelasteter Medien. Temperaturbeständig bis 500 °C.
9
Ø (mm) Best.-Nr. VE CHFCHF 25 EN17.1 100 Stück 20,45 15,25 37 EN18.1 100 Stück 25,50 19,10 40 EN19.1 100 Stück 27,30 20,45 45 EN20.1 100 Stück 27,30 20,45 47 1P1X.1 100 Stück 27,30 20,45 55 EN21.1 100 Stück 29,00 21,70 70 EN22.1 100 Stück 36,05 26,95 90 EN23.1 100 Stück 47,60 35,65 110 EN24.1 100 Stück 60,35 45,20 125 EN25.1 100 Stück 74,90 56,15 150 EN26.1 100 Stück 98,55 73,90 185 EN27.1 100 Stück 137,80 103,35 200 EN28.1 100 Stück 209,30 156,95 240 EN29.1 100 Stück 209,30 156,95 270 EN30.1 100 Stück 244,40 183,30 320 EN31.1 100 Stück 331,50 248,60
Ø (mm) Best.-Nr. VE CHFCHF 25 HK45.1 100 Stück 35,75 26,75 37 HK46.1 100 Stück 45,25 33,90 45 HK47.1 100 Stück 48,50 36,30 47 1P1Y.1 100 Stück 51,50 38,60 55 HK48.1 100 Stück 53,05 39,75 70 HK49.1 100 Stück 64,90 48,60 90 HK50.1 100 Stück 86,35 64,70 110 HK51.1 100 Stück 108,85 81,55 125 HK52.1 100 Stück 136,50 102,35 150 HK53.1 100 Stück 185,90 139,40 185 HK54.1 100 Stück 261,30 195,95 240 HK55.1 100 Stück 369,20 276,90 270 HK56.1 100 Stück 443,30 332,45 Laborbedarf
Inkubationsschüttler INC 125 FS digital IKA.
Mit herausnehmbarer Schüttelplattform, die statische als auch Schüttelinkubation ermöglicht. Wird die Schüttelplattform herausgenommen, kann das Gerät wie ein normaler Inkubator verwendet werden.
• Schüttel- und Temperierfunktion können unabhängig voneinander genutzt werden
• Mit herausziehbarer Plattform zur einfachen Entnahme und Bestückung von Proben
• Counter, Timer- und Timer-Auto-Modi (Timer startet erst nach Erreichen der eingestellten Temperatur)
• Dekontaminationsmodus verfügbar (120 °C / 2 h)
• Innenbeleuchtung
• Mit Ventilator, Lüftergeschwindigkeit von 0 bis 100 % einstellbar
• Plattform mit Lochraster zum Schütteln von Erlenmeyerkolben mittels Federklammern (Federklammern bitte separat bestellen). Aufstellfläche B 480 x T 340 mm
Max. Bestückung per Tablar:
39 Halteklammern für 25 ml Kolben oder 39 Halteklammern für 50 ml Kolben oder 24 Halteklammern für 100 ml Kolben oder 12 Halteklammern für 200/250 ml Kolben oder 6 Halteklammern für 1000 ml Kolben oder 2 Halteklammern für 2000 ml Kolben

Reagenzglasschüttler ROTILABO ® Mini Vortex
ROTH SELECTION. Material: ABS, Silikon.
• Für Kleingefäße mit Ø bis 30 mm wie Reagenzgläser, Zentrifugenröhrchen, Reaktionsgefäße etc.
• Mit fest eingestellter Drehzahl von 4500 min -1
• 5 Jahre Garantie
Technische Daten:
Best.-Nr. HXH6.1
Bewegungsart kreisförmig vibrierend Drehzahl 4500 min ¹
B x T x H 110 x 75 x 130 mm
Netzanschluss 100–240 V, 50/60 Hz
Lieferung inkl. Steckernetzteil 12 V und 2 Standard-Silikon-Aufsätzen.
Best.-Nr. VE
HXH6.1

Technische Daten:
Best.-Nr. 1YNK.1
Bewegungsart kreisförmig
Arbeitstemperatur +8 °C über Raumtemperatur bis +80 °C
Auflösung 0,1 °C
Genauigkeit ±0,2 K
Drehzahlbereich 10 bis 300 min ¹
Schüttelamplitude (Hub) 20 mm
Zeitschaltuhr 99 d, 23 h und 59 min
Einlegeböden max. 5 Volumen 125 l
B x T x H innen 550 x 415 x 550 mm
B x T x H außen 700 x 705 x 720 mm
Netzanschluss 200–240 V, 50/60 Hz
Lieferung inkl. Federklammernaufsatz SP20 zur Befestigung von Halteklammern oder -matten und 1 Gittereinlegeboden Typ IO T 1.00, verchromt (548 x 421 mm). Ohne Federklammern, bitte separat bestellen. Weiteres Zubehör wie Gittereinlegeböden, Halteklammern oder Haftmatte, findet man auf unserer Homepage.

• IR-Sensor- oder Dauerbetrieb wählbar
• Bei aktiviertem berührungslosem IR-Sensor startet der Reagenzglasschüttler die typische Vortex-Bewegung mit der zuvor eingestellten Geschwindigkeit sobald ein Probenröhrchen in unmittelbarer Nähe detektiert wird
Technische Daten:
Best.-Nr. ACN9.1
Bewegungsart kreisförmig vibrierend Drehzahlbereich 0 bis 3000 min ¹
B x T x H 150 x 165 x 130 mm
Netzanschluss 100–240 V, 50/60 Hz
Lieferung inkl. Standardaufsatz für Reagenzgläser und Kleingefäße.
Reagenzglasschüttler mit Infrarot-Sensor ZX4 Velp. Best.-Nr.
/ 10
Best.-Nr. VE CHFCHF 1YNK.1 1 Stück 6.758,70 5.744,90
CHFCHF
1 Stück 151,20 113,35
VE CHFCHF ACN9.1 1 Stück 270,40 216,30 Laborbedarf



Schüttler Orbital Digital Heathrow Scientific.
• Bewegungsart kreisförmig

Technische Daten:
Best.-Nr. PY67.1
Bewegungsart kreisförmig
Drehzahlbereich 20 bis 300 min ¹
Schüttelamplitude (Hub) 19 mm
Zeitschaltuhr 1 min bis 49 h oder Dauerbetieb
Schüttelfläche 279 x 279 mm
B x T x H 314 x 312 x 197 mm
Netzanschluss 100–240 V, 50/60 Hz
• Flexible Fixierung von Plates, Petrischalen, Glaskolben und Kulturflaschen mittels Gummibändern
• Beladungsmöglichkeiten: z. B. 9 Erlenmeyerkolben 250 ml oder 4 Erlenmeyerkolben 500 ml oder 4 Erlenmeyerkolben 1000 ml oder 16 Bechergläser 250 ml oder 4 Bechergläser 1000 ml
• 5 Jahre Garantie
Lieferung inkl. Plattform mit Gummimatte und 8 Gummibänder.
Best.-Nr. VE CHFCHF PY67.1 1 Stück 1.307,80 915,45
11
Laborbedarf

/
Tiefkühlschrank Performance SFFfg-Serie, Ex-geschützt
Liebherr.
Mit explosionsgeschütztem Innenraum gem. EU Richtlinie 2014/34/EU („ATEX Richtlinie“). Klassifizierung des Innenraums nach <Ex> II 3 G Ex ec IIC T6 (als Zone 22 deklariert) für brennbare Stoffe in geschlossenen Behältnissen, die explosive Atmosphären bilden könnten.
Allgemeine Angaben für alle Modelle:
• Kühltemperatur regelbar von -9 bis -30 °C
• Statische Kühlung
• Temperaturkonstanz ±5,0 K
• Bedienung über 3 Tasten, selbsterklärender/sprachunterstützter Menüfluss, 9 Sprachen verfügbar
• Speicher für Min/Max-Temperaturen, Aufzeichnungsdauer 999 h oder 42 d. Mit Möglichkeit, die Zeit und die Min-/Max-Temperatur für eine neue Aufzeichnung zurückzusetzen (nach Überprüfung der Temperaturen).
• Mit abschließbarer Tür
Labor-Kühl- und Gefrierkombination
Performance SCFfg 4002, Ex-geschützt Liebherr.
Mit explosionsgeschütztem Innenraum gem. EU Richtlinie 2014/34/EU
(„ATEX Richtlinie“). Klassifizierung des Innenraums nach <Ex> II 3 G Ex ec IIC T6 (als Zone 22 deklariert) für brennbare Stoffe in geschlossenen Behältnissen, die explosive Atmosphären bilden könnten.
• Kühltemperatur regelbar (2 getrennte regelbare Kältekreisläufe) Kühlteil: +3 bis +16 °C
Gefrierteil: -9 bis -30 °C
• Kühlteil mit Umluftventilation, Gefrierteil mit statischer Kühlung
• Temperaturkonstanz
Kühlteil: ±3 K
Gefrierteil: ±5 K
• Bedienung über 3 Tasten, Selbsterklärender/sprachunterstützter Menüfluss, 9 Sprachen verfügbar
• Speicher für Min/Max-Temperaturen, Aufzeichnungsdauer 999 h oder 42 d. Mit Möglichkeit, die Zeit und die Min-/Max-Temperatur für eine neue Aufzeichnung zurückzusetzen (nach Überprüfung der Temperaturen).
• Mit abschließbarer Tür
Technische Daten:
Best.-Nr. 24PA.120E9.120EA.1 257P.1
Typ SFFfg 4001 Var 740 SFFfg 4001SFFfg 5501SFFfg 5501 Var 740
Kühlinhalt 190 l 242 l 394 l
Gefriertemperatur ab -9 °C
Gefriertemperatur bis -30 °C
Anzahl Böden 5 Stück4 Stück
Schubfächer 6 Stück 8 Stück
Breite außen 597 mm 747 mm
Tiefe außen 654 mm 769 mm
Höhe außen 1.884 mm 1.684 mm
Abtauverfahren manuell
Energieverbrauch (24 h)1,052 kWh1,055 kWh1,414 kWh
Netzanschluss 220–240 V, 50 Hz
M odelle mit Glasböden
M odell mit Schubfächern Lieferung inkl. Schubfächern.

Technische Daten:
Best.-Nr. 260E.1
Kühlinhalt Kühlteil 199 l
Kühlinhalt Gefrierteil 62 l
Kühltemperatur ab +3 °C
Kühltemperatur bis +16 °C
Gefriertemperatur ab -9 °C
Gefriertemperatur bis -30 °C
Anzahl Böden Kühlteil 4
Anzahl Böden Gefrierteil 3
Breite außen 597 mm
Tiefe außen 654 mm
Höhe außen 2.044 mm
Abtauverfahren Kühlteil automatisch, Gefrierfach manuell
Energieverbrauch (24 h)0,951 kWh
Netzanschluss 230–240 V, 50 Hz
12
Typ Best.-Nr. VE CHFCHF SFFfg 4001 20E9.1 1 Stück 3.417,70 2.563,25 SFFfg 5501 20EA.1 1 Stück 4.002,70 3.002,00
Typ Best.-Nr. VE CHFCHF SFFfg 4001 Var 740 24PA.1 1 Stück 3.807,70 2.855,75 SFFfg 5501 Var 740 257P.1 1 Stück 4.496,70 3.372,50
CHFCHF 260E.1
3.768,70 2.826,50 Laborbedarf
Best.-Nr. VE
1 Stück

Lösungsmittelpumpe SEKUROKA®
Carl ROTH. Material: PTFE, Edelstahl 1.4301 und 1.4305.
Zum Abfüllen brennbarer Flüssigkeiten.
• Funktion nach dem Kolbenhubprinzip
• Tauchrohr auf jeweilige Fasstiefe stufenlos einstellbar
• Nahezu vollständige Fassentleerung
• Abnehmbarer Auslaufbogen zum Anschluss eines Auslaufschlauches mit Absperrhahn, bitte separat bestellen
Lieferung inkl. Fassverschraubung.
Gewinde Länge (mm) Best.-Nr. VE CHFCHF
2 ″ Stahl- Feingewinde 680 N502.1 1 Stück 352,30 264,20
2 ″ Stahl- Feingewinde 1.020 N503.1 1 Stück 387,40 290,55
Beim Abfüllen von brennbaren Flüssigkeiten müssen Gebinde und Pumpe z. B. mit dem Antistatik-Set ROTH (Best.-Nr. 0213.1) geerdet sein.
Technische Daten:
Best.-Nr. N502.1 N503.1 Förderleistung 140 ml 200 ml Eintauchtiefe 570 mm 910 mm Ø Tauchrohr 32 mm
Leitfähig Ja Gebinde bis 50 l bis 200 l Gewicht 1.2 kg 1.8 kg
Hinweis: Die Förderleistung bezieht sich auf einen Hub.
Antistatik-Set ROTH
Carl ROTH. Best.-Nr. VE

Sicherung gegen Brand und Explosion beim Abfüllen aus Lösungsmittelfässern infolge elektrostatischer Aufladung. Besteht aus zwei isolierten Kabeln (je Länge 3 m, Ø 3 mm) mit beidseitigen Klemmzangen und einem blanken Kupferband (Länge 3 m, Ø 2 mm) mit einseitiger Klemmzange.
13
CHFCHF
73,00 58,35 Laborbedarf
0213.1 1 Stück
Präzisionswaage PCB-Serie
KERN.
Ausstattung:
• Funktionsprogramme: Stückzählung, Rezeptur, Prozentwägung und Tierwägung
• Externe Justierung
• Windschutzring bei den Modellen mit 0,001 g Ablesbarkeit, Wägeraum Ø 90 mm x H 40 mm
• Hinterleuchtetes LCD-Display
Lieferung inkl. Netzgerät und Arbeitsschutzhaube.


Analysen- und Präzisionswaage
PR-Serie
Ohaus.
Anwendung
Stückzählung, Prozentwägen
Ausstattung:
• Mit interner Justierung
• Hintergrundbeleuchtetes LCD
• Glaswindschutz (W) mit 3 Schiebetüren bei den Modellen mit 0,0001 g und 0,001 g Ablesbarkeit (Innenraumhöhe 170 mm); (W) = inkl. Windschutz
• RS 232-Datenschnittstelle
M odelle mit interner Justierung, nicht eichfähig

14
Typ Wägebereich (g) Ablesbarkeit (g) Linearität (g) Reproduzierbarkeit (g) Waagschale (mm) Best.-Nr. VE CHFCHF PCB 200-3 200 0,001 ±0,005 0,001 Ø 82 261L.1 1 Stück 442,00 353,60 PCB 300-3 360 0,001 ±0,005 0,001 Ø 82 261N.1 1 Stück 468,00 374,40 PCB 300-2 300 0,01 ±0,02 0,01 Ø 105 261P.1 1 Stück 351,00 280,80 PCB 1000-2 1200 0,01 ±0,03 0,01 130×130 261T.1 1 Stück 429,00 343,20 PCB 3000-2 3600 0,01 ±0,05 0,01 130×130 261X.1 1 Stück 455,00 364,00 PCB 2000-1 2000 0,1 ±0,2 0,1 130×130 261Y.1 1 Stück 338,00 270,40 PCB 6000-1 6000 0,1 ±0,3 0,1 150×170 262C.1 1 Stück 364,00 291,20 PCB 10000-1 10000 0,1 ±0,3 0,1 150×170 262E.1 1 Stück 390,00 312,00 PCB 6000-0 6000 1 ±2 1 150×170 262A.1 1 Stück 208,00 166,40
Typ Wägebereich (g) Ablesbarkeit (g) Linearität (g) Reproduzierbarkeit (g) Waagschale (mm) Best.-Nr. VE CHFCHF PR224 (W) 220 0,0001 ±0,0002 ±0,0001 Ø 90 KHH9.1 1 Stück 1.846,00 1.384,50 PR523 (W) 520 0,001 ±0,002 ±0,001 Ø 120 KHK0.1 1 Stück 1.365,00 1.023,75 PR2202 2200 0,01 ±0,02 ±0,01 Ø 180 KHK1.1 1 Stück 1.345,50 1.009,10 PR4202 4200 0,01 ±0,02 ±0,01 Ø 180 KHK2.1 1 Stück 1.417,00 1.062,75 PR4201 4200 0,1 ±0,2 ±0,1 Ø 180 KHK3.1 1 Stück 1.241,50 931,10 PR6201 6200 0,1 ±0,2 ±0,1 Ø 180 KHK4.1 1 Stück 1.280,50 960,35
Laborbedarf

/
Weithalsfass
CurTec. Material: HDPE mit Gummidichtung.
UN-Zulassung (X-Zulassung) für Lagerung und Transport von festen Stoffen und Pasten. Geeignet für Lebensmittel, chemische und pharmazeutische Produkte. Luft-, wasser- und wasserdampfdicht. Maximale Fülltemperatur 70 °C. Verplompbar.
Ohne Handgriffe
Mit Handgriffen
15
Volumen (l) Ø außen (mm) Ø Hals innen (mm) Höhe (mm) UN-Zulassung Best.-Nr. VE CHFCHF 2,9 194 136 158 1H2/X12/S 255C.1 1 Stück 20,30 15,20 3,6 198 136 171 1H2/X12/S K280.1 1 Stück 23,30 17,40 5 198 136 222 1H2/X20/S 255E.1 1 Stück 26,65 19,95 6 198 136 263 1H2/X20/S 0788.1 1 Stück 28,25 21,10 10 274 203 238 1H2/X22/S L958.1 1 Stück 44,20 33,15 15 274 203 327 1H2/X22/S 0789.1 1 Stück 49,90 37,35 20 274 203 417 1H2/X27/S L959.1 1 Stück 56,50 42,30 26 316 203 425 1H2/X33/S 0790.1 1 Stück 63,85 47,80
Volumen (l) Ø außen (mm) Ø Hals innen (mm) Höhe (mm) UN-Zulassung Best.-Nr. VE CHFCHF 42 410 282 418 1H2/X51/S CY90.1 1 Stück 91,60 68,60 55 410 282 520 1H2/X66/S CY91.1 1 Stück 98,10 73,50 68 410 282 634 1H2/X81/S 5459.1 1 Stück 104,20 78,10
Laborbedarf

Rollwanne

Transportbehälter ROTILABO ® für Flaschen
ROTH SELECTION. Material: LDPE, Polyamid (Rollen).
Sperrholzplatte unter dem Behälter für zusätzliche Stabilität.
Technische Daten:
Best.-Nr. 225L.1 225N.1
Länge 610 mm 838 mm
Breite 381 mm 584 mm
Höhe 584 mm 508 mm
Rollen-Ø 65 mm 100 mm
Gewicht 6,9 kg 12,3 kg
135 l Mit vier Lenkrollen.
227 l Mit zwei Lenk- und zwei Bockrollen.

Made in Germany / Made in Germany /
Zubehör Deckel
ROTH SELECTION. Material: MDPE.
Technische Daten:
Best.-Nr. 225P.1 225T.1 Länge
ROTH SELECTION. Material: PP. Autoklavierbar: Ja.
Für den sicheren Flaschentransport. Fachunterteilungen können leicht herausgenommen werden. Die Behälter sind robust, kratzfest und reinigungsfreundlich.

Aufbewahrungsbehälter MultiStore
ROTH SELECTION. Material: PS. Farbe: lichtgrau.
• Stapelbar und zur Wandmontage geeignet
• Herausnehmbare, transparente Kippschubladen mit integriertem Etikettenhalter
• Staubfreie und saubere Lagerung des Inhaltes
• Vielseitig kombinierbar für individuelle Lagerlösungen
• Temperaturbeständigkeit: -20 bis +70
121 °C
16
/
Farbe Best.-Nr. VE CHFCHF rot 225L.1 1 Stück 282,10 225,65
Farbe Best.-Nr. VE CHFCHF rot 225N.1 1 Stück 429,00 343,20
Anzahl Fächer Fachgröße (mm) L x B x H außen (mm) Best.-Nr. VE CHFCHF 8 97 x 97400 x 3 00 x 270 C014.1 1 Stück 68,35 54,60 12 85 x 8 5400 x 3 00 x 2 20 C013.1 1 Stück 66,05 52,75
660 mm 902 mm
432 mm 660 mm
Breite
Für Rollwanne 135 l Passend für Farbe Best.-Nr. VE CHFCHF Best.-Nr. 225L.1 rot 225P.1 1 Stück 97,05 77,60 Für Rollwanne 227
Passend für Farbe Best.-Nr. VE CHFCHF Best.-Nr. 225N.1 rot 225T.1 1 Stück 163,15 130,50
l
°C
Fächer Fachgröße (mm) L x B x H außen (mm) Best.Nr. VE CHFCHF 2 221 x 265 x 241601 x 310.5 x 3 53 254C.1 1 Stück 160,20 128,10 3 149 x 176 x 161601 x 198 x 238 254A.1 1 Stück 99,10 79,20 4 128 x 125,5 x 133,5601 x 171.5 x 206 253Y.1 1 Stück 65,15 52,05 5 97 x 6 01 x 163601 x 136 x 163 253X.1 1 Stück 57,85 46,25 6 67 x 8 0 x 6 9601 x 9 4 x 112.5 253T.1 1 Stück 34,55 27,55 9 44,5 x 4 9 x 4 6601 x 6 4.5 x 76 253P.1 1 Stück 28,55 22,80 Laborbedarf
Anzahl

/
Etagenwagen mit Wannenböden
ROTH SELECTION. Material: Edelstahl 18/10, Radgehäuse aus Stahl verzinkt, Rollen aus Gummi.
Vier Lenkrollen, zwei feststellbar.
Anzahl Böden Plattform (mm) Best.-Nr. VE CHFCHF 2 750 x 510 250E.1 1 Stück 1.014,00 760,50
Technische Daten:
Best.-Nr. 250E.1
Länge 800 mm
Breite 550 mm
Höhe 920 mm
Wannenhöhe innen 95 mm
Etagenabstand 500 mm
Rollen-Ø 125 mm
Tragkraft 150 kg
Gewicht 18,1 kg
17
Laborbedarf

Mehrfach-Wischtücher WYPALL® X70
Kimberly-Clark. Material: Zellstoff, Kunststoff.
Aus HYDROKNIT® (Fest in ein Spinnvlies (Synthetik-Fasern 13 %) eingebundene Zellstoff-Fasern (87 %)). 1-lagig. Farbe: weiß. Hohe Saugfähigkeit, Reißfestigkeit und Strapazierfähigkeit (nass und trocken).
• Reinigungstuch für den mehrmaligen Gebrauch
• Für leichte und mittelschwere Wischvorgänge insbesondere dort, wo die Saugfähigkeit entscheidend ist
• Beständig gegen die meisten Lösungsmittel, reduziert Rückstände und ermöglicht ein schnelles Aufwischen verschütteter Flüssigkeiten wie z. B. Öl oder Wasser
• Zur Reinigung von Oberflächen, Werkzeugen und Maschinen
• Für den Kontakt mit Lebensmitteln geeignet
Tücher gefaltet (Typ 8296)
Länge (cm)
Vorperforierte Tücher auf Rolle (Typ 8348)

Reinigungsbürste ROTILABO ® ROTH SELECTION.
Aus Naturborsten mit Wollkopf oder komplett aus Wolle. Drehdraht verzinkt.
Bürste aus Naturborsten mit Wollkopf
Ø Bürste (mm)

Ultraschallreiniger ULTRASONOL® 7
Carl ROTH.
Materialschonender Spezialreiniger zur Unterstützung und Intensivierung der Ultraschallreinigung.
• Auch für empfindliche Gegenstände und Materialien geeignet. Nicht reizend oder toxisch
• Nicht brennbar, keine Gasbildung, biologisch abbaubar
• Flüssigkonzentrat pH 7
Einsatz 2-10 %ig in Wasser. Einwirkzeit ca. 10 min, anschließend gründlich nachspülen und trocknen.
Technische Daten:
Best.-Nr. 5356.1 5356.2 5356.4 Einsatzzweck für Ultraschallbäder Lieferform Flüssigkonzentrat
pH-Bereich neutral
Chlorfrei Ja Dosierung 2-10 %ig in Wasser
g Achtung H319
Kein Medizinprodukt/Kein ivD-Produkt.
Bürste aus Wolle
Ø
(mm)

Zur Verwendung als Schliffpaste, Dichtungspaste, Gleitmittel und Schutzpaste. Feuchtigkeitsabweisend. Auch als Dichtungsmittel für elektrische Geräte, als Gleitpaste an Kühlaggregaten und als Formtrennmittel einsetzbar. Temperaturbeständig von -50 bis +200 °C. Silikonpaste KORASILON ® Obermeier.
Niedrigviskos
Mittelviskos
Hochviskos
18
Bürstenlänge (mm) Länge gesamt (mm) Best.Nr. VE CHFCHF 5 85 280 XK58.1 5 Stück 20,80 14,55 8 85 280 XK59.1 5 Stück 22,95 16,05 10 60 230 XK60.1 5 Stück 16,65 11,60 12 85 280 XK61.1 5 Stück 22,95 16,05 15 85 280 XK62.1 5 Stück 16,65 11,60
105 270 XK63.1 5 Stück 22,95 16,05 30 115 270 XK64.1 5 Stück 29,60 20,65 40 130 520 XK66.1 1 Stück 8,00 5,55 50 150 320 XK67.1 1 Stück 11,20 7,80 60 145 520 XK69.1 1 Stück 10,25 7,05
20
Bürste
Bürstenlänge (mm) Länge gesamt (mm) Best.Nr. VE CHFCHF 35 100 330 XK65.1 1 Stück 9,25 6,40 55 140 390 XK68.1 1 Stück 11,45 8,00
Best.-Nr. VE CHFCHF 5356.1 1 l 20,75 14,50 5356.2 5 l 80,75 56,45 5356.4 20 kg 241,80 169,25
Verpackungsart Best.-Nr. VE CHFCHF Tube 0855.1 35 g 8,95 6,15
Verpackungsart Best.-Nr. VE CHFCHF Tube 0856.1 35 g 8,95 6,15
Verpackungsart Best.-Nr. VE CHFCHF Tube 0857.1 35 g 8,95 6,15
Breite
Verpackungsart
Best.-
42,6 28,2 Box 1 x 200 Tü cher 1H50.1 200 Stück 82,20 61,60
(cm)
Verp.
Nr. VE CHFCHF
Länge (cm) Breite (cm) Ø (cm) Verpackungsart Verp. Best.Nr. VE CHFCHF 34 31,5 37 Rolle 870 Tü cher 1H51.1 1 Stück 257,40 193,05 Laborbedarf
Ultraschallgerät Emmi ® Serie-D
Emag.
Leistungsstarke Universalgeräte mit digitaler Anzeige zum Reinigen von Laborutensilien, zur Beschleunigung von Lösungsvorgängen sowie zum Entgasen von Flüssigkeiten. Gehäuse und Schwingwanne aus Edelstahl 1.4301.
Ausstattung:
• Zeitschaltuhr 1-30 min oder Dauerbetrieb
• Heizung regelbar bis ca. 80 °C
• Leistungsregulierung 50/100 %
• Sweeptechnik
• Degasfunktion
• Betriebsfrequenz ca. 40 kHz
Technische Daten:
Lieferung inkl. Deckel und Einsatzkorb aus Edelstahl.
Kein Medizinprodukt/Kein ivD-Produkt.



Technische
Daten:
Best.-Nr. 5354.1 5354.2
Einsatzzweck für Ultraschallbäder
Lieferform Flüssigkonzentrat
pH-Bereich alkalisch
Dosierung 2-10 %ig in Wasser
Ultraschallreiniger ULTRASONOL® 11
Carl ROTH.
Hochwirksamer Spezialreiniger zur Unterstützung und Intensivierung der Ultraschallreinigung.
• Entfernt spurenfrei Destillationsrückstände, Teere, Harze, Kanadabalsam, Klebstoffe, Silikone, Fette, Öle und ähnliche Verschmutzungen
• Nicht brennbar, keine Gasbildung, biologisch abbaubar
• Flüssigkeitskonzentrat pH 12,9
Einsatz 2-10 %ig in Wasser. Einwirkzeit 1 bis 10 min, anschließend gründlich nachspülen und trocknen.
h Gefahr H290-H314-H412
Kein Medizinprodukt/Kein ivD-Produkt.
Best.-Nr. VE
5354.1 1 l
5354.2 5 l
19
Best.-Nr. CPL1.1 CPL2.1
CPL3.1
CPL5.1
Typ Emmi ® -D30 Emmi ® -D40 Emmi ® -D60 Emmi ® -D130 Emmi ® -D280 Volumen 2,6 l 3,55 l 5,3 l 11,5 l 26,4 l Volumen max. 3 l 4 l 6 l 13 l 28 l Länge Wanne innen 238 mm 300 mm 302 mm 300 mm 502 mm Breite Wanne innen 138 mm 150 mm 152 mm 240 mm 298 mm Wannenhöhe innen 100 mm 150 mm 200 mm Länge Korb innen 200 mm 265 mm 270 mm 280 mm 460 mm Breite Korb innen 105 mm 115 mm 120 mm 225 mm 270 mm
70 mm 115 mm 180 mm 140 mm Länge außen 325 mm 385 mm 380 mm 330 mm 530 mm Breite außen 180 mm 185 mm 175 mm 270 mm 330 mm Höhe außen 240 mm 250 mm 240 mm 355 mm 360 mm Betriebsfrequenz 40 kHz Ultraschall Spitzenleistung 240 W 320 W 400 W 640 W Heizleistung 150 W 200 W 250 W 400 W 600 W Ablaufhahn Ja
220–240 V, 50/60 Hz
CPL6.1
Höhe Korb innen
Netzanschluss
Typ Volumen (l) Länge außen (mm) Breite außen (mm) Höhe außen (mm) Best.-Nr. VE CHFCHF Emmi ® -D30 2,6 325 180 240 CPL1.1 1 Stück 769,60 615,65 Emmi ® -D40 3,55 385 185 250 CPL2.1 1 Stück 986,70 789,35 Emmi ® -D60 5,3 380 175 240 CPL3.1 1 Stück 1.112,80 890,20 Emmi ® -D130 11,5 330 270 355 CPL5.1 1 Stück 2.203,50 1.762,80 Emmi ® -D280 26,4 530 330 360 CPL6.1 1 Stück 2.719,60 2.175,65
CHFCHF
18,75 13,05
80,60 56,40 Laborbedarf
Flaschen-Mehrfachverteiler GL 45
Autoklavierbar: Ja.
Schraubkappe GL 45 mit 2 oder 3 Gewindehälsen GL 14. Geeignet zum Transfer von Flüssigkeiten, z. B. zum Beschicken von HPLC-Automaten mit Lösungsmitteln oder zur Verwendung in Titrationsanlagen.
Auch als Woulff’sche Flasche nutzbar. An den Flaschen-Mehrfachverteiler können mittels GL 14-Laborverschraubungen Schläuche mit einem Außen-Ø von 1,6 bis 6,0 mm befestigt werden. Verschlusseinsatz frei drehbar, verhindert das Verdrehen der Schläuche beim Austausch der Flasche.
Lieferung ohne Flasche, Laborverschraubungen und Druckausgleichset, bitte separat bestellen.
Einsatz und Schraubkappe aus PP Material: PP. Gute Chemikalienbeständigkeit, temperaturbeständig von -40 bis +140 °C.
Anzahl Anschlüsse

Zubehör für Flaschen-Mehrfachverteiler
DWK Life Sciences.
Bezeichnung Best.-Nr. VE CHFCHF
Druckausgleich-Set GL 14 (Schraubkappe mit Olive, Schlauch aus Tygon, Membranfilter)
Schraubverschlusskappen PBT, GL 14
Flaschen-Mehrfachverteiler GL 45 mit Oliven
Mit zwei durchgängigen Oliven, oben gebogen um ein Abknicken der Schläuche zu verhindern. Temperaturbeständig bis +140 °C, spülmaschinengeeignet.
• Sicherer Transfer flüssiger Medien innerhalb geschlossener Systeme
• Kern ist frei beweglich und ermöglicht einen Behälterwechsel ohne Verdrehen der fest fixierten Schläuche
• Ideal zum Einsatz mit elastischen, weichen Schläuchen mit ID 6-9 mm (Viton ®, Tygon ®, Silikon), z. B. bei der Arbeit mit Peristaltikpumpen

DWK Life Sciences. Material: PP. Autoklavierbar: Ja. für Schläuche Ø innen (mm)
• Druckausgleichs-Filteraufsatz optional erhältlich
Laborverschraubungen GL 14
DWK Life Sciences. Material: PP, Einsätze aus PTFE mit Silikonring.
Autoklavierbar: Ja.
Bestehend aus je 2 Schraubverbindungskappen GL 14 und 2 Einsätzen für unterschiedliche Schlauchdurchmesser.

für Schläuche Ø außen (mm) Gewinde Best.-Nr.
121 °C 121 °C 121 °C 20
HX90.1 1 Stück 36,25 29,60
TX90.1 10 Stück 31,05 25,40
Best.-Nr. VE CHFCHF
GL 45 HX84.1 2 Stück 77,35 63,35 3 GL 45 HX85.1 2 Stück 82,70 67,80
Gewinde
2
VE CHFCHF 1.6 GL 14 HX86.1 2 Stück 45,25 37,05 3.0 GL 14 HX87.1 2 Stück 45,25 37,05 3.2 GL 14 HX88.1 2 Stück 45,25 37,05 6.0 GL 14 HX89.1 2 Stück 45,25 37,05
Best.-Nr. VE CHFCHF 6-9 GL 45 PY86.1 2 Stück 81,65 66,85 Laborbedarf
Gewinde
121 °C
Gewindeflasche DURAN ® Braunglas
DWK Life Sciences. Material: DURAN ® -Glas. Autoklavierbar: Ja.

Amberfarben, unveränderte DURAN ® -Eigenschaften im Inneren der Flasche da Farbauftrag nur äußerlich. Lange Haltbarkeit und gute chemische Resistenz der Braunfärbung. Lichtschutz: Absorption im kurzwelligen Bereich bis zu 500 nm.
• Mit DIN-GL-Gewinde und Teilung
• Flaschen bis 25 ml mit speziell geformtem Glasrand, dadurch ist kein zusätzlicher Ausgießring notwendig
• Flaschen 100 bis 2000 ml: ringförmige Verstärkung an der Schulter der Flaschen markiert den Nenninhalt
• Mit aufgedrucktem Retrace Code (Chargenkennung)
• Nach ISO 4796-1
Mit Ausgießring und Schraubverschlusskappe aus PP
21
Volumen (ml) Ø außen (mm) Höhe (mm) Gewinde Best.-Nr. VE CHFCHF 50 46 91 GL 32 A367.1 10 Stück 318,50 261,15 100 56 105 GL 45 A368.1 10 Stück 358,80 294,15 150 62 110 GL 45 PC85.1 10 Stück 422,50 346,45 250 70 143 GL 45 A369.1 1 Stück 50,15 41,05 500 86 181 GL 45 A370.1 1 Stück 63,70 52,20 750 95 203 GL 45 PC86.1 10 Stück 689,00 564,95 1.000 101 230 GL 45 A371.1 1 Stück 78,30 64,15 2.000 136 265 GL 45 A372.1 1 Stück 122,80 100,65 3.500 160 295 GL 45 PC87.1 1 Stück 258,70 212,10 5.000 182 335 GL 45 A373.1 1 Stück 356,20 292,05 10.000 227 415 GL 45 A374.1 1 Stück 578,50 474,35
Laborbedarf

S
Spritzenfilter
Carl ROTH. Steril
ROTILABO
®
Einzeln verpackt. Mit Luer-Lock-Eingang und Luer-Ausgang.
Kein Medizinprodukt/Kein ivD-Produkt.
C ME
Mit hydrophiler Membran aus Cellulosemischester (CME) zur Filtration von Zusätzen, Gewebekulturmedien und Antibiotika.
Technische Daten:
Best.-Nr. KH54.1 KH55.1
Ø Membran 30 mm
Ø Gehäuse 33 mm
Material Membran CME
Material Gehäuse PMMA-Polymer
Probenvolumen ~100 ml
Totvolumen <80 µl
Filterfläche 4,52 cm²
Einsatztemperatur max. 45 °C
Betriebsdruck max. 8,6 bar
Anschluss Eingang Luer-Lock
Anschluss Ausgang Luer
Porengröße (µm)
Ø Membran (mm)
VE
Spritzenfilter ROTILABO ® Glasfaser
ROTH SELECTION.
Zur Vorfiltration von Proben mit hoher Partikelbelastung. Rückhaltebereich 1-2 μ m, bindemittelfrei.
Gehäuse aus PP ultraschallverschweißt, Gehäuse aus PC randumspritzt.
Technische Daten:
Best.-Nr. KC98.1 KC99.1 KE00.1
Ø Membran 15 mm 25 mm 30 mm
Ø Gehäuse 20 mm 30 mm 34 mm
Material Membran Glasfaser
Material Gehäuse PP PC
Probenvolumen 1–10 ml 10–100 ml >100 ml
Totvolumen <25 µl <65 µl <170 µl
Gesamtfiltervolumen 0,335 ml 0,6 ml 0,864 ml
Filterfläche 1,77 cm² 4,90 cm² 7,07 cm²
Betriebsdruck max. 7 bar 6 bar
Anschluss Eingang Luer-Lock
Anschluss Ausgang Luer
PES
Mit hydrophiler Membran aus Polyethersulfon (PES) zur ultraschnellen Filtration von Gewebekulturmedien, -zusätzen und anderen wässrigen Lösungen.
Technische Daten:
Best.-Nr. P668.1
Ø Membran 30 mm
Ø Gehäuse 33 mm
Material Membran PES
Material Gehäuse PMMA-Polymer
Probenvolumen ~100 ml
Totvolumen <80 µl
Filterfläche 4,52 cm²
Einsatztemperatur max. 45 °C
Betriebsdruck max. 8,6 bar
Anschluss Eingang Luer-Lock
Anschluss Ausgang Luer
Porengröße (µm)
PVDF
Sterilität Ø Membran (mm)
Mit hydrophiler Membran aus Polyvinylidenfluorid (PVDF) zur Filtration von Proteinlösungen, Gewebekulturmedien, Zusätzen, Antibiotika und alkoholischen Lösungen.
Technische Daten:
Best.-Nr. P666.1 P667.1
Ø Membran 30 mm
Ø Gehäuse 33 mm
Material Membran PVDF
Material Gehäuse PMMA-Polymer
Probenvolumen ~100 ml
Totvolumen <80 µl
Filterfläche 4,52 cm²
Einsatztemperatur max. 45 °C
Betriebsdruck max. 8,6 bar
Anschluss Eingang Luer-Lock
Anschluss Ausgang Luer
Porengröße (µm)
Sterilität Ø Membran (mm)
VE

Kein Medizinprodukt/Kein ivD-Produkt.
Porengröße (µm) Sterilität Ø Membran (mm)
VE
22
Best.-Nr.
S teril 30 KH54.1 50 Stück 113,45 90,70 0,45 S teril 30 KH55.1 50 Stück 186,55 149,20
Sterilität
CHFCHF 0,22
Best.-Nr.
CHFCHF
VE
50 Stück 131,90 105,50
0,22 S teril 30 P668.1
Best.-Nr.
CHFCHF
S teril 30 P666.1 50 Stück 131,90 105,50 0,45 S teril 30 P667.1 50 Stück 131,90 105,50
0,22
Best.-Nr.
CHFCHF
KC98.1 100 Stück 96,95 77,45
100 Stück 161,40 129,05
100 Stück 287,30 229,80 Laborbedarf
1-2 Unsteril 15
1-2 Unsteril 25 KC99.1
1-2 Unsteril 30 KE00.1

Hand-Refraktometer analog
KERN.
Zur Messung des Brechungsindex von transparenten Stoffen in flüssigem Zustand.
• Okular mit Dioptrienausgleich
• Skala exakt kalkuliert und geprüft, mit sehr dünnen und klaren Linien
• Ohne oder mit automatischer Temperaturkompensation (ATC)
Messtemperatur mit ATC: 10 bis 30 °C
Messtemperatur ohne ATC: 20 °C
Lieferung inkl. Kalibrierlösung und Aufbewahrungsbox.
Anwendungsbereich: Labor
Anwendungsbereich: Lebensmittelindustrie/Qualitätskontrolle
Anwendungsbereich: Lebensmittelindustrie/Weinherstellung
23
Typ Skala / Messb ereich Auflösung Temp.-kompensation Best.-Nr. VE CHFCHF ORA 4RR Brechungsindex / 1,440–1,520 nD 0,001 nD Nein CEX9.1 1 Stück 123,50 86,45 ORA 1RE Brechungsindex / 1,333–1,517 nD 0,005 nD Nein CEY0.1 1 Stück 468,00 327,60
Typ Skala / Messb ereich Auflösung Temp.-kompensation Best.-Nr. VE CHFCHF ORA 10BA Brix / 0–10 % 0,1 % Ja CEY1.1 1 Stück 123,50 86,45 ORA 20BA Brix / 0–20 % 0,1 % Ja CEY2.1 1 Stück 123,50 86,45 ORA 32BA Brix / 0–32 % 0,2 % Ja CEY3.1 1 Stück 123,50 86,45 ORA 80BB Brix / 0–80 % 0,5 % Nein CEY4.1 1 Stück 117,00 81,90
Typ Skala / Messb ereich Auflösung Temp.-kompensation Best.-Nr. VE CHFCHF ORA 3WA Brix / 0–32 % , Oechsle / 30–140 °Oe 0,2 %, 1 °Oe Ja CEY5.1 1 Stück 123,50 86,45 ORA 1WA Brix / 0–32 % Oechsle / 0–140 °Oe, KMW (Babo) / 0–25 ° KMW 0,2 %, 1 °Oe, 0,25 °KMW Ja CEY6.1 1 Stück 123,50 86,45 ORA 2AB Vol (Gewicht)
% Vol 1 % Vol (0–50 % Vol), 2,5 % Vol (50–80 % Vol) Nein CEY7.1 1 Stück 117,00 81,90
/ 0–80
Laborbedarf
Präzisionsthermometer
ROTH SELECTION.
• Einschlussform
• Füllflüssigkeit: Spezialfüllung
mit hoher Genauigkeit
• Kapillarform: unbelegt, prismatisch
• Ganztauchend justiert: Ja
S tandard
Messbereich
Mit FEP-Sicherheitsummantelung

Thermometer für Autoklaven
ROTH SELECTION. Autoklavierbar: Ja.
Zur Überwachung der Temperatur während des Autoklaviervorgangs.
• Anzeigen der max. Temperatur durch Mitschleppen des roten Stellmarkers
• Manuelle Rückstellung via Drehschraube
• Bimetall-Thermometer mit Gehäuse und abnehmbarem Standfuß aus Edelstahl, Staubschutzkappe aus Silikon
• Wasserdichte Glasscheibe, druckbeständig
Messbereich

121 °C 24
Temperatur (°C) Auflösung Temperatur Genauigkeit Temperatur Länge (mm) Thermometer-Ø (mm) Füllflüssigkeit Best.-Nr. VE CHFCHF -10 bis +50 0,5 °C ±0,5 °C 220 8 – 10 blau HKX4.1 1 Stück 86,30 64,65 -10 bis +100 0,5 °C ±0,5 °C 270 8 – 10 blau HKX5.1 1 Stück 98,10 73,50 -10 bis +1500,5 °C ±0,5 °C 350 8 – 10 blau HKX6.1 1 Stück 117,30 87,95 -10 bis +2000,5 °C ±0,5 °C 450 8 – 10 blau HKX7.1 1 Stück 128,45 96,30 -5 bis +50 0,2 °C ±0,3 °C 350 8 – 10 blau HKX8.1 1 Stück 99,75 74,75 -5 bis +100 0,2 °C ±0,3 °C 420 8 – 10 blau HKX9.1 1 Stück 138,20 103,60 -5 bis +2010,2 °C ±0,4 °C 550 8 – 10 blau HKY0.1 1 Stück 252,20 189,15 -10 bis +50 0,1 °C ±0,2 °C 400 8 – 10 blau HKY1.1 1 Stück 146,60 109,90 0 bis +100 0,1 °C ±0,2 °C 550 8 – 10 blau HKY2.1 1 Stück 237,90 178,40
Messbereich Temperatur (°C) Auflösung Temperatur Genauigkeit Temperatur Länge (mm) Thermometer-Ø (mm) Füllflüssigkeit Best.-Nr. VE CHFCHF -10 bis +50 0,5 °C ±0,5 °C 220 8 – 10 blau HKY3.1 1 Stück126,75 95,00 -10 bis +100 0,5 °C ±0,5 °C 270 8 – 10 blau HKY4.1 1 Stück 165,90 124,40 -10 bis +1500,5 °C ±0,5 °C 350 8 – 10 blau HKY5.1 1 Stück 194,10 145,50 -10 bis +2000,5 °C ±0,5 °C 450 8 – 10 blau HKY6.1 1 Stück 215,80 161,85 -5 bis +50 0,2 °C ±0,3 °C 350 8 – 10 blau HKY7.1 1 Stück 175,00 131,20 -5 bis +100 0,2 °C ±0,3 °C 420 8 – 10 blau HKY8.1 1 Stück 221,00 165,75 -5 bis +2010,2 °C ±0,4 °C 550 8 – 10 blau HKY9.1 1 Stück 358,80 269,10 -10 bis +50 0,1 °C ±0,2 °C 420 8 – 10 blau HLA0.1 1 Stück 227,50 170,60 0 bis +100 0,1 °C ±0,2 °C 550 8 – 10 blau HLA1.1 1 Stück 349,70 262,25
Temperatur (°C) Auflösung Temperatur Genauigkeit Temperatur Material Gehäuse Ø (mm) Tiefe (mm) Höhe (mm) Best.-Nr. VE CHFCHF -20 bis +1502 °C ±1,5 °C Edelstahl 81 85 95 CXP0.1 1 Stück 127,40 89,15 Laborbedarf

Thermometer Lab Serie Dostmann.
Anwendungsgebiete: Messungen in Kühl- und Gefrierschränken, Lagerung von Lebensmitteln u. v. a.
• Wasserdichtes Gehäuse
• Min/Max- und Hold-Funktion
• Akustischer und optischer Alarm bei Unter-/Überschreiten von frei einstellbaren Temperaturwerten
• Magnet zum Befestigen an Metallflächen
Lieferung inkl. Batterie.
(1) Lab Basic
Kalibrierung
Temperaturbremse für Thermometer Dostmann.
Referenzkörper für konstante Temperaturmessung in Kühlschränken. Vermeidet größere Temperaturschwankungen z. B. durch häufiges Öffnen der Kühlschranktür. Der Fühler wird in eine der passgenauen Bohrungen gesteckt und mit einer Schraube fixiert. Der Referenzkörper wirkt als Puffer und sorgt für einen homogenen Temperaturverlauf, da Masse und nicht Luft gemessen wird. Passend für Fühler Ø 3,5 / 4,2 / 5,0 mm
Technische Daten:
Best.-Nr. KA32.1PY66.1KA33.1 Typ Lab Basic Lab Pro Parameter Temperatur
Messbereich Temperatur -40 bis +70 °C -40 bis +200 °C
Auflösung Temperatur 0,1 °C
Genauigkeit Temperatur
IP-Schutzklasse 65
Kabellänge 3 m 1 m
Fühler: Ø x L 5 x 20 mm 3.5 x 100 mm
L x B x H 86 x 30 x 57 mm
Gewicht 40 g
Stromversorgung Batterie Knopf CR 2032 (3 V)
(2) Lab Pro


25
±0,5 °C
°C),
±1,0 °C (-40 bis 0 °C), ±0,5 °C
+50 °C), ±1,0 (+50
+100 °C),
°C
(-20 bis +25
±1,0 °C (außerhalb)
(0 bis
bis
±1,5
(außerhalb)
Best.-Nr.
CHFCHF
KA32.1 1 Stück 27,45 20,50
+5 °C) PY66.1 1 Stück 41,60 31,20
VE
ohne
mit Werksprüfschein (Prüfpunkt bei
Kalibrierung Best.-Nr. VE CHFCHF ohne KA33.1 1 Stück 34,95 26,10
Best.-Nr. VE CHFCHF 60 x 25 x 25 PT43.1 1 Stück 29,10 21,75 Laborbedarf
L
x B x H (mm)

Vakuum-Messgerät
ROTH SELECTION.
Die Geräte werden mit einer Vakuumpumpe saugseitig in Serie geschaltet. Stativmontage möglich (über Federklemmen an der Geräterückseite).
Technische Daten:
Best.-Nr. Y457.1
Typ VAR
Ausführung Regler
Messbereich 1020–0 mbar
Auflösung 10 mbar
Anschluss für Schlauch-Ø innen 8 mm
B x T x H 80 x 80 x 150 mm
VAR mit manuellem Regler
Zur Regelung und Konstanthaltung des Vakuums mittels Regelknopf. Stufenlos regelbar für variables Vakuum-Niveau.

Membran-Vakuumpumpe LABOPORT ® N 96, drehzahlgeregelt KNF.
Chemiefeste Membranpumpe, kompakt im Design, mit geringer Stellfläche. Durch integrierte, manuelle Drehzahlregelung mittels Drehknopf problemlos an die entsprechende Anwendung anpassbar. Sehr energieeffizient und leise. Oberfläche sehr leicht zu reinigen.
Technische Daten:
Best.-Nr. 1EK3.1
Typ N 96
Saugvermögen (l/min) 7.0
Saugvermögen (m³/h) 0.4
Endvakuum abs. 130 mbar
Überdruck 2,5 bar
Medientemperatur +5 – +40 °C
Anschluss für Schlauch-Ø innen 4–6 mm
Motorleistung 19 W
IP-Schutzklasse 40
Medienberührende
Materialien
Pumpenkopf: PPS, Membran: PTFE-beschichtet, Ventile: FKM
B x T x H 156 x 75 x 119 mm
Gewicht 1,3 kg
Netzanschluss 100–240 V, 50/60 Hz
Anwendung: Filtration, Flüssigkeitsabsaugung.
Best.-Nr.

Schlauchschellen mit Schneckengewinde
ROTH SELECTION. Material: Edelstahl 1.4016, Schraube verzinkt.
Schlauch ROTILABO ® Silikon

Deutsch & Neumann. Material: Silikon schwach trüb. Autoklavierbar: Ja.
Kurzfristig temperaturbeständig bis +260 °C.
Vakuumausführung Dickwandig.
Technische Daten:
Temp.-beständigkeit -60 bis +180 °C
Farbe farblos
Härte 55 Shore A
Ø innen (mm) Ø außen (mm) Wandstärke (mm)
ROTH 121 °C 26
Best.-Nr. VE CHFCHF Y457.1 1 Stück 297,70 253,05
Passend für Best.-Nr. VE CHFCHF Schlauch Ø außen 8–12 mm AEH1.1 10 Stück 20,35 16,25 Schlauch Ø außen 10–16 mm AEH2.1 10 Stück 20,30 16,15 Schlauch Ø außen 12–20 mm AEH3.1 10 Stück 22,95 18,30 Schlauch Ø außen 16–27 mm AEH4.1 10 Stück 24,25 19,35 Schlauch Ø außen 20–32 mm AEH5.1 10 Stück 24,85 19,80
VE CHFCHF 1EK3.1 1 Stück 608,40 486,70
Best.-Nr. VE CHFCHF 3 9 3 9737.1 5 m 49,90 39,85 4 12 4 9738.1 5 m 67,50 53,95 5 15 5 9740.1 5 m 98,00 78,30 6 12 3 9742.1 5 m 62,70 50,10 7 15 4 9744.1 5 m 104,85 83,85 8 16 4 9746.1 5 m 117,55 93,95 10 20 5 9747.1 5 m 148,95 119,05 12 22 5 T980.1 5 m 163,90 131,00 Laborbedarf

Drehschieberpumpen-Paket ROTILABO ® CR-DS40
ROTH SELECTION.
Robuste, zweistufige Vakuumpumpe v.a. für Vakuumöfen, Gefriertrockner und Schlenkline Technik. Dank innovativer Technologie lange Lebensdauer, hohe Zuverlässigkeit und geringer Wartungsbedarf.
• Niedrigere Betriebstemperatur durch optimierte Kühlung verringert die chemische Aktivität in der Pumpe und reduziert den Ölverbrauch
• Verlängerte Ölwechselintervalle durch großen Ölvorratsbehälter
• Größere Ölkapazität führt zur stärkeren Verdünnung chemischer Dämpfe, Minimierung der Ölzerfallsraten und Reduktion chemischer Angriffe in der Pumpe
• Verlangsamte Metallkorrosion durch zusätzliche Beschichtung von Pumpenmodul und Ölvorratsbehälter verlängern in Verbindung mit Kühlfallen die Wartungsintervalle
Lieferung inkl. Ölnebelfilter, Adapter (Kleinflansch DN 16 auf Schlauchwelle DN 10/8 mm), 1 l Pumpenöl, Trichter, Spann- und Zentrierringe.
Technische Daten:
Best.-Nr.
1A9E.1
Typ CR-DS40
Saugvermögen (l/min) 38.0
Saugvermögen (m³/h) 2.3
Endvakuum abs. 3 x 10 -3 mbar
Endvakuum abs. mit Gasballast9 x 10 -2 mbar
Medientemperatur +10 – +40 °C
Anschluss Kleinflansch KF DN 16
Ölfüllung 0,45 l
Motorleistung 290 W
Umgebungstemperatur +10 – +40 °C
IP-Schutzklasse 54
Geräuschpegel 50 dB
B x T x H 384 x 138 x 211 mm
Gewicht 15 kg
Netzanschluss 115–230 V, 50/60 Hz
27
Best.-Nr. VE CHFCHF 1A9E.1 1 Stück 2.523,30 2.018,60 Laborbedarf

Arbeitsplatzleuchte MAULcraft MAUL.
Leistungsstarke Leuchte mit geringem Energieverbrauch.
Ideal für Arbeiten in Laboren, Werkstätten und technischen Büros.
• Stufenlos dimmbar
• 90 tageslichtweiße LEDs
• Dreidimensional verstellbarer Leuchtenkopf
• Bedienfeld am Leuchtenkopf für bequemes Schalten
• Robuster Metallarm, drehbar um 360° und neigbar um 110°
• Armlänge unten 400 mm und oben 440 mm
• Höhe in normaler Arbeitsstellung 470 mm, höhenverstellbar von -23 cm (unter Tischkante) bis +76 cm (über Tischkante)
• Klemmfuß mit Klemmweite bis 63 mm
Technische Daten:
Best.-Nr. KLT7.1
Typ MAULcraft
Farbe weiß
Ausführung mit Klemmfuß
Lichtquelle LED
Leistung 14 W
Lebensdauer 20 000 Stunden
Energieeffizienzklasse E
Lichtstärke 2.960 lx
Lichtstrom 970 lm
Farbtemperatur 6500 K
Kabellänge 1,70 m
Netzanschluss 230 V, 50 Hz
Lieferung inkl. Leuchtmittel.

Digitales USB-Handmikroskop ODC 895 KERN.
Zur schnellen und einfachen Vorabuntersuchung z. B. von P flanzen, Insekten oder Hautproben. Starke und effektive Ausleuchtung der Proben durch acht in Ringform angebrachte LEDs. Mitgelieferte Software multilingual. Mit den Funktionen Streaming, Bilder-Snapshot und Video. Unterstützte Betriebssysteme: Win XP, Vista, 7, 8, 10.
Technische Daten:
Best.-Nr. HNH2.1
Typ ODC 895
Gesamtvergrößerung 10x, 200x
Arbeitsabstand 60 mm
Lichtquelle LED
Beleuchtungsart Auflicht
Scharfstellung Grobtrieb
Objekttisch 150 x 80 mm
Schnittstelle USB 2.0
Sensortyp CMOS
Sensorformat 1/3,2 ″
Pixelzahl 2 MP
Bilder pro Sekunde 15–30
Stromversorgung über USB-Anschluss (Festkabel, Länge 1,4 m)

Leuchtplatte
Rex.
Zur Betrachtung und präzisen Farbbeurteilung von Dias, zur Begutachtung großformatiger Filme und Folien, Beleuchtung von Röntgenaufnahmen, Auswahl und Beurteilung von Bildmaterial oder zum Vergleichen übereinandergelegter Kurven oder Chromatogramme usw.
• Besonders flache Bauweise
• Plane und kratzfeste Kunststoff-Opalscheibe
• Flimmer-/flackerfreies Licht, für ermüdungsfreies Betrachten
• Randlose und gute Ausleuchtung
• Bei Dauerbetrieb nur geringfügige Erwärmung der Oberfläche
Technische Daten:
Best.-Nr. KKL1.1 KKK8.1KKK9.1KKL0.1
Typ Gr. 2-LEDGr. 6-LED Gr. 1-LED (2000) Gr. 1-LED (3500)
L x B x H 550 x 378 x 58 mm 316 x 250 x 58 mm 416 x 270 x 58 mm
Leuchtfläche 530 x 355 mm298 x 230 mm395 x 248 mm
Farbtemperatur 6500 K
Leuchtdichte 2.000 cd/m² 3.500 cd/m² Leistung 18 W 7 W 10 W 20 W Energieeffizienzklasse F Kabellänge 2 m
Netzanschluss 230 V, 50/60 Hz
Mit LED Material: Kunststoff (Gehäuse), Farbe lichtgrau.
Gr. 1-LED (3500)416

Linsenpapier MN 13 B Macherey-Nagel.
Fusselfreies Seidenpapier zur Reinigung optischer Gläser, Küvetten und als Schutzpapier für metallographische Schliffe. Block mit 50 Blatt.
Länge (mm) Breite (mm) Best.-Nr. VE CHFCHF
28
Farbe Leistung (W) Best.-Nr. VE CHFCHF weiß 14 KLT7.1 1 Stück 280,80 224,60
VE CHFCHF HNH2.1 1 Stück 286,00 200,20
Best.-Nr.
Typ L x B x H (mm) Best.-Nr. VE CHFCHF
550 x 378 x 5 8 KKL1.1 1 Stück 432,90 324,65
316 x 250 x 5 8 KKK8.1 1 Stück 269,10 201,80
(2000)416
270
5 8 KKK9.1 1 Stück 284,70 213,50
Gr. 2-LED
Gr. 6-LED
Gr. 1-LED
x
x
x 270 x 5 8 KKL0.1 1 Stück 392,60 294,45
80 100 1068.1 10 Stück 82,95 66,30 Laborbedarf
Instrumentenschale ROTILABO ® mit Deckel

ROTH SELECTION. Material: Edelstahl 18/10. Autoklavierbar: Ja.
Schale tiefgezogen aus einem Stück, daher leicht zu reinigen und zu desinfizieren. Spezialdeckel mit Griff. Stapelbar.
Kein Medizinprodukt/Kein ivD-Produkt.
Länge außen (mm) Breite außen (mm) Höhe außen (mm)Länge innen (mm) Breite innen (mm) Höhe innen (mm)
Spritzflasche
Kartell. Material: PE.
Mit gebogenem Steigrohr und abnehmbarer Spritzdüse.

121
29
°C
Best.-Nr. VE CHFCHF 230 133 55 210 120 45 C849.1 1 Stück 69,55 55,60 315 215 65 295 195 55 C850.1 1 Stück 105,00 83,95
Volumen (ml) Ø (mm) Best.-Nr. VE CHFCHF 50 35 Y767.1 1 Stück 3,85 2,85 100 43 Y768.1 1 Stück 3,90 2,90 250 60 Y769.1 1 Stück 4,95 3,70 500 75 Y770.1 1 Stück 5,55 4,10 1.000 95 Y771.1 1 Stück 7,25 5,40 Laborbedarf
PCR-Platten ROTILABO ® 96-well
ROTH SELECTION. Material: PP. Autoklavierbar: Ja.
• Schwarze, alphanumerische Kennzeichnung
• Dünnwandig für optimalen Hitzetransfer zwischen Thermocycler und Probe
• Kavitäten mit erhöhtem Rand zur verbesserten Abdeckung mit PCR-Folien
• Passend zu den meisten gängigen Thermocyclern
• RNase-, DNase- und human-DNA-frei

250
Kühlbox ROTILABO ® PCR
ROTH SELECTION. Material: PP, mit nicht-toxischer Gelfüllung.
Zur Kühlung von wärmeempfindlichen Proben auf dem Labortisch. Geeignet für 0,2 ml PCR-Gefäße, -Platten und -Reaktionsgefäßstreifen.
• Rack ändert ab ca. 7 °C die Farbe
• Empfohlene Lagertemperatur: -20 °C
TemperaturkonstanzAnordnung StellplätzeAnzahl

Schraubgefäße
Sarstedt. Material: PP, Verschluss mit O-Ring-Dichtung aus EPDM. Unsteril. Autoklavierbar: Ja.
• Ohne Graduierung und Beschriftungsfeld
• Mit Rändelung, zum einhändigen Verschrauben in passenden Ständern
• Verschluss anhängend, unverschraubt
• Gemäß IATA-Anforderungen
In-vitro -Diagnostikum nach IVDD.
Freistehend

Konisch
Nicht in der Schweiz erhältlich.
121 °C 121 °C 30
Vol./Well (µl) Cut Corner Farbe Best.-Nr. VE CHFCHF 250 H12 farblos CEL7.1 50 Stück 231,40 173,55
H12 blau CEL8.1 50 Stück 235,30 176,45
250
H12 gelb CEL9.1 50 Stück 235,30 176,45
Stellplätze Länge (mm) Breite (mm) Höhe (mm) Farbumschlag Best.-Nr. VE CHFCHF 4-7 °C (3 h) 8 x 12 96 141 99 44 violett nach pink EX48.1 2 Stück 202,80 162,20 4-7 °C (3 h) 8 x 12 96 141 99 44 grün nach gelb EX49.1 2 Stück 202,80 162,20
Volumen (ml) Ø außen (mm) Höhe (mm) Zentrifugierbarkeit Ausschwingrotor x g Zentrifugierbarkeit Festwinkelrotor x g Best.-Nr. VE CHFCHF 2 10,8 44 20.000 20.000 HPX5.1 500 Stück 84,50 67,60
Volumen (ml) Ø außen (mm) Höhe (mm) Zentrifugierbarkeit Ausschwingrotor x g Zentrifugierbarkeit Festwinkelrotor x g Best.-Nr. VE CHFCHF 1,5 10,8 44 20.000 20.000 HPX3.1 500 Stück 79,60 63,60 2 10,8 44 20.000 20.000 HPX4.1 500 Stück 84,50 67,60
Laborbedarf

Reaktionsgefäßständer Recycling
ROTH SELECTION. Material: Kunststoff (recycelt), Farbabweichungen möglich.
Anzahl Stellplätze
• Doppelseitig, Stellplätze alphanumerisch gekennzeichnet
• Bohrungs-Ø 10,5 mm für Reaktionsgefäße 1,5/2 ml
• Bohrungs-Ø 7,5 mm für Reaktionsgefäße 0,5 ml
• Große Abstände zwischen Bohrungen für komfortables Öffnen von Schraubgefäßen
• Temperaturbeständigkeit -80 bis +50 °C
31
ROTH
L x B x H (mm) Best.-Nr. VE CHFCHF 48 215 x 6 9 x 27 EEC5.1 5 Stück 44,85 31,40 96 215 x 130 x 27 EEC6.1 5 Stück 98,15 68,70 Laborbedarf
Mikrotiterplatten 6-well
Boettger. Material: PS. Unsteril.
Für alle bakteriologischen Arbeiten, welche eine Mehrfachunterteilung der Kulturschale erfordern. Einfache und platzsparende Alternative zu sechs herkömmlichen 35-mm-Petrischalen.
• Hergestellt unter keimarmen Bedingungen
• Vertiefungen alphanumerisch gekennzeichnet, Well-Ø 35 mm
• Max. Volumen 15 ml pro Well
• Zentrifugierbar bis 4500 x g
• Temperaturbeständig von -20 bis ca. +60 °C
Lieferung inkl. Deckel.
Spatel-Set
ROTH SELECTION. Material: Edelstahl 18/10 (Instrumente), Etui aus Kunststoff.
Instrumente autoklavierbar, Etui nicht autoklavierbar.
Inhalt:
Mikrolöffel, L 150 mm, Löffelbreite 5 mm
Mikro-Löffelspatel L 150 mm, Löffelbreite 7 mm
Mikro-Doppelspatel, L 150 mm, Blattbreite 4 mm
Doppelspatel, L 150 mm, Blattbreite 9 mm
Doppelspatel gebogen, L 150 mm, Blattbreite 4 mm
Doppelspatel gebogen, L 150 mm, Blattbreite 9 mm
Pinzette, gerade stumpf (anatomisch), L 145 mm
Kein Medizinprodukt/Kein ivD-Produkt.
Länge (mm)
Pipettierball ROTILABO ®
Carl ROTH. Material: Naturkautschuk.
Öffnen der Glaskugelventile durch leichtes Zusammendrücken an bezeichneter Stelle.
S tandardmodell
Länge: 125 mm, Gewicht: 50 g.
Ausführung Passend für Best.-Nr. VE CHFCHF manuell Voll-/Messpipetten bis 10 ml 0251.1 1 Stück 11,60 9,20
Universalmodell
Passend zu Pipetten-Ø bis 9 mm. Länge: 152 mm, Gewicht: 58 g.
Ausführung Passend für Best.-Nr. VE CHFCHF manuell Voll-/Messpipetten



32
Wells Vol./Well (ml) Farbe Sterilität L x B x H (mm) Verp. Best.-Nr. VE CHFCHF 6 2-5 transparent Unsteril 128 x 8 5 x 1550 x 2 ATC0.1 100 Stück 221,00 154,70
Breite (mm) Best.-Nr. VE CHFCHF 150 90 E286.1 1 Stück 67,95 50,90
100 ml PC78.1
Stück 10,35
Laborbedarf
bis
1
8,25

Hebebühne ROTILABO ® Mini
Usbeck. Material: Edelstahl, Scherengitter aus Aluminium.
Gummifüsse für rutschfesten Stand.
33
x B
Höhenverstellbarkeit (mm) Betriebslast (kg) Statische Last (kg) Normen Best.-Nr. VE CHFCHF 75 x 8 0 49–147 2 15 DIN 12897 YT68.1 1 Stück 184,75 147,75 Laborbedarf
L
(mm)

Einweg-Overall aus PP-Vlies
WIROS. Material: PP Vlies.
• Hautsympathisch und atmungsaktiv
• Mit Kapuze und Reißverschluß
• Elastische Bänder an Arm- und Bein-Abschluss
• Einzeln hygienisch verpackt
• 30 g/m2
Geeignet für Labor- und Reinigungsarbeiten in schmutzigen Umgebungen oder als Hygieneprävention für Pflegefachleute oder in der Lebensmittelherstellung.
Größe Farbe Länge (cm) Verp. Best.-Nr. VE
weiß 188 einzeln 1N2Y.1 10 Stück 32,90 24,60



Kälteschutzschürze Tempshield. Material: Nylon, Futter aus Polyolefin/Polyester.
Gem. EN ISO 13688 (Allgemeine Anforderungen an Schutzkleidung), EN 388, EN 511. Aus wasserabstoßendem Nylonstoff mit Polyolefin-/ Polyesterfutter. Für Arbeiten im Tiefkühlbereich.
• Schutz vor cryogenen Spritzern bis -196 °C
• Schutz vor Kontaktkälte bis -150 °C
• Leicht und bequem
• Sehr gute Passform durch längenverstellbare Bänder
• Leichtgängige Schnappverschlüsse für schnelles Aus- und Anziehen
Cryo-Apron Wasserabweisende Oberfläche. Farbe

Hautschutz HERWESAN UV 50 SPRAY HERWE.
Hoch wirksames UV-Schutzspray für die OUTDOOR-Anwendung.
• Wasserfest, transparent, nicht fettend
• Hoher UV-B-Lichtschutzfaktor 50, ausgewogener UV-A-Schutz
• Schützt gegen UV-A und UV-B-Strahlung (LSF 50 )
• Sehr leichte, gut einziehende Formulierung, daher auch bestens großflächig und auf behaarten Körperpartien anwendbar
• Versorgt die Haut mit Panthenol und Vitamin E
• Vorteihafte Überkopfpumpe für die komfortable Ganzkörperanwendung (z. B. auch Rücken, Beine)
• Leicht parfümiert, silikonfrei


Anwendungen: Umgang und Tragen von cryogenen Flüssigkeiten und Proben, Entnahme aus Vorratsgefäßen. Arbeiten mit Trockeneis (-79 °C).
Achtung: Nicht in cryogene Flüssigkeiten eintauchen!
Cryo-Industrial Apron Speziell für den Einsatz in der Industrie. Höhere Reißfestigkeit. Mehr Sicherheit durch 100 % wasserdichte und robuste Außenschicht.
TIP
I
Cat.
34
TIP Cat. III /
CHFCHF
167
1N2N.1
Stück 32,90 24,60
M weiß
einzeln
10
171
1N2P.1 10 Stück 32,90 24,60 XL weiß 178 einzeln 1N2T.1 10 Stück 32,90 24,60 XXL
183 einzeln
10 Stück 32,90 24,60
L weiß
einzeln
weiß
1N2X.1
XXXL
Verp. Best.-Nr. VE CHFCHF 200 ml Sprühflasche KAL7.1 1 Stück 34,65 27,65
Breite (cm) Länge (cm) Best.-Nr. VE CHFCHF blau 61 91 0525.1 1 Stück 330,20 280,65 blau 61 107 0526.1 1 Stück 347,10 295,00 blau 61 122 240P.1 1 Stück 399,10 339,20 blau 61 138 240N.1 1 Stück 484,90 412,15 pink 61 91 240L.1 1 Stück 330,20 280,65 pink 61 107 240K.1 1 Stück 365,30 310,50
Farbe Breite (cm) Länge (cm) Best.-Nr. VE CHFCHF dunkelblau 61 107 240E.1 1 Stück 510,90 434,25 dunkelblau 61 138 240H.1 1 Stück 650,00 552,50 Laborbedarf


Schutzbrille i-5
UVEX.
Gem. EN 166, EN 170 und EN 172 (graue Scheibe).
• Scheiben aus Polycarbonat - innen beschlagfrei, außen kratzfest, chemikalienbeständig
• Weiche und flexible Nasenauflage für maximale Komfort und rutschfesten Halt
• Verbesserte Scheibenkonstruktion für mehr Seitenschutz und Schutz vor umherfliegenden Partikeln, Staub und Schmutz
• 3-Stufen Inklination und Bügellängenverstellung emöglichen eine einfache Anpassung an jede Kopfform
Farbe Scheibe Farbe Gestell Scheibenausführung
farblos anthrazit, blauklar, UV-Schutz, kratzfest, chemikalienfest, beschlagfrei
grau anthrazit, lime getönt, UV-Schutz, kratzfest, chemikalienfest, beschlagfrei

Überbrille super f OTG
UVEX.
Gem. EN 166, EN 170 und EN 172 (graue Scheibe). Leichte Überbrille mit sehr guter Augenraumabdeckung.
• Kratz- und chemikalienfeste Scheibe aus Polycarbonat
• Passt über die meisten Korrektionsbrillen
• Scharnierlose Bügel
• Flexible, weiche Bügelenden
(2) grau schwarz, weiß getönt, UV-Schutz, kratzfest, chemikalienfest
CBR65
Die Tönung der CBR65 (Contrast-Blue-Relax-65) Version wirkt kontrastverstärkend, reduziert Blaulicht und sorgt für entspanntes Sehen. Lichttransmission 65 %.
35
Hersteller-Nr. Best.-Nr.
CHFCHF
9183265 1CY4.1 1 Stück 26,95 20,15
9183281 1CY5.1 1 Stück 29,00 21,70
VE
Farbe Gestell Scheibenausführung Hersteller-Nr. Best.-Nr. VE CHFCHF
9169585 1E1N.1 1 Stück 28,80 21,55
9169586 1E1T.1 1 Stück 28,30 21,15
Farbe Scheibe Farbe Gestell Scheibenausführung Hersteller-Nr. Best.-Nr. VE CHFCHF
beschlagfrei 9169164 1E1L.1 1 Stück 30,55 22,85
Bild Farbe Scheibe
(1) farblos schwarz, weiß klar, UV-Schutz, kratzfest, chemikalienfest
Bild
(3) braun schwarz, weiß getönt, UV-Schutz, kratzfest, chemikalienfest,
Laborbedarf

Kanülensammler KONTAMED-chen Söhngen. Material: PP.
Gem. BGR 250/TRBA 250: Biologische Arbeitsstoffe im Gesundheitswesen und in der Wohlfahrtspflege. Mit Verschlussdeckel und einem Abziehschlitz für Kanülen/Spritzen. Für unterwegs, passt in alle Arzttaschen und Notfallkoffer oder in die Kitteltasche. Verstärktes Bodenteil verhindert das Durchstechen von Kanülen.

Entsorgungsbeutel-Drahtständer Epoxygrid
Bel-Art Products. Material: Edelstahl, Epoxid. Autoklavierbar: Ja.
Stabiler Drahtständer für Abfall- und Entsorgungsbeutel. Weite Öffnung für die leichte Entsorgung von Abfall. Ein separater oberer Hakenring hält den Beutel sicher an Ort und Stelle. Der mit Epoxidharz beschichtete Stahldraht ist chemikalien- und korrosionsbeständig, unempfindlich gegenüber vielen organischen Lösungsmitteln, Salzen, schwachen Säuren und schwachen Laugen. Temperaturbeständig von -223 °C (-369 °F) bis 121 °C (250 °F).
Lieferung ohne Entsorgungsbeutel.
Typ Passend fürØ x H (mm) Best.-Nr. VE CHFCHF

Staubhaftmatten SEKUROKA® Carl ROTH.
Mehrlagige, blaue Folienmatten zur Säuberung der Schuhsohlen vor Reinbereichen in der Medizin, Industrie, Lebensmittelverarbeitung, Elektronik etc.
Selbsthaftende Unterseite hält die Matte am Platz. Gebrauchte Folien werden hygienisch und schnell entfernt. Matte enthält 30 selbsthaftende, abtrennbare, durchnummerierte Folien.
VE CHFCHF

Chemikalien-Etikett SEKUROKA®
Carl ROTH. Material: PVC.
Für Spritzflaschen und Standflaschen für den Handgebrauch. Mit Substanzname und Gefahrensymbolen.
Dreisprachig: deutsch, englisch, französisch.
Ausführung L x B (mm) Best.-Nr. VE CHFCHF
121 °C / 36
Ø
Farbe Best.-Nr. VE CHFCHF 180 50 x 115 gelb HA52.1 10 Stück 26,35 21,05
Volumen (ml)
x H (mm)
Best.-Nr.
45 x 9 0 NK53.1 10 Stück 152,10 114,05 60 x 9 0 NK54.1 10 Stück 167,70 125,75 66 x 114 NK55.1 10 Stück 202,80 152,10
B x L (cm)
Small Beutel: 300 x 610 mm185 x 520 241T.1 1 Stück 208,00 166,40 Medium Beutel: 610 x 760 mm370 x 6 00 241X.1 1 Stück 219,70 175,75 Large Beutel: 610 x 910 mm370 x 750 241Y.1 1 Stück 227,50 182,00
Aceton 105 x 75 8416.1 10 Stück 19,15 13,30 Ethanol 105 x 75 8419.1 10 Stück 19,15 13,30 Destilliertes Wasser 105 x 75 8420.1 10 Stück 19,15 13,30 Isopropanol 105 x 75 8430.1 10 Stück 19,15 13,30 Laborbedarf




Chemikalien-Schutzhandschuhe Butoject ® 897 KCL by Honeywell. Material: Butylkautschuk.
Gem. EN 420, EN 388 (2000X) und EN ISO 374-1/Typ A (ABCIKL), EN ISO 374-5 (Virus). AQL 0,65. Ein hochflexibler, extrem schützender Chemikalienschutzhandschuh geeignet für Arbeiten mit Ester und Ketonen u.a. Chemikalien. Besonders für den Einsatz im Laborbereich geeignet. Mit Rollrand, innen gepudert. Wandstärke 0,3 mm.
• Erhöhte Griffigkeit bei nassen Teilen durch besondere Oberflächenaufrauhung
• Enganliegende Form, dadurch auch für Feinarbeiten geeignet oder als Unterziehhandschuh
• Sehr gute mechanische Beständigkeit und Gasdichtigkeit
• Sehr gute Flexibilität bei Kälte und gute Ozonbeständigkeit
Länge (mm) Größe Farbe Best.-Nr. VE


Hitzeschutzhandschuhe RGE 6811 CRYSTAL S REINFORCED Honeywell Safety. Material: Baumwolle.
Gem. EN 420, EN 388 (1222) und EN 407 (X1XXXX). Angerauter Baumwollköper außen und innen. Gerade angesetzter Daumen, Tuchstulpe (Länge 6 cm).
• Komfortabel durch schweißaufnehmendes Baumwollfutter
• Angerautes Material verbessert die thermische Isolierung und Griffigkeit
• Sehr strapazierfähig durch den verstärkten Handrücken
• Schutz vor Kontakthitze bis +100 °C in trockener Arbeitsumgebung

Länge (mm) Größe Farbe
TIP Cat. III
37
TIP Cat. II /
CHFCHF 350 7 schwarz AXN0.1 1 Paar 71,80 57,40 350 8 schwarz AXN1.1 1 Paar 71,80 57,40 350 9 schwarz AXN2.1 1 Paar 71,80 57,40 350 10 schwarz AXN3.1 1 Paar 71,80 57,40 350 11 schwarz AXN4.1 1 Paar 71,80 57,40
Best.-Nr.
CHFCHF 270 9 natur 23EK.1 6 Paar 78,00 62,40 Laborbedarf
VE

Gesichtsschutz Bionic Honeywell Safety.
Gem. EN 166, EN 170
• Großes Visier für gute Sicht
• Polycarbonatscheibe gewährt UV-Schutz und gute Farberkennung
• Kratzfest und beschlagfrei
• Schutz vor Flüssigkeitsspritzern
• Schutz vor umherfliegenden Partikeln mittlerer Energie (120 m/s), getestet bei extrem hohen Temperaturen
• Scheiben sehr leicht auswechselbar
• Individuell einstellbar für guten Sitz
• Ratschen-Kopfhalterung
• Rahmen aus robustem ABS-Kunststoff
• Weiche Polsterung aller Teile, die mit dem Kopf in Berührung kommen
• Hautsympathisches Schweißband, auswechselbar und waschbar
• Erweiterter Schutz für Oberkopf und Kinn
• Kombinierbar mit Atemschutz oder Schutzbrillen
• Sehr leicht, Gewicht 407 g
• Abmessungen: H 31 x B 24 cm
Scheibenausführung Best.-Nr. VE
klar, UV-Schutz, kratzfest, beschlagfrei

Partikelfilter 3M™ 3M.
Gem. EN 143 (Partikelfilter). Die runde Form ermöglicht eine einfachere Montage, da die Filter in jeder Position mit Bajonettverschlüssen angebracht werden können. Die Atemwiderstände wurden um bis 30 % reduziert, dadurch ist ein längeres ermüdungsfreies Arbeiten möglich. Passend zu den Atemschutzmasken von 3M: L167.1ff/N168.1ff/PT45.1f/ N182.1/HLL0.1ff.
Atemschutz-Halbmaske
3M.

Gem. EN 140. Leicht, robust und komfortabel. Starke, stabile Maskenkörper mit einer festen, aber weichen Gesichtsabdichtung.
• Gesichtsabdichtung aus elastischem Silikon bietet einen optimalen & bequemen Dichtsitz
• Strapazierfähige und einstellbare Kopfbebänderung gewährleistet eine optimale Passform und einen hohen Tragekomfort
• 3M™ Cool Flow™-Ausatemventil reduziert den Atemwiderstand und sorgt für einfaches Atmen
• Das flache und kompakte Design ermöglicht ein weites Sichtfeld und erleichtert die Reinigung der glatten Oberfläche
• Die Gestaltung des Atemventils leitet Hitze und Feuchtigkeit nach unten ab und mindert das Beschlagen der Schutzbrille
• Bajonett Klick System, kompatibel mit 3M-Atemschutzfilter für vielfältige Einsatzbereiche
• Bebänderung und das Ausatemventil sind als Ersatzteile auf Anfrage erhältlich
Lieferung ohne Filter, passende Filter: L170.1ff, L177.1, HLK8.1, HHY2.1ff und TE83.1ff bitte separat bestellen.
Serie 6500QL
Mit „Quick Release“ Mechanismus ermöglicht ein schnelles und einfaches Absetzen der Maske bei kurzen Arbeitspausen.
Größe Hersteller-Nr.
Technische Daten:
Best.-Nr. L177.1 L179.1L178.1 L180.1
Schutzstufe P2 R P3 RP2 R mit AktivkohleP3 R mit Aktivkohle
feste und flüssige
Zum Schutz gegen
Partikel gesundheitsschädlicher Stoffe bis zum 10-fachen (bei Halbmasken) / 15-fachen (bei Vollmasken) des Grenzwertes
Normen EN 143
feste und flüssige
Partikel giftiger und sehr giftiger Stoffe bis zum 30-fachen (bei Halbmasken) / 200-fachen (bei Vollmasken) des Grenzwertes
Partikel gesundheitsschädlicher Stoffe bis zum 10-fachen (bei Halbmasken) / 15-fachen (bei Vollmasken) des Grenzwertes, mit zusätzlichem Schutz gegen org. und saure Gase und Dämpfe sowie Ozon unterhalb des Grenzwertes
Partikel giftiger und sehr giftiger Stoffe bis zum 30-fachen (bei Halbmasken) / 200-fachen (bei Vollmasken) des Grenzwertes, mit zusätzlichem Schutz gegen org. und saure Gase und Dämpfe unterhalb des Grenzwert sowie Ozon bis zum 10-fachen des Grenzwertes
Brillenreiniger Anti-Beschlag Univet. Best.-Nr.
Lösung zum Reinigen von Brillen und Visieren, verhindert das Beschlagen. Inhalt: 17 ml.

38
CHFCHF
CA34.1 1 Stück 113,30 90,60
VE CHFCHF CNH5.1 1 Stück 21,80 17,40
Best.-Nr. VE CHFCHF S 6501QL HLL3.1 1 Stück 52,50 44,50 M 6502QL HLL4.1 1 Stück 52,50 44,50 L 6503QL HLL5.1 1 Stück 52,50 44,50
Schutzstufe Hersteller-Nr. Verp. Best.-Nr. VE CHFCHF P2 R 2125 10 x 2 L177.1 20 Stück 122,30 103,85 P2 R mit Aktivkohle 2128 10 x 2 L178.1 20 Stück 143,60 122,00 P3 R 2135 10 x 2 L179.1 20 Stück 150,80 128,15 P3 R mit Aktivkohle 2138 10 x 2 L180.1 20 Stück 181,65 154,35 Laborbedarf

Entsorgungsbeutel Biohazard Bench-Top Kit
Bel-Art Products. Autoklavierbar: Ja.
Geeignet zum Sammeln von Pipettenspitzen, Mikrozentrifugenröhrchen usw. im täglichen Gebrauch. Für Labortische, Abzüge und Untersuchungszimmer.
• Entsorgungsbeutel: aus PE, Wandstärke 18 µm, Farbe rot. Gem. ASTMD 1922 (Weiterreißfestigkeit) und ASTMD 1709 (Durchstoßfestigkeit). Mit aufgedrucktem „Biohazard“ Warnsymbol und Sterilitätsindikatorfeld.
• Ständer: Epoxidbeschichtetes Edelstahl-Drahtgestell, L 127 x B 85 x H 216 mm
• Deckel: aus PP, L 127 x B 89 x H 16 mm
Lieferung inkl. 100 Entsorgungsbeutel, ein Ständer und Deckel
VE
1 Set
Entsorgungsbeutel SEKUROKA® Biohazard
Carl ROTH. Material: PE. Autoklavierbar: Ja.
Zur Aufnahme und Entsorgung von kontaminierten Kleinabfällen wie Pipettenspitzen, Reaktionsgefäße und Probenfläschchen gleich am Arbeitsplatz.
Farbe rot zur leichten Erkennung und Identifizierung.
Mit BIOHAZARD-Kennzeichnung und Indikatorfeld, Farbänderung zeigt abgeschlossenen Autoklaviervorgang an. Beutel während des Autoklaviervorganges offen lassen. Sicherheitsaufdruck in Deutsch, Englisch, Französisch und Spanisch. Passend für SEKUROKA® -Tischständer H508.1.

121 °C 121 °C 39
Best.-Nr.
CHFCHF 25EL.1
133,85 100,35
Verp. Best.-Nr. VE CHFCHF rot 210 x 290 20 10 x 100 Stück EPY0.1 1.000 Stück 208,00 156,00 Laborbedarf
Farbe B x L (mm) Wandstärke (µm)
Einmalhandschuhe Touch N Tuff ® Ansell. Material: Nitrilkautschuk.
Gem. EN 420, EN ISO 374-1/Typ B (JKPT) und EN ISO 374-5 (Virus). AQL 1,5. Antistatisch gem. EN 1149-5. Gem. EG 1935/2004 – für den Kontakt mit Lebensmitteln geeignet.
• Silikonfrei
• Beidhändig verwendbar
• Mit Rollrand
• Farbe: grün
• Wandstärke: 0,12 mm
• 100 Stück pro Dispenserbox
Bietet optimalen Schutz gegen Spritzer von Chemikalien.
92-600 puderfrei, Länge 240 mm Unsteril. Glatte Oberfläche, Lebensmittelgeeignet.
Größe Länge
(7,5–8)

92-605 puderfrei, Länge 300 mm Unsteril. Gem. EN 421. Fingerspitzen strukturiert, Lebensmittelgeeignet.
Größe Länge (mm)
(mm) Farbe Best.-Nr. VE CHF CHF
≥240 grün K966.1 100 Stück 47,30 35,40 M
≥240 grün K967.1 100 Stück 47,30 35,40
≥240 grün K968.1 100 Stück 47,30 35,40 XL (9,5–10) ≥240 grün K969.1 100 Stück 47,30 35,40
10
33,00 / Box
S (6,5–7)
L (8,5–9)
Ab
Boxen pro Größe
Farbe Best.-Nr. VE CHF CHF S (6,5–7) 300 grün PA90.1 100 Stück 44,95 33,65 M (7,5–8) 300 grün PA91.1 100 Stück 44,95 33,65 L (8,5–9) 300 grün PA92.1 100 Stück 44,95 33,65 XL (9,5–10) 300 grün PA93.1 100 Stück 44,95 33,65 Ab 10 Boxen pro Größe 31,40 / Box
061 / 712 11 60 · info@carlroth.ch Laborbedarf
Bestellungen:
TOP-Angebote Life Science

























Elektrophorese-Komplettsystem ROTIPHORESE ® PROfessional runVIEW
ROTH SELECTION.
Komplettsystem für die real-time -Elektrophorese: Kammer, Power Supply und Illuminator in Kombination
Geeignet für:
• Optimal für schnelle Labor-Analysen, Gelelutionen und alle Kontrollgele
• Direktansicht der wandernden Banden im Blaulicht – ohne mutagene oder netzhautschädigende Effekte
• Passendes Zubehör ist das runDOC Geldokumentationssystem (Best.‑Nr. 1315.1)






• Empfohlen für SYBR ® Green, ROTI ® GelStain (grün) und ROTI ® GelStain Red Eco (rot), außerdem verwendbar mit Ethidiumbromid und den gängigen Ersatzfarbstoffen wie SYBR ® Green
Lieferung inkl. 1 ROTIPHORESE ®PROfessional runVIEW Basis (Basisstation mit integriertem Blaulicht und Power Supply, auch einzeln erhältlich unter Best.‑Nr. 4850.1), 1 horizontale Gelkammer ROTIPHORESE ®PROfessional III (auch einzeln erhältlich unter Best.‑Nr. 2850.1), 1 Spezialdeckel für Blaulicht (auch einzeln erhältlich unter Best.‑Nr. 3077.1) mit integriertem Spektralemissions filter für grüne und rote Fluoreszenz und Elektrophoresekabeln (4 mm Stecker), 1 UV transparente Geltrageschale (15 x 15 cm) mit 2 Gelgießsperren, 8 doppelseitige Kämme, kompatibel mit Mehrkanalpipetten: 2 x 4/16 Proben und 4 x 20/28 Proben (jeweils 1 mm), 1 x 4/16 Proben und 1 x 20/28 Proben (jeweils 3 mm).
Typ
ROTH AG · Fabrikmattenweg 12 · 4144 Arlesheim
Bestellungen: 061 / 712 11 60 · Faxbestellungen: 061 / 712 20 21 · E-Mail-Bestellungen: info@carlroth.ch · Roth im Internet: www.carlroth.ch www.carlroth.com/ch/de/Kaufmaennische-Beratung-Aussendienst Netto-Preise in CHF zzgl. MwSt. Bei
























Best.-Nr.
CHF CHF
PROfessional runview 4849.1 1 Stück 2.895,10 2.316,05
VE
Komplettsystem
200,–
sparen Sie die Versandkostenpauschale von 15,– CHF.
die allgemeinen Geschäfts-
Lieferbedingungen der Roth AG, Arlesheim CH-DE
Aufträgen über
CHF
Es gelten
und
Gültig
von 3. Juni bis 31. Juli 2024
Zellkultur

Zellkulturmedien
• Steril und ready-to-use
• Versand bei Umgebungstemperatur
• Alle Produkte in CELLPURE® -Qualität –geprüft auf Endotoxine
Medien mit stabilem Glutamin* können bei Raumtemperatur gelagert werden.
*Sofern keine weiteren temperatursensitiven Zusätze vorhanden sind. Sicherheitsrelevante Daten und zusätzliche Informationen im aktuellen Katalog oder unter www.carlroth.ch
▶ Weitere Zellkulturmedien finden Sie unter www.carlroth.ch

Produktname
ROTI ® Cell MEM-AA-Lösung 50x konz., steril, ohne Glutamin Für die Zellkultur
ROTI ® Cell MEM-NEAA- Lösung 100x konz., 10 mM (jeweils), steril Für die Zellkultur
ROTI ® Cell Glutamin-Lösung 200 mM, steril, stabil Für die Zellkultur
ROTI ® Cell HEPES-Lösung 1 M, steril Für die Zellkultur
ROTI ® Cell Pyruvat-Lösung 100 mM, steril Für die Zellkultur
Zellkulturmedienzusätze
• Steril und ready-to-use
• Alle Produkte in CELLPURE® -Qualität –geprüft auf Endotoxine
Lösung in Wasser.
Verdünnung 1:50 in Zellkulturmedium. Endkonzentration pro Aminos äure entspricht EMEM.
Lösung in Wasser. Verdünnung 1:100 in Zellkulturmedium. Endkonzentration pro Aminosäure 0,1 mM.
Lösung in für die Zellkultur geeignetem Wasser.
Die empfohlene Endkonzentration im Medium liegt, wie auch im Falle des normalen L Glutamins, zwischen 292 mg/l (2 mM) und 585 mg/l (4 mM).
Lösung in für die Zellkultur geeignetem Wasser.
Empfohlene Endkonzentration 25 mM.
Lösung in für die Zellkultur geeignetem Wasser.
Empfohlene Endkonzentration 1 mM, in Spezialmedien bis zu 5 mM.
*Keine Medizinprodukte / keine ivD Produkte. Sicherheitsrelevante Daten und zusätzliche Informationen im aktuellen Katalog oder unter www.carlroth.ch
2
Glucose g/l Glutamin (mM) HEPES (mM) Natriumpyruvat (mM) NaHCO 3 (mM) Phenolrot Salze Best.-Nr. VE CHF CHF ROTI ® Cell DMEM : F12 3,151 2,5 15 0,5 14,3 ja X 1YTP.1 500 ml 25,90 20,65 ROTI ® Cell DMEM High Glucose 4,5 4 X 1 44 ja X 9005.1 500 ml 20,15 16,10 4,5 4 stab. X 1 44 ja X 9007.1 500 ml 24,05 19,20 4,5 X X X 44 X X 1TE8.1 500 ml 19,40 15,45 4,5 4 stab. 25 X 44 ja X 1TE9.1 500 ml 23,30 18,55 ROTI ® Cell DMEM Low Glucose 1,0 X X 1 44 ja X 9027.1 500 ml 20,15 16,10 ROTI ® Cell Eagle’s MEM-Alpha 1 X X 1 26,2 ja Earle’s 9058.1 500 ml 29,80 23,75 ROTI ® Cell Eagle’s MEM / Earle’s 1 2 X X 26,2 ja Earle’s 9044.1 500 ml 20,15 16,10 ROTI ® Cell Ham’s F12 1,8 1 X 1 14 ja X 9108.1 500 ml 35,75 25,00 ROTI ® Cell Iscoveʹs MDM 4,5 4 25 1 36 ja X 9033.1 500 ml 31,85 25,45 ROTI ® Cell McCoy’s 5A 3 1,5 X X 26,2 ja X 9111.1 500 ml 43,55 34,80 ROTI ® Cell RPMI 1640 2 2 X X 23,8 ja X 9085.1 500 ml 20,15 16,10 2 2 25 X 23,8 ja X 9086.1 500 ml 22,75 18,20 2 2 stab. X X 23,8 ja X 9091.1 500 ml 22,75 18,20
Produktname
S
Reinheit Allgemeine Verwendung Verwendungshinweis Best.-Nr. VE CHF CHF
0647.1 100 ml 48,00 38,35
9185.1 100 ml 31,10 24,80
9183.1 100 ml 36,30 28,95
9157.1 100 ml 48,75 39,00
9182.1 100 ml 25,90 20,65
S
Life Science TIP
Zellanalyse

ROTITEST ®Vital
S
ROTITEST® BioAnalysis Grade, steril, ready-to-use Kolorimetrische Testlösung zur Bestimmung von Zellproliferation und vitalität. Nicht toxisch

Mechanismus
Die Sensitivität des verwendeten Formazansalzes ist höher als die von üblichen Standardreagenzien wie MTT, XTT, MTS oder WST 1
Die Testresultate zeigen eine hochstringente Korrelation mit [3H]Thymidin-Inkorporations-Assays und repräsentieren damit sowohl die Vitalität der Zellen als auch den Proliferationsstatus (Tominaga et al., Anal. Commun. 1999 (36) 47 50).
In allen lebenden Zellen werden durch die Atmungskette NADH und NADPH gebildet. ROTITEST®Vital basiert auf dem (farblosen) WST-8, das als Akzeptor für die NADH/NADPH Dehydrogenase fungiert und dabei zu (farbigem) Formazan reduziert wird.
Schnelles und einfaches Testsystem zur nicht-radioaktiven Zählung von proliferierenden Zellen und für Zytotoxizitätsanalysen.
Optimaler Ersatz für MTT:
• Zellen bleiben vital
• Einfache Handhabung
• Ein-Komponenten-System ohne Radioaktivität
• Für adhärente und Suspensionszellen
• Photometrisches Testergebnis in 1 bis 4 Stunden
• Strenge Korrelation zwischen Absorption und Zellzahl
• Geeignet für alle Kulturmedien
Stabil bei Raumtemperatur, sehr stabil unter Kühlung. Lagerung lichtgeschützt. Nicht einfrieren. 1 ml ist ausreichend für 100 Messungen.
Lagertemperatur: +4 °C
ROTITEST ®Annexin V
ROTITEST® BioAnalysis Grade, ready-to-use
Zur Detektion und Zählung apoptotischer bei gleichzeitiger Differenzierung nekrotischer Zellen
Mechanismus
Während der ersten apoptotischen Stadien einer Zelle wird Phosphatidylserin (PS) vom inneren Membranlayer zur äußeren Oberfläche der Zelle transloziert. Der ROTITEST®Annexin V Kit basiert auf der Ca 2+ abhängigen starken Bindung von Annexin V an PS und färbt hierdurch die Zellmembran von Zellen mit gestörter Membran an. Zusätzlich fungiert das Propidiumiodid als Gegenfärbung der Nuklei von Zellen mit offener Membranhülle, also solcher in nekrotischem Abbau. Als Ergebnis können Zellen mit gelb-grüner Membranfärbung eindeutig als apoptotisch identifiziert werden, während doppelt gefärbte Zellen (mit gelb-grüner Membran und orange-rotem Nukleus) als nekrotisch eingestuft werden können. Die Auswertung erfolgt mittels Durchfluss zytometrie oder fluoreszenzmikroskopischer Analyse.
• Einfache, schnelle Anwendung
• Für adhärente und Suspensionszellen
• Für kultivierte und primäre Zellen (auch Hefezellen)
• Unterscheidet apoptotische und nekrotische Zellen
• Testergebnis in ca. 30 Minuten
Im Kit enthalten:
Annexin V FITC Konjugat, Propidiumiodid Lösung, Annexin Bindungspuffer, detaillierte Anleitung.
Die Einzelbestandteile dieses Kits können nicht separat nachgekauft werden.
Lagerung lichtgeschützt. Nicht einfrieren.
1 Set ist ausreichend zur Analyse von 50 Proben zu je 105 Zellen.
Lagertemperatur: +4 °C
Best.-Nr. Abpackung VE Verp. CHF CHF 7735.1 ca. 50 Assays 1 Kit Karton 323,70 258,95
▶ EdU Click Proliferationskits von baseclick finden Sie in unserem aktuellen Katalog oder unter www.carlroth.ch

3
Best.-Nr. Abpackung VE Verp. CHF CHF 0069.3 1 x 1 ml 1 ml Kunst. 97,40 77,85 0069.1 1 x 5 ml 5 ml Kunst. 271,70 217,35 0069.2 4 x 5 ml 20 ml Kunst. 812,50 650,00
Life Science
Grundstoffe für mikrobiologische Nährmedien
Agar-Agar
Produktname Reinheit
Agar-Agar, bakteriologisch hochrein, für die Bakteriologie Kunst.
Agar-Agar, Noble Qualität ultrarein, für die Bakteriologie Kunst.
Agar-Agar, BioScience BioScience Grade, pulv. Kunst.
Agar-Agar, BioScience, granuliert BioScience Grade, granuliert Kunst.
Agar-Agar, Kobe I Kobe I, pulv., für die Mikrobiologie Kunst.
Extrakte
Produktname Reinheit
Hefeextrakt, mikro gr anuliert mikro-granuliert, für die Bakteriologie Kunst.
Hefeextrakt pulv., für die Bakteriologie Kunst.
Malzextrakt, standard pulv., für Nährböden Kunst.
Peptone
Produktname Reinheit
Pepton aus Casein tryptisch verdaut, für die Mikrobiologie Kunst.
Pepton aus Soja papainisch verdaut, für die Mikrobiologie Kunst.
Trypton/Pepton aus Casein pankreatisch verdaut, für die Mikrobiologie Kunst.
Trypton/Pepton aus Casein, granuliert pankreatisch verdaut, granuliert, für die Mikrobiologie
Sicherheitsrelevante



Kunst.
4
Verp. Best.-Nr. VE CHF CHF
2266.1 250 g 170,95 136,75 2266.3 500 g 292,50 234,00 2266.2 1 kg 531,70 425,35 2266.4 2,5 kg 1.116,70 893,35
3558.1 250 g 224,25 179,40 3558.2 500 g 383,50 306,80 3558.3 1 kg 661,70 529,35 3558.4 2,5 kg 1.298,70 1.038,95
6494.1 250 g 107,80 86,15 6494.2 500 g 193,70 154,95 6494.3 1 kg 362,70 290,15 6494.4 2,5 kg 804,70 643,75
1347.1 250 g 113,00 90,35 1347.2 500 g 201,50 161,20 1347.3 1 kg 370,50 296,40 1347.4 2,5 kg 804,70 643,75
5210.1 250 g 61,00 45,70 5210.3 500 g 105,95 79,40 5210.2 1 kg 194,35 145,70 5210.4 2,5 kg 409,50 307,10 5210.5 5 kg 700,70 525,50 5210.6 10 kg 1.124,50 843,35
Verp. Best.-Nr. VE CHF CHF Fleischextrakt pulv.,
Nährböden Kunst. X975.1 500 g 206,70 165,35 X975.2 1 kg 362,70 290,15
für
2904.1 250 g 70,85 56,65 2904.2 500 g 128,70 102,95 2904.3 1 kg 240,50 192,40 2904.4 2,5 kg 466,70 373,35 2904.5 5 kg 903,50 722,80
2363.1 250 g 66,95 53,55 2363.3 500 g 122,85 98,25 2363.2 1 kg 232,70 186,15 2363.4 2,5 kg 435,50 348,40 2363.5 5 kg 773,50 618,80 2363.7 10 kg 1.259,70 1.007,75
X976.1 500 g 56,55 45,20 X976.2 1 kg 102,60 82,00
Verp. Best.-Nr. VE CHF CHF
8986.1 500 g 133,25 106,60 8986.2 1 kg 240,50 192,40 8986.3 2,5 kg 518,70 414,95 8986.4 5 kg 921,70 737,35
2365.1 250 g 60,45 45,30 2365.3 500 g 105,20 78,85 2365.2 1 kg 201,50 151,10 2365.4 2,5 kg 383,50 287,60
8952.1 250 g 83,10 66,40 8952.3 500 g 149,50 119,60 8952.2 1 kg 253,50 202,80 8952.4 2,5 kg 557,70 446,15 8952.5 5 kg 973,70 778,95
6681.1 250 g 107,80 86,15 6681.2 500 g 188,50 150,80 6681.3 1 kg 331,50 265,20 6681.4 2,5 kg 661,70 529,35 6681.5 5 kg 1.267,50 1.014,00
Daten und zusätzliche Informationen im aktuellen Katalog oder unter www.carlroth.ch Life Science
Mikrobiologische Trockennährmedien
... als Pulver
• Einfach: sehr gut löslich
• Sicher: staubarmes Granulat minimiert Gesundheitsrisiken
• Sauber: minimiert Arbeitsplatzkontamination
• Homogen: Klumpenbildung und Entmischung der Medienbestandteile minimiert
• Schnell: verbesserte Fließfähigkeit für schnellere Verarbeitung
• Bewährt: gleiche Formulierung wie unsere Pulver Medien, ohne weitere Zusätze


CASO-Agar Zur Isolierung und Kultivierung von anspruchslosen Mikroorganismen Kunst.
CASO-Bouillon Für die Kultivierung von anspruchsvollen und anspruchslosen Mikro organismen
Fraser Halb M edium (Basis) Anreicherungsmedium zur Detektion und Isolierung von Listerien in Lebensmitteln und Umweltproben
Kartoffelextrakt Glucose Agar Zur Kultivierung und Identifizierung von Hefen und Schimmelpilzen
Kristallviolett-Galle-Glucose-Agar Für die Kultivierung und die Bestimmung der Anzahl von Entero bakterien in Wasser, Nahrungsmitteln und anderen Stoffen
Legionella-Agar (Basis) Zur selektiven Kultivierung von Legionella.
Listeria chromogener Agar (Basis)
Selektivmedium zur Detektion und Zählung von Listeria mono cytogenes nach Ottaviani und Agosti
MacConkey-Agar Für die selektive Isolierung und Identifizierung von Enterobakterien aus Abwasser, Lebensmitteln und anderen Proben
NZamin Zusatz von molekularbiologischen Nähr medien, v. a. LB-Medien
Plate-Count-Agar
Kunst.
Für die Bestimmung der Anzahl von aeroben Mikroorganismen in Milch, Nahrungsmitteln und anderen Substanzen
Sicherheitsrelevante Daten und zusätzliche Informationen im aktuellen Katalog oder unter www.carlroth.ch
... als Granulat
• Einfach: sehr gut löslich
• Sicher: staubarmes Granulat minimiert Gesundheitsrisiken
• Sauber: minimiert Arbeitsplatzkontamination
• Homogen: Klumpenbildung und Entmischung der Medienbestandteile minimiert
• Schnell: verbesserte Fließfähigkeit für schnellere Verarbeitung
• Bewährt: gleiche Formulierung wie unsere Pulver Medien, ohne weitere Zusätze

• Vielseitig: geeignet für Umweltanalytik, Kosmetik , Lebensmittel und Wasser Industrie, uvm.
granuliert Ph. Eur., granuliert, für die Mikrobiologie
CASO-Bouillon, granuliert Ph. Eur., granuliert, für die Mikrobiologie
(Basis), granuliert
MacConkey-Agar, granuliert
Peptonwasser, gepuffert, granuliert

granuliert, für die Mikrobiologie
Ph. Eur., granuliert, für die Mikrobiologie
Plate-Count-Agar, granuliert granuliert, für die Mikrobiologie
R2A-Agar, granuliert Ph. Eur., granuliert, für die Mikrobiologie
Standard-Nährmedium I, granuliert granuliert, für die Mikrobiologie
Sicherheitsrelevante Daten und zusätzliche
5
Allgemeine Verwendung Verp. Best.-Nr. VE CHF CHF
Produktname
X937.1 500 g 133,25 106,60 X937.2 1 kg 235,95 188,75 X937.3 2,5 kg 516,75 413,40 X937.7 5 kg 981,50 785,20
Kunst. X938.1 500 g 113,75 91,00 X938.2 1 kg 185,25 148,20 X938.3 2,5 kg 396,50 317,20 X938.7 5 kg 760,50 608,40
Kunst. HP18.1 500 g 159,25 127,40 HP18.2 1 kg 284,70 227,75 HP18.3 2,5 kg 661,70 529,35
X931.1 500 g 159,25 119,40 X931.2 1 kg 284,70 213,50 X931.3 2,5 kg 635,70 476,75
Kunst. X939.1 500 g 126,75 101,40 X939.2 1 kg 227,50 182,00 X939.3 2,5 kg 474,50 379,60
Kunst. CL48.1 500 g 201,50 161,20
Kunst. 3008.1 100 g 103,90 83,05 3008.2 500 g 370,50 296,40
Kunst. X922.3 100 g 44,10 35,20 X922.1 500 g 136,50 109,20 X922.2 1 kg 245,70 196,55
Kunst. CP76.2 250 g 128,70 102,95 CP76.1 500 g 232,70 186,15
Kunst. X930.1 500 g 141,70 113,35 X930.2 1 kg 258,70 206,95 X930.3 2,5 kg 531,70 425,35
Produktname Reinheit Best.-Nr. VE CHF CHF
1506.1 500 g 279,50 223,60
CASO-Agar,
6678.1 500 g 167,70 134,15 6678.2 1 kg 279,50 223,60 Columbia-Agar
1507.1 500 g 310,70 248,55
Ph. Eur.,
1514.1 500 g 227,50 182,00
EN ISO 6579, EN ISO 6887, ISO 11133, ISO 11290, EN ISO 19250, ISO 21528,
Mikrobiologie 6680.1 500 g 136,50 109,20 6680.2 1 kg 240,50 192,40
granuliert, für die
1521.1 500 g 282,75 226,20
1523.1 500 g 349,70 279,75
1533.1 500 g 310,70 248,55
Informationen
im aktuellen Katalog oder unter www.carlroth.ch
Life Science
Größenausschlusschromatographie
Entsalzung und Pufferaustausch von Protein- und Nukleinsäurelösungen mittels ROTI®Dex-Spin
Größenausschluss-Chromatographiesäulen
ROTI ® Dex-Spin
Größenausschluss-Chromatographie, Dextran Epichlorhydrin Copolymer, Gelfiltration
Vorgepackte ROTI ® Dex Spin Säulen für die Größenausschlusschromatographie mittels Zentrifugation, für eine schnelle und effiziente Entfernung unerwünschter niedermolekularer Faktoren, wie Verunreinigungen, Salze, Hilfsstoffe, Marker, Zelltrümmer etc. aus Protein- oder Nukleinsäurelösungen.
Zur Aufbereitung kleiner Probevolumina (optimal 50 µl) in weniger als 5 Minuten.
Die Aufreinigung basiert auf ein kugelförmiges, poröses Gelfiltrationsmedium, das aus mit Epichlorhydrin vernetztem Dextran besteht.
Bei der Größenausschlusschromatographie werden Moleküle nach ihrer Größe in Lösung getrennt. Dabei passieren kleinere Moleküle die Säule deutlich langsamer als größere Moleküle.
Im Gegensatz zu anderen Chromatographiemodi kommen hierbei keinerlei Wechselwirkungen zwischen dem Analyten und der stationären Phase der Säule zum Tragen. Dies bietet die ideale Grundlage für die Aufreinigung und Analyse intakter Proteine.
Vorteile:
• Probenaufbereitung in nur wenigen Minuten
• Entsalzen, Entfernen von Verunreinigungen und Pufferaustausch in einem einzigen Schritt
• Keine Wechselwirkung zwischen Analyt und Medium
• Hohe Selektivität, hohe Auflösung und hohe Ausbeute (> 95%)
• Auch für geringe Probevolumina geeignet
• Hohe chemische Stabilität und damit kompatibel mit vielen organischen und anderen Lösungsmitteln
S /
Größenausschluss-Chromatographiesäulen
ROTI ® Dex-25 Medium Spin
ROTI®Dex
Für die Entsalzung und den Pufferaustausch von Protein und Nukleinsäurelösungen
Das Säulenbett besteht aus ROTI ® Dex 25 Medium (Best. Nr. 21A5), vorgequollen in deionisiertem Wasser.
Geeignet für:
• Oligonukleotide > 10 bp
• Globuläre Proteine > 5 kDa
• Partikel > 2 nm
Für optimale Ergebnisse wird ein Probevolumen von 50 µl empfohlen. Detaillierte Informationen zur Anwendung finden Sie in unserer Technischen Infobroschüre und in unseren Gebrauchsanweisungen
Geeignet für Proteine >5 kDa und Oligonukleotide >10 bp.
Lagertemperatur: +2 bis +25 °C
Ausführung

Größenausschluss-Chromatographiesäulen
ROTI ® Dex-50 Medium Spin
ROTI®Dex
Für die Entsalzung und den Pufferaustausch von Protein und Nukleinsäurelösungen
Das Säulenbett besteht aus ROTI ® Dex 50 Medium (Best. Nr. 21A6), vorgequollen in deionisiertem Wasser.
Geeignet für:
• Oligonukleotide > 20 bp
• Globuläre Proteine > 25 kDa
• Partikel > 4 nm
Für optimale Ergebnisse wird ein Probevolumen von 50 µl empfohlen.
Detaillierte Informationen zur Anwendung finden Sie in unserer Technischen Infobroschüre und in unseren Gebrauchsanweisungen
Geeignet für Proteine >25 kDa und Oligonukleotide >20 bp.
Lagertemperatur: +2 bis +25 °C
6
Best.-Nr. VE CHF CHF ROTI®Dex 25 S pin 21C4.1 25 Stück 271,70 217,35
Ausführung Best.-Nr. VE CHF CHF ROTI®Dex 5 0 S pin 21C5.1 25 Stück 271,70 217,35
S / Life Science
Molekularbiologie · Southern Blot

Semi-Dry-Blotter ROTIPHORESE ® PROfessional Zum Transfer von Proteinen und Nukleinsäuren.
Ausstattung:
• Schneller Transfer mit gleichmäßiger Temperaturverteilung
• Hohe Blotqualität durch Schraubfixierung und langlebige Elektroden
• Minimale Hitzeentwicklung und Pufferverbrauch
Die Semi-Dry-Blotter PROfessional überzeugen durch schnelle Transferzeiten für Proteine wie für Nukleinsäuren bei Gelen von 0,25 bis zu 10 mm Dicke.
Semi-Dry-Blotter ROTIPHORESE ® PROfessional MINI ROTH SELECTION.
Typ
Semi-Dry-Blotter ROTIPHORESE ® PROfessional MAXI ROTH SELECTION. Typ
Nylon-Membran-Zuschnitte
Produktname Abmessung Porengröße Material
ROTI ®Nylon Plus Reprobe
Sicherheitsrelevante Daten und zusätzliche Informationen im aktuellen Katalog oder unter www.carlroth.ch
Reagenzien
Puffer & Zusätze für die Hybridisierung
Produktname
Denhardt ʹs Pulvermischung 50x, BioScience Grade, für die Molekular biologie
Lachssperma-DNA Natriumsalz ex salmon testes
ROTI ® Fair 20x SSC für 1 000 ml/Portionsbeutel, für die Molekular biologie
ROTI ® Fair SSPE für 200 ml/Tablette, für die Molekular biologie
ROTI ®Hybri-Quick BioScience Grade, ready-touse, für die Molekularbiologie
ROTI ® Stock 20x SSC 20x konz., BioScience Grade, ready-to-use,
Blockierungsreagenz für Hybridisierung und Strippen
Konzentrierte Pufferlösung für Southern- und Northern-Transfer
Pufferlösung für die DNA- und RNA-Hybridis ierung.
Hybridisierungspuffer für die DNA- und RNA-Hybridisierung
Sicherheitsrelevante Daten und zusätzliche Informationen im aktuellen Katalog oder unter www.carlroth.ch


7
L x B x H Gerät (cm) Best.-Nr. VE CHF CHF Semi-Dry-Blotter MINI 16.5 x 15 x 5.5 KK58.1 1 Stück 1.157,00 925,60
L x B x H Gerät (cm) Best.-Nr. VE CHF CHF Semi-Dry-Blotter MAXI 26 x 26 x 7 KK59.1 1 Stück 2.334,80 1.867,80
Reinheit Allgemeine Verwendung Best.-Nr. VE CHF CHF
HP33.1 50 ml 139,75 111,80
5434.1 5 g 57,85 46,25 5434.2 10 g 108,55 86,80
1232.1 5 Stück 250,25 200,20
1233.1 100 Stück 165,75 132,60
A981.1 1 l 79,95 63,95 A981.2 2,5 l 146,25 117,00
die Molekularbiologie 1054.1 1 l 103,35 82,65
dampfsterilisiert Für
Best.-Nr. VE CHF CHF Transfermembran ROTI ® Nylon 0.2 20 × 20 cm 0,2 µm Nylon 260N.1 5 Blatt 201,50 161,20 Transfermembran ROTI ® Nylon 0.45 0,45 µm 260X.1 5 Blatt 201,50 161,20 20 × 20 cm
261H.1 5 Blatt 201,50 161,20 0,45
Transfermembran
µm 20 × 20 cm
Life Science
Molekularbiologie · Reagenzien für die PCR
ROTI®Pol DNA-Polymerasen
Für die PCR.
Rekombinante, temperaturstabile DNA-Polymerasen aus den thermophilen Bakterien Thermus aquaticus

Sicherheitsrelevante Daten und zusätzliche Informationen im aktuellen Katalog oder unter www.carlroth.ch Lagertemp.: 20 °C • Transporttemp.: gekühlt

Nukleotide von ROTH
Hochrein · Stabil · Getestet
dNTP Set 1 ≥99 % dATP, dTTP, dGTP, dCTP,
ROTI ® Mix PCR 3 10 mM (/dNTP), 40 mM (gesamt), dATP, dTTP, dGTP, dCTP, ready-to-use
ROTI ® Mix PCR 3 (pH 7) 10 mM (/dNTP), 40 mM (gesamt), dATP, dTTP, dGTP, dCTP, ready-to-use
Sicherheitsrelevante Daten und zusätzliche Informationen im aktuellen Katalog oder unter www.carlroth.ch
S
Wasser
BioScience Grade, DEPC-behandelt, steril, Nuklease-frei, autoklaviert
Für die Molekularbiologie
Jede Charge wird nach Autoklavieren spektral-photometrisch auf optimale Reinheit im Nukleinsäure-relevanten Bereich geprüft.
Best.-Nr. Abpackung
PCR Wasser
Reinstwasser (Typ I), steril, Nuklease-frei, frei von DNA und RNA
Reinstwasser, frei von Nukleasen, DNA und RNA zum Einsatz in empfindlichen molekularbiologischen Anwendungen
Jede Charge wird mittels PCR getestet, um Verunreinigungen durch DNA und Nukleasen auszuschließen.
Best.-Nr. Abpackung VE Verp. CHF
1HPE.1
1HPE.4
1HPE.3
Protease-free RNase-free DNase-free DNA-free S 8
Reinheit Anwendung Amplicon- Enden Best.-Nr. VE CHF CHF ROTI ®Pol TaqS 5 U/μ l Standard-PCR 3 ʹdA 9223.1 100 µl 93,50 65,35 9223.2 500 µl 453,70 317,55 ROTI ® Pol TaqS Mix (2x) 2x konz., ready-to-use Standard-PCR 3 ʹdA 9239.1 2 ml 67,50 53,95 9239.2 10 ml 271,70 217,35 ROTI ® Pol TaqS Red Mix (2x) 2x konz., ready-to-use Standard-PCR mit folgender Gelbeladung 3 ʹdA 9241.1 2 ml 74,00 59,15 9241.2 10 ml 292,50 234,00 ROTI ® Pol Hot TaqS Red Mix (2x) 2x konz., ready-to-use Besonders sequenzspezifische Standard PCR mit folgender Gelbeladung 3 dA 9256.1 2 ml 107,80 86,15 9256.2 10 ml 492,70 394,15 ROTI ®Pol TaqHY 5 U/μ l Schnelle PCR Protokolle und/oder hohe Ausbeute, GC-reiche Template-DNA 3 ʹdA 9345.1 100 µl 107,80 86,15 9345.2 500 µl 492,70 394,15
®Pol Hot-TaqHY 5 U/μ l Besonders sequenzspezifische, schnelle PCR Protokolle und/oder hohe Ausbeute, GC reiche Template-DNA 3 dA 9346.1 40 µl 107,80 86,15 9346.2 200 µl 492,70 394,15
Produktname
ROTI
Reinheit Abpackung Best.-Nr. VE CHF CHF
100 mM per dNTP 4 x 25 µmol (250 µl), 100 mM K039.1 1 Set 159,25 127,40 5 x 4 x 25 µmol (250 µl), 100 mM K039.2 1 Set 643,50 514,80
Produktname
1 x 0.2 ml L785.1 0,2 ml 37,05 29,60 5 x 0,2 ml L785.2 1 ml 149,50 119,60 5 x 1 ml L785.3 5 ml 604,50 483,60
1 x 0,2 ml 0179.1 0,2 ml 37,05 29,60 5 x 0,2 ml 0179.2 1 ml 149,50 119,60
RNase-free DNase-free
VE Verp. CHF CHF
50 x 1 ml in Röhrchen 50 ml Kunst. 154,70 123,75 T143.6 50 x 1 ml in Glasbrechampullen 50 ml Glasamp. 167,70 134,15 T143.5 5 x 20 ml 100 ml Glas 40,95 32,75 T143.1 1 x 250 ml 250 ml Glas 38,90 31,05 T143.2 1 x 500 ml 500 ml Glas 48,75 39,00
1 x 1 l 1 l Glas 66,95 53,55
T143.4
T143.3
CHF
in
15 ml Kunst. 116,90 93,45
in Röhrchen 30 ml Kunst. 227,50 182,00
10 x 1,5 ml
Röhrchen
1HPE.2 20 x 1,5 ml
60 ml 60 ml Kunst. 253,50 202,80
1 x
in
75 ml Kunst. 513,50 410,80
50 x 1,5 ml
Röhrchen
125 ml 125 ml Kunst. 492,70 394,15 Life Science
1HPE.5 1 x
Elektrophorese · PAGE
Q-PAGE™ TGN Fertiggele
SMOBIO.
Fertig gegossene Minigele für die schnelle und einfache Gelelektrophorese in Labor und Praktikum.
Q-PAGE™ TGN Fertiggele mit optimierten Trenn-Eigenschaften.
• Kompatibilität – Gelkassetten in den Größen Mini (10 x 8,3 cm) und Midi (10 x 10 cm), passend für die meisten Mini Gelkammern
• Einfaches Beladen – nummerierte Geltaschen mit Separatoren
• Besonders schnelle Auftrennung – klare, scharfe Banden schon nach 30 40 Minuten
• Besonders lange Haltbarkeit – bis zu 12 Monate ab Herstellung bei 4 °C Lagertemperatur
• Große Anwendungsbreite – erhältlich als konstant konzentrierte Gele und als Gradienten-Gele
• Einfache Überwachung während des Gellaufs – transparente Orientierungslinien auf der Gelkassette
Produktname
Q-PAGE™ TGN Mini
Q-PAGE™ TGN Midi
Gel mit fest eingestellter Polyacrylamid Konzentration (10 %)
Gel mit fest eingestellter Polyacrylamid Konzentration (10 %)
(4–15
Gel mit fest eingestellter

Solide Blister – Verpackung für sicheren Transport der Gele Gelkassetten mit Kamm zum Schutz der Geltaschen
Lagertemperatur: +4 °C
Transporttemperatur: gekühlt
Gele werden eingeschweißt geliefert in Tris/Glycinpuffer, ohne SDS (konserviert).
Sicherheitsrelevante Daten und zusätzliche Informationen im aktuellen Katalog oder unter www.carlroth.ch
Vakuum-Geltrockner
Vakuum-Geltrocker zur Trocknung und Dokumentation von Protein- und Sequenziergelen.
Ausstattung:
• Für eine schnelle und gleichmäßige Geltrocknung
• Zum Trocknen von Protein- und Sequenziergelen
• Sehr gleichmäßige Temperaturverteilung über die gesamte Trocknungsfläche
• Feineinstellung der Temperatur bis 90 °C
• Digitale Anzeige der Temperatur
• Timer für Heizelement und Vakuumpumpe (1 Minuten Schritte)
• Sehr robuste Konstruktion
Lieferung inkl. Vakuum-Geltrockner, Netzkabel, Silikon-Abdeckung, Poröse Gelmatte, Bedienungsanleitung
Kein Medizinprodukt/Kein ivD Produkt

9
Typ Verwendungshinweis Gelstärke Volumen pro Tasche Best.-Nr. VE CHF CHF
Gelkassette: 10 x 8,3 cm,
Taschen 1 mm 25 µl 3681.1 2 Stück 64,90 51,85 3681.2 10 Stück 271,70 217,35
12
Gelkassette: 10 x 8,3 cm, 15 Taschen 1 mm 22 µl 3682.1 2 Stück 64,90 51,85 3682.2 10 Stück 271,70 217,35
Gelkassette: 10 x 8,3 cm, 12 Taschen 1 mm 25 µl 3670.1 2 Stück 64,90 51,85 3670.2 10 Stück 271,70 217,35 Gradientengel
%) Gelkassette: 10 x 8,3 cm, 15 Taschen 1 mm 22 µl 3671.1 2 Stück 64,90 51,85 3671.2 10 Stück 271,70 217,35
Gradientengel (4–15 %)
mit fest eingestellter Polyacrylamid Konzentration (10 %) Gelkassette: 10 x 10 cm, 12 Taschen 1 mm 40 µl 3683.1 2 Stück 64,90 51,85 3683.2 10 Stück 271,70 217,35
Polyacrylamid Konzentration (10 %) Gelkassette: 10 x 10 cm, 15 Taschen 1 mm 28 µl 3684.1 2 Stück 64,90 51,85 3684.2 10 Stück 271,70 217,35 Gradientengel
%) Gelkassette: 10 x 10 cm, 12 Taschen 1 mm 40 µl 3673.1 2 Stück 64,90 48,60 3673.2 10 Stück 271,70 203,75 Gradientengel
%) Gelkassette: 10 x 10 cm, 15 Taschen 1 mm 28 µl 3676.1 2 Stück 64,90 51,85 3676.2 10 Stück 271,70 217,35
Gel
(4–15
(4–15
Typ Best.-Nr. VE CHF CHF Mini 20LT.1 1 Stück 4.572,10 3.657,65 Midi 20LX.1 1 Stück 5.739,50 4.591,60
Life Science
Blotting · Verbrauchsmaterial und Reagenzien

Blotting-Membranen
Sicherheitsrelevante Daten und zusätzliche Informationen im aktuellen Katalog oder unter www.carlroth.ch


Blotting-Papier
Zusätzliche Informationen im aktuellen Katalog oder unter www.carlroth.ch
Reagenzien
Sicherheitsrelevante Daten und zusätzliche Informationen im aktuellen Katalog oder unter www.carlroth.ch
▶ Viele zusätzliche Informationen im aktuellen Katalog oder unter www.carlroth.ch
TIP 10
Produktname Abmessung Porengröße Material Best.-Nr. VE CHF CHF Transfermembran ROTI ® NC 0.2 20 × 20 cm 0,2 µm Nitrocellulose 200H.1 5 Blatt 164,00 131,15 Transfermembran ROTI ® NC 0.45 20 × 20 cm 0,45 µm Nitrocellulose 200N.1 5 Blatt 143,00 114,40 10 × 10 cm 0,45 µm Nitrocellulose 200P.1 10 Blatt 122,70 98,05 Transfermembran ROTI ® NC 0.2 10 × 10 cm 0,2 µm Nitrocellulose 204H.1 10 Blatt 150,25 120,10 Transfermembran ROTI ® PVDF 0.45 20 × 20 cm 0,45 µm Polyvinylidenfluorid 23HA.1 5 Blatt 197,60 158,05 Transfermembran ROTI ® PVDF 0.2 20 × 20 cm 0,2 µm 23HC.1 5 Blatt 197,60 158,05 Polyvinylidenfluorid 9 × 10 cm 0,2 µm 23H9.1 10 Blatt 184,05 147,15 Polyvinylidenfluorid Transfermembran ROTI ® PVDF 0.45 7 × 8,4 cm 0,45 µm Polyvinylidenfluorid 23HE.1 10 Blatt 143,35 114,65 Transfermembran ROTI ® PVDF 0.2 7 × 8,4 cm 0,2 µm 23HH.1 10 Blatt 143,35 114,65 Polyvinylidenfluorid Transfermembran ROTI ® PVDF 0.45 10 × 10 cm 0,45 µm 23HK.1 10 Blatt 184,05 147,15 Polyvinylidenfluorid
Produktname L x B Dicke Best.-Nr. VE CHF CHF Blottingpapiere ROTILABO ® 13 x 10 cm 0,35 mm CL64.1 100 Blatt 55,00 43,90 20 x 20 cm CL65.1 100 Blatt 103,85 83,00 Blottingpapiere ROTILABO ® 13 x 10 cm 0,75 mm 0942.1 100 Blatt 84,85 67,85 20 x 20 cm 0943.1 100 Blatt 175,25 140,10 Blottingpapiere ROTILABO ® 15 x 15 cm 1,0 mm CL72.1 25 Blatt 37,05 29,60 20 x 20 cm CL73.1 25 Blatt 61,75 49,40
Produktname Reinheit Allgemeine Verwendung Best.-Nr. VE CHF CHF Glycin
%, Blotting Grade Für Western B lotting 0079.1 250 g 38,35 30,65 0079.2 500 g 71,40 57,05 0079.3 1 kg 122,85 98,25 0079.4 2,5 kg 237,25 189,80 Methanol
%, Blotting Grade Für Western B lotting 0082.1 500 ml 35,00 27,95 0082.2 1 l 48,75 39,00 0082.3 2,5 l 100,75 80,60 ROTI
ready-to-use
Blockierungslösung A151.1 250 ml 77,90 62,25 A151.4 500 ml 133,25 106,60 A151.2 1 l 232,70 186,15 A151.3 2,5 l 440,70 352,55
Western
lotting
0188.1 250 g 64,90 51,85 0188.2 500 g 111,70 89,30 0188.3 1 kg 193,70 154,95 0188.4 2,5 kg 409,50 327,60
≥99
≥99,9
®Block 10x konz.,
Proteinfreie
TRIS ≥99,9 %, Blotting Grade Für
B
und Immundetektionen
Life Science
Substrate für die Biochemie, die Mikrobiologie und für Immunoassays
5-Brom-4-chlor-3-indolylphosphat- p -Toluidinsalz
≥99 % , BioScience Grade
Histochemisches Substrat für die alkalische Phosphatase
Gut löslich in DMF (20 mg/ml), schwer löslich in Wasser. Vor Licht und Feuchtigkeit schützen.
Lagertemperatur: –20 °C
Transporttemperatur: Umgebungstemp. n Achtung H371
ROTI ® Lumin
10x konz., fluoreszenzfrei, für die Protein- und Cytoimmunchemie
Chemolumineszenz-Substrat für Peroxidase vermittelte Nachweisreaktionen

2 x 120 ml sind ausreichend für ca. 3.500 cm2 Membran (ca. 50 Minigel Blots) oder 2.400 Wells im ELISA.
Lagertemperatur: +4 °C
5-Brom-4-chlor-3-indolylphosphat-Dinatriumsalz
≥99 %
Substrat für die alkalische Phosphatase, insbesondere für Immunoblot-Verfahren
Gut löslich in Wasser (20 mg/ml), schlecht löslich in DMF. Vor Licht und Feuchtigkeit schützen.
Lagertemperatur: –20 °C
Transporttemperatur: Umgebungstemp.
DNase-free
X- β -Gal ≥99 % , BioScience Grade Kolorimetrisches Substrat der β Galactosidase. Für die Biochemie und Molekularbiologie
Lagertemperatur: –20 °C

Transporttemperatur: Umgebungstemp.
ROTI ® DAB Kit
für die Immunchemie
Substrat-Kit zur Detektion von HRP-Aktivität auf Blotmembranen und Objektträgern
Das Kit enthält
DAB Lösung (Best. Nr. 9869), DAB Puffer (Best. Nr. 9870) und Aktivierungsreagenz (Best. Nr. 9871) in Tropfflaschen. Die Einzel bestandteile dieses Kits können nicht separat nachgekauft werden. Ein Kit reicht aus zur Färbung von ca. 44 Minigel Blotmembranen oder 500 Objekt trägern.
Lagertemperatur: +4 °C
Transporttemperatur: gekühlt g n Gefahr H302 H3 41 H3 51 H3 60D H373
Best.-Nr. Abpackung VE
für ca. 44
X-Gluc
≥99 % , für die Mikrobiologie Glucuronidase-Substrat
Lagertemperatur: –20 °C
Transporttemperatur: Umgebungstemp.
4-Methylumbelliferyl- β - D - glucuronid Dihydrat
≥99 % , p.a.
MUG. Substrat für β -Glucuronidase zum Nachweis von E. coli.
Lagertemperatur: –20 °C
Transporttemperatur: Umgebungstemp.
Protease-free RNase-free
RNase-free DNase-free 11
Best.-Nr. VE Verp. CHF CHF 6368.1 500 mg Glas 58,40 46,65 6368.2 1 g Glas 115,05 92,00 6368.3 5 g Glas 427,70 342,15
Best.-Nr. VE Verp. CHF CHF A155.1 100 mg Glas 43,55 34,80 A155.2 500 mg Glas 188,50 150,80 A155.3 1 g Glas 336,70 269,35 A155.4 5 g Glas 1.077,70 862,15
Best.-Nr. VE Verp. CHF CHF 2315.1 100 mg Glas 31,10 24,80 2315.2 500 mg Glas 91,65 73,30 2315.3 1 g Glas 167,70 134,15 2315.5 2,5 g Glas 318,50 254,80 2315.4 5 g Glas 578,50 462,80
Best.-Nr. VE Verp. CHF CHF 6394.1 50 mg Glas 36,30 28,95 6394.2 250 mg Glas 100,00 79,95
1 g Glas 310,70 248,55
6394.3
Best.-Nr. Abpackung VE Verp. CHF CHF P078.1 2 x 120 ml 1 Kit Kunst. 609,70 487,75 P078.2 2 x 25 ml 1 Kit Kunst. 162,50 130,00
CHF CHF 9202.1
Tropfflaschen 1 Kit Karton 279,50 223,60
Verp.
Assays, in
Best.-Nr.
Verp. CHF CHF 0018.1 100 mg Glas 167,70 117,35 0018.2 500 mg Glas 630,50 441,35 0018.3 1 g Glas 1.051,70 736,15
VE
Life Science
Histologie
Xylol-Ersatzmedien
• Adäquater Ersatz für Xylol
• Mischbar mit IPA, Butanol, Ethanol
• Einsatz als Intermedium und zur Entparaffinierung
ROTI ® Histol
ready-to-use, für die Histologie
Intermedium aus Orangenterpen. Zum Entwachsen von histologischem Material.
l g n j Gefahr H226 H304 H315 H317 H411 Best.-Nr.
Einbettmedien
Paraplast ® für die Histologie Leica.

Gewebeeinbettungsmedium aus hochreinem Paraffin mit komplexen Elastomeren mit geregeltem Molekulargewicht. Schmelzpunkt: 56 °C
Paraffin in Pastillenform
In-vitro -Diagnostikum Klasse A
ROTICLEAR ®

ROTICLEAR® ready-to-use, für die Histologie Intermedium aus aliphatischen Kohlenwasserstoffen, praktisch aromatenfrei. Zum Ent wachsen histologischer Schnitte.
l g n
Gefahr H226 H304 H336 H412 EUH066
OCT Embedding Matrix ready-to-use, für die Histologie CellPath.
Einbettmedium für Gefrierschnitte
In-vitro -Diagnostikum Klasse A
ROTI ® Plast
100 % , für die Histologie Gewebeeinbettungsmedium aus hochreinem Paraffin
Schmelzbereich 54-56 °C Paraffin in Pastillenform
Kein Medizinprodukt/Kein ivD Produkt
Paraplast Plus ® für die Histologie Leica.
Gewebeeinbettungsmedium aus hochreinem Paraffin mit komplexen Elastomeren mit geregeltem Molekulargewicht und einem Anteil an DMSO für große und schwer zu infiltrierende Proben.
Schmelzpunkt: 56 °C Paraffin in Pastillenform
In-vitro -Diagnostikum Klasse A
Kältespray-Solidofix ® ready-to-use, für die Histologie Zum Einfrieren von histologischen Präparaten, zum Kühlen von Paraffinblöcken. Kühlt bis –45 °C
Gefahr H222-H229
Kein Medizinprodukt/Kein ivD Produkt
ROTH
VE Verp. CHF CHF 6640.1 1 l Glas 57,85 46,25 6640.4 2,5 l Glas 117,65 94,10 6640.5 5 l Alu 214,50 171,60 6640.2 10 l Weißbl. 396,50 317,20 6640.6 25 l Weißbl. 877,50 702,00
Best.-Nr. VE Verp. CHF CHF A538.1 1 l Glas 26,65 21,30 A538.5 2,5 l Glas 51,35 41,05 A538.6 5 l Alu 84,40 67,45 A538.2 10 l Weißbl. 154,70 123,75 A538.3 25 l Weißbl. 310,70 248,55 A538.4 200 l Fass 1.677,00 1.341,60
Best.-Nr. Abpackung VE Verp. CHF CHF X880.1 1 x 1 kg 1 kg Papiertüte 27,95 22,35 X880.3 3 x 1 kg 3 kg Papiertüte 77,35 61,85 X880.2 8 x 1 kg 8 kg Papiertüte 188,50 150,80
Best.-Nr. Abpackung VE Verp. CHF CHF 6478.1 1 x 125 ml 125 ml Kunst. 39,65 31,70 6478.2 3 x 125 ml 375 ml Kunst. 109,85 87,85
Best.-Nr. Abpackung VE Verp. CHF CHF 6642.1 1 x 1 kg 1 kg Kunst. 37,60 30,00 6642.5 1 x 2,5 kg 2,5 kg Kunst. 75,30 60,15 6642.2 1 x 10 kg 10 kg Kunst. 271,70 217,35 6642.6 1 x 20 kg 20 kg Kunst. 500,50 400,40
l
Best.-Nr. Abpackung VE Verp. CHF CHF T200.3 1 x 400 ml 400 ml Sprayfl. 16,25 13,00 T200.4 4 x 400 ml 1,6 l Sprayfl. 50,60 40,40
Best.-Nr. Abpackung VE Verp. CHF CHF X881.1 1 x 1 kg 1 kg Papiertüte 33,15 24,80 X881.3 3 x 1 kg 3 kg Papiertüte 94,25 70,65 X881.2 8 x 1 kg 8 kg Papiertüte 214,50 160,85
Bestellungen: 061 / 712 11 60 · info@carlroth.ch Life Science
TOP-Angebote Chemikalien
Osmolalitätsstandards
ROTI®Calipure
Die Osmometrie verwendet den osmotischen Druck zur Bestimmung der Konzentration. Der osmotische Druck einer Lösung hängt von der Temperatur und der darin gelösten Teilchenzahl ab.

Diese kolligative Eigenschaft kann über eine Bestimmung der Gefrierpunktserniedrigung erfolgen und somit indirekt der osmotische Wert bestimmt werden.
Unsere Osmolalitätsstandards werden aus hochreinem Natriumchlorid und deionisiertem Wasser hergestellt und durch 0,22 µm Membran filtriert. Sie können bei allen Osmometern zur Kalibrierung verwendet werden und sind auf SRM von NIST rückführbar.
Die chargenspezifischen Analysenzertifikate sind online erhältlich.

Osmolalitätsstandard
Best.-Nr. VE Verp. CHFCHF
Osmolalitätsstandard
ROTI®Calipure 850 mOsm/kg H2O
ROTI®Calipure 300 mOsm/kg H2O Best.-Nr. VE Verp. CHFCHF 216C.1 10 x 1 ml Glasamp. 77,90 66,15
10 x 1 ml Glasamp. 77,90 66,15
Osmolalitätsstandard
ROTI®Calipure 100, 300, 500, 850, 2000 mOsm/kg H2O, Linearitätsset mit je 2 Ampullen
Best.-Nr. VE Verp. CHFCHF 216E.1 10 x 1 ml Glasamp. 84,40 71,70
216A.1
ROTH
Bestellungen:
60 · Faxbestellungen: 061
712 20 21 · E-Mail-Bestellungen: info@carlroth.ch · Roth im Internet: www.carlroth.ch www.carlroth.com/ch/de/Kaufmaennische-Beratung-Aussendienst Netto-Preise in CHF zzgl. MwSt. Bei Aufträgen über 200,– CHF sparen Sie die Versandkostenpauschale von 15,– CHF. Es gelten die allgemeinen Geschäfts- und Lieferbedingungen der Roth AG, Arlesheim CH-DE
AG · Fabrikmattenweg 12 · 4144 Arlesheim
061 / 712 11
/
Gültig von 3. Juni bis 31. Juli 2024
Kalibrier- und Kontrollstandards
ROTI®Calipure
Brechungsindexstandards ROTI ® Calipure
Unsere Brechungsindexstandards werden aus hochwertigen Reagenzien hergestellt. Sie können mit allen Refraktometern verwendet werden. Sie sind lösungsmittelbasiert und werden in Flaschen mit zusätzlicher Pipette geliefert. Die chargenspezifischen Analysenzertifikate sind online erhältlich.
1,44468
Sicherheitsrelevante Daten und zusätzliche Informationen im aktuellen Katalog oder unter www.carlroth.ch

Gefrierpunktstandards ROTI ® Calipure
Die Konzentration eines gelösten Stoffes in einer Flüssigkeit, hat Einfluss auf einige kolligative Eigenschaften der Mischung, eine der Eigenschaften ist der Gefrierpunkt. Auch der Gefrierpunkt von Milch beruht auf diesem Phänomen und liegt bei unverfälschter Milch unter 0 °C. Wird die Milch mit Wasser verdünnt, rückt der Gefrierpunkt näher an den von reinem Wasser (0 °C). Die Erhöhung des Gefrierpunkts liegt an der Verdünnung der Lactose und anorganischen Salzen, die anderen Bestandteile wie Fett, Proteine und andere Inhaltsstoffe haben vermutlich keinen Einfluss auf den Gefrierpunkt.
Die Gefrierpunktstandards werden aus hochwertigen Rohstoffen gravimetrisch (w/w) hergestellt. Die Analysenzertifikate sind online erhältlich.
Eigenschaften:
• Kalibrier- und Kontrollstandard
• Für alle Kryoskope geeignet
• Für die Bestimmung des Gefrierpunkts in Milch
• Hergestellt gemäß ISO 5764
Produktname
Gefrierpunktstandard – Wärmeträgerflüssigkeit
Sicherheitsrelevante Daten und zusätzliche Informationen im aktuellen Katalog oder unter www.carlroth.ch

2
Reinheit Verp. Best.-Nr. VE CHFCHF
(20 °C) Glas 3100.1 15 ml 206,70 175,70 1,40485 (20 °C) Glas 3102.1 15 ml 357,50 303,85
(20 °C) Glas 3103.1 15 ml 206,70 175,70
1,38779
1,42345
(20 °C) Glas 3106.1 15 ml 206,70 175,70
(20 °C) Glas 3120.1 15 ml 206,70 175,70 1,49672 (20 °C) Glas 3124.1 15 ml 206,70 175,70 1,50044 (20 °C) Glas 3125.1 15 ml 206,70 175,70
(20 °C) Glas 3126.1 15 ml 206,70 175,70 1,53660 (20 °C) Glas 3143.1 15 ml 206,70 175,70 1,65808 (20 °C) Glas 3152.1 15 ml 344,50 292,80
1,46768
1,51726
Marke/ Reinheit Verp. Best.-Nr. VE CHFCHF
ROTI ® Calipure 000 (0,000 °C) Kunst. 1PEX.1 250 ml 53,20 45,15 ROTI ® Calipure 422 m°H (-0,408 °C) Kunst. 1PEY.1 100 ml 37,05 31,45 1PEY.2 250 ml 53,20 45,15 ROTI ® Calipure 530 m°H (-0,512 °C) Kunst. 1PH0.1 100 ml 37,05 31,45 1PH0.2 250 ml 53,20 45,15 ROTI ® Calipure 577 m°H (-0,557 °C) Kunst. 1PH1.1 250 ml 53,20 45,15 ROTI ® Calipure 621 m°H (-0,600 °C) Kunst. 1PH2.1 100 ml 37,05 31,45 1PH2.2 250 ml 53,20 45,15
– Kühlbadflüssigkeit ROTI ® Calipure für die Kryoskopie Kunst. 1PH3.1 500 ml 58,40 49,60
Gefrierpunktstandard
Gefrierpunktstandard
die Kryoskopie Kunst. 1PH4.1 250 ml 85,70 72,80
ROTI ® Calipure für
Chemikalien
Lösungsmittel zur Analyse
Aceton ROTIPURAN® ≥99,8 % , p.a., ACS, ISO l g Gefahr H225-H319-H336-EUH066
Best.-Nr. VE Verp. CHFCHF
9372.1 1 l Glas 43,55 34,80
9372.4 1 l Kunst. 39,65 31,70
9372.2 2,5 l Glas 90,90 72,65
9372.5 2,5 l Kunst. 85,70 68,50
9372.6 5 l Kunst. 146,25 117,00
9372.7 10 l PE/Stahl 245,70 196,55
9372.3 25 l Weißbl.448,50 358,80
1-Butanol
ROTIPURAN® ≥99,4 % , p.a., ACS l h g Gefahr H226-H302-H315-H318-H335-H336
Best.-Nr. VE Verp. CHFCHF
Essigsäureethylester
l g Gefahr H225-H319-H336-EUH066
Best.-Nr. VE Verp. CHFCHF
6784.1
2-Propanol
ROTIPURAN® ≥99,8 % , p.a., ACS, ISO
l g Gefahr H225-H319-H336
Cyclohexan
ROTIPURAN® ≥99,5 % , p.a., ACS, ISO
l g n j Gefahr H225-H304-H315-H336-H410
Best.-Nr.
Dichlormethan
ROTIPURAN® ≥99,5 % , p.a., ACS, ISO g n Achtung H315-H319-H336-H351
Best.-Nr. VE Verp. CHFCHF
6053.3 100 ml Glas 24,60 19,60 6053.1
498,15
Diethylether
ROTIPURAN® ≥99,5 % , p.a., stabilisiert
l g Gefahr H224-H302-H336-EUH019 EUH066
Best.-Nr. VE Verp. CHFCHF
3942.1
3942.5 25 l Weißbl. 760,50 608,40
Dimethylsulfoxid (DMSO)
ROTIPURAN® ≥99,8 % , p.a.
Best.-Nr. VE Verp. CHFCHF
4720.4 100 ml Glas 31,85
4720.6 10 l Kunst. 817,70 654,15 4720.7 25 l Kunst. 1.948,70 1.558,95
l g Gefahr H225-H319
Toluol
ROTIPURAN® ≥99,5 % , p.a.,
ISO l g n Gefahr H225-H304-H315-H336-H361d-H373-H412
*inkl. deutscher Alkoholsteuer
Ethanol*
ROTIPURAN® ≥70 % , p.a. l g Gefahr H225-H319
*inkl. deutscher Alkoholsteuer
Isooctan ROTIPURAN® ≥99
l g n j Gefahr
Trichlormethan/Chloroform
ROTIPURAN® ≥99 % , p.a., stabilisiert i n Gefahr H302-H315-H319-H331-H351-H361d-H372
Wasser
ROTIPURAN® p.a., ACS Wasser ISO Qualität 2
Methanol
ROTIPURAN® ≥99,9 % , p.a., ACS, ISO
l i n Gefahr H225-H301+H311+H331-H370
H225-H304-H315-H336-H410 Best.-Nr.
Petrolether 40–60 °C
ROTIPURAN® p.a., ACS, ISO
l g n j Gefahr
H225-H304-H315-H336-H411
Xylol (Isomere)
ROTIPURAN® ≥99 % , p.a., ACS, ISO
l g n Gefahr H226-H304-H312+H332H315-H319-H335-H373
3
Glas
7171.3
l Kunst. 297,70 238,15 7171.4 10 l Kunst. 531,70 425,35 7171.5 25 l Kunst.
7171.2 1 l Glas 89,60 71,60 7171.1 2,5 l
175,50 140,40
5
1.033,50 826,80
VE Verp. CHFCHF
1 l Glas 100,00
6886.2
l Glas
6886.3 5 l Alu 357,50 286,00 6886.4 10 l Weißbl. 596,70 477,35 6886.5 25 l Weißbl. 1.189,50 951,60
6886.1
79,95
2,5
206,70 165,35
1 l Glas
2,5 l Glas
10 l Weißbl.
66,20 52,90 6053.2
123,40 98,65 6053.4
318,50 254,80 6053.5 25 l Weißbl. 622,70
1 l Glas 74,75 59,80 3942.6 2,5 l Glas 133,25 106,60
3942.4 5 l Alu 253,50 202,80
25,45
500 ml Glas 59,70 47,70
1 l Glas 101,30 80,95
l Glas
4720.2
4720.1
4720.3 2,5
206,70 165,35
4720.5 5 l Kunst. 427,70 342,15
ROTIPURAN® ≥99,5 % , p.a., ACS, ISO
1 l Glas 54,50 43,55 6784.3 1 l Kunst. 50,60 40,40 6784.2 2,5 l Glas 97,40 77,85 6784.4 2,5 l Kunst. 94,25 75,40 6784.5 5
154,70 123,75
l Kunst. 266,50 213,20 6784.7
l Kunst. 531,70 425,35
l Kunst.
6784.6 10
25
139,00 111,15 9065.3 1 l Kunst. 136,50 109,20 9065.2 2,5 l Glas 282,75 226,20 9065.4 2,5 l Kunst. 279,50 223,60 9065.5 5 l Kunst. 500,50 400,40 9065.7 10 l Kunst. 825,50 660,40 9065.6 25 l Weißbl. 1.714,70 1.371,75 9065.8 25 l Kunst. 1.683,50 1.346,80
Best.-Nr. VE Verp. CHFCHF 9065.1 1 l Glas
%
p.a.
Best.-Nr. VE Verp. CHFCHF T868.1 1 l Kunst. 94,25 75,40 T868.2 2,5 l Kunst. 206,70 165,35 T868.3 5 l Kunst. 383,50 306,80 T868.4 10 l Kunst. 700,70 560,55 T868.5 25 l Kunst. 1.397,50 1.118,00
Ethanol* ROTIPURAN® ≥99,8
,
Verp. CHFCHF
Best.-Nr. VE
2,5 l Glas 201,50 161,20
6889.1 1 l Glas 93,50 74,75 6889.2
%
p.a., ACS
,
VE Verp. CHFCHF
l Glas 41,50 33,15
l Kunst. 38,90 31,05
l Glas 72,70 58,10
55,60
5 l Kunst. 129,90 103,85 4627.3 25 l Weißbl. 292,50 234,00
4627.1 1
4627.4 1
4627.2 2,5
4627.5 2,5 l Kunst. 69,55
4627.6
Best.-Nr. VE Verp. CHFCHF T173.1 1 l Glas 66,95 53,55 T173.2 2,5 l Glas 136,50 109,20 T173.3 5 l Alu 245,70 196,55 T173.5 25 l Weißbl. 864,50 691,60
Best.-Nr. VE Verp. CHFCHF 6752.1 1 l Glas 49,30 39,35 6752.3 1 l Kunst. 46,70 37,30 6752.2 2,5 l Glas 116,90 93,45 6752.4 2,5 l Kunst. 114,30 91,35 6752.5 5 l Kunst. 188,50 150,80 6752.7 10 l PE/Stahl 331,50 265,20 6752.8 10 l Kunst. 318,50 254,80 6752.6 25 l Weißbl. 609,70 487,75 6752.9 25 l Kunst. 591,50 473,20
Best.-Nr. VE Verp. CHFCHF 7115.1 1 l Glas 61,75 49,40 7115.2 2,5 l Glas 122,10 97,60 7115.3 5 l Alu 175,50 140,40 7115.4 25 l Weißbl. 539,50 431,60
Best.-Nr. VE Verp. CHFCHF 3313.4 100 ml Glas 28,50 22,75 3313.1 1 l Glas 84,40 67,45 3313.2 2,5 l Glas 167,70 134,15 3313.5 25 l Weißbl. 1.293,50 1.034,80
ACS,
Best.-Nr. VE Verp. CHFCHF T172.1 1 l Kunst. 16,80 13,35 T172.2 2,5 l Kunst. 33,70 26,90 T172.3 5 l Kunst. 53,20 42,50 T172.5 30 l Kunst. 214,50 171,60
Best.-Nr.
Verp. CHFCHF 4436.1 1 l Glas 66,95 53,55 4436.2 2,5 l Glas 149,50 119,60 4436.3 5 l Alu 240,50 192,40 4436.4 10 l Weißbl. 323,70 258,95 4436.7 25 l Weißbl. 674,70 539,75
VE
Chemikalien
Säuren und Laugen zur Analyse
Ameisensäure
ROTIPURAN® ≥98 % , p.a., ACS
l h i Gefahr
H226-H290-H302-H314-H331-EUH071
Essigsäure
ROTIPURAN® 100 % , p.a.
l h Gefahr H226-H314 Best.-Nr.
Laugen Säuren
Ammoniaklösung ROTIPURAN® ≥25 % , p.a.
h g j Gefahr H290-H314-H335-H410
6774.1 1 l
6774.3 5 l Kunst. 85,70 68,50

Salpetersäure
ROTIPURAN® ≥65 % , p.a., ISO o h i Gefahr H272-H290-H314-H331-EUH071
Natronlauge
Kaliumhydroxid
≥85 % , p.a., in Plätzchen h g Gefahr H290-H302-H314
Salzsäure
ROTIPURAN® ≥32 % , p.a., ISO h g Gefahr H290-H314-H335
Sicherheitsrelevante Daten und zusätzliche Informationen im aktuellen Katalog oder unter www.carlroth.ch
Natriumhydroxid
4
VE Verp. CHFCHF
Best.-Nr.
Glas
38,35 30,65
6774.2 2,5 l Glas 57,10 45,60
Best.-Nr. VE Verp. CHFCHF 6751.3 250 g Kunst. 25,35 20,25 6751.1 1 kg Kunst. 51,35 41,05 6751.4 2,5 kg Kunst. 103,90 83,05 6751.2 5 kg Kunst. 193,70 154,95 6751.6 10 kg Kunst. 349,70 279,75 6751.5 25 kg Kunst. 700,70 560,55
Best.-Nr. VE Verp. CHFCHF 6771.3 500 g Kunst. 31,85 25,45 6771.1 1 kg Kunst. 53,20 42,50 6771.4 2,5 kg Kunst. 106,50 85,15 6771.2 5 kg Kunst. 198,25 158,60 6771.6 10 kg Kunst. 370,50 296,40 6771.5 25 kg Kunst. 791,70 633,35
Reinheit Best.-Nr. VE CHFCHF 50 %, p.a.
1 l 51,90 41,45 22CY.2 2,5 l 103,90 83,05 22CY.3 5 l 180,70 144,55 22CY.4 10 l 323,70 258,95 22CY.5 25 l 791,70 633,35 45 %, p.a. 22E0.1 1 l 48,00 38,35 22E0.2 2,5 l 95,55 76,40 22E0.3 5 l 167,70 134,15 22E0.4 10 l 297,70 238,15 22E0.5 25 l 739,70 591,75 40 %, p.a. 22E1.1 1 l 44,10 35,20 22E1.2 2,5 l 87,00 69,55 22E1.3 5 l 154,70 123,75 22E1.4 10 l 271,70 217,35 22E1.5 25 l 669,50 535,60 ≥32 %, p.a. T196.1 1 l 47,45 37,95 T196.2 2,5 l 90,90 72,65 T196.3 5 l 145,60 116,45 T196.7 25 l 552,50 442,00 Reinheit Best.-Nr. VE CHFCHF 25 %, p.a. 22E2.1 1 l 35,00 27,95 22E2.2 2,5 l 66,20 52,90 22E2.3 5 l 123,40 98,65 22E2.4 10 l 206,70 165,35 22E2.5 25 l 513,50 410,80 20 %, p.a. 22E3.1 1 l 33,70 26,90 22E3.2 2,5 l 62,30 49,75 22E3.3 5 l 114,30 91,35 22E3.4 10 l 193,70 154,95 22E3.5 25 l 479,70 383,75 10 %, p.a. 22E4.1 1 l 31,10 24,80 22E4.2 2,5 l 58,40 46,65 22E4.3 5 l 102,60 82,00 22E4.4 10 l 167,70 134,15 22E4.5 25 l 383,50 306,80 5 %, p.a. 22E5.1 1 l 29,80 23,75 22E5.2 2,5 l 51,90 41,45 22E5.3 5 l 90,90 72,65 22E5.4 10 l 146,80 117,35 22E5.5 25 l 336,70 269,35
≥98 % , p.a., ISO, in Plätzchen h Gefahr H290-H314
22CY.1
VE Verp. CHFCHF 3738.1 1 l Glas 43,55 34,80 3738.4 1 l Kunst. 40,95 32,75 3738.2
Glas 94,80 75,75 3738.5 2,5 l Kunst. 92,20 73,70 3738.6 5 l Kunst.
3738.3
Best.-Nr.
2,5 l
159,25 127,40
10 l Kunst. 284,70 227,75
VE Verp. CHFCHF 4724.3 500 ml Glas 38,35 30,65 4724.1 1 l Glas 71,40 57,05 4724.2 2,5 l Glas 141,70
10 l PE/Stahl
369,20 4724.5 25 l PE/Stahl
747,75
113,35 4724.4
461,50
934,70
Best.-Nr. VE Verp. CHFCHF 4989.3 250 ml Glas 29,80 23,75 4989.1 1 l Glas 53,95 43,15 4989.2 2,5 l Glas 111,15 88,90 4989.4 2,5 l Kunst. 107,80 86,15
CHFCHF P074.1
l Glas 31,85 25,45 P074.3 1 l Kunst. 29,25 23,40 P074.2 2,5 l Glas 57,10 45,60 P074.4 2,5 l Kunst. 54,50 43,55 P074.5 10 l Kunst. 157,95 126,35 P074.6 25 l Kunst. 357,50 286,00
Best.-Nr. VE Verp.
1
Chemikalien
Stickstoffbestimmung nach Kjeldahl
Die Stickstoffbestimmung in organischem Material wird meist mit der Kjeldahl-Methode durchgeführt und findet in vielen Bereichen Anwendung, unter anderem in der Umwelt-, Lebensmittel- und Wasseranalytik, der landwirtschaftlichen Analytik, der pharmazeutischen und chemischen Industrie.
Kjeldahl
Tabletten
Sicherheitsrelevante Daten und zusätzliche Informationen im aktuellen Katalog oder unter www.carlroth.ch
Zusammensetzung der Kjeldahl Tabletten:
Hinweis: 8225 Kjeldahl-Tabletten Antischaum enthalten keinen Katalysator. Bitte zusätzlich Kjeldahl-Tabletten mit Katalysator verwenden.


5
Produktname Reinheit Best.-Nr. VE CHFCHF Kjeldahl-Tabletten Antischaum Tablette 1 g 8225.1 250 Stück 162,50 130,00 8225.2 1.000 Stück 513,50 410,80 Kjeldahl-Tabletten C Tablette 5,1 g 8241.1 250 Stück 188,50 150,80 8241.2 1.000 Stück 583,70 466,95 Kjeldahl-Tabletten CK Tablette 3,9 g 8243.1 250 Stück 188,50 150,80 8243.2 1.000 Stück 583,70 466,95 Kjeldahl-Tabletten CT Tablette 5,3 g 9637.1 250 Stück 188,50 150,80 9637.2 1.000 Stück 583,70 466,95 Kjeldahl-Tabletten CX Tablette 5,5 g 8236.1 250 Stück 188,50 150,80 8236.2 1.000 Stück 583,70 466,95 Kjeldahl-Tabletten (Missouri-Katalysator) Tablette 2,5 g HN22.1 250 Stück 188,50 150,80 HN22.2 1.000 Stück 583,70 466,95 Kjeldahl-Tabletten (quecksilber- und selenfrei) Tablette 5 g HN19.1 250 Stück 219,70 175,75 HN19.2 1.000 Stück 786,50 629,20 Kjeldahl-Tabletten (quecksilber- und selenfrei) Tablette 2,5 g HN20.1 250 Stück 188,50 150,80 HN20.2 1.000 Stück 583,70 466,95 Kjeldahl-Tabletten ST Tablette 3,5 g 9693.1 250 Stück 188,50 150,80 9693.2 1.000 Stück 583,70 466,95 Kjeldahl-Tabletten TCT Tablette 3,71 g 9763.1 250 Stück 188,50 150,80 9763.2 1.000 Stück 583,70 466,95 Kjeldahl-Tabletten ( Wieninger-Katalysator) Tablette 2,5 g HN21.1 250 Stück 188,50 150,80 HN21.2 1.000 Stück 583,70 466,95
Typische Zusammensetzung Best.-Nr. Bezeichnung Gewicht der Tablette (g)K 2SO 4 Na 2SO 4 CuSO 4 CuSO 4 • 5 H 2O TiO 2 Se Antischaum HN19 Kjeldahl-Tabletten (quecksilber- und selenfrei) 5 23,10 % 69,30 % 1,80 % – 2,80 %––HN20 Kjeldahl-Tabletten (quecksilber- und selenfrei) 2,5 23,10 % 69,30 % 1,80 % – 2,80 %––HN21 Kjeldahl-Tabletten (Wieninger-Katalysator) 2,5 – 96,25 % 1,50 % – – 1,50 % –HN22 Kjeldahl-Tabletten (Missouri-Katalysator) 2,5 48,40 %48,30 %0,30 %– –8225 Kjeldahl-Tabletten Antischaum 1 – 97,00 % – – – –3,00 % 8236 Kjeldahl-Tabletten CX 5,5 90,91% – – 9,09 % –8241 Kjeldahl-Tabletten C 5,1 98,04 %– – 1,96 % –8243 Kjeldahl-Tabletten CK 3,9 89,74 % – – 10,26 % –9637 Kjeldahl-Tabletten CT 5,3 94,34 %– – 2,83 % 2,83 %––9693 Kjeldahl-Tabletten ST 3,5 99,90 %– – – – 0,10 % –9763 Kjeldahl-Tabletten TCT 3,71 94,34 %– – 2,83 % 2,83 %––
Chemikalien
Mehrelementstandards für die ICP-OES
MISA-ICP-OES Mehrelementstandards
MISA (Metals and Inorganics Sectoral Approach) ist ein Kooperationsprogramm, das von der ECHA und Eurometaux, dem europäischen Verband für Nichteisenmetalle, ins Leben gerufen wurde, um offene technische und wissenschaftliche Fragen speziell für den Metall- und den anorganischen Sektor weiterzuentwickeln und gleichzeitig die Registrierungsdossiers in diesen Sektoren weiter zu verbessern.
Produktname
MISA ICP-OES-Standard 1- Seltenerdmetalle 18 Ce, Dy, Er, Eu, Gd, Ho, La, Lu, Nd, Pr, Sc, Sm, Tb, Th, Tm, U, Y, Yb
MISA ICP-OES-Standard 2- Edelmetalle 6 Au, Ir, Pd, Pt, Rh, Ru
MISA ICP-OES-Standard 3-A lkali, Erdalkali- und Nicht-Übergangsmetalle 16 Al, As, Ba, Bi, Be, Ca, Cs, Ga, In, K, Li, Mg, Na, Rb, Se, Sr
MISA ICP-OES-Standard 4- Fluoridlösliche Gruppe 15 B, Ge, Hf, Mo, Nb, P, Re, S, Sb, Si, Sn, Ta, Ti, W, Zr
MISA ICP-OES-Standard 5- Übergangsmetalle 13 Ag, Cd, Co, Cr, Cu, Fe, Hg, Mn, Ni, Pb Tl, V, Zn
Sicherheitsrelevante Daten und zusätzliche Informationen im aktuellen Katalog oder unter www.carlroth.de / www.carlroth.at
Zur Unterstützung des MISA-Programms ROTI ® Star Salpetersäure Blanks
Die verdünnten hochreinen Salpetersäuren sind hervorragend geeignet um die Blindwertbestimmungen bei AAS, ICP-OES und ICP-MS durchzuführen. Sie können ebenfalls zur Verdünnung der Proben verwendet werden.
Eigenschaften:
• hergestellt mittels Subboiling-Destillation
• eingesetztes Wasser mit Leitfähigkeit von max. 0,055 µS/cm bei 25 °C, zum Zeitpunkt der Herstellung
• durch 0,2 µm Membran filtriert
Salpetersäure
ROTI®Star 5 % h Gefahr H290-H314-EUH071
Salpetersäure
ROTI®Star 0,5 %
Zum Mischen und Vorbereiten von Kalibrierstandards für die spektrometrische Analyse von Metallen in Kohlenwasserstoff-/Petrochemieproben.
Mineralöl Blank
Mineralöl Blank
ROTI®Star 75 cSt n Gefahr H304 Best.-Nr. VE
ROTI®Star 20 cSt n Gefahr H304
6
Anzahl Elemente Zusammensetzung Info zur Konz. Matrix Best.-Nr. VE CHFCHF
100 mg/l 5 % HNO3 1YP2.1 100 ml310,70 264,10
100 mg/l 10 % HCl 1YP3.1 100 ml 232,70 197,80
100 mg/l 10 % HNO3 1YT2.1 100 ml 214,50 182,30
100 mg/l 5 % HNO3 + tr% HF 24Y8.1 100 ml 240,50 204,40
100 mg/l 10 % HNO3 24Y9.1 100 ml 227,50 193,35
ROTI
® Star Mineralöl Blanks
Best.-Nr. VE Verp. CHF CHF 23PX.1 500 ml LDPE 75,30 63,95 23PX.2 1 l LDPE 103,90 88,25
Best.-Nr. VE Verp. CHF CHF 23PY.1 500 ml LDPE 75,30 63,95 23PY.2 1 l LDPE 103,90 88,25
Best.-Nr. VE Verp. CHF CHF 25T6.1 500 ml Kunst. 111,70 94,90
Verp. CHF CHF 25T7.1 500 ml Kunst. 103,90 88,25
Chemikalien
Elementstandards für die ICP-MS
(Inductively Coupled Plasma – Massenspektrometrie)
Die Lösungen sind zertifiziert und auf Standard-Referenzmaterialien des NIST rückführbar (ausgenommen: Iridium, Osmium und Ruthenium). Die Herstellung der Lösungen findet nach ISO 17034 in einem akkreditierten Umfeld statt. Die Lösungen sind in einem nach ISO/IEC 17025 akkreditierten Laboratorium geprüft und werden mit einem umfangreichen, chargenbezogenen Analysenzertifikat ausgeliefert.
Jede Standardlösung wird aus hochreinen Ausgangstoffen (überwiegend ≥99,999 %) gefertigt und deren Gehalt gravimetrisch und mittels ICP ermittelt. Bei der Herstellung der Lösungen kommen Säuren (gereinigt mittels Subboiling-Destillation) und Wasser von höchster Qualität zum Einsatz. Dies bedeutet für Sie erstklassige Referenzmaterialien höchster Reinheit und Qualität.
• Bis zu 70 gemessene Spurenverunreinigungen im ppt Bereich
• Bis zu 36 Monate Haltbarkeit auf die ungeöffnete Flaschen Produktname
ICP-MS- St andardlösung
Sicherheitsrelevante Daten und zusätzliche Informationen im aktuellen Katalog oder
Mehrelementstandards
ICP-MS Tuning Solution A 6 Be (10), Bi (2), Ce (2), Co (5), In (2), Mn (5)Konz.
ICP-MS Tuning Solution B 6 Be (1000), Bi (200), Ce (200), Co (500), In (200), Mn (500)
ICP-MS Interferenztestlösung A – 6020 12 Cl – (20000), Ca (3000), Fe (2500), Na (2500), C (2000), Al (1000), Mg (1000), P (1000), K (1000), S (1000), Mo (20), Ti (20)
Sicherheitsrelevante Daten und zusätzliche Informationen im aktuellen Katalog oder unter www.carlroth.ch

▶ Weitere Mehrelementstandardlösungen für die ICP-MS im aktuellen Katalog oder unter www.carlroth.ch
▶ Wir bieten Ihnen unsere ROTI ® Star Multi-Elementstandardlösungen auch als kundenspezifische Sonderanfertigung in allen gängigen Gebindegrößen an.
7
Element Reinheit Konz. Matrix Best.-Nr. VE CHFCHF Quecksilber
10 mg/l Hg, in 5 % HNO3 10 mg/l 5 % HNO3 5017.1 100 ml 93,50 79,40 Rhodium ICP-MS-Standardlösung Rhodium (Rh) 100 mg/l Rh, in 2 % HCl 100 mg/l 2 % HCl 22HC.1 100 ml 219,70 186,75 Yttrium
andardlösung Yttrium (Y) 100 mg/l Y, in 2 % HNO 3 100 mg/l 2 % HNO3 25KL.1 100 ml 77,90 66,15
Quecksilber (Hg)
ICP-MS- St
www.carlroth.ch
unter
Produktname Anzahl Elemente Zusammensetzung Info zur Konz. Matrix Best.-Nr. VE CHFCHF ICP-MS Kalibrierstandardlösung 5 Ca, Fe, K, Mg, Na 1000 mg/l 2 % HNO3 0409.1 100 ml 427,70 363,55 8Ge, Hf, Mo, Sb, Sn, Te, W, Zr 10 mg/l 2 % HNO3 + 0,1 % HF 6816.1 100 ml 375,70 319,35 6816.2 500 ml 305,50 259,65 ICP-MS Tuning Solution 5 Ce, Co, Li, Tl, Y 10 mg/l 2 % HNO3 6819.1 100 ml 141,70 120,45 6 Ce, Co, Li, Mg, Tl, Y 1 μ g/l 2 % HNO3 6806.1 100 ml 193,70 164,65 6806.2 500 ml 357,50 303,85
in μ g/l 1 % HNO3 0900.2 250 ml 396,50 337,00
Konz. in μ g/l 1 % HNO3 0902.1 100 ml 284,70 242,00
Konz. in μ g/l 5 % HNO3 6808.1 100 ml 474,50 403,30
Chemikalien
Isotopenmarkierte Mykotoxine als Standards
Unter Mykotoxinen versteht man sekundäre Stoffwechselprodukte, welche von Pilzen gebildet werden. Deshalb werden diese auch als Schimmelpilzgifte beschrieben. Anhand ähnlicher Molekularstrukturen und der produzierenden Schimmelpilzgattung können diese in verschiedene Gruppen gefasst werden wie z. B. die Aflatoxine (Aspergillus flavus) oder die Fumonisine (Fusarium verticillioides). Diese Mykotoxine sind oftmals in Agrarprodukten und Nahrungsmitteln vorhanden, welche bei Verzehr schwere chronische Erkrankungen und akute Vergiftungen (Mykotoxikosen) auslösen können. Um dies zu regulieren wurden in vielen Ländern Grenzwerte eingeführt, wodurch Lebensmittel regelmäßig auf deren Kontamination geprüft werden müssen. Zur präzisen Analyse Ihrer Proben, bieten wir 13-C isotopenmarkierte Mykotoxine als Standards für die gängigsten Schimmelpilzgifte an.

Sicherheitsrelevante Daten und zusätzliche Informationen im aktuellen Katalog oder unter www.carlroth.de / www.carlroth.at
Sicherheitsrelevante
8
Mykotoxine
Strukturformel Produktname Reinheit Best.-Nr. VE CHFCHF C C C C C C C C C O O C C C C C C O C C O O CH3 H H 13 13 13 13 13 13 13 13 13 13 13 13 13 13 13 13 13 13C17-Aflatoxin B1 0.5 µg/ml in Acetonitril 25X1.1 1,2 ml 2.470,00 2.099,50 C C C C C C C C C C C C O C C O O C C C O H H O CH3 13 13 13 13 13 13 13 13 13 13 13 13 13 13 13 13C17-Aflatoxin B2 0.5 µg/ml in Acetonitril 25X2.1 1,2 ml 2.470,00 2.099,50 O C C C C C C C C C C C O C C O O H H O CH3 C C O C O 13 13 13 1313 13 13 13 13 13 13 13 13 13C17-Aflatoxin G1 0.5 µg/ml in Acetonitril 25X3.1 1,2 ml 2.470,00 2.099,50 O C C C C C C C O C C C C C C C O C C O O O H H O CH3 13 13 13 13 13 13 13 13 13 13 13 13 13 13 13C17-Aflatoxin G2 0.5 µg/ml in Acetonitril 25X4.1 1,2 ml 2.470,00 2.099,50 O C C C C C C O C C C C O C C C C C C O CH3 O O H OH 13 13 13 13 13 13 13 13 13 13 13 13 13 13C17-Aflatoxin M1 0.5 µg/ml in Acetonitril 25X5.1 1,2 ml 2.470,00 2.099,50 C C C C C C H3C O C C C O H OHC HO CH3 O C C C OH H 13 13 13 13 13 13 13 13 13 13 13 13 13C15 -Deoxynivalenol 25 µg/ml in Acetonitril 25XC.1 1,2 ml 2.470,00 2.099,50 H3C C C C C C C C C C C C C C C C C C C CH3 O C C C C C O HO C HO O O CH3 O CH3 OH NH2 OH OH C C C C C O HO O C O HO 13 13 13 13 13 13 13 13 13 13 13 13 13 13 13 13 13 13 13 13 13 13 13 13 13 13 13 13 13 13 13 13 13C 34 -Fumonisin B1 25 µg/ml in Acetonitril/Wasser (1:1) 25X7.1 1,2 ml 1.987,70 1.689,55 H3C C C C C C C C C C C C C C C C C C C CH3 O C C C C C HO O O C O HO CH3 CH3 NH2 OH OH O C C C C C HO O O C HO O 13 13 13 13 13 13 13 13 13 13 13 13 13 13 13 13 13 13 13 13 13 13 13 13 13 13 13 13 13 13 13C 34 -Fumonisin B2 10 µg/ml in Acetonitril/Wasser (1:1) 25X8.1 1,2 ml 2.600,00 2.210,00 H3C C C C C C C C C C C C C C C C C C C CH3 O C C C C C HO O O C O HO CH3 CH3 NH2 OH O C C C C C HO O O C HO O OH 13 13 13 13 13 13 13 13 13 13 13 13 13 13 13 13 13 13 13 13 13 13 13 13 13 13 13 13 13 13 13 13C 34 -Fumonisin B3 10 µg/ml in Acetonitril/Wasser (1:1) 25X9.1 1,2 ml 2.600,00 2.210,00 C C C C C C C C O H C O C H CH3 C C OH OH O C H3C C O C C CH3 H3C O C CH3 O 13 13 13 13 13 13 13 13 13 13 13 13 13 13 13 13 13 13 13 13 13C22-HT-2 Toxin 25 µg/ml in Acetonitril 25XL.1 1,2 ml 2.470,00 2.099,50 C C C C C C C C O C O OH Cl CH3 C O N H C C C O HO C C C C C C 13 13 13 13 13 13 13 13 13 13 13 13 13 13 13 13 13 13 13 13C20 -Ochratoxin 10 µg/ml in Acetonitril 25X6.1 1,2 ml 1.987,70 1.689,55 C C C C C C H3C C C C O C C OH CH3 O C H3C O C O C H3C O O C C O C CH3 H3C O C 13 13 13 13 13 13 13 13 13 13 13 13 13 13 13 13 13 13 13 13 13 13 13C24-T-2 Toxin 25 µg/ml in Acetonitril 25XK.1 1,2 ml 2.470,00 2.099,50 C C C C C C C C O C C C C C C C C C OH HO CH3 O O 13 13 13 13 13 13 13 13 13 13 13 13 13 13 13 13C18-Zearalenon 25 µg/ml in Acetonitril 25XA.1 1,2 ml 2.470,00 2.099,50
Daten und zusätzliche Informationen im aktuellen Katalog oder unter www.carlroth.ch
Chemikalien
HPLC

HPLC-Säule NUCLEODUR ® 300-5 C18 ec 5 µm
Macherey-Nagel.
Standard RP-Phase mit weiten Poren (300 Å) zur Trennung von Biomolekülen in analytischen Säulen. Diese Octadecyl-Modifizierung basiert auf dem hochreinen Kieselgel NUCLEODUR ®
Partikelgröße (µm)

Säulenlänge (mm) Säuleninnendurchmesser (mm) Best.-Nr. VE CHFCHF
5 100 4,6 26C2.1 1 Stück 484,90 412,15
5 150 2 26C3.1 1 Stück 538,20 457,45
5 150 4,6 26C4.1 1 Stück 484,90 412,15
5 250 4 26C5.1 1 Stück 559,00 475,15
5 250 4,6 26C6.1 1 Stück 590,20 501,65

▶ Entdecken Sie viele weitere HPLC-Säulen in unserem Webshop.
Column Protection System
Innovatives und universelles Vorsäulenhaltersystem. Geeignet für alle analytischen HPLC-Säulen mit 1/16″ Fitting.
• Idealer Schutz für Ihre analytische HPLC Säule → deutlich verlängerte Standzeit
• Minimiertes Totvolumen → geeignet für die ultra fast HPLC
• Spezielle Ferrules → Druckstabilität bis 1300 bar (18850 psi)
• Visuelle Verschmutzungskontrolle → rechtzeitiges Austauschen der Vorsäule
• Passende Vorsäulen mit 4 mm Länge und 2 mm ID (für Hauptsäulen mit 2 mm ID) bzw. 3 mm ID (für Hauptsäulen mit 3, 4 und 4,6 mm ID)
• UNIVERSAL RP Vorsäulen passend zu allen HPLC Säulen unter RP Bedingungen
Inhalt des Column Protection Systems:
• Vorsäulenhalter (1 Stück)
• Kapillaren (2 Stück)
• Ferrules (3 Stück)
• Schraubenschlüssel (2 Stück)
• Bedienungsanleitung
Column Protection System
Macherey-Nagel.
Typ Best.-Nr. VE CHFCHF
Column Protection System 6041.1 1 Set 193,70 164,65

ROTISOLV® LC-MS-Eluent-Mischungen für die HPLC
Eigenschaften:
• Fertigmischungen ready-to-use für eine bequeme Handhabung
• Höchste chemische Reinheit der eingesetzten Ausgangsprodukte: HPLC-Lösungsmittel (≥99,9 %) und Säuren (≥99,9 %)
• Hohe Genauigkeit des Mischungsverhältnisses
• Hohe UV-Durchlässigkeit der Fertigmischung
• Metallische Verunreinigung: ≤0,05 ppm
• Auf LC-MS-Eignung getestet
• Partikelfiltration (0,2 μm Membran)
• Unter Schutzgas abgefüllt
Sicherheitsrelevante
9
Daten und zusätzliche Informationen im aktuellen Katalog oder unter www.carlroth.ch
Produktname Reinheit Verp. Best.-Nr. VE CHFCHF Acetonitril mit 0,1 % A meisensäure ≥99,9 %, LC - MS Grade Glas CP00.2 2,5 l 323,70 275,15 Acetonitril mit 0,1 % Trifluoressigsäure ≥99,9 %, LC - MS Grade Glas CP02.1 1 l 146,25 124,25 CP02.2 2,5 l 323,70 275,15 Wasser mit 0,1 % Ameisens äure LC - MS Grade Glas CP03.1 1 l 74,75 63,50 CP03.2 2,5 l 141,70 120,45 Wasser mit 0,1 % Trifluoressig s äure LC - MS Grade Glas CP05.2 2,5 l 141,70 120,45
Chemikalien
Peptidsynthese PEPTIPURE®
Harze für die Peptidsynthese
2-Chlortritylchlorid-Harz PEPTIPURE®
Best.-Nr.
Rink-Amid-Harz
Best.-Nr.
Sieber-Amid-Harz PEPTIPURE®
Lagertemperatur: +4 °C
Geschützte Aminosäuren
Für die gängigen Anwendungen in der Biochemie und speziell für die Peptidsynthese führen wir geschützte Aminosäuren von höchster Qualität und Reinheit.

Wang-Harz PEPTIPURE®
Lagertemperatur: +4 °C

Sicherheitsrelevante Daten und zusätzliche Informationen im aktuellen Katalog oder unter www.carlroth.ch
▶ Weitere geschützte Aminosäuren sowie Schutzgruppen für die Peptidsynthese unter www.carlroth.com
10
VE Verp. CHFCHF
5 g Kunst. 123,40 98,65
25 g Kunst.
373,35
7405.1
7405.2
466,70
100–200 mesh, 1 % DVB
VE Verp. CHFCHF 7515.1 1 g Glas 53,20 42,50 7515.2 5 g Kunst. 227,50 182,00
Best.-Nr. VE Verp. CHFCHF 7408.1 1 g Glas 128,70 102,95 7408.2 5 g Kunst. 518,70 414,95
100–200
PEPTIPURE® 100–200 mesh, 1 % DVB
mesh
Best.-Nr. VE Verp. CHFCHF 7506.1 1 g Glas 25,90 20,65 7506.2 5 g Kunst. 64,90 51,85 7506.3 25 g Kunst. 266,50 213,20
100–200 mesh,
% DVB
1
Produktname Reinheit Alternative Bezeichnung Best.-Nr. VE CHFCHF Boc-L-Alanin ≥97 %,
Boc-L-Ala-OH 6907.1 5 g 25,90 20,65 6907.2 25 g 88,30 70,55 6907.3 100 g 276,25 221,00 Boc-L-Arginin Hydrochlorid M onohydrat ≥98 %, für die Biochemie Boc-L-Arg-OH 6914.1 5 g 44,10 35,20 6914.2 25 g 120,80 96,55 6914.3 100 g 344,50 275,60 Boc-L-Asparagin ≥98 %, für die Biochemie Boc-L-Asn-OH 6915.1 5 g 22,00 17,55 6915.2 25 g 63,05 50,40 6915.3 100 g 206,70 165,35 Boc-L- Glutamin ≥97 %, für die Biochemie Boc-L-Gln-OH 6916.1 5 g 25,90 20,65 6916.2 25 g 88,30 70,55 6916.3 100 g 276,25 221,00 Boc-L- Glutaminsäure ≥99 %, für die Biochemie Boc-L-Glu-OH 6917.1 5 g 30,55 24,40 6917.2 25 g 96,85 77,45 6917.3 100 g 318,50 254,80 Boc-Glycin ≥98 %, für die Biochemie Boc-Gly-OH 6918.1 5 g 18,85 15,05 6918.2 25 g 51,35 41,05 6918.3 100 g 162,50 130,00 Boc-L-Phenylalanin ≥99 %, für die Biochemie Boc-L-Phe-OH 6931.1 5 g 29,80 23,75 6931.2 25 g 89,05 71,20 6931.3 100 g 279,50 223,60
Monohydrat ≥98 %, für die Biochemie Fmoc-L-Ala-OH 6646.1 10 g 29,25 23,40 6646.2 50 g 87,00 69,55 6646.3 250 g 344,50 275,60 6646.4 500 g 656,50 525,20 6646.5 1 kg 1.233,70 986,95
≥98
Fmoc-L-Arg-OH 6896.1 5 g 48,00 38,35 6896.2 25 g 185,25 148,20 Fmoc-L-Asparagin ≥98,5 %, für die Biochemie Fmoc-L-Asn-OH 6897.1 5 g 26,65 21,30 6897.2 25 g 80,50 64,35 6897.3 100 g 258,70 206,95 Fmoc-L-Asparagins äure-(OtBu) ≥96 %, für die Biochemie Fmoc-L-As p(OtBu)-OH 9654.1 5 g 35,75 28,60 9654.2 25 g 107,25 85,80 9654.3 100 g 344,50 275,60 Fmoc-L- Glutamin ≥98 %, für die Biochemie Fmoc-L-Gln-OH 6898.1 5 g 29,25 23,40 6898.2 25 g 89,60 71,60 6898.3 100 g 297,70 238,15 Fmoc-Glycin ≥99 %, für die Biochemie Fmoc-Gly-OH 6899.1 5 g 19,40 15,45 6899.2 25 g 53,20 42,50 6899.3 100 g 185,25 148,20
für die Biochemie
Fmoc-L-Alanin
Fmoc-L-Arginin
%, für die Biochemie
Chemikalien
Peptidsynthese PEPTIPURE®
Kupplungsreagenzien
h i Gefahr H302-H311-H317-H318
Best.-Nr.
4193.1
4193.3
DIC
PEPTIPURE® ≥99 %
l h i n j Gefahr H226-H315-H317-H318-H330-H334-H410
Best.-Nr. VE
DIPEA
PEPTIPURE® ≥99,5 %
l h i Gefahr H225-H302-H318-H331-H335
DMAP
PEPTIPURE® ≥99 %
h i n j Gefahr H301+H331-H310-H315-H318-H370-H411
EDC - HCl
PEPTIPURE® ≥99 %
L agertemperatur: –20 °C
Transporttemperatur: Umgebungstemp.
i n j Gefahr
H302-H311-H315-H317-H319-H373-H410
HATU
PEPTIPURE® ≥99 %
L agertemperatur: +4 °C
g n Gefahr H315-H317-H319-H334-H335

Reagenzien zum Entschützen und Abspalten
≥99 % h n Gefahr H314-H361fd-H373
Best.-Nr. VE
2473.1
Lösungsmittel
Dichlormethan
PEPTIPURE® ≥99,9 % g n Achtung H315-H319-H336-H351
Best.-Nr. VE Verp. CHFCHF
P089.1 2,5 l Glas 105,95 84,75
Piperidin
PEPTIPURE® ≥99,5 %
l h i Gefahr H225-H302-H311+H331-H314
PyBOP®
PEPTIPURE® ≥98,5 %
L agertemperatur: +4 °C
g j Achtung H302-H317-H410
DMF
PEPTIPURE® ≥99,8 %
l g n Gefahr
H226-H312+H332-H319-H360D
Best.-Nr. VE Verp. CHFCHF
A529.3 500 ml Glas 64,90 51,85
A529.1 2,5 l Glas 191,75 153,40
A529.7 10 l Kunst. 323,70 258,95
A529.2 25 l Kunst. 609,70 487,75
TFA
PEPTIPURE® ≥99,9 %
h g Gefahr H290-H314-H332-H412
NMP
PEPTIPURE® ≥99,8 %
g n Gefahr H315-H319-H335-H360D
Best.-Nr. VE Verp. CHFCHF
P052.1 2,5 l Glas 243,75 195,00
11
VE Verp. CHFCHF
100
Glas
250 g Glas
g
30,55 24,40 4193.2
61,75 49,40
500 g Glas 107,80
1 kg Glas 201,50 161,20
kg Glas 427,70 342,15 DCC
86,15 4193.4
4193.5 2,5
PEPTIPURE® ≥98 %
Verp. CHFCHF
ml Glas
25 ml Glas 80,50
100 ml Glas 227,50 182,00
500 ml Glas
6981.1 5
29,80 23,75 6981.2
64,35 6981.3
6981.4
778,70 622,95
VE Verp. CHFCHF 6988.1 5 g Glas 22,00 17,55 6988.2 25 g Glas 42,80 34,15 6988.3 100 g Glas 129,90 103,85 6988.4 500 g Glas 453,70 362,95
Best.-Nr.
Best.-Nr. VE Verp. CHFCHF 2156.1 5 g Glas 36,30 28,95 2156.2 25 g Glas 103,35 82,65 2156.3 100 g Glas 305,50 244,40 2156.5 1 kg Glas 2.587,00 2.069,60
Best.-Nr. VE Verp. CHFCHF 2131.1 5 g Glas 84,40 67,45 2131.2 25 g Glas 310,70 248,55
Best.-Nr.
Verp. CHFCHF 2178.1 5 g Glas 48,00 38,35 2178.2 25 g Glas 146,25 117,00 2178.3 100 g Glas 427,70 342,15 2178.5 1 kg Glas 3.107,00 2.485,60
VE
2474.1 100 ml Glas 40,20 32,10 2474.2 250 ml Glas 72,70 58,10 2474.3 1 l Glas 245,70 196,55 2474.4 2,5 l Glas 505,70 404,55
Best.-Nr. VE Verp. CHFCHF
Best.-Nr. VE Verp. CHFCHF A122.1 200 ml Glas 51,35 41,05 A122.2 500 ml Glas 96,85 77,45 A122.3 1 l Glas 159,25 127,40 A122.4 2,5 l Glas 279,50 223,60
Verp. CHFCHF
10 ml Glas 66,20 52,90
25 ml Glas 133,25 106,60
100 ml Glas
383,75 HFIP
Best.-Nr.
Verp. CHFCHF P088.1 100 ml Glas 123,40 98,65 P088.2 500 ml Glas 583,70 466,95 P088.3
2473.2
2473.3
479,70
PEPTIPURE®
VE
1 l Glas 1.012,70 810,15
Chemikalien
Zubehör zu Peptidsynthese

Reaktoren für die Peptidsynthese
2
5
5
Fritten für Reaktoren
ROTH SELECTION.
5
Luer Stopp Kappen für Reaktoren
ROTH SELECTION.


Schüttler Orbital Digital Heathrow Scientific.
• Bewegungsart kreisförmig
• Flexible Fixierung von Plates, Petrischalen, Glaskolben und Kulturflaschen mittels Gummibändern
• Digitale Anzeige für Drehzahl und Laufzeit
• Elektronische Drehzahlregelung mit Softstart
• Beladungsmöglichkeiten: z. B. 9 Erlenmeyerkolben 250 ml oder 4 Erlenmeyerkolben 500 ml oder 4 Erlenmeyerkolben 1000 ml oder 16 Bechergläser 250 ml oder 4 Bechergläser 1000 ml
• 5 Jahre Garantie
Technische Daten:
Best.-Nr.
PY67.1
Typ Digital Orbitalschüttler
Bewegungsart kreisförmig
Drehzahlbereich 20 bis 300 min ¹
Schüttelamplitude (Hub) 19 mm
Zeitschaltuhr 1 min bis 49 h oder Dauerbetieb
Schüttelfläche 279 x 279 mm
B x T x H 314 x 312 x 197 mm
Beladungskapazität 4,5 kg
Zul. Umgebungsbedingungen +2 bis +40 °C bei 80 % rF
Netzanschluss 100–240 V, 50/60 Hz
Lieferung inkl. Plattform mit Gummimatte und 8 Gummibänder.
Typ Best.-Nr. VE CHFCHF Digital Orbitalschüttler PY67.1 1 Stück 1.307,80 915,45
Passend für Ausführung Best.-Nr. VE CHFCHF 2 ml Reaktoren PE 226H.1 100 Stück 90,90 72,65 5 ml Reaktoren PE 226K.1 100 Stück 141,70 113,35 10 ml Reaktoren PE 226L.1 100 Stück 175,50 140,40 20 ml Reaktoren PE 220N.1 100 Stück 175,50 140,40 2 ml Reaktoren PTFE 7946.1 100 Stück 129,35 103,45
ml Reaktoren PTFE 7960.1 100 Stück 141,70 113,35 10 ml Reaktoren PTFE 7962.1 100 Stück 167,70 134,15
Passend für Best.-Nr. VE CHFCHF Luer (männlich) 1Y23.1 10 Stück 16,25 13,00 Luer (männlich) 1Y23.2 100 Stück 119,50 95,55
ROTH SELECTION. Volumen (ml) Ausführung Best.-Nr. VE CHFCHF
PP, Fritte aus PE 7926.2 10 Stück 14,20 11,30
PP, Fritte aus PE 7926.1 100 Stück 120,80 96,55
2
PP, Fritte aus PE 7927.2 10 Stück 18,10 14,40
PP, Fritte aus PE 7927.1 100 Stück 144,95 115,95 10 PP, Fritte aus PE 7944.2 10 Stück 20,70 16,50 10 PP, Fritte aus PE 7944.1 100 Stück 159,25 127,40 20 PP, Fritte aus PE 9261.2 10 Stück 24,05 19,20 20 PP, Fritte aus PE 9261.1 100 Stück 201,50 161,20 Bestellungen: 061 / 712 11 60 · info@carlroth.ch Chemikalien
Preishammer!
Gültig von 3. Juni bis 31. Juli 2024
Weitere Sonderpreise in der aktuellen Life Science-Broschüre!
Nährmedienzusätze für die Mikrobiologie
Bacillus cereus-Zusatz

Campylobacter-Preston-Zusatz
Clostridium perfringens Zusatz
Eigelb-Emulsion
Eigelb-Tellurit-Emulsion
Legionella BCYE Wachstumszusatz
Legionella GVPC-Zusatz
Listeria-Chromo-Lipase C-Zusatz
Listeria-Chromo-Selektiv-Zusatz
TTC-Zusatz
Yersinia-Zusatz

Medienzusatz zur selektiven Isolation von Bacillus cereus.
Medienzusatz zur selektiven Isolation von Clostridium perfringens.
Medienzusatz zur Herstellung von Eigelb-Agar zum Nachweis mikrobieller Lecithinase-Aktivität
Medienzusatz zur Herstellung von Eigelb-Tellurit-Agar zum Nachweis von S taphylococcus aureus
Wachstumszusatz zur Isolation von Legionellen
Medienzusatz zur selektiven Isolation von Legionellen
Medienzusatz zur selektiven Isolation von Listeria
Medienzusatz zur selektiven Isolation von Listeria
Medienzusatz zur Identifikation von coliformen Enterobakterien
Medienzusatz zur selektiven Isolation von Yersinia enterocolitica
Sicherheitsrelevante Daten und zusätzliche Informationen im aktuellen Katalog oder unter www.carlroth.ch


ROTH AG · Fabrikmattenweg 12 · 4144 Arlesheim Bestellungen: 061 / 712 11 60 · Faxbestellungen: 061 / 712 20 21 · E-Mail-Bestellungen: info@carlroth.ch · Roth im Internet: www.carlroth.ch www.carlroth.com/ch/de/Kaufmaennische-Beratung-Aussendienst
Es gelten die allgemeinen Geschäfts- und Lieferbedingungen der Roth AG, Arlesheim
Life Science
Produktname Allgemeine Verwendung Best.-Nr. VE CHFCHF
4856.1 10 Stück 176,15 123,30
8851.1 10 Stück 604,50 423,15
Zur selektiven Isolation von Campylobacter spp.
CL52.1 10 Stück 375,70 262,95
0402.1 100 ml 70,85 49,60
0339.1 100 ml 84,40 59,00 0339.2 250 ml 103,90 72,70
CL49.1 1 Set 383,50 268,45
CL50.1 10 Stück310,70 217,45
2948.1 10 Stück 175,50 122,85
2947.1 10 Stück 175,50 122,85
CP72.1 500 mg 126,00 88,10
4880.1 10 Stück 180,70 126,45
CH-DE
Preishammer!
Gültig von 3. Juni bis 31. Juli 2024
Weitere Sonderpreise in der aktuellen Chemikalien-Broschüre!
Standards für die Ionenchromatographie
Ammonium IC-Standardlösung
ROTI®Star 1 000 mg/l NH4+
Typanalyse
c (NH4+) in H2O 1000 mg/l Rückführbar auf SRM von NIST.
Bromat IC-Standardlösung
ROTI®Star 1 000 mg/l BrO3 –n Gefahr H350
Typanalyse
c (BrO3 –) in H2O 1000 mg/l Rückführbar auf SRM von BAM.

Chlorit IC-Standardlösung
ROTI®Star 1 000 mg/l ClO2–
Typanalyse c (ClO2-) in 0,1 % NaOH 1000 mg/l Rückführbar auf SRM von NIST.
Bromid IC-Standardlösung
ROTI®Star 1 000 mg/l Br –
Typanalyse
c (Br–) in H2O 1000 mg/l Rückführbar auf SRM von NIST.
Chlorid IC-Standardlösung
ROTI®Star 1
Typanalyse c (Cl-) als KCl in H2O 1000 mg/l Rückführbar auf SRM von NIST.
Fluorid IC-Standardlösung
ROTI®Star 1 000 mg/l F –
Typanalyse c (F-) in H2O 1000 mg/l Rückführbar auf SRM von NIST.
Nitrit IC-Standardlösung
ROTI®Star 1 000 mg/l NO2–
Typanalyse c (NO2–) in H2O
mg/l Rückführbar auf SRM von BAM.
Nitrat IC-Standardlösung
ROTI®Star 1 000 mg/l NO3 –
Typanalyse c (NO3 –) in H2O 1000 mg/l Rückführbar auf SRM von NIST.
Phosphat IC-Standardlösung
ROTI®Star 1 000 mg/l PO43–
Typanalyse c (PO43-) als NH4H2PO4 in H2O 1000 mg/l Rückführbar auf SRM von NIST.
▶ Weitere Anionen- und Kationen-Standards finden Sie unter www.carlroth.ch
Sulfat IC-Standardlösung
ROTI®Star 1 000 mg/l SO42–
Typanalyse c (SO42–) in H2O 1000 mg/l Rückführbar auf SRM von NIST.
Best.-Nr.
Verp. CHFCHF
100 ml HDPE 72,70 50,80 2654.2 500 ml HDPE 149,50 104,65
VE
2654.1
Best.-Nr. VE Verp. CHFCHF 8170.1 100 ml HDPE 73,45 51,40 8170.2 500 ml HDPE 149,50 104,65
VE Verp. CHFCHF 2655.1 100 ml HDPE 73,45 51,40 2655.2 500 ml HDPE 149,50 104,65
Best.-Nr.
Best.-Nr. VE Verp. CHFCHF 2656.1 100 ml HDPE 73,45 51,40 2656.2 500 ml HDPE 149,50 104,65
000 mg/l
Cl –
Verp. CHFCHF 8172.1 100 ml HDPE 73,45 51,40
Best.-Nr. VE
Best.-Nr.
Verp. CHFCHF 2659.1 100 ml HDPE 73,45 51,40 2659.2 500 ml HDPE 149,50 104,65
VE
Best.-Nr. VE Verp. CHFCHF 2661.1 100 ml HDPE 73,45 51,40 2661.2 500 ml HDPE 149,50 104,65
Best.-Nr. VE Verp. CHFCHF 2664.1 100 ml HDPE 73,45 51,40 2664.2 500 ml HDPE 149,50 104,65
Best.-Nr. VE Verp. CHFCHF 2665.1 100 ml HDPE 73,45 51,40 2665.2 500 ml HDPE 149,50 104,65
1000
Verp. CHFCHF 2666.1 100 ml HDPE 73,45 51,40 2666.2 500 ml HDPE 149,50 104,65
Best.-Nr. VE
Chemikalien





 Luca Meister redaktion@sigwerb.com
Luca Meister redaktion@sigwerb.com

















































































































 Semadeni – Grosses Interesse am Stand des Anbieters von Kunststoffprodukten für das Labor.
Scat – Im unverkennbaren Pink: Mara Höcker, Verkauf bei Scat, in Ihrer Messerolle.
Socorex – Yves Lachavanne, Geschäftsführer, und Giulia Faé, Verkauf Italien und Tessin.
Semadeni – Grosses Interesse am Stand des Anbieters von Kunststoffprodukten für das Labor.
Scat – Im unverkennbaren Pink: Mara Höcker, Verkauf bei Scat, in Ihrer Messerolle.
Socorex – Yves Lachavanne, Geschäftsführer, und Giulia Faé, Verkauf Italien und Tessin.